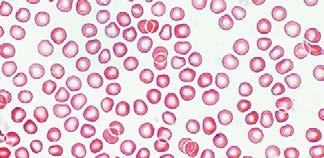

Lehen hiruhilekoa
6 LEHEN HEZKUNTZA Inguruaren Ezaguera
PROIEKTU
DAUKA Munduahelburu
12HILEKO LIZENTZIA
DIGITALA

4 Lurra etengabe

Ikasturtean zehar zientzia egiteko erabiliko dituzun STEM tresna guztiak ditugu.
16 Gizakion zenbait «matxura» ikertuko ditugu, zerk huts egiten duen ikusi eta matxura horiek nola konpon daitezkeen jakiteko.
32 Gure ohituren inguruan hausnartu, eta proposamen bat egingo dugu, haiek hobetu eta osasungarriagoak izan daitezen lortzeko.
Osasuna eta ongizatea
Jonayren egoera ikuspuntu biologikotik aztertuko dugu, eta gutun bat idatziko diogu, anima dadin.
5 Materia ezagutuz
Zenbait paisaiaren maketak egingo ditugu, paisaiak nolakoak diren eta nola zaindu ditzakegun ulertzeko.
Osasuna eta ongizatea
7 Aurrerabidea edo natura? Biak?
92 Gure plater gustukoenen errezetak aztertuko ditugu, haietan materia nola erabiltzen den jakiteko.
Osasuna eta ongizatea






9 Zatoz gu bisitatzera!
Ikastetxea argindarrik gabe gelditu dela imajinatu eta Uxoarena bezalako biziraupen-plan bat egingo dugu.
Lehorreko bizitza
Goserik ez izatea

Energia eskuragarria eta ez-kutsatzailea

126 Sare sozialen bidez, gure erkidegoko herrikideei jakinaraziko diegu zein garrantzitsua den ekoizpen eta kontsumo arduratsuaren aldeko ekintzen berri ematea. Ekoizpen eta kontsumo arduratsua
Gutun bat idatziko diogu Europako Batzordeari, ur-eskasiagatik kezkatuta gaudela jakinarazteko; aldi berean, arazoa arintzeko politiken aldeko sinadura-bilketa bat jarriko dugu martxan.
164
Edateko ura eta saneamendua
Turismoarekin lotutako negozio bat irekiko dugula imajinatuko dugu, eta, hura eratzeko, ekonomia-, gizarte-eta ingurumen-jasangarritasuna izango ditugu kontuan. Lan duina eta hazkunde ekonomikoa
Inkesta bat egingo dugu, etxeko lanetan familiako nor aritzen den jakiteko.
Genero-berdintasuna
Medikuntzako aurrerapenei buruz eta osasun-zerbitzuen arloan lan egiten duten profesionalei gure esker ona erakusteko moduei buruz eztabaidatuko dugu. Osasuna eta ongizatea
Energia aurrezteko eta energiaren erabilera arduratsua egiteko ideia-gida bat egingo dugu. Energia eskuragarria eta ez-kutsatzailea



Zer ikasiko dugu? OR. IKASKUNTZA-EGOERA HELBURUA AURRERA GJH DIZIPLINARTEKOA
8 Nire STEM tresna-kaxa
mendean
184 10 Espainia XIX.
11 Espainia XX. eta XXI. mendeetan
200
216 12 Ekonomia, gizartea eta kultura
144 8 Ur-eskasia, benetako arazo bat?
1 Zerez eginak gauden ikasiko dugu
2 Osasungarria da gure elikadura
54 3 Erlazio- eta ugalketafuntzioen osasun ona
70
aldatzen dela ikasiko dugu
106 6 Energia erabiltzen dugu
• Metodo zientifikoa
• Bizi-funtzioak eta zelulak
• Zelulen ezaugarriak, formak eta tamainak
• Nutrizio-funtzioa eta mantenugaiak
• Elikagaiak eta haien sailkapena
• Dieta eta elikadura osasungarria
• Erlazio-funtzioa eta haren etapak
• Ohitura osasungarriak eta zentzumen-organoen funtzionamendua
• Lurraren geruzak, mineralak eta arrokak
• Magmatismoa, lurrazalaren deformazioa eta haien ondorioz eratzen diren arrokak
• Proiektuetan oinarritutako metodoa
• Ehunak eta zer ehun mota ditugun
• Organoak eta zer organo mota ditugun
• Digestioa, arnasketa, zirkulazioa eta aparatu horien osasun ona
• Iraizpena eta iraitz-aparatuaren osasuna
• Ohitura osasungarriak eta nerbio-sistemaren funtzionamendua
• Ohitura osasungarriak eta lokomozioaparatuaren funtzionamendua
• Erliebea modelatzen duten prozesuak eta arroka sedimentarioak
• Lurraren historia geologikoa
• Pentsamendu konputazionala
• Aparatuak eta sistemak eta zer aparatu eta sistema mota ditugun
Konpetentziak lantzeko ariketak
Konpetentziak lantzeko ariketak
1. hiruhilekoaren berrikuspena: 1. eta 2. u ni tateak. STEAM: Lynn Margulis
• Ugalketa-funtzioa. Pubertaroa
Konpetentziak lantzeko ariketak
Konpetentziak lantzeko ariketak
1. hiruhilekoaren berrikuspena: 3. eta 4. unitateak. STEAM: Rita Levi-Montalcini
DIZIPLINARTEKO PROIEKTUA · Kutxa magikoa eta haren zaintza: Kutxa magikoaren misterioa
• Materia eta haren propietate orokorrak
• Dentsitatea eta flotagarritasuna
• Materiaren egitura. Atomoak
• Energia, haren ezaugarriak, energia motak eta aldaketak
• Energia-iturriak eta energia-iturri motak
• Elektrizitatea eta magnetismoa
• Erliebea eta haren aldaketak
• Espainia: erliebearen kokapena eta ezaugarriak
• Planetako urak: hidrosfera
• Ibaiak eta gainerako ur kontinentalak
• Espainiako hidrografia
• Materiaren egoerak eta haien aldaketak
• Nahasteak, nahaste motak eta haien osagaiak bereizteko metodoak
• Energia behar bezala erabiltzen dugu?
• Aerodinamika, errodadura eta flotagarritasuna: oinarrizko printzipioak
• Proiektuak eta bideojoko bat egiten
• Penintsulako erliebea
• Kostaldeetako erliebea
• EAEko erliebea
• EAEko hidrografia
• Europako hidrografia
• Uraren kontsumo arduratsua
Konpetentziak lantzeko ariketak
Konpetentziak lantzeko ariketak
2. hiruhilekoaren berrikuspena: 5. eta 6. unitateak. STEAM: Hedy Lamarr eta Émilie du Châtelet
• Europa: erliebearen kokapena eta ezaugarriak
Konpetentziak lantzeko ariketak
Konpetentziak lantzeko ariketak
2. hiruhilekoaren berrikuspena: 7. eta 8. unitateak
DIZIPLINARTEKO PROIEKTUA · Orain edo inoiz ez: Nik, zuk, guk... Denok ekin!
• Ekonomia-jarduerak
• Kontsumitzaileak gara
• Enpresak eta enpresa motak
• Aro Garaikidearen hasiera
• Fernando VII.aren erreinaldia. Azkeneko errege absolutista
• Alfontso XIII.aren erreinaldia eta II. Errepublika
• Gerra Zibila eta Francoren diktadura
• xix mendeko ekonomia- eta gizarte-aldaketak
• xix mendeko kultura eta artea
• Ekonomia-sektoreak. Lehen sektorea
• Bigarren sektorea
• Hirugarren sektorea
• Isabel II.a eta Seiurteko Iraultzailea
• Borboiko etxearen Berrezarkuntza
• EAE xix mendean
• Demokrazia iritsi zen
• Espainia Europar Batasunean
• EAE xx eta xxi mendeetan
• xx -xxi mendeetako ekonomia eta gizartea
• xx eta xxi mendeetako kultura eta artea
• Aro Garaikideko gertaerak eta pertsonak
• EAEko ekonomia-sektoreak
• Ekonomia-sektoreak Europan
Konpetentziak lantzeko ariketak
• xix mendeko gertaerak eta pertsonak
Konpetentziak lantzeko ariketak
3. hiruhilekoaren berrikus.: 9. eta 10. unitateak
• xx eta xxi mendeetako gertakari eta pertsona ospetsuak
Konpetentziak lantzeko ariketak
Konpetentziak lantzeko ariketak
3. hiruhilekoaren berrikuspena: 11. eta 12. unitateak
PROYECTO INTERDISCIPLINAR - Aprender de lo natural DIZIPLINARTEKO PROIEKTUA · Birika berdea: Itzaltzea baino, saihestea hobe
JAKITEA... IKASTEKO, APLIKATZEKO ETA IKERTZEKO
BIZIRAUPEN-PLANA
ZER BEHAR DUT?





IDEIAK




– Bi esku-argi ditut: bata, biradera bati eraginez kargatzen da eta, besteak, eguzki-plakatxo bat du.
– Bainugelan, bost kandela usaindun eta hamasei pospolo dituen kutxa txiki bat dauzkagu.
– Eguzki-argia dugu egunez.
– Gure etxea hondartzatik hurbil dagoenez, laguntza eskatzeko mezuak itsasora jaurti ditzaket. Zorte pixka batekin, olatuek eraman eta baten batek aurkituko ditu. – Kometa handi samar bat daukat, eta haizea dabil. Laguntza-mezu bat idatz dezaket bertan, eta zeruan hegaldarazi.
Despentsako elikagaiak berotzea
– Eguzki-labe bat egin dezaket paperarekinaluminioeta kaxa batekin. Udalekuetan ikasi nuen hori egiten.

Bideojoko bat egingo dut, urratsez Bloke bidezko programazioa 7 Energia eta
Marruskadurari, murgilketari eta errodadurari buruzko proiektu teknologikoak 6 Energia behar bezala erabiltzen dugu? Energiaren erabilerak eragiten dituen arazoak 5 Magnetismoa Imanak eta haien erabilerak 3 4 Energia-iturri etaberriztagarriakberriztaezinak Energia-iturriak eta energia-iturri motak 7
mugimendua
Argia
Laguntza eskatzea
Proiektu honek ikasturteko eduki guztiak eskaintzen dizkizu, bai liburu digitalaren bidez, bai era askotako baliabideen bidez.
Ikasteko beste modu bat ezagutuko duzu, erraza, intuitiboa eta edozein plataforma eta gailurekin bateragarria.
4 Nola sailkatzen dugu materia? Agregazio-egoerak
Materia egoeraz aldatzen da
Materiak aldaketa fisikoak izan ditzake. Halako aldaketetan, materiak jatorrizko itxura aldatzen du, baina ez bere konposizioa.
Aldaketa fisiko ohikoenak materia berotzean edo hoztean gertatzen dira. Hain zuzen, tenperatura-aldaketaren ondorioz, materiaren agregazio-egoera aldatu egiten da.

Materia berotzean edo hoztean, materiaren egoerak (solidoa, likidoa edo gasa) aldaketa itzulgarriak izaten ditu; materiaren egoera-aldaketak dira horiek.

Materiaren egoera-aldaketak itzulgarriak dira. Horrek esan nahi du solido bat, berotzean, likido bihurtuko dela, eta likido hori bera, hoztean, berriz ere solido bilakatuko dela. Horixe bera gertatzen da gainerako egoera-aldaketekin ere. Egoera-aldaketa gertatu bitartean, tenperatura konstante mantentzen da.

Aldaketa-egoeren izenak
Sublimazioa
Izotz solidoa
2 Osatu esaldia koadernoan. ... konstante mantentzen da, ... gertatu bitartean.
Alderantzizko sublimazioa
Atmosferako ur-lurruna
Ur likidoa
haren tenperatura astiro ... da.


6. Tenperatura igotzen den heinean, likidoan burbuilatxo batzuk agertzen hasi dira.
4 Berdina al da Espainiako kostalde osoa?

Nola sartu?
Zure liburuko lehenbiziko orrialdearekin batera aurkituko dituzu proiektu digitalean sartzeko behar dituzun argibide guztiak.

Kostalde atlantikoa
behar da; hau da, urak likido-egoeratik gas-egoerara aldatu behar du.
Kostalde mediterraneoa


136


Espainiako kostaldeak 5 970 km ditu gutxi gorabehera, Iberiar penintsularen, Balear eta Kanaria uharteen, eta Ceuta eta Melilla hirien artean banatuta. Kostalde atlantikoaren eta kostalde mediterraneoaren artean aldeak daude.



Kostaldea Kokapena Ezaugarriak
KantauriarraBidasoa ibaiaren bokalean hasten eta Ortegal lurmuturreraino iristen da.
Galiziakoa Ortegal lurmuturrean hasten eta Miño ibaiaren bokaleraino iristen da.
AndaluziakoaGuadiana ibaiaren bokalean hasten eta Gibraltarko itsasarteraino iristen da.

Hegoaldekoa Gibraltarko itsasartean hasten da eta Murtziako Eskualdearen eta Valentziako Erkidegoaren arteko hegoaldeko mugaraino iristen da.
Ekialdekoa Valentziakoa. Segura ibaiaren ibar beherean hasten eta Ebroren deltaraino iristen da.
Kostalde garaia, malkartsua, harritsua eta zuzena da.
Zer hartu behar dugu aintzat gure kostaldeetan ekonomia- jarduerak garatzeko? rraldeko Ezaugarriak: Balear Kokapena. kostaldearen Ezaugarriak:
Galiziako kostalde atlantikoaren iparraldea Rías Altas da, eta hegoaldea, Rías Baixas. Itsasadarrak tarteko, hain zuzen, kostaldea oso koskatua da, bai eta garaia eta harritsua ere.

Zuzena, baxua eta hareatsua da, eta hondartza handiak ditu.
Kostalde garaia, malkartsua, harritsua eta zuzena izateagatik nabarmentzen da.
Gata eta Palos lurmuturrak. Almeríako golkoa.
Gero eta ohikoagoa da influencerrek bizi garen natura-inguruneen egoera salatzea beren sare so-


Kostalde baxu eta hareatsua da, eta, oro har, hondartza handiak ditu.
Koskatua, garaia, malkartsua eta harritsua da. Creus lurmuturra. Rosesko golkoa.
Nau lurmuturra Kataluniakoa. Ebroren deltan hasten eta Frantziako mugaraino iristen da.
zialetan. Hona hemen, adibide modura, zenbait post, al hauetariko ATLANTIKOA BALEARRAK Major PORTUGAL FRANTZIA ANDORRA Kantauri OZEANO ATLANTIKOA M d t raneo itsa a Melilla itsasartea Almeríako golkoa Sant Jordi golkoa Valentziako golkoa Bizkaiko Cádizko golkoa Gibraltarko Ortegal lurmuturra Matxitxako Ajo Gata lurmuturra Palos lurmuturra lurmuturra Ebroren Trafalgar Ekhi_lore Euskadiko kostaldean pasieran ibili, eta hau aurkitu ez dugu, ba? Oporrak horrela? Gero, zikinkeria hori guztia Kantauri itsasora iritsiko da. #bizitzajasangarria #horrelaez Ekhi_lore Head_JL Hauxe egiten diogu etengabe Baixas maiteari. Bihotzak krak egiten #stopplastikoak #bizitzajasangarria Head_JL Kantauriko kosta Andaluziako kosta atlantikoa Atlantikoko kosta
Honelakoa da zure proiektu digitala 102 103
Kondentsazioa Solidotzea Lurrunketa Urtzea
Kanaria uharteetako erliebea Kokapena. Ozeano Atlantikoan daude, Afrika iparraldeko kostaldearen parean. Ezaugarriak: Erliebea. Menditsua eta sumendijatorrikoa da, eta, hori dela eta, oso paisaia berezia dute. Tenerife uhartean dago Espainiako mendirik altuena: Teide (3 718 m). Kostaldea. Oro har, kostaldea altua, malkartsua eta koska handirik gabea da, baina uharteetako hegoaldean hondartzak daude: ekialdekoak harrizkoak dira, eta mendebaldekoak, hareazkoak.

Balear uharteetako erliebea Kokapena. Mediterraneo itsasoan dago, Valentziako kostaldearen parean. Ezaugarriak: Erliebea. Oro har, menditsua eta Penintsulako erliebearen antzekoa da. Mallorca, Eivissa eta Formenteran, erliebea Mendikate Penibetikoaren luzakin bat da, eta Menorcan, Kataluniako kostaldeko mendikatearena. Uharteetako mendi garaiena, Puig Major (1 445 m), Mallorcan dago, Tramuntana


Nolakoa da?
Erantzun globala era askotako hezkuntza-ingurune baterako.
Intuitiboa
Zuk erraz erabiltzeko modukoa.
Gailu anitzekoa
Edozein gailu motatan (ordenagailuan, tabletan, smartphonean…) egokitzen eta ikusten da, pantailaren edozein tamaina eta bereizmenetan.

Deskargagarria

Aukera ematen du Interneteko konexiorik gabe lan egiteko eta gailu batean baino gehiagotan deskargatzeko.

Sinkronizagarria
Erabiltzaileak egiten dituen aldaketak berez sinkronizatzen dira, lan egiteko erabilitako edozein gailu konektatzean.
Unibertsala
U7 137
Zer eskaintzen dizu?
Era askotako baliabideak ditu; paperezko liburuaren erreprodukzioa baino askoz gehiago da.
Honakoak egiteko aukera izango duzu:

Ariketak egin ariketa elkarreragileak
Aztertu laburpen elkarreragileak, eskemak...
Ikasi
audioak, bideoak, Game Room-ak...
Ebaluatu autoebaluazioa, portfolioa...
Bateragarria da ikastetxeetan gehien erabiltzen diren sistema eragileekin, ikaskuntzako inguru birtualekin (IIB) eta hezkuntza-plataformekin (LMS).
ere Mallorca eta
post, arazo horren berri ematen dutenak. Jakingo zenuke esaten zer kostaldetan atera den argazki hauetariko bakoitza? etengabe gure Rías egiten dit. Princess_cons19 Konponbideak behar ditugu Mar Menor salbatzeko. kostaldeak ez du hau merezi. #bizitzajasangarria #SOSmarMenor Princess_cons19 mediterraneoa: Levantekoa Mediterraneoko
mendilerroan. Kostaldea. Garaia eta koskatua da, eta kalak ditu, batez
Menorca iparraldean.
Nire STEM tresna-kaxa
Zientzia egiteko, ikasturte honetan baliatuko dugun tresna-kaxa
aurkeztuko dizuet. Bertan, zientzian diharduten pertsonek erabiltzen dituzten metodoak, prozesuak eta abar aurkituko dituzue.
Metodo zientifikoa aplikatzen

ikasiko dugu!

Bai, eta ikerketa-lanak egingo ditugu, esperimentuak eta behaketak eginez.

8
Hainbat gauza berri ikasiko ditugu, informazioa bilatzeko, proiektuak egiteko, gure aurkezpenak prestatzeko, Scratch-en programatzeko...!






Nire lehen tresna



Metodo zientifikoa
Metodo zientifikoa baliatzen dugu naturari buruzko jakintzak lortzeko. Jakintza multzo horri Naturaren Zientziak deritzo.
Metodo zientifikoa laborategietan eta landa-ikerketetan aplikatzen da; izan ere, batzuetan, behaketak eta esperimentuak egin behar izaten dira, hipotesiak egiaztatzeko. Zientziaren arloan ez ezik, egunerokoan ere baliatzen da.

Metodo zientifikoaren urratsak
4



Behaketa eta esperimentuak egingo ditut, nire hipotesia egiaztatzeko
5
Datuak aztertu, eta ondorioak aterako ditut
6


Nire ikerketa-lana erakutsiko diet besteei
Nola aplikatzen da metodo zientifikoa? Adibide bat.
1. Terrazako geranioetako bat zimeltzen ari da, bestea, ordea, eder-ederra dago. Biek lur berdina dute, eta berdin ureztatu ditugu. Neure buruari galdera bat egingo diot: zergatik zimeltzen ari da geranio hori?
2. Informazioa bilatuko dut geranioek hazteko behar dituzten baldintzen inguruan. Ikerketan, datu hauek lortu ditut: 18-20 gradu arteko tenperatura, eguzkiaren argitasuna eta lur azido samarra behar dituzte.
3. Hipotesi bat egingo dut: bi geranioek lur berdina badute, eta berdin ureztatzen baditugu, eguzkiaren argitasuna da bien arteko alde bakarra.
4. Nire hipotesia egiaztatuko dut: zimeltzen ari den geranioa leku eguzkitsuago batean jarriko dut.
5. Emaitzak aztertuko ditut: geranioa berpizten ari da. Ondorioak aterako ditut: nire hipotesia zuzena da.

6. Nire ikerketa-lana ezagutzera emateko, familiakoei kontatuko diet edo txosten labur bat idatziko dut.

10
diot 1 Gai horri buruzko informazioa bilatuko dut 2
Neure buruari galdera bat egingo
3
Galderaren erantzun bat proposatuko dut (hipotesia)
Nire bigarren tresna Proiektuetan oinarritutako metodoa

Kasu batzuetan, ez da nahikoa izaten bururatzen zaizkigun galderei erantzun fidagarriak ematea, eta arazo bat konpontzeko edo funtzio zehatz bat egingo duen zerbait asmatzeko beharra izaten dugu. Horretarako, proiektuak egiten ditugu.
Liburu honetako zenbait unitatetan, proiektu-proposamen batzuk dituzu. Hauxe da proiektu bat: arazo jakin bat konpontzea helburu duen produktu bat egiteko edo zerbitzu bat emateko egin beharreko ekintzen multzoa.



Metodo teknologikoa





11
1 Konponbide
3 Eredu
4 Informazioa
2 Planifikatu,
5 Eraiki 6 Egiaztatu 7
Arazoa zein den identifikatu eta horri buruz zeure buruari galdetu
bat proposatu (makina edo zerbitzu bat)
bat diseinatu, marrazkiak edo maketa bat egin
bilatu, eta ikertu
zereginak ordenatu
Funtzionatu du Ez du funtzionatu
Konponbide egokia ezagutzera eman
Nire hirugarren tresna


Pentsamendu konputazionala
Pentsamendu konputazionala pentsatzeko modu bat da eta, hari esker, inguruan ditugun arazoen konponbideak aurkitu ditzakegu, informatikan erabili ohi diren tekniketan oinarrituta.
Zer teknika erabiltzen ditu pentsamendu konputazionalak?

Kodifikatzea
Informazioa (irudiak, kontzeptuak, ideiak, datuak...) sistema bilakatzea (hitzak, testuak...), eta horri esker, pertsonekin edo ordenagailuekin (programak) komunikatu ahal izatea.



Ereduak aurkitzea

Antzeko arazoekin alderatuta, parekotasunak bilatzea eta identifikatzea.
Algoritmoak sortzea
Gure arazoak konpontzeko, urratsez urrats egin beharreko jarraibideetan oinarritutako
Arazo konplexu bat zenbait arazo txikiagotan eta konpontzeko errazagotan banatzea.
Abstrakzioak egitea
Arazo baten elementu

Egiaztatzea
Proposatutako konponbidea egokia den, hobetu daitekeen

12
Pentsamendu konektatua eta deskonektatua
Pentsamendu konputazionala metodo zientifikoan eta proiektuak lantzeko baliatu ohi da, baita gure eguneroko bizitzako zeregin zehatz batzuk egiteko ere. Esaterako, eskulan bat egiteko, urrats-segida bati jarraitzen badiozu, algoritmo bat erabiltzen ariko zara. Eta on egiten diguten elikagaiak identifikatzeko egunero jaten dugunari erreparatzen badiogu, ereduak aurkitzen ariko gara, zer elikagai jateari utzi behar diogun zehaztu arte.
Liburu honetan, pentsamendu konputazionala landuko dugu zenbait ariketaren bidez. Haien aldamenean, robot baten ikonoa ikusiko duzu.
Pentsamendu konputazionala eta proiektuak
Proiektu bat egiteko, urrats hauek egin behar dituzu:
1
Hausnartu
Zer helburu lortu edo zer arazo konpondu nahi dugun pentsatu.
Diseinatu

Ereduak egin, arazoa konpontzen edo helburua lortzen lagunduko baitigute. Eredu horiek marrazkiak eta maketak izan daitezke.
Planifikatu
Zer zeregin egin behar diren, nola eta zer ordenatan erabaki.
4




Zereginak egin Egitekoak ezarritako ordenan gauzatu.
5
Ebaluatu
Proiektuaren emaitza balioetsi,
6



Ezagutzera eman
Proiektuaren emaitzak ezagutarazi, beste pertsona batzuek ere haren berri izan dezaten.
Lotzen al duzu urrats hauetakoren bat pentsamendu konputazionalaren teknika jakin batekin? Adierazi zein.
13
2
3
Nire laugarren tresna Bloke bidezko programazioa: Scratch

Programazio informatikoa pentsamendu konputazionalean oinarritzen da.
Informatika-programa bat ordenagailu batek edo beste gailu adimendun batek interpreta eta exekuta ditzakeen jarraibide kodifikatuen multzoa da.
Informatika-programen jarraibideak hizkuntza berezietan idatzita daude. Hain zuzen, programazio-lengoaiak dira horiek, eta hainbat desberdin daude (hala nola C+, java, python eta ruby).
Scratch
Scratch programazio-lengoaia bat eta online komunitate bat da, eta, tresna horri esker, ikus-entzunezko edukiak sortu eta parteka daitezke; hala nola bideojokoak eta marrazki bizidunak.



Scratch-en online bertsioa helbide elektroniko honetan dago eskuragarri: https://scratch.mit.edu/.
Scracht-en programazio-ingurunea irudietan oinarritzen da: programaren aginduak puzzle baten piezen antzeko blokeak dira, eta, programazio-sekuentzia osatzeko, piezak ahokatu egin behar dira. Programa, beraz, puzzle osoaren baliokidea da.
Liburu honetan, bloke bidezko programazioa landuko dugu ikono hau duten ariketetan.
Zer atal ditu Scratch-ek?

Scratch-ek hiru atal ditu: eszena, blokeak eta programa.
Blokeak
Programa
«Blokeak» ataleko lan-pantaila da. Bertara arrastatzen dira gero elkarrekin lotuko diren programa-blokeak; eta bertan daude eskuragarri programan hautatutako pertsonaien edo objektuen «Tankerak» eta «Hotsak» atalei dagozkien aukerak.
Begiratu «Scratch nola erabili», anayaharitza.es webgunean, programa zertan datzan ikusteko: zertarako baliatzen den programazio-bloke bakoitza, nola erabili programa segurtasunez...
Eszena
Bertan, programa osatuko duten atzeko irudiak, objektuak eta pertsonaiak hautatzen dira; eta, gainera, sortzen ari garen programaren aurrebista moduko bat da, besteak beste, atzeko irudiak, objektuak, pertsonaiek egiten dutena... ikusteko.
14
Hiru atal ditu: programak, tankerak eta hotsak.
Nire bosgarren tresna
IKT-IET plana




Naturaren Zientziak ikasteko eta gure proiektuak garatzeko baliagarriak izan daitezkeen hainbat tresna eskaintzen dizkigute teknologia berriek.

Anayaren IKT-IET planean, eskuragarri duzu informazio zehatza, tresna horiek zertan diren eta nola erabiltzen diren ikas dezazun. Tresna horietako baten inguruko zalantzarik baduzu, ez ahaztu anayaharitza.es webgunean kontsultatu dezakezula.

Zertarako erabiliko dituzu IKT-IET planeko tresnak?
Komunikatzeko balioko dizuten tresnak erabiltzen ikasiko duzu; esaterako, urrun dagoen norbaitekin hitz egiteko (harekin hitz egiten duzun aldi berean, ikusi ahal izango duzu gainera!) Tresna horiek hainbat laguneko taldeak sortzeko aukera ere emango dizute.
Adiskideei, senideei eta abarrei mezuak bidaltzen ikasiko duzu.
Edozein gai interesgarriri buruzko informazioa bilatzeko trikimailu erabilgarriak ikasiko dituzu, baita gai horiekin lotutako argazkiak eta bideoak ikusten ere.
Testuak, afixak eta aurkezpenak egiten ikasiko duzu. Horrez gainera, marrazkiak, animazioak eta bideojokoak egiten, eta argazkiak eta bideoak editatzen ere.
Informazioa eta irudiak antolatzeko tresnak ikasiko dituzu. Egutegi digital bat egiteko gai izango zara!

Informazioa argitaratzen eta ezagunekin partekatzen ikasiko duzu, eta hori modu seguruan eta arduratsuan egiten.

15
PLAN TIC TAC
1Zerez eginak gauden ikasiko dugu
Gure familia ez da zorte onekoa, ez! Bidaiaren bat egiten dugun bakoitzean, bidean goazela, autoa matxuratu egiten zaigu, eta turismoa konponketa-lantegietan egiten dugu, hondartzan egin beharrean.
Egia esateko, gure autoa nahiko zaharra da, baina gurasoek diote ez dela beharrezkoa berri bat erostea, gurea konpontzeko modua badago.
Hori horrela, nire ametsa auto-mekanikaria izatea da! Izugarri gustatuko litzaidake autoaren zer pieza matxuratu den berehala antzemateko gai izan eta arazoa nola konpon daitekeen jakitea. Baliteke horrela ezustekorik izan gabe oporretan joan ahal izatea!
Zer deritzozu?


Autoa edo bestelako aparaturik matxuratu zaizu inoiz? Zer gertatu zen? Nola konpondu zenuten arazoa? «Matxuratu» zaizu inoiz gorputza? Zer gertatu zitzaizun? Zure ustez, ba al dago gure gorputza «konpontzeko» modurik?

Datua

Unitate honetarako...
Helburua aurrera
Gizakion zenbait «matxura» ikertuko ditugu, zerk huts egiten duen ikusi eta matxura horiek nola konpon daitezkeen jakiteko.
70 kg inguruko heldu baten gorputza 30 bilioi zelulaz osatuta dago. Zelula horiek guztiak koordinatu egiten dira, gure gorputzak behar bezala funtziona dezan.
Jarraitu hariari!
Bizi-funtzioak eta zelulak
1
Izaki bizidunak gara!
Zelulen ezaugarriak, formak eta tamainak
2
Zelulaz osatuta gaude
16
5




3

17
Zer diren aparatuak eta sistemak, eta zer aparatu eta sistema mota ditugun
Organoek aparatuak eta sistemak osatzen dituzte
Zelulek ehunak osatzen dituzte
Zer diren ehunak eta zer ehun mota ditugun
Ehunek organoak osatzen dituzte
3
Zer diren organoak eta zer organo mota ditugun 4
Izaki bizidunak gara!

Izaki bizidunok funtzionatzeko oso modu berezia dugu: bizirik gaude!
Izaki bizidunok hiru ezaugarri komun ditugu: hiru bizi-funtzioak egiten ditugu, zelulaz osatuta gaude, eta antzeko osagaiak ditugu.
Bizi-funtzioak egiten ditugu


Nutrizio-funtzioa

Nutrizio-funtzioari esker, izaki bizidunek ingurunetik substantziak hartu ditzakete, eta energia lortzeko, hazteko eta gorputzean dituzten kalteak osatzeko erabili. Gainera, hondakinak kanporatzeko bidea ematen du.
Gizakion nutrizioa heterotrofoa da; hau da, elikagaiak lortzeko, beste izaki bizidunez elikatzen gara.
Erlazio-funtzioa
Erlazio-funtzioa gorputzaren barruan eta kanpoan gertatzen diren aldaketak (estimuluak) hautematea eta erreakzionatzea da.
Ugalketa-funtzioa
Ugalketa-funtzioaren bidez, gurasoek beren antzeko ezaugarriak dituzten ondorengoak sortzen dituzte.
Gizakion ugalketa sexu bidezkoa da. Mota horretako ugalketan, bi banakok (bata arra eta bestea emea) ugalketa-zelulak edo gametoak sortzen dituzte; eta, bi gameto elkartzen direnean, bana ko bat sortzen da.
1 Gogoratzen duzu nutrizio autotrofo terminoa? Idatzi koadernoan zertan diren desberdinak nutrizio autotrofoa eta heterotrofoa. Zer elikadura mota dugu animaliok?
2 Gogoratzen duzu zer den sexugabeko ugalketa ? Idatzi koadernoan zein den sexu bidezko eta sexugabeko ugalketen arteko alde nagusia. Zer ugalketa mota dugu animaliok?

18
1
Elikagaiak jateko eta arnasa hartzeko beharra dugu, gure gorputzak behar dituen mantenugaiak eskuratzeko.
Erlazio-funtzioari esker, estimuluak hauteman eta erreakzionatzen dugu.
Ugaltzean, gizakiok gure antzeko ezaugarriak dituzten ondorengoak sortzen ditugu.
Zelulaz osatuta gaude
Izaki bizidun guzti-guztiak, izan bakterio bat, zuhaitz erraldoi bat edo gizaki bat, zelulaz osatuta gaude.
Zelula bat izaki bizidunen zatirik txikiena da; hau da, hiru bizi-funtzioak egiteko gai den organismo baten zatirik txikiena.
Antzeko osagaiak ditugu
Izaki bizidunok osagai berdintsuak ditugu. Hain zuzen, bi osagai nagusi ditugu: ura, disolbatutako zenbait konposatu mineral dituena, eta izaki bizidunok soilik ditugun substantzia batzuk (hala nola karbohidratoak, proteinak, gantzak eta azido nukleikoak ).
Izaki bizidunon konposizio kimikoaren matematika
El agua es imprescindible para que existan seres vivos ya que, sin ella, las células no pueden realizar las funciones vitales. Todos los seres vivos estamos compuestos por agua: unos tenemos más y otros menos. Fíjate en los siguientes gráficos: representan la cantidad de agua (en tanto por ciento) de diferentes seres vivos.


Ura ezinbestekoa da izaki bizidunak biziko badira, izan ere, zelulek ezin dute bizi-funtziorik egin, urik ez badute. Izaki bizidun guztiok urez osatuta gauden arren, izaki mota bakoitzaren ur kantitatea desberdina da. Erreparatu grafikoei: lau izaki bizidun mota horien ur kantitateak irudikatzen dituzte ehunekotan.
1 Ordena en tu cuaderno a estos seres vivos, desde el que contiene más agua al que contiene menos. ¿Tienen alguna característica común los dos seres vivos que contienen más agua en su cuerpo?



Ordenatu zure koadernoan grafikoetako izaki bizidunak, ur gehien duenetik gutxien duenera. Ba al dute ezaugarri berdinik beren gorputzetan ur gehien duten bi izaki bizidunek?
2 Zenbat kilogramo ur ditu gorputzean 70 kg-ko gizon heldu batek?
2 Un humano adulto humano de 70 kg ¿Cuántos kg de agua tiene en su cuerpo?

3 Uraren pisua neurri-unitatez erraz aldatu dezakezu, baldin eta kontuan baduzu kilo batek litro bateko bolumena hartzen duela. Litro bateko zenbat ur-botila bete ditzakezu bigarren ariketan kalkulatu duzun ur kantitatearekin?
3 Puedes transformar el peso de agua en volumen fácilmente porque 1 kg de agua ocupa 1 l de volumen. ¿Cuántas botellas de 1 l de agua puedes llenar con la cantidad de agua que has calculado?




4 Un elefante africano adulto también tiene un 60% de agua en su cuerpo, pero pesa 6.000 kg ¿Cuántos kg de agua tiene en su cuerpo?
4 Elefante afrikar heldu batek ere % 60ko ur kantitatea du gorputzean, baina 6 000 kg-ko pisua. Zenbat kilo ur ditu gorputzean? Eta litro bateko zenbat ur-botila bete ditzakezu elefante afrikar baten gorputzaren ur kantitatearekin?
Izugarria da, ezta?
¿Cuántas botellas de 1 l de agua puedes llenar con el agua del cuerpo de un elefante africano? Sorprendente, ¿verdad?
Gogoan hartu!





Izaki bizidun guztiak bezalaxe, gizakiok zelulaz osatuta gaude, eta hiru bizi-funtzioak egiten ditugu.

19 U1
Árbol Alga Ser humano 95% de agua Medusa 99 % de agua 60% de agua 50 % de agua
Alga Gizakia Ura (% 95) Marmoka Ura (% 99) Ura (% 60) Ura (% 50)
Zuhaitza
Gizakion gorputza milioika zelulaz osatuta dago.
Zure

Zelulaz osatuta gaude
Animalia guztien moduan, gizakiok izaki zelulaniztunak gara. Horrek esan nahi du funtzio jakin batzuk betetzen dituzten hainbat motatako zelulaz osatuta gaudela, alegia.
Giza zelulak
Gizakion gorputza animalia-zelula eukariotoz osatuta dago.
Giza zelulek lau atal nagusi dituzte:
Mintz plasmatikoa
Zelula inguratzen duen bilgarria da. Zelularen barrualdearen eta kanpoaldearen arteko substantzien trukea kontrolatzen duen hesi antzeko bat da.
Zitoplasma
Zitoplasma zelularen barnealdea betetzen duen likido bat da, eta bertan daude zelularen milaka substantzia eta hainbat egitura. Egitura horiei organulu deritze.
Material genetikoa
Material genetikoa (DNA) zelulen fun tzionamendurako informazioa gordetzen duen substantzia da.
Giza zelulak eukariotoak direnez, material genetikoa nukleo izeneko mintzezko konpartimentu batean dago babestuta.

Organuluak
Zitoplasman dauden egiturak dira, eta hainbat funtzio betetzen dituzte. Organulu mota asko daude, baina bi besterik ez ditugu aztertuko orain:
• Mitokondriak: zotz itxurako organuluak dira, eta zelulen energia-zentralak direla esan genezake.
• Erribosomak: oso egitura txikiak dira, eta zitoplasman aske edo beste zenbait egituratan itsatsita egon daitezke. Erribosomek proteinak sortzeko funtzioa betetzen dute.
Kontuan hartu zelulak bi motatakoak izan daitezkeela:
Prokariotoak: material genetikoa zitoplasman barreiatuta dute. Bakterioak, esaterako, zelula prokariotoak dira.
Eukariotoak: material genetikoa nukleo batean dago babestuta. Animaliak eta landareak, adibidez, zelula eukariotoz osatuta daude.
1 Zergatik esaten da zelulak bizirik daudela?
2 Nolakoak dira zelula eukariotoak? Zer alde dituzte zelula horiek eta prokariotoek?
3 Zertarako balio du zelulen mintz plasmatikoak?
4 Zer funtzio egiten dute mitokondriek? Eta erribosomek?
20
2
gorputza milioika pieza txiki-txikiz osatuta dago, zelulaz, alegia, eta haietako bakoitza bere kabuz funtzionatzeko gai da.
Honelakoak dira animalia-zelulak
Nukleoa
Material genetikoa (DNA)


Zitoplasma
Erribosomak
Begira nola pentsatzen dudan
Jateko moduko zelula bat
Lana prestatu Naturaren egitura ulertzeko modu egoki bat ereduak egitea da; hau da, natura hobeto ulertzeko baliagarriak izango zaizkigun adierazpen sinplifikatuak.
Ariketa honetan, hain zuzen, animalia-zelula eukarioto bat egingo dugu, zenbait elikagai baliatuta. Kontuan hartu honako hau proposamen bat besterik ez dela, eta, hala nahi izanez gero, beste osagai batzuk ere erabil ditzakezula. Sormenak agindu dezala!
Mintza egiteko, zirkulu formako ontzi bat behar dugu.
Zitoplasma egiteko, limoizko gelatina.
– Nukleoa egiteko, erdibitutako kiwi bat.
– Eta organuluak egiteko, gominolak, erregaliza, espagetiak eta kakahuete-azalak.
Zitoplasma



Mitokondria
Nukleoa
Mitokondria
Aholku bat: animalia-zelulen marrazkiak bilatu ditzakezu Interneten, ikasi ez ditugun beste zenbait organuluren berri izateko (izena, itxura...), eta haiek bururatzen zaizkizun elikagai edo osagaiekin ereduan irudikatzeko.
21 U1
Mintz plasmatikoa
–
–
Mintz plasmatikoa
Zelulaz osatuta gaude
Zelulen tamainak
Gure gorputzaren zelulak oso-oso txikiak dira, eta, beraz, mikroskopioz baino ezin zaie behatu.
Zelulak neurtzeko, mikrometro edo mikra (μm) izeneko neurri-unitatea baliatzen da. Hauxe da mikra bat: milimetro bat zati mila egin ondoren gelditzen den zatitxoa. Zelula gehienek 1 eta 100 mikra inguru neurtzen dute luzeran: pentsa, hortaz, nolako txikiak diren!
Gure gorputzaren zelulak hamaika forma eta tamainatakoak dira. Eredu gisa, ondoko irudian ikusgai dituzu giza zelula mota batzuk, baita haietako bakoitzak gutxi gorabehera izaten duen tamainaren datua ere.
Zelulen formak

Irudian ikus dezakezunez, giza zelulak era askotakoak dira.
Zelula mota bakoitza funtzio jakin bat egiten espezializatuta dago, eta funtzio hori egoki egitea ahalbidetzen dion formakoa da. Esate baterako:
• Neuronak, nerbio-sistemaren zelulak, alegia, izar itxurakoak dira, eta luzakin asko dituzte, beste neurona batzuekin konexioak egin eta informazioa trukatzeko.
• Muskulu-zelulak, aldiz, luzangak dira. Muskuluak haiei esker mugi daitezke, uzkurtu baitaitezke.
• Organoak estaltzen dituzten zelulek kubo edo prisma forma izaten dute, eta elkarri oso lotuta egoten dira.
5 Begiratu arretaz irudiko giza zelulei, eta adierazi haietako zein den handiena eta zein txikiena.
6 Badira giza zelula batzuk, disko formakoak, hain zuzen, odolean oxigenoa garraiatzen dutenak. Erreparatu irudiari, eta esan zein diren.
7 Espermatozoideek zer funtzio egiten duten gogoratzen ez baduzu, ikertu. Gero, hausnartu: zure ustez, zergatik dute itxura hori?
Zenbait giza zelula mota
150 mikra (0,15 milimetro)
Espermatozoidea




Zelula epiteliala
Obulua Globulu gorriak
53 mikra (0,053 milimetro)
15 mikra (0,015 milimetro)
7 mikra (0,007 milimetro)
Muskulu-zelula
20 eta 500 mikra inguru (0,020-0,5 milimetro inguru)
Neurona



5 eta 100 mikra inguru (0,005-0,1 milimetro inguru)

22 2
Nire lanbidea: zitologoa

Kaixo, Igor dut izena, eta zitologoa naiz. Nire zeregina zelulak aztertzea da. Horretarako, hainbat motatako mikroskopioak erabiltzen ditut. Esaterako, mikroskopio optikoak eta elektronikoak. Lehenengoak bakunenak dira; eta, bigarrenak baliatzen ditut, zelulen barnealdea xehetasunez behatu nahi dudanean, irudiak izugarri handitzeko aukera ematen baitute. Alderatu bi argazkiak. Aurrenekoak organo bat estaltzen duten zelulak erakusten ditu, eta mikroskopio optiko batekin egin zen. Bigarrena, berriz, potentzia handiagoko mikroskopio batekin (elektronikoa) egin genuen, zelula baten organulu bat irudikatzeko.

1 Begiratu anayaharitza.es webgunean eskura duzun «Zelulen tamaina» baliabidea, eta esan zenbat milimetro diren 25 μ m.
2 Neurtu A argazkiaren azpialdeko lerroa erregela batekin. Neurri hori kontuan hartuta, kalkulatu zenbat neurtzen duen luzeran argazki horretan nabarmenduta dagoen zelulak. Gero, kalkulatu zelularen tamaina, mikratan eta milimetrotan. Neurtu beste bizpahiru zelula gehiago ere, eta kalkulatu zelula guztien batez besteko tamaina.

3 Orain, erreparatu B argazkiari: mikroskopio elektroniko batekin zelula baten barnealdeko organulu bati ateratako irudia da. Zehatzago esateko, organulu hori mitokondria bat da, zotz itxurako egitura bat. Baliatu argazkiaren azpialdeko eskala, eta kalkulatu, gutxi gorabehera, mitokondriaren tamaina.
Gogoan


Mota askotako zelulaz osatuta zaude, eta zelula mota bakoitzak berezko ezaugarriak ditu.

23 U1
hartu!
0,5
μm 5 μm zelula
Zelulek ehunak osatzen dituzte
Ehunak





Ehunak zeregin edo lan zehatz bat egiten duten zelula espezializatuen multzoak dira.
Gizakion gorputzean nagusi dira lau ehun mota hauek: ehun epiteliala, muskulu-ehuna, nerbio-ehuna eta odol-ehuna.
Ehunak antzeko zelulaz osatuta egon daitezke, hala nola muskuluehuna. Beste kasu batzuetan, aldiz, ehunak era askotako zelulen konbinazioaren emaitza dira; horixe gertatzen da, esaterako, odolehunarekin.
Ehun gehienek egitura solidoak osatzen dituzte; esaterako, hezur- eta nerbio-ehunek. Dena den, badira likidoak diren ehun batzuk ere. Odolehuna, hain zuzen, era horretakoa da.
Zenbait ehun mota
Ehun epiteliala


Elkarrekin itsatsita dauden prisma formako hainbat zelulaz osatuta dago. Gorputzaren kanpoaldea estaltzen du, baita haren barrunbeak ere (hala nola urdaila). Ehun epitelialaren zeregina gorputza kanpotik babestea da.
Nerbio-ehuna

Elkarrekin komunikatzeko hainbat luzakin dituzten izar itxurako zelulaz osatuta dago. Ehun horrek nerbiosistema osatzen du, eta estimuluak hauteman eta garraiatzeko, eta gorputz osora aginduak eramateko funtzioa betetzen du.
Muskulu-ehuna
Ildaskak dituzten hainbat zelula luzangaz osatuta dago (zelula horiek multzo trinkotan antolatuta daude). Ehun horrek muskuluak osatzen ditu. Uzkurtzeko gai direlako, muskulu-ehuneko zelulek egiten duten funtzio nagusia gorputza mugitzea da.
Odol-ehuna
Bi osagai ditu: era askotako zelulak eta plasma izeneko likido bat. Ehun horrek odola osatzen du, eta zelulak eta substantziak (hala nola mantenugaiak eta oxigenoa) banatzen ditu gorputz osoan.

24
3
Gure gorputzean hainbeste zelula izanik, ezinbestekoa da egoki antola daitezen, zereginak elkarren artean banatzeko.
Ehunen antzera mugituko gara!

Ariketa honetan, ikasi berri ditugun lau ehun motetako zelulak garela imajinatuko dugu. Irakurri jarraibideak, ehun bakoitzaren zelulak nola antolatuta dauden behar bezala ikasteko eta ikasgelan joko dibertigarri honetaz gozatzeko:
Ehunak osatzeko jarraibideak
1. Ikasgela lau taldetan banatuko dugu, ehun mota bakoitza osatzeko.
2. Talde bakoitzak egokitu zaion ehunari buruz ikertuko du. Ikasle bakoitzak ehun hori osatzen duen zelula bat marraztu eta margotuko du DIN A4 orri batean.
3. Taldeko kide bakoitzak egin duen marrazkia bere aurrean jarriko du.
4. Zelulak ehunean jarrita dauden antzera kokatuko zarete, ehunak imitatzeko. Adibidez:
– Ehun epiteliala osatzeko, elkarrengandik oso hurbil jarriko zarete.
– Odol-ehuna osatzeko, likido batean igerian ariko bazinate bezala mugituko zarete. Batzuk, globulu gorriak izango zarete, eta, beste batzuk, aldiz, globulu zuriak.
– Nerbio-ehuna osatzeko, elkarren ondoan besoak altxatuta jarriko zarete. Gero, eskuetako hatzak zabaldu eta ondoko ikaskidearen burutik hurbil ipiniko dituzue (ukitu gabe). Kate antzeko bat osatuko duzue.
5. Egokitu zaizuen ehunaren itxura imitatu ostean, gainerako ikaskideei labur azalduko diezue ehun hori zer funtzio egiteaz arduratzen den eta zer zelula mota dituen.
6. Nahi izanez gero, zelulen marrazkiak beste taldeetako kideekin trukatu ditzakezue, ikaskide guztiok lau ehunen antzera mugi zaitezten!
ehuN epitaliala osatzeN dugu
Nerbio-ehuNa osatzeN dugu
odol-ehuNa osatzeN dugu
Gogoan hartu!




Zer gerta liteke ehun batek oker funtzionatuko balu edo kaltetuta balego?

25 U1
Ehunek organoak osatzen dituzte



Auto batek hainbat egitura konplexu ditu: abiadura handitzeko, biratzeko, frenatzeko…
Zure gorputzak ere baditu era askotako funtzioak egiten dituzten egitura konplexu batzuk.
Organoak

Organoak ehunez osatutako gorputz-atalak dira, eta funtzio jakin bat egiten espezializatuak daude.
Esaterako, bihotzak odola ponpatzen du, giltzurrunek odola garbitzen dute, eta birikek gasak hartu eta kanporatzen dituzte.
Organo bakoitzak dagokion funtzioa egiteko egokiak diren forma eta tamaina ditu. Normalean, organoak era askotako ehunez osatuta daude; halere, badaude ehun mota bakarreko organo batzuk ere. Hala nola muskuluak, muskulu-ehunez soilik eratuta baitaude.




Hainbat organok barrunbeak dituzte: bihotzak, urdailak, hesteek… beste batzuk, berriz, zelulez beteta daude: pankrea, gibela eta abar.
Organo ugariren bi ale ditugu, eta haietako bakoitza gorputzaren alde banatan dago kokatuta. Horixe gertatzen da, besteak beste, birikekin, obulutegiekin eta begiekin.
Beste organo batzuk, aldiz, bakarrak dira; hala nola garuna, bihotza, urdaila, maskuria, etab.
1 Zer alde dituzte organoek eta ehunek?
2 Aipatu zer organo ditugun bikoiztuta gizakiok gorputzean.
3 Non daude gizakion zentzumen-organo gehienak: buruan, gorputz-enborrean edo gorputz- adarretan? Eta non daude nutrizioarekin lotutako organoak?

4 Pertsona bat parez pare dugunean, gorputzaren zer organo ikus ditzakegu begi hutsez?
5 Orri birakaria Zerrendatu giza gorputzaren hamar organo, eta sailkatu bakarrak diren edo bi ditugun kontuan hartuta.

Organoak ezin bitxiagoak dira!

Ezkerreko birika eskuinekoa baino txikiagoa dugu, bihotzarentzat lekua uzteko.
Eskuineko giltzurruna ezkerrekoa baino beheraxeago dugu.
Gure urdaileko azido sendoak metala ere disolba lezake. Garuna da gizakion organo guztietatik energiarik gehien
Heste meharra da gure organorik luzeena: 7 metro inguru ditu.
Belarriek ez diote hazteari uzten bizitza osoan zehar.
Gure gorputzaren hezurrik txikiena belarrian dago.
Gure bihotzak 100 000 taupada egiten ditu egunero.
Gure gorputzaren zatirik handiena muskuluz osatuta dago: 600 muskulu baino gehiago ditugu.
26
4
Ongi etorri «Zer organok pisatzen du gehien?» lehiaketara!
Imajinatu gure gorputzeko organoek lehiaketa batean parte hartzen dutela, guztietan gehien pisatzen duena saritzeko. Hona hemen heldu baten organo nagusien batez besteko pisuak. Ez ahaztu batez besteko datuak direla!
Lehen lehiakidea: gibela
Bigarren lehiakidea: birika
Hirugarren lehiakidea: giltzurruna
1 800 g
Laugarren lehiakidea:


Bosgarren lehiakidea: bihotza




150 g
Seigarren lehiakidea: gorputz osoko azala
1 500 g
1 Kalkulatu 65 kg-ko pertsona baten pisuaren zer ehuneko adierazten duen organo hauetako bakoitzak.
2 Irudikatu ehuneko horiek sektore-grafiko zirkular batean. Gainerako ehunekoaren sektoreari, % 100 osatu arte, izen hau jarriko diogu: «beste organo batzuk».
3 Grafikoan ageri diren organo guztiak kontuan hartuta, zeinek irabaziko luke «Zer organok pisatzen du gehien?» lehiaketa? Zeinek eskuratuko luke zilarrezko domina? Eta zeinek brontzezkoa?
4 Iragarpena Ariketa honetan landu ditugun datuak benetako organoen batez besteko pisuak dira. Bestela, organo bakoitzaren pisua pertsonaren araberakoa da. Zure ustez, zer alderdirekin dago lotuta pertsonen organoen pisua?

5 000 g








Gogoan hartu!
Organo bat «gaixotu» edo kaltetzen denean, behar bezala funtzionatzeari uzten dio.
27 U1
550 g
325 g
Organoek aparatuak eta sistemak osatzen dituzte
Zer gertatuko litzateke, auto baten bolantea maletategian jarriko bagenu? Eta gurpilak sabaian baleude? Gure
gorputzaren organoak ere modu jakin batean konektatuta daude, elkarri lagundu diezaioten.
Organo-aparatuak eta organo-sistemak


Organoek ez dute bakarka lan egiten, baizik eta koordinatuta funtzionatzen duten aparatu edo sistema deritzen multzoak osatzen dituzte, zeregin zehatzak egiteko.
Esate baterako, arnas aparatua osatzen duten organoek, hala nola, birikek, diafragmak, trakeak eta faringeak, koordinatuta lan egiten dute, arnasketa egiteko.
Giza gorputza nola dagoen antolatuta hobeto ulertzeko, «Berehala kontatuko dizut», webgunean: anayaharitza.es
Erlazio-funtzioa
Digestioaparatua

Nerbiosistema








Muskulu-sistema

Hezur-sistema
Ugalketa-funtzioa
Emakumezkoen ugalketa-aparatua
Gizonezkoen ugalketa-aparatua
Iraitz-aparatua
28
5
Giza gorputzaren aparatuak eta sistemak, eta bizi-funtzioak
Nutrizio-funtzioa egiteko
egiteko
egiteko
Zirkulazio-aparatua
Arnas aparatua
Gure gorputza «orekan» dago

Gure gorputzak bizi-funtzioak egiten ditu, hain zuzen, gizakion aparatu eta sistemek koordinatuta lan egiten dutelako.
Gure inguruaren baldintzak aldatzen direnean edo gorputzaren funtzionamenduak hala eskatzen duenean, gure gorputza erregulatu egiten da, orekan egoteko.
Kanpoan gertatzen diren aldaketei erantzun eta gure gorputza orekan egotea lortzeko, organo, sistema eta aparatuek zenbait ekintza egiten dituzte. Haiek egin ezean, gorputzak kalte larriak jasan litzake kasu batzuetan.
1 Bilatu hiztegian oreka terminoaren definizioa, eta azaldu zer esan nahi duen gure gorputza erregulatu egiten dela, orekan egoteko.
2 Jarri ikasliburukoa ez den beste adibide bat, aldaketa zehatz bat gertatzen denean, gure gorputza nola erregulatzen den azaltzeko.
Bero handia egiten duenean, gorputzaren tenperatura igo egiten da. Aldaketa hori guretzat arriskutsua izan daitekeenez, une horretan, azalak gorputzaren tenperatura igotzen ari dela jakinarazten dio garunari.
Informazio hori jasotzean, garunak seinale bat helarazten dio azalari, izerdia sortu dezan. Gure azala freskatu egiten da izerdia lurruntzean, eta, beraz, gorputzaren tenperatura jaitsi egiten da.
Begira nola pentsatzen dudan
Aparatuak atalez atal!




Erreparatu irudiari: giza gorputzaren hiru aparatu erakusten ditu. Ba al dakizu zein diren? Adierazi izenak.
Dakizunez, deskonposatzea eta kodifikatzea pentsamendu konputazionalaren estrategietako bi dira.
1 Jarri praktikan zure pentsamendu konputazionala. Ho rretarako, deskonposatu irudian ageri diren aparatuak.
2 Egin eskema bat irudiko aparatuak jasotzeko, eta esan zein diren eta zer funtzio dituzten.
Gogoan hartu!


Osasun ona izango badugu, beharrezko da gure aparatu eta sistema guztiek hutsik gabe funtzionatzea.

29 U1
Gure gorputza erregulatu egiten da
1 2
Z er ikasi dut?
1 Idatzi zure koadernoan zelularen definizioa.
2 Lotu termino hauetako bakoitza bizi-funtzio batekin:
a) Hondakin
b) Gameto





c) Estimulu

d) Mantenugai


3 Idatzi koadernoan izaki bizidunok ditugun lau osagai komun.
4 Marraztu oso bestelako forma duten bi giza zelula, eta adierazi zer funtzio egiten dituen haietako bakoitzak.
5 Giza zelulei dagokienez, non dago babestuta material genetikoa?
6 Azaldu pertsona batek dituen zelula guztiak forma berekoak diren ala ez. Eman arrazoiak.
7 Erreparatu irudiei, eta esan unitate honetan ikasi dituzun hiru gauza, gutxienez, haietako bakoitzari buruz:
10 Begiratu irudiei. Adierazi zer ehun mota erakusten duen bakoitzak, eta azaldu nolakoak diren ehun horiek osatzen dituzten zelulak.
8 «Ehun guzti-guztiak antzeko zelulaz osatuta daude». Adierazi esaldi hori zuzena ala okerra den, eta eman arrazoiak.
9 Nola esaten zaie funtzio zehatz bat egiten duten organo multzoei? Jarri multzo horien hiru adibide.
11 Irakurri adibide hau:


Korrika egitean, muskuluek oxigeno asko behar dute. Hori ikusita, garunak seinale bat bidaltzen du biriketara eta bihotzera, arnasketa eta taupada-abiadura bizkortzeko. Hala, muskuluetara odol gehiago heltzen da, oxigenoz aberastua gainera, eta, horri esker, behar bezala funtziona dezakete.
a) Zer aparatuk hartzen dute parte korrika egiten dugunean?
b) Azaldu zer onura dakarren aparatu horiek koordinatuta lan egiteak?
c) Zer gertatuko litzateke...? Zer gertatuko litzateke aparaturen batek behar bezala funtzionatzeari utziko balio?
Ez ahaztu unitate honetako zure argazki-albuma osatzea, webgunean: anayaharitza.es
Semaforoa. Margotu koadernoan, ariketa bakoitzaren ondoan, honela:
erantzuna badakizu
laguntza behar izan baduzu
erantzuna jakin ez baduzu
30 PORTFOLIOA
A B C D E
A
B
HELBURUA AURRERA
Gizakion zenbait «matxura» ikertuko ditugu, gure gorputzak nola funtzionatzen duen ulertzeko
1 Gizakiok izan ditzakegun «matxura» jakin batzuk aztertuko ditugu. Binaka, hautatu ondoko zerrendako «matxura» bat. Nahi izanez gero, zerrendan ez dagoen besteren bat ere aukeratu dezakezue.
2 Bakarka, kopiatu eta osatu Pentsatu - gogoko izan - ikertu antolatzaile grafiko hau, hautatu duzuen «matxurari» buruz ikertzeko eta gehiago jakiteko:
Zer dakizu «matxura» horren inguruan?
Zer sintoma eragiten ditu? Zer zelula, ehun edo organo motari eragiten die? Ba al dago tratamendurik, «matxura» hori «konpontzeko»?
Jada dakizuna kontuan hartuta, zer galdera bururatzen zaizkizu?
Zer jakin nahiko zenuke hautatu duzun «matxurari» buruz?

Bilatu informazioa, bururatu zaizkizun galdera horiei erantzuteko.
Aurkitzen duzun informazio interesgarria hemen idatzi.
3 Elkartu zure ikaskidearekin, eta alderatu zuen antolatzaile grafikoak eta ateratako ondorioak. Gero, idatzi azalpen labur bat, ikertu duzuen «matxura» nola gertatzen den eta hura «konpontzeko» zer egin behar dugun ezagutarazteko. Amaitzeko, egin aurkezpen bat gelan, gainerako ikaskideei zuen ikerketaren berri emateko (behar baduzue, erabili irudiak).
Asma


Tendinitisa
Orkatila bihurritzea
Gastroenteritisa


Polenak
alergiaeragindako
Miopia

1 Amaitu duzu ikasturte honetako lehen unitatea. Hausnartu koadernoan nola sentitu zaren egoera hauetako bakoitzean:
Ikasturtea hastean.
Kontzeptu berriak ikastean.
Zure lana eta ikastea antolatzean.
Talde-laneko zeregin eta ariketak egitean.
U1 31
N ola ikasi dut?
Ikertu Pentsatu
Gogoko
izan «MATXURAK» Erradioa haustea
2 Osasungarria da gure elikadura
Sinistu ezinik nago! Gure hip-hop dantza-taldeko dantzari titular hautatu naute. Hemendik aurrera, beraz, lehiaketa guztietan parte hartuko dut. Ai ama, pozez zoratzen nago! A zer urduritasuna!
Orain dantzari profesionala naizenez, entrenatzaileak elikadura era berezian zaintzeko aholkatu dit, txapelketen erritmoari eutsi ahal izateko. Bada, serio hartuko dut aholkua! Bihar bertan hasiko dudan plan ezin osasungarriago bat daukat, nire mailarik onena emateko.

Zer deritzozu?


Zer iruditzen zaizu Iraiaren plana?
Zure ustez, egingo dituen ekintzak
dantzari gisa maila hobetzeko baliagarriak izango zaizkio?
Erreparatu datuari. Zure ustez, gorputza behar bezala zaindu dezakegu
ekintza osasungarriak egun batez soilik eginda? Beharrezkoa iruditzen zaizu
kirolik egiten ez dutenek elikadura zaintzeko ohiturak izatea?
Zergatik?
Datua

Ohiturak maiz egiten ditugun eguneroko ekintzak dira. Ohiturek sekulako ondorioak izan ditzakete guregan epe luzera.
Helburua aurrera
Gure ohituren inguruan hausnartu, eta proposamen bat egingo dugu, haiek hobetu eta osasungarriagoak izan daitezen lortzeko.
Jarraitu hariari!
Nutriziofuntzioa eta
mantenugaiak
Unitate honetarako... 2
Elikagaiak eta haien sailkapena
1
Zertan datza
elikatzea?
Mantenugaiak nondik lortzen
ditugun ikasiko dugu
32
1. Egun osoan zehar fruta eta barazkiak soilik jatea. Elikagai osasungarriak besterik ez dira jan behar!
2. Zazpi ordu baino ez lo egitea. Hala, goizean bi orduko korrikaldia egiteko astia izango dut (ea aguantatzen dudan, ez baitut korrika egiteko ohiturarik…)!

3. Gero, indarberritzeko, freskagarri energetiko asko edatea.






33 3 Ohitura osasungarriak eta arnas aparatuaren funtzioa Arnasketa eta arnas aparatuaren osasun ona 5 Ohitura osasungarriak eta zirkulazioaparatuaren funtzioa Zirkulazioa eta zirkulazio-aparatuaren osasun ona 6 Ohitura osasungarriak eta iraitz-aparatuaren funtzioa Iraizpena eta iraitz-aparatuaren osasun ona 7 Nola izan dezakegu elikadura osasungarria? Dieta eta elikadura osasungarria 3 Digestioa eta digestio-aparatuaren osasun ona Ohitura osasungarriak eta digestioaparatuaren funtzioa 4
Zertan datza elikatzea?
Hip-hop musika dantzatzea bezalako jarduerak egiteko, gure gorputzak elikatzeko beharra du. Zorionez, gizakiok horretarako makineria biologiko aproposa dugu. Ezagutzen al duzu?
Nutrizio-funtzioa
Nutrizioa gizakiok hazteko, gure gorputzean ditugun kalteak osatzeko, eta eguneroko jarduerak egin ahal izateko behar ditugun materia eta energia lortzeko prozesuen multzoa da.
Nutrizio-funtzioak hiru prozesu hauek hartzen ditu barne:
• Mantenugaiak elikagaietatik eta arnasten dugun oxigenotik eskuratzea.
• Mantenugaiak eta oxigenoa zeluletara garraiatzea, behar bezala funtziona dezaten.
• Zelulek sortzen dituzten hondakinak eta karbono dioxidoa kanporatzea.
Ondoko irudiak gizakiaren nutrizio-funtzioa egiteko parte hartzen duten aparatuak erakusten ditu.
1 Orri birakaria Hiru ikasleko taldetan, kopiatu eskema hau orri batean, eta, gero, osatu, azpialdeko hitzak erabilita. Amaitutakoan, alderatu zuen eskema eta gainerako taldeek egin dituztenak.
.... ....
Digestioaparatua

Ahoa
Gibela
Heste lodia
Zirkulazioaparatua
Listuguruinak
Hestegorria
Urdaila Pankrea
Heste meharra
Arnas aparatua
Arnasbideak
Bihotza
Odol-hodien sarea
Zirkulazio-aparatua
Zelulak
Karbono dioxidoa ....
Digestioaparatua Arnas aparatua
Iraitzaparatua
Oxigenoa Hondakinak Mantenugaiak
Ureterrak


Birikak
Diafragma
Iraitzaparatua
Giltzurrunak
Uretra



Gernumaskuria

34
1
Mantenugaiak
Mantenugaiak elikagaietatik eskuratzen ditugun substantzia jakin batzuk dira, gure gorputzeko zelulek egoki funtzionatzeko behar dituzten materia eta energia ematen dizkigutenak, alegia.
Honako hauek dira elikagaien mantenugai nagusiak:
• Karbohidratoak edo azukreak. Zelulek energia eskuratzeko baliatzen dituzten «erregai» garrantzitsuenak dira.
• Lipidoak. Hainbat funtzio egiten dituzte. Batzuek, hala nola gantzek, energia ematen dute, eta energiagordekin gisa metatu daitezke. Beste batzuek, berriz, zelulen egitura zehatz batzuk eratzen dituzte, hala nola mintz plasmatikoa.


• Proteinak. Ezinbestekoak dira zelulen egiturak, ehunak eta organoak osatzeko. Horretaz gainera, zelulen jarduerak erregulatzen dituzte.
• Bitaminak eta mineralak. Zelulen funtzionamendu orokorra erregulatzeaz arduratzen dira.
• Ura. Zelulen osagai nagusia da. Ura funtsezkoa da zelulek egiten dituzten prozesu gehienak zitoplasman gertatzen direlako, ingurune urtarrean, alegia. Gainera, urari esker, era askotako substantziak garraia daitezke gorputzaren alde batetik bestera, baita beste mantenugai batzuk ere.
Mantenugaien funtzioak
Azukreak eta lipidoak energia ematen diguten mantenugaiak dira.
Proteinak eta lipidoak ezinbestekoak dira zelulak behar bezala eratzeko.
Bitaminak, proteinak eta mineralak gorputzaren funtzionamendua erregulatzen duten mantenugaiak dira.
2 Errepasatu mantenugaiei buruzko testua, eta osatu taula. Horretarako, adierazi gurutze baten bidez (X) haietako bakoitzak betetzen dituen funtzioak.
Funtzio eraikitzailea Funtzio energetikoa Funtzio erregulatzailea
Ura zeluletako prozesu guztiak gertatzen diren ingurunea da.
Proteinak
Lipidoak



Ura
Bitaminak
Mineralak

Karbohidratoak
Lau aparatuk hartzen dute parte mantenugaiak eskuratu eta prozesatzeko: digestio-, arnas, zirkulazioeta iraitz-aparatuek.
35 U2
Gogoan hartu!
Mantenugaiak nondik lortzen ditugun ikasiko dugu
Gizakiok
behar ditugun mantenugai gehienak elikagaietan daude. Baina... elikagai guztiek mantenugai berdinak ematen dizkigute?
Elikagaiak
Elikagaiak gure gorputzak behar bezala funtzionatzeko behar dituen mantenugaiak dituzten substantziak dira.
Elikagaiak mantenugai mota bakar batez osatuta egon daitezke, hala nola olioa, gantzez egina baitago; edo mota askotako mantenugaiz, hala nola lekaleak, proteinaz, karbohidratoz, bitaminaz eta gatz mineralez osatuta baitaude.
Elikagaien sailkapena
Elikagaiak hainbat eratan sailkatu daitezkeen arren, bi hauek dira gaur egun gehien erabiltzen diren sailkapen- irizpideak:
• Elikagaiaren osagai nagusiek egiten dituzten funtzioak.
• Elikagaien prozesatze-maila (NOVA sailkapena).
Osagaiek egiten dituzten funtzioak
Elikagaien mantenugaiek betetzen duten funtzioa kontuan hartuta, honako elikagai mota hauek bereizten dira:
• Elikagai energetikoak. Karbohidrato edo gantz askoko elikagaiak dira. Karbohidratotan aberatsak dira, besteak beste, zerealak, irina, pasta, ogia, patatak eta azukrea. Aldiz, gantzetan oparoak dira, esaterako, olioak eta gurina.
• Elikagai eraikitzaileak. Proteina askoko elikagaiak dira. Halakoak dira haragia, arraina, arrautzak, esnea, esnekiak eta lekaleak.
• Elikagai erregulatzaileak. Bitamina, mineral edo landare-zuntz askoko elikagaiak dira. Elikagai erregulatzaileen zeregin garrantzitsuenak gorputzaren funtzionamendu onari laguntzea eta gaixotasunak saihestea da. Fruta eta barazkiak dira mota horretako elikagaiak.
Elikagaiak sailkatuko ditugu
Paulok eta Zuriñek ez dakite eskolako jangelan gaur bazkaltzeko izango dituzten elikagai hauek energetikoak, eraikitzaileak edo erregulatzaileak diren. Lagunduko diezu elikagai bakoitza egoki sailkatzen?
Sagarra
Ura: 85,7 g
Proteinak: 0,3 g
Lipidoak: 0 g
Karbohidratoak: 12 g

Zuntza: 2 g
Haragi gorria
Ura: 62,3 g
Proteinak: 21 g


Lipidoak: 16,7 g


Karbohidratoak: 0 g
Zuntza: 0 g
Eskutada bat
fruitu lehor

Ura: 4,6 g
Proteinak: 22,9 g
Lipidoak: 54,1 g
Karbohidratoak: 7,9 g

Zuntza: 7,5 g
Ogia
Ura: 10 g
Proteinak: 15 g
Lipidoak: 2,5 g
Karbohidratoak: 70 g


Zuntza: 2,5 g
Jogurta
Ura: 87,9 g
Proteinak: 3,7 g
Lipidoak: 2,7 g
Karbohidratoak: 4,4 g

Zuntza: 0 g
Zerbak
Ura: 87,5 g
Proteinak: 2 g
Lipidoak: 0,4 g
Karbohidratoak: 4,5 g
Zuntza: 5,6 g
1 Sailkatu elikagaiak, haien osagaiei erreparatu ondoren. Arrazoitu zer taldetan jarri duzun elikagai bakoitza.
2 Elikagai hauetakoren bat talde batean baino gehiagotan egon liteke? Idatzi adibide bat, eta eman arrazoiak.
36
2
Elikagaien prozesatze-maila
NOVA sailkapenak lau taldetan banatzen ditu elikagaiak haien prozesatze-maila kontuan hartuta:
• 1. taldea. Prozesatu gabeko edo oso gutxi prozesatutako elikagaiek osatzen dute, hala nola haragiak, arrainak, esneak, jogurtek, irinek eta pastak.
• 2. taldea. Kozinatzeko (hala nola olioak), elikagaiak ontzeko (hala nola gatza, piperbeltza eta espezieak) eta gozatzeko (hala nola azukrea eta eztia) erabiltzen diren oinarrizko osagaiek osatzen dute.

• 3. taldea. Kontsumitzeko prest dauden elikagai prozesatuak hartzen ditu barne. Osagairen bat (hala nola gatza edo olioa) gehitu zaien 1. taldeko elikagaiak dira. Halaber, 3. taldekoak dira elikagai egosi eta hartzituak, ogia, edari batzuk, etab.
• 4. taldea. Asko prozesatutako elikagai eta edariek osatzen dute. Prozesu industrialen bidez egiten dira, eta gehigarriak, edulkoratzaileak, zaporea eta testura emateko substantziak eta antzeko osagai mordoa izaten dute.
Nahas-mahasa supermerkatuan

Supermerkatu honetako elikagaiak NOVA sailkapenari jarraikiz ordenatu dituzte. Dirudienez, gaur zabalduko dute denda, eta inor gutxik daki zer talderi dagokion apal bakoitza. Lagunduko al diezu?
1 Lotu apal bakoitza NOVA sailkapeneko talde batekin, eta eman arrazoiak.
2 Hiru elikagai hauek dagokien apalean jarri gabe utzi dituzte. Erantzun haiei buruzko galdera hauei:
a) Zein da osagai nagusia kasu bakoitzean?
b) Zer motatako elikagaiak dira haien funtzioa kontuan hartuta?
c) Zer apaletan jarriko zenituzke?
3 Erreparatu, lehenengo, elikagaiek dituzten osagai kopuruari eta, gero, haiei NOVA sailkapenean dagokien taldeari. Zer ondorio ateratzen duzu? Zer elikagaik ditu osagai gehiago? Eta zer elikagaik ditu gutxien?
Izokin-hanburgesak. Osagaiak: izokina, gatza, sojaren proteina, azidotasun-zuzentzailea, egonkortzailea, aroma, antioxidatzaileak eta koloragarriak.
NOVA sailkapen-sistemari eta elikagaien etiketatzeari buruz gehiago jakiteko, eskuragarri dituzu zenbait baliabide anayaharitza.es webgunean.
Izokin freskoa:
Osagaiak: izokina
Arrain-xerrak:




Osagaiak: izokina
eta gatza

Gogoan hartu!
Hamaika elikagai mota daude. Haiek ezagutzeak konbinazio osasungarriak egiteko aukera ematen digu.
37 U2
A
C
B
Nola izan dezakegu
elikadura osasungarria?
Elikadura ona izateko, elikagai osasungarriak noizbehinka jatea nahikoa dela iruditzen zaizu?
Dieta egokia izatea gure gorputza zaintzeko ohitura eraginkorra da.
Dieta



Gure beharrak asetzeko egokia den elikadura osasungarria izango badugu, arreta berezia jarri behar diogu egiten dugun dietari.
Dieta erregulartasunez kontsumitzen ditugun elikagai-errazioen multzoa da.
Errazio bat gutxi gorabeherako neurri bat da, otordu batean kontsumituko dugun elikagai jakin baten kantitateari dagokiona, alegia. Ondoko irudian, errazioak nola neurtzen diren erakusten duten adibide batzuk ikus ditzakezu.
Dieta eta elikadura osasungarria
Dieta osasungarria badugu, gure gorputzak behar duen mantenugai bakoitzaren kantitate egokia hartzen du.
Mantenugaien kantitate egokiak hainbat elikagaikonbinazioren bidez eskuratu ditzakegunez, dieta osasungarri mordoa dagoela esan dezakegu.
Edonola ere, dieta batek bete behar duen baldintza nagusia pertsona bakoitzaren beharrei erantzutea da. Behar horiek faktore askorekin lotuta daude.
Adibidez:



• Adina.
• Pisua eta altuera.
• Sexua.

• Zenbat ariketa fisiko eta buru-ariketa egiten den.
• Eskualde geografikoa edo urtaroa, behar diren mantenugaiak klimaren arabera aldatu baitaitezke. Esaterako, leku hotzetan, elikagai energetiko kantitate handiagoa behar izaten da.

• Egoera fisiko jakin batzuetan egotea, hala nola haurdunaldia, edoskitzaroa, gaixoaldia eta abar.
Errazioen adibide batzuk
Zopa-koilara baten edukia 20-30 mL ingurukoa da.
Edozein elikagairen apur batek (zatitxo batek, alegia), gurin apur batek, esaterako, 10 g inguru ditu.
Edalontzi baten edukia (ura edo esnea, esaterako) 200-250 mL ingurukoa da.

Ogi-xerra batek (3 hatzen zabalerako pusketak, alegia) 30 g inguru ditu.
Fruitu lehorren eskutada batek 20 g inguru ditu.
Ale bat.
Xerra bat.


1 Pisua galdu nahi dugunean, «dieta egin» behar dugula esan ohi dugu. Azaldu esapide hori zuzena iruditzen zaizun.
2 Demagun ezaugarri hauek dituzten bi pertsona ditugula: antzeko ariketa fisikoa egiten dute, hiri berean bizi eta adin eta sexu berekoak dira. Zure ustez, dieta osasungarri desberdinak izan ditzakete? Eman arrazoiak.
3 Adierazi atzoko afarian zer elikagai eta zer erraziotan hartu zenituen.
4 Bilatu dietetiko hitzaren esanahia. Zure ustez, zuzena al da zenbait elikagairen ezaugarri gisa dietetikoak direla esatea? Eman arrazoiak.
38
3
Nire lanbidea: nutrizionista

Kaixo, Maite dut izena, eta nutrizionista naiz. Nutrizionista bat nutrizioan, elikaduran eta giza dietetikan espezializatutako osasun-profesionala da. Nire zeregina era guztietako pertsonentzako dieta egokiak diseinatzea da.
Jende askok uste du dieta bat pisua galtzera bideratutako elikagaien konbinazio berezi bat dela. Baina uste okerra da hori! Izan ere, dieta egunero jaten ditugun elikagaiak dira. Guztiok egiten dugu dieta, beraz!
Egiten dugun dieta guretzat ahalik eta onena izatea da erronka, eta, horretarako, honako baldintza hauek bete behar ditu:
Nahikoa izan behar du; hau da, pertsona bakoitzaren energia-beharrak asetzeko aski, haren jarduera, pisua, adina eta abar kontuan hartuta.
Denetarik izan behar du; hau da, mantenugai mota guztiak kopuru egokietan hartu behar ditu barne.
Orekatua izan behar du; hau da, kalitate oneko askotariko elikagaiak eta NOVA sailkapeneko 1. taldekoak
hartu behar ditu barne.




Segurua izan behar du; hau da, kutsatzailerik edo substantzia toxikorik edo kantzerigenorik gabekoa.
Gustukoa izan behar du; hau da, elikagaiek gustura jateko modukoak izan behar dute.
Pertsonaren, gizartearen, kulturaren eta ingurunearen ezaugarrietara egokituta egon behar du.
Soziala eta eskuragarria izan behar du. Horrek esan nahi du gizarte-elkarreragina eta bizikidetza bultzatu behar dituela jateko jardueraren inguruan. Gainera, ekonomikoki bideragarria izan behar du, guztion eskura egon dadin.
Jasangarria izan behar du; hau da, kontuan hartu behar ditu elikagaiak ekoizteko behar den baliabide kopurua eta prozesu horretan egiten den gas kutsagarrien isuria. Horretaz gain, benetan jasangarria izango bada, kontsumituko diren lekutik gertu ekoitzitako elikagaiak hartu behar ditu barne (landare-elikagaiak batik bat eta haragi gutxi).
Lana prestatu Dieta osasungarri batek bete behar dituen baldintzak kontuan hartuta, lagunduko didazue nire lana egiten?
1 Dieta mediterraneoa aztertuko dugu. Taldetan, begiratu dieta horri buruzko baliabidea anayaharitza.es webgunean, eta adierazi goian jasotako baldintzak betetzen dituen. Horretarako, eman 1etik 5erako puntuazioa haietako bakoitzari.
2 Alderatu zuen puntuazioak eta gainerako taldeenak. Zer ondorio ateratzen dituzue? Zuen ustez, dieta mediterraneoa osasungarria da?
3 Orain, imajinatu egun bateko jatekoa prestatzeko ardura eman dizuetela etxean. Dieta mediterraneoaren ezaugarriak zein diren kontuan hartuta, pentsatu egun osorako menu bat. Ez ahaztu ohitura osasungarria bost otordu egitea dela. Erabili sormena, menua ahalik eta «mediterraneoena» izan dadin!
4 Ikertu zer den glutena eta zer elikagaitan aurkitu dezakegun. Zuen ustez, dieta mediterraneoa egokia da glutenarekiko jasanezintasuna duten pertsonentzat? Eman arrazoiak.
39 U2
Nola izan dezakegu elikadura osasungarria?
Dietari buruzko gomendioak



Era askotan irudika daitezke grafikoki bizimodu osasungarria izateko gomendioak. Dena den, bi grafiko mota hauek erabiltzen dira gehienbat: elikadura osasungarriaren piramidea eta elikagaien gurpil berria.
Elikadura osasungarriaren piramidea












Hiruki formako grafiko horrek bizimodu osasungarriaren ohiturak eta gehien komeni zaizkigun elikagai motak ezagutarazten dizkigu. Grafikoa ulertzeko, alderdi hauek izan behar dira kontuan:
Honelakoa da elikadura osasungarriaren piramidea
Noizean behin eta neurriz jateko elikagaiak
Egunero jateko elikagaiak
Bizimodu osasungarria izatea






Astean behin jateko elikagaiak







Esnekiak: 2-3 eguneko




Gainerako elikagaiak: < 3 eguneko
Barazkiak: 2-3 ale eguneko

Frutak: 3-4 ale eguneko


Egiten den ariketa fisikoaren arabera

Dieta osasungarriak zer diren hobeto ulertzeko, «Berehala kontatuko dizut», webgunean: anayaharitza.es
Triangeluaren erpinean, gutxitan eta kantitate txikitan jatea komeni den elikagaiak daude.
Eta azpiko mailetan, maiz jatea komeni den elikagaiak ageri dira.
Triangeluaren oinarrian, berriz, bizimodu osasungarria izateko hartu behar diren ohiturak irudikatzen dira.
40
3
Behar bezala hidratatzea
Modu osasungarrian kozinatzea
Ariketa fisikoa egitea
Elikagaien gurpila
Elikagaien gurpila grafiko zirkular bat da, eta gure eguneroko dietan hartu behar ditugun elikagaiak erakusten ditu, haien proportzio egokiak adierazita. Gaur egun, gurpilak sei talde ditu, baina aldiro berraztertzen dute, nutrizioaren arloan egindako aurkikuntza berrietara egokitzeko.
Sektoreen koloreak Elikagai taldeak
I, II Energetikoa
Funtzioak II. taldea. Olioak eta gantzak (hala nola gurina) hartzen ditu barne. Lipido askoko elikagaiak dira, eta funtzio energetikoa dute.














III, IV Eraikitzailea
V, VI Erregulatzailea


I. taldea. Zerealak, haietatik datozen elikagaiak (hala nola ogia eta pasta), patatak eta azukrea hartzen ditu barne. Karbohidrato askoko elikagaiak dira, eta funtzio energetikoa dute.
VI. taldea. Fruta freskoak hartzen ditu barne. Gatz mineral eta bitamina askoko elikagaiak dira, eta funtzio erregulatzailea dute.













5 Alderatu elikadura osasungarriaren piramidea eta elikagaien gurpila. Dakizunez, grafiko bakoitzak informazio mota desberdina ematen du. Zein? Bestalde, zertan dira berdinak bi grafikoak?
6 Bi grafiko horiek kontuan hartuta, asmatu aste baterako menu osasungarri bat. Ez ahaztu bost otordu egin behar ditugula egunero: gosaria, hamaiketakoa, bazkaria, askaria eta afaria.






III. taldea. Haragia, arraina, lekaleak, fruitu lehorrak eta arrautzak hartzen ditu barne. Proteina askoko elikagaiak dira, eta funtzio eraikitzailea dute.
IV. taldea. Esnea eta esnekiak (hala nola gazta) hartzen ditu barne. Proteina askoko elikagaiak dira, funtzio eraikitzailea dute.
V. taldea. Barazkiak hartzen ditu barne. Gatz mineral eta bitamina askoko elikagaiak dira, eta funtzio erregulatzailea dute.
7 Imajinatu elikadura osasungarriaren piramidearen eta elikagaien gurpilaren gomendioak laburbildu behar dituzula, sei urteko haur bati haien berri emateko. Zer bost aholku emango zenizkioke?
Dieta egokia egiteko, jarraitzen errazak diren aholku batzuk izan ditzakegu kontuan. Dena den, pertsona bakoitzak berezko behar batzuk ere izan ditzake.
41 U2
Gogoan hartu!
Digestioa eta digestioaparatuaren osasun ona
Digestioari esker, elikagaiak zati txikiagotan deskonposatzen dira, mantenugaitan, alegia. Gogoratzen duzu nola egiten duen prozesu hori zure gorputzak?
Digestio-aparatuaren funtzionamendua ulertzen badugu, errazagoa izango zaigu elikadura osasungarriaren alde egitea. Izan ere, egoki elikatuta, digestioaparatuaren funtzionamenduarekin lotutako hainbat gaixotasun eta arrisku saihestu ditzakegu.
Digestio-aparatua eta digestioa

Aurreko urteetan ikasi zenuenez, digestio-aparatua jaten ditugun elikagaietatik behar ditugun mantenugaiak eskuratzeaz arduratzen diren organoen multzoa da.
Xede horretarako, hiru prozesu egiten ditu: elikagaiak digeritu, mantenugaiak xurgatu eta hondakinak kanporatzen ditu.
Digestio izeneko prozesuaren bidez, elikagaiak mantenugai bihurtzen dira; gero, mantenugai horiek xurgatu eta odolera igarotzen dira. Prozesuan sortutako hondakinak gorputzetik kanporatzen dira.
Gizakion digestio-aparatuak elikagaiek dituzten substantzia gehien-gehienak xurgatzen ditu. Horrek esan nahi du, mantenugaiak ez ezik, gehigarriak, sendagaiak, drogak eta substantzia toxikoak (hala nola alkohola) ere xurgatzen dituela.
Digestioa, urratsez urrats





Ahoan, hortzek birrindutako elikagaiak listuarekin nahasten dira, eta elikadura-boloa sortzen da. Ahotik behera, elikagaiak hestegorritik igarotzen dira, urdailera iritsi arte.
Urdailean, elikadura-boloa urin gastrikoekin nahastu eta kimo izeneko ahi moduko bat bihurtzen da. Kimoa heste meharrera igarotzen da gero.

Heste meharrean, gibelak behazuna isurtzen du, eta pankreak urinak. Bi isurkari horiek elikagaiak digeritzen
izeneko beste ahi bat da.
1 Eman arrazoiak, esaldi hau zuzena ala okerra den azaltzeko: «Digestio-aparatuak elikagaiak eraldatu eta haien osagai onuragarri eta elikagarriak soilik xurgatzen ditu».
2 Adierazi digestio-aparatuaren zer ataletan gertatzen diren digestioaren urrats hauek: kimoa sortzea, xurgapena eta gorozkiak eratzea.
Digestio-aparatuaren egitura anayaharitza.es webgunean duzu zehatzago azalduta.

Digestioaren bidez eskuratutako mantenugaiak odolera igarotzen dira hestearen hormetan zehar. Prozesu horri xurgapen deritzo.
Heste lodiak ura, gatz mineralak eta zenbait bitamina xurgatzen ditu. Xurgatzen ez diren hondakinak gorozki bihurtzen dira, gero uzkiaren bidez kanporatuko direnak.
42
4
1 3 5 2 4
Digestio-aparatua zaintzeko aholku batzuk
Gure digestio-aparatuak osasun ona izan dezan, komenigarria da ohitura hauek hartzea:
• Elikadura orekatua izatea, mantenugaien beharrezko kantitateak hartu ditzagun. Fruta eta barazkiak egunero jan behar dira.
• Jaten ditugun elikagaiek landare-zuntzetan aberatsak izan behar dute, heste-igarotzeari laguntzeko.
• Astiro jatea, elikagaiak behar bezala mastekatuz.
• Hartzen ditugun elikagaiak lauzpabost otordutan banatzea, eta, ahal dela, egunero ordu berdinetan jatea. Afaldu ondoren, pare bat ordu itxarotea komeni da lotara joan aurretik.
• Behar dena baino gehiago ez jatea, digestioa arina izan dadin. Neurriz hartu beharrekoak dira gatza, txokolatea, saltsa minak, kafea eta edari karbonatatuak, digestio-aparatua kaltetu baitezakete.



• Jaten ditugun elikagaiak garbitzea, eta jan aurretik eta ondoren eskuak garbitzea, gaixotasun infekziosorik edo intoxikaziorik izan ez dezagun.
• Hortzak egoki garbitzea, txantxarrik ez sortzeko. Horretarako, otordu bakoitzaren ostean eskuilaz garbitu behar ditugu hortzak.
Begira nola pentsatzen dudan
Hortzen higienea «programatuz»

Hortzak behar bezala garbitu behar ditugu otordu bakoitzaren ondoren. Ohitura osasungarri hori egoki egiten duzun ikusteko modu dibertigarri bat pentsamendu konputazionalaren tekniketako bat baliatzea da: algoritmoak sortzea, alegia. Hala, hortzak nola garbitzen dituzun xehetasunez aztertuko duzu, eta oker egiten dituzun urratsez jabetuko zara.
Imajinatu etxeko sofan eserita zaudela, eta, egunero egiten duzun moduan, komunera joan behar duzula hortzak garbitzera. Idatzi, urratsez urrats, sofatik altxatzen zarenetik prozesua amaitu arte egiten dituzun ekintza guztiak.
Amaitutakoan, begiratu «Hortzen higienea, urratsez urrats» baliabidea, anayaharitza.es webgunean, eta egiaztatu hortzak egoki garbitzen dituzun. Aldatu algoritmoan aurrerantzean kontuan hartu behar dituzun alderdiak.
1. Sofatik altxatzen naiz.
2. Bi urrats egiten ditut aurrera.

3. Ezkerrera biratu eta zazpi urrats egiten ditut gelako ateraino.
4. Eskuinera biratu eta zortzi urrats egiten ditut komuneko ateraino.
5. Osatu algoritmoa, egiten dituzun gainerako urrats guztiekin.
3 Idatzi testu bat, irudiak erakusten duen aholkua azaltzeko, eta arrazoitu zergatik den garrantzitsua ohitura hori digestioaparatuaren osasun onerako.
Gogoan hartu!




Ziur egunero egiten dituzula zure digestio-aparatuari mesede egiten dioten ekintzak. Zein, adibidez?


43 U2
Arnasketa eta arnas aparatuaren
Oxigenoa



osasun ona

Gizakion gorputza egoki oxigenatuta dagoenean, energia gehiago izaten dugu, eta gure garunak hobeto egiten du lan. Arnasketa behar bezala egiteko, lagungarria da arnas aparatuak nola funtzionatzen duen jakitea eta zenbait ohitura osasungarri barneratzea.
Arnas aparatua eta arnasketa
Dakizunez, arnas aparatua arnasketa egiteaz arduratzen diren organoen multzoa da.
Arnasketa izeneko prozesuaren bidez gure gorputzak oxigenoa (O 2) hartzen du airetik, biriketara eraman eta zeluletan hondakin gisa eratzen den karbono dioxidoa (CO 2) kanporatzen du.
Irudian ikus daitekeen moduan, prozesuak hiru fase ditu:
Arnasketa, urratsez urrats
O2 asko duen airea sartzen da
Arnas aparatuaren egitura nolakoa den zehatz-mehatz gogoratzeko, balibide bat duzu anayaharitza.es webgunean.

Gas-trukea Arnasbehera
O2-a sartzen da
O2 asko duen odola
O2-a

CO2-a ateratzen da
CO2 asko duen odola
CO2 asko duen airea ateratzen da
Diafragma Diafragma
Diafragma uzkurtu eta jaitsi egiten da, eta birikak dilatatu, leku gehiago dutelako. Hori egitean, birikak xurgagailuen antzerakoak dira, sudur-hobietatik sartu eta arnasbideetatik haietara heltzen den airez puzten baitira.
Aire arnastu berria oxigenotan oparoa da. Oxigeno horren zati bat odolera igarotzen da albeoloetako hormetan zehar. Aldi berean, karbono dioxido asko duen odolak hondakin gisa sortu den gas horren zati bat albeoloetako airera isurtzen du.
Gas-trukearen ondoren, albeoloetako aireak oxigenoa galtzen du, eta karbono dioxidoz betetzen da. Diafragma erlaxatu eta igo egiten da, birikak uzkurtu, eta airea arnasbideetatik igaroz kanporatzen da.

44
5
oso substantzia berezia da… gas bat da! Gizakiok ba al dugu modurik gas hori «jateko»?
2 3
Arnas aparatua zaintzeko aholku batzuk
Gure arnas aparatuaren osasuna zaintzeko, gomendagarria da ohitura hauek hartzea:
• Arnasa sudurretik hartzea, sudur-hobietan airea berotu eta hezetu egiten baita biriketara sartu aurretik.
• Ariketa fisikoa egunero egitea, biriken arnasketa-gaitasuna hobetzeko.
• Giro kutsatuak saihestea. Denbora luzez egoten garen lekuak behar bezala aireztatu behar ditugu.
• Neguan, bufandak edo antzeko jantziak janztea, arnasbideetan sartzen den airea oso hotza egon ez dadin; izan ere, aire hotzak zaurgarriago egiten gaitu arnas germenen aurrean.
• Ahoa eta sudurra estaltzea doministiku edo eztul egitean, agente patogenoak noranahi ez zabaltzeko.
• Maskara janztea, batetik, inguruan ke edo hauts gehiegi badago, eta, bestetik, gaixotasun zehatzen epidemia- edo pandemia-garaietan, jende asko biltzen den lekuetan bagaude.
• Eta garrantzitsuena, tabakoaren kea saihestea. Erretzea gure arnas aparatua neurrigabe kaltetzen duen ohitura da.
Ohitura kaltegarri bat
Erretzea ezin kaltegarriagoa dela dakigun arren, oso zabalduta dago oraindik ohitura hori.
Tabakoak zer kalte eragiten dituen ikasi ondoren, kanpaina bat egingo dugu, gazteei ez dutela ohitura hori hartu behar ulertarazteko.
1 Taldeka, begiratu anayaharitza.es webgunean eskuragarri duzuen «Tabakoa, osasunerako arrisku handi bat» baliabidea, eta idatzi ohar batzuk.
2 Bildu duzuen informazio guztia baliatuta, egin sei aurpegiko liburuxka bat:


Aurpegi honetan, liburuxkaren azala egongo da. Bertan, idatzi erretzeari uzteari buruzko eslogan bat, eta egin horrekin lotutako marrazki bat.
Hemen, jaso tabakoarekiko mendekotasunari buruzko informazioa.
Tabakoaren keak dituen osagaiak eta hura arnasteak dakartzan ondorioak.
Tabakoarekiko mendekotasunari lotutako arnas gaixotasunak.
1 Idatzi testu bat, irudiak erakusten duen aholkua azaltzeko, eta arrazoitu zergatik den garrantzitsua ohitura hori arnas aparatuaren osasun onerako.
Gogoan hartu!




Tabakoarekiko mendekotasunari lotutako beste gaixotasun batzuk.
Erretzen hasteko tentazioari eusteko zenbait aholku.
Arnas aparatuari esker, oxigenoa hartu eta karbono dioxidoa kanporatu ditzakegu uneoro gure bizitzan. Zaindu dezagun, bada!

45 U2
Zirkulazioa eta zirkulazioaparatuaren osasun ona
Zirkulazio-aparatua eta zirkulazioa
Zirkulazio-aparatua gorputz osoan zehar mantenugaiak banatu eta hondakinak jasotzen dituen zirkuitua da. Zer gertatuko litzateke zirkuitu hori buxatu edo haren motorra, bihotza, alegia, matxuratuko balitz? Zirkulazioak nola funtzionatzen duen ikasteak arazo horiek saihesteko ohitura osasungarriak hartzen lagunduko digu.
Odol-zirkulazioa
Odol-zirkulazioa odolak bihotzetik ateratzen denetik bertara itzultzen den arte egiten duen ibilbide zirkularra da.
Gizakion odol-zirkulazioa bikoitza da; hau da, bi ibilbide egiten ditu: bata, biriketan eta, bestea, gorputz osoan zehar.
1 Biriketako odol-zirkulazioa: bihotza eta birikak lotzen ditu. Ibilbide horretan, odola karbono dioxidoz beteta ateratzen da bihotzetik eta, biriketara heltzean, hura askatu eta oxigenoz betetzen da. Gero, bihotzera itzultzen da berriz.
2 Odol-zirkulazio orokorra: bihotza eta gorputzeko gainerako organoak lotzen ditu. Hauek dira haren zereginak: mantenugaiak eta oxigenoa gorputz osora eramatea, eta zeluletako hondakinak eta karbono dioxidoa jasotzea.
Bihotz-taupadak dira odola odol-hodietan barrena bultzatzen dutenak. Hain zuzen, etengabeko mugimendu erritmikoak dira taupadak, bihotzaren horma gihartsuak uzkurtu eta erlaxatzean gertatzen direnak.
1 Azaldu, zure hitzak erabilita, zer funtzio egiten duen bihotzak zirkulazio-aparatuan.
2 Arteriek oxigenorik gabeko odola garraia dezakete? Eman arrazoiak.

Odol-zirkulazioa


1 Biriketako zirkulazioaren irudikapena
Zirkulazio-aparatuaren egitura nolakoa den zehatzmehatz gogoratzeko, baliabide bat duzu anayaharitza. es webgunean.
3 Kapilarrak dira giza gorputzaren odol-hodirik txikienak. Haien hormak mehe-meheak dira. Zure ustez, zergatik dira horrelakoak?

46
6
Gure zelulek mantenugaiak behar dituzte, egoki funtzionatuko badute. Gogoratzen duzu nola banatzen diren gorputz osoan?
2 Gorputz osoko zirkulazioaren irudikapena
Zaina
Arteria
Arteria
Birikak Zaina
Zirkulazio-aparatua zaintzeko aholku batzuk
Gure zirkulazio-aparatuak osasun ona izan dezan, komenigarria da ohitura hauek hartzea:
• Neurrizko ariketa fisikoa egitea egunero. Bihotzeko hormak muskuluz eratuta daude, eta muskulu horiek entrenatu eta indartsu mantendu behar dira.
• Elikadura orekatua eta askotarikoa izatea. Koipe eta azukre ugariko elikagaien kontsumoa murriztu behar dugu, bihotzaren eta odol-hodien osasun onerako kaltegarriak baitira.
• Ezinbestekoa da ura edatea. Gogoratu gure odolak ur kantitate handia duela.
• Gure ezaugarri fisikoen eta jardueraren araberako pisu egokia izatea. Gehiegizko pisua izatea kaltegarria da bihotzarentzat.
• Tabakorik ez erretzea eta alkoholik ez edatea. Arnasten eta edaten ditugun substantzia toxikoak odolera igarotzen dira, eta odolhodiak eta bihotza larri kaltetzen dituzte.


• Estres-egoerak saihestea eta behar bezala lo egitea.
Bihotza lanean jarriko dugu



Zientziaren ikuspegitik erreparatuko diogu bihotzaren osasunari eta ariketa fisikoari. Jarri binaka, eta prestatu ariketa pixka bat egiteko!
Lehenengo eta behin, eskatu zure kideari aulki batean esertzeko, eta ahalik eta lasaien egoteko, pultsua hartuko baitiozu. Horretarako, jarri hatz erakuslea eta luzea kidearen lepoaren albo batean, eta egin presioa taupada erritmikoak sumatu arte. Kontatu minutu bateko taupada kopurua. Ondoren, eskatu kideari 20 kokorikatze egiteko, eta kontatu berriro minutu bateko taupada kopurua. Trukatu zereginak, eta egin berriz neurketak.
1) Zer sentitu duzu ikaskidearen bihotz-taupada bakoitzean?
2) Nolakoa da bihotz-taupaden erritmoa ariketa fisikoa egin ondoren: motelagoa ala bizkorragoa?
3) Zuen ustez, zergatik aldatzen da bihotz-taupaden erritmoa ariketa egitean?
4) Ikasi duzun moduan, bihotzaren hormak muskuluz eginak daude, bihotz-muskuluz, alegia. Hori horrela, zer gertatuko zaio bihotzmuskuluari, ariketa fisikoa egiten badugu?

4 Idatzi testu bat, irudiak zer erakusten duen aholkua azaltzeko, eta arrazoitu zergatik den garrantzitsua ohitura hori zirkulazio-aparatuaren osasun onerako.
Gure zirkulazio-aparatuak atsedenik gabe funtzionatzen du bizitza osoan zehar, eta egoera onean egon dadin lagundu diezaiokegu.
47 U2
Gogoan hartu!
Iraizpena eta iraitzaparatuaren osasun ona
Gure organoek hondakinak sortzen dituzte funtzionatzean, eta haiek neurrigabe pilatzea kaltegarria izan daiteke guretzat. Ba al dakizu nola kanporatzen ditugun?
Iraizpenaren mekanismoak ezagutzeak gure gorputzean hondakinak pilatzearekin lotutako arazoak saihesten lagunduko digu, baita iraitz-funtzioak erraztuko dituzten ohiturak hartzen ere.
Iraizpen deritzon funtzioari esker, gure gorputzak nutrizioprozesua egitean sortzen dituen hondakinak kanporatzen ditu.
Iraitz-aparatua eta iraizpena
Iraitz-aparatua zelulek sortutako hondakinak kanporatzeaz arduratzen diren organoen multzoa da. Hondakin horiek gure odolean daude.
Honako hauek dira iraizpenaren fase nagusiak:
Nola sortzen da gernua?
Giltzurrunak odol «zikina» iragazi eta gernua sortzen du.
Gogoratu gure gorputzak hondakinak kanporatzeko beste sistema batzuk ere badituela. Esaterako, azalean dauden izerdi- guruinek izerdiaren bidez kanporatzen dituzte substantziak. Digestioaparatuak digestioan sortzen diren hondakinak gorozkien bidez kanporatzen ditu. Eta arnas aparatuak karbono dioxidoa kanporatzen du.
Ureterra


Gernua uretraren



Iraitz-aparatuaren egitura anayaharitza.es webgunean duzu zehatzago azalduta.
1 Zerrendatu giza gorputzaren hondakinak, eta adierazi zer aparatu edo organo arduratzen den haietako bakoitza kanporatzeaz.
2 Idatzi zerrenda batean giza gorputzak uraren irazpena egiteko dituen modu guztietatik ezagutzen dituzunak. Ikertu prozesu horietakoren batek, gorputzean soberan dagoen ura kanporatzeaz gain, ba ote duen beste lako funtziorik.
48
7
2 5
1 Gorputz osoan zehar hondakinak jasotzen aritu den odola giltzurrunetan sartzen da.
3 Odol garbia giltzurrunetik ateratzen da.
bidez kanporatzen da gorputzetik.
4 Gernuak ureterretan barrena zirkulatu eta gernu-maskurian biltegiratzen da.
Iraitz-aparatua zaintzeko aholku batzuk
Gure iraitz-aparatuaren osasuna zaintzeko, gomendagarria da ohitura hauek hartzea:
• Likido ugari edatea, eta, ahal dela, ura izan dadila. Hala, ez dugu gernu oso kontzentratua sortuko, ezta kalkulurik (harriak giltzurrunetan edo gernu-maskurian) edo infekziorik izango ere.
• Gorputza behar bezala garbitzea. Ohitura horri esker, gernumaskuriko infekzioak izateko aukerak gutxituko ditugu.

• Tabakorik ez erretzea, alkoholik ez edatea eta produktu kutsatzaileen eraginpean ez jartzea.


• Medikuek agindu gabe sendagairik ez hartzea, mina kentzeko, esaterako. Botiketan errezetarik gabe saltzen dituzten analgesiko gehiegi hartzeak giltzurrunak kaltetzen ditu.
• Gernuari behar baino gehiago eustea. Gernu-maskuria gehiegi betetzen bada, eta hustu gabe denbora gehiegi ematen badugu, infekzioak edo kalteak izan ditzakegu.
3 Idatzi testu bat, irudiak erakusten duen aholkua azaltzeko, eta arrazoitu zergatik den garrantzitsua ohitura hori iraitzaparatuaren osasun onerako.
Iraizpenean, gernuaren eta izerdiaren bidez, ura kanporatzen dugu gorputzetik. Horrexegatik da hain garrantzitsua nahikoa ur edatea.
Konturatzen ez garen arren, elikagaiak hartzen ditugunean, ura ere «edaten» dugu. Erreparatu ondoko taulari: zenbait elikagairen ur kantitateak jasotzen ditu.
1 Ordenatu zure koadernoan taulako elikagaiak haien ur kantitatea kontuan hartuta. Gero, erantzun galdera hauei:
a) Zer motatako elikagaiek dute ur kantitate handiena?
b) Zer motatako elikagaiek dute ur kantitate txikiena?
c) Zure ustez, zergatik da hori horrela?
2 Azaldu zer esan nahi duen angurri batek 95 mL ur dituela elikagaiaren 100 gr-ko. Orduan, zenbat ur «edango» duzu, 300 g angurri jaten badituzu? Eta kilo bateko angurri bat janez gero?
3 Multzokatu taulako elikagaiak, NOVA sailkapenari jarraikiz, eta alderatu haien ur kantitateak.
4 Zure ustez, prozesatu gabeko edo oso gutxi prozesatutako elikagaiak hartzea onuragarria izan daiteke zure iraitzaparatuarentzat? Eman arrazoiak.
Gogoan





hartu!

49 U2
Ura «edateko» beste zenbait modu
Mantenugaiak hartzea bezain garrantzitsua da hondakinak kanporatzea. Zorionez, funtzio hori zaintzeko lagungarriak diren ohiturak ezagutzen ditugu! Elikagaia Zenbat mL ur dauden elikagaiaren 100 g-tan Angurria 95 mL Ogia 35 mL Luzokerra 92 mL Laranja 86 mL Esnea 95 mL Galletak 9 mL Gazta ondua 39 mL Opil industriala 15 mL Oilaskoa 70 mL Latako sardinak 60 mL
Z er ikasi dut?
1 Adierazi zer hiru prozesu hartzen dituen barne nutrizio-funtzioak.
2 Zerrendatu nutrizio-funtzioa egiteko parte hartzen duten aparatuak.
3 Azaldu zertan diren desberdinak mantenugai eta elikagai kontzeptuak. Gero, jarri haietako bakoitzaren bi adibide.
4 Esan zein den hitz arrotza multzo bakoitzean, eta arrazoitu zergatik hautatu duzun hitz hori kasu bakoitzean.
a) Bitaminak, ura, gurina, karbohidratoak, proteinak.
b) Giltzurruna, ureterra, gernu-maskuria, nefrona, albeoloa, uretra.
c) Urdaila, hestegorria, heste meharra, birika, gibela.
5 Esan elikagai hauek energetikoak, eraikitzaileak edo erregulatzaileak diren. Kontuan hartu elikagaietako batzuk talde batean baino gehiagotan egon daitezkeela:

Ogia, letxuga, arrautza, patata, gazta, mandarina.
6 Osatu zirkulazio-aparatuaren funtzioei buruzko esaldi hau:
Hauek dira zirkulazio-aparatuaren zereginak: ... eta ... gorputz osoko zeluletara eramatea, eta zeluletako ... eta ... jasotzea.
7 Esan non gertatzen diren nutrizioaren prozesu hauek, eta azaldu zertan diren.
a) Mantenugaiak xurgatzea.
b) Oxigenoa hartzea.
c) Gernua sortzea.
d) Karbono dioxidoa kanporatzea.
8 Adierazi esaldi hauek zuzenak ala okerrak diren, eta zuzendu oker daudenak:
a) Arnasbeheran, airea biriketan sartzen da.
b) Mantenugai gehien-gehienak hestean xurgatzen dira.
c) Iraitz-aparatuak odolaren hondakin guztiak kanporatzen ditu, karbono dioxidoa barne.
9 Azaldu zergatik diren garrantzitsuak ekintza hauek:
a) Elikagaiak ukitu aurretik, eskuak garbitzea.
b) Astiro jatea, elikagaiak behar bezala mastekatuz.
c) Egunean zehar ur asko edatea.




10 Erreparatu irudiei, eta adierazi zer ohitura osasungarri erakusten dituzten. Lotu ohitura bakoitza dagokion aparatuarekin (aparatu bat baino gehiago izan daitezke).
11 Unitatean, nutrizio-funtzioa egiten duten aparatuak zaintzeko hainbat ohitura osasungarri ikasi dituzu. Irakurri berriz, eta idatzi gutxienez bi aparaturen osasun onari laguntzen dioten ohiturak. Gero, hautatu bost ohitura esanguratsuenak, eta egin zerrenda bat, garrantziaren arabera ordenatuta, zure nutrizio-funtzioaren osasuna nola zaindu behar duzun ez ahazteko.
12 Unitate honetan, behin baino gehiagotan aipatu dugu alkohola saihestu beharreko substantzia dela, oso kaltegarria delako. Bilatu informazioa, eta azaldu labur zer kalte eragin ditzakeen alkohola edateak.
Ez ahaztu unitate honetako zure argazki-albuma osatzea, webgunean: anayaharitza.es
Semaforoa. Margotu koadernoan, ariketa bakoitzaren ondoan, honela:
erantzuna badakizu
laguntza behar izan baduzu

erantzuna jakin ez baduzu

50 PORTFOLIOA
A B C D
HELBURUA AURRERA
Gure ohituren inguruan hausnartu eta haiek hobetzeko proposamen bat egingo dugu
Gure nutrizio-funtzioa zaintzeko ohiturak nola hobetu ditzakegun aztertuko dugu. Horretarako, egin urrats hauek:
1 Kopiatu eta osatu antolatzaile grafiko hau, ispiluaren teknika aplikatuta, zure ohiturak eta unitate honetan ikasi dituzunak alderatzeko. Ez kezkatu ikasliburuko ohiturak eta zureak bete-betean bat ez badatoz. Hain zuzen, hori da normalena!
Ohitura osasungarri idealak
Zure ohiturak eta ikasi dituzunak alderatuta, zein dira desberdinak?
Zure ohiturak eta ikasi dituzunak alderatuta, zein dira antzekoak edo berdinak?

Eguneroko bizitzako ohiturak
Eguneroko bizitzako ohiturak eta ikasi dituzunak alderatuta, zein dira desberdinak?
2 Erreparatu ohitura idealen eta zure ohituren arteko aldeei. Bururatzen al zaizu zure ohiturak hobetzeko egin dezakezun ekintza errazik? Idatzi zure ohiturak hobetzeko proposamen bat bost ekintzarekin, gutxienez. Saiatu proposamen errealista bat egiten, benetan egin ditzakezun ekintzak idatzita.


3 Ikasgelan, irakurri berriz Iraiak unitate hasieran adierazitako plana. Zer aholku emango zenizkiokete orain, gorputza egoki zaindu eta dantzari gisa maila ona emateko?
N ola ikasi dut?
1 Kopiatu koadernoan ondoko taula, eta ipini esaldi bakoitzari 1etik 5erako puntuazioa. Kontuan hartu 1 jartzeak esaldiarekin ez zaudela batere konforme adierazten duela, eta 5 jartzeak, berriz, esaldiarekin bete-betean bat egiten duzula. Gero, erantzun galdera hauei.
a) Lau esaldietatik, zeinekin zaude erabat ados? Zergatik?
b) Lau esaldietatik, zeinekin ez duzu bat egiten? Zergatik?
c) Idatzi testu labur bat, zure ustez, unitate hau ikastea baliagarria izan zaizun ala ez azaltzeko.
Puntuazioa Gaitasuna
Unitatea amaitu ondoren, bizimodu osasungarriarekin lotutako ohitura gehiago ezagutzen ditut.
Atsegina izan da nutriziofuntzioari buruz ikastea.
Bizimodu osasungarria izateko ikasi ditudan ohiturak nire ezagunei gomendatuko dizkiet.
Gauza gehiago ikasi nahiko nituzke, nire osasuna eta ingurukoena nola hobetu dezakedan jakiteko.
U2 51
Antzeko ohiturak Ohitura desberdinak
Ohitura desberdinak
Adierazi zer bizi-funtzio erakusten duen irudi bakoitzak, eta lotu hitz bakoitza dagokion irudiarekin.
Aurkitu ezkutuko ehunak, eta adierazi zer funtzio nagusi betetze duten. Zer organo osatzen dituzte?

Organuluak eta beste substantzia asko daude ... hau betetzen duen likidoan.

... zelulen funtzionamendurako informazioa gordetzen du.
... zelularen barrualdearen eta kanpoaldearen arteko substantzien trukea kontrolatzen duen hesi antzeko bat da.


Hiru saski «berezi» eraman dituzu, erosketak egiteko:
Lehena, energia ematen dizuten elikagaiak erosteko.
Bigarrena, egitura berriak eratzeko balioko dizuten elikagaiak erosteko.
Hirugarrena, zelulen funtzionamendu onari laguntzen dioten elikagaiak erosteko.
Zer elikagai sartuko dituzu saski bakoitzean?
Adierazi gure gorputzaren zer aparaturekin lotzen dituzun hitz hauek:



REPASO BERRIKUSPENA 3 5 4
1 2 C Sexuala Estimuluak Heterotrofoa Gametoak Mantenugaiak Energia lortzea Erreakzionatu
E S T I R A M U A N E R B I L E A P I T L O I A S Iragazi Ureterra Gernua Uretra Taupada Arteria Banatu Zaina Arnasgora Diafragma Karbono dioxidoa Gastrukea O U O N A S K U L U R
Oihane pentsakor dago, Aitorrek egin dizkion iruzkinak direla-eta: ez daki Aitor osasuna behar bezala zaintzen ari den. Zer diozu zuk?

Oso azkar jaten dut beti: ez daukat denborarik!
Eztarria ez dut sekula estaltzen. Deseroso nago bestela!
sTEAM


Ez naiz ura edateaz gogoratzen, ez dudalako inoiz egarririk izaten.
Entretenituta banago, ez naiz komunera joaten: ez dut dibertimenduko une bakar bat ere huts egin nahi!
Zientzialari misteriotsuaren atzetik...
Ondoko landa-koadernoan idatzitako oharrak zientzia lari ezagun batenak dira. No renak? Erantzuna ez bada kizu, ea beheko laguntzekin asmatzen duzun.

Erreinu bakoitzaren
Laguntzak

AEBn jaio nintzen, 1938an.



Nire koadernoan egin nituen oharrez gain, teoria endosinbiotikoaren sortzailea ere banaiz.



16 urte nituela hasi nituen unibertsitateko ikasketak, eta oso gustuko nuen mikroorganismoei buruz ikastea.
Eskaneatu, eta ikusi zein den zientzialari misteriotsua.

HIRUHILEKOA 1 6
izaki bizidun bat:
Erlazio- eta ugalketafuntzioen osasun ona
Ez dakit zer gertatzen zaidan… Azkenaldian oso erraz haserretzen naiz, energiarik gabe sentitzen naiz, negargura etortzen zait… Okerrena da ez dakidala zer dela eta nagoen horrela! Azkar hazten ari naiz, eta ez zait gustatzen. Gainera, ez daukat batere antzik Interneten ikusten ditudan nire adineko neska-mutilekin.
Orain ez naiz hain ondo moldatzen ez familiakoekin, ez betiko lagunekin: badirudi bat-batean ez zaizkigula gauza berdinak gustatzen… Anaia nagusiarekin hitz egin dut, baina «pubertaroaren kontuak» izango direla esan dit soilik. Auskalo, baina nire mundua hankaz gora jarri da!
Zer deritzozu?
Jonay sentitzen den antzera sentitu zara zu ere inoiz?
Erreparatu datuari. Zure ustez, osasun emozionala bizi-funtzioetako baten batekin erlazionatuta dago?
Ba al dakizu zer den pubertaroa?
Zerikusia izan dezake horrek
Jonayren egoerarekin?
Unitate honetarako...
Jonayren egoera ikuspuntu biologikotik aztertuko dugu, eta gutun bat idatziko diogu, anima dadin.
dugun moduarekin.


Jarraitu hariari!

Erlazio-funtzioa eta haren etapak
1
Zertan datza erlazio-funtzioa?
Ohitura osasungarriak eta zentzumen-organoen funtzionamendua
2
Hautematea eta zentzumen-organoen osasun ona

54
3
Helburua aurrera
4





55 3
Ohitura osasungarriak eta ugalketa-funtzioa. Pubertaroa
Ugalketa eta ugalketaaparatuaren osasun ona
5
Koordinazioa eta nerbiosistemaren osasun ona
Ohitura osasungarriak eta nerbio-sistemaren funtzionamendua
3
Erantzunak gauzatzea eta organo efektoreen osasun ona
Ohitura osasungarriak eta lokomozio-aparatuaren funtzionamendua
Zertan datza erlazio-funtzioa?
Gizakiok etengabe ari gara gure inguruan gertatzen diren aldaketetara egokitzen: hitz, barre, korrika egiten dugu... Baina nola lortzen du gure gorputzak ekintza horiek guztiak egitea?
Erlazio-funtzioa
Erlazio-funtzioari esker, gure inguruaren eta gorputzaren barrualdeko informazioa hautematen dugu, informazio hori prozesatzen dugu, eta erantzun egokiak ematen ditugu, bizirik iraun dezagun.
Erlazio-funtzioa egiteko, giza gorputzak gure inguruan eta barrualdean gertatzen diren aldaketak hautemateko mekanismo espezializatu jakin batzuk ditu. Aldaketa horiei estimulu deritze.
Estimuluak jasotzea
Zentzumen-organoek eta gorputzaren barne-errezeptoreek informazioa hautematen dute.
Erlazio-funtzioa egiten duten organoak zaintzen ikasteko, begiratu horri buruzko baliabidea « Berehala kontatuko dizut » atalean, anayaharitza.es webgunean.
Erantzun bat ematea
Zentzumen-organoek eta beste zenbait errezeptorek hautemandako informazioa nerbio-sistema zentralera iristen da, eta hark interpretatu eta erantzun zehatz bat ematen du.


1 Adierazi estimulu hauetako zein dagozkien inguruan gertatzen diren aldaketei, eta zein gorputzaren barrualdeko aldaketei: urdaileko mina, argi bizia, txokolate-zaporea.
2 Esaldi hauetako bakoitza erlaziofuntzioaren faseetako bati dagokio. Ordenatu, eta esan zer faseri dagokion bakoitza.
a) Nire hanka eta besoak erritmoari jarraikiz mugitzen dira.
b) Nire belarriek abesti bat entzun dute.




c) Nire garunak, abesti hori oso gustukoa dudala jabetu, eta dantza eginez erantzutea erabaki du.
Erantzuna gauzatzea

Nerbio-sistema zentralaren aginduak organo efektoreetara iristen dira, estimuluari erantzun diezaioten.


Gogoan hartu!

Etengabe ari gara estimuluak hautematen, haientzako erantzunak ematen, eta erantzunok gauzatzen.

56
1
Erlazio-funtzioaren faseak
Hautematea eta zentzumenorganoen osasun ona

Jonayk Interneten ikusten dituen pertsonekin alderatzen

du bere burua. Baina zeri esker daki zer itxura duten?
Zentzumen-organoak
Zentzumen-organoak gure gorputzaren kanpoaldean daude, eta hainbat eratako estimuluak hautematen espezializatuta daude.



Informazioa jasotzeko, zentzumen-organoek zelula errezeptoreak eta zentzumen-nerbioak dituzte. Lehenengoek hautemandako estimuluak seinale bihurtzen dituzte, eta bigarrenek, berriz, seinale horiek nerbio-sistema zentralera bidaltzen dituzte.
1 Azaldu zer den guruin pituitarioa eta zer funtzio duen.
2 Zer dela eta diozu hori? Zure ustez, zergatik ditugu bi belarri, bat buruaren alde bakoitzean? Eman arrazoiak.
Nola funtzionatzen duten usaimenak, dastamenak eta ukimenak
Usaimena usaimen-zelula errezeptoreen bidez (guruin pituitarioan daude, sudur-hobien barnean) airean disolbatutako substantzia kimikoak hautemateko gaitasuna da. Zelula horiek informazioa garunera bidaltzen dute usaimen-nerbioaren bidez.

Dastamena mihian dauden dastamen-papiletako zelula errezeptoreen bidez likidoetan disolbatutako substantzia kimikoak hautemateko gaitasuna da. Zelula horiek informazioa garunera bidaltzen dute dastamennerbioaren bidez.
Ukimena azalean dauden hainbat motatako errezeptoreren bidez tenperatura- edo presioaldaketak hautemateko gaitasuna da. Azaleko errezeptore horiek seinaleak garunera bidaltzen dituzte ukimen-nerbioen bidez.
57 U3
2
Usaimena Dastamena Ukimena
Usaimen-nerbioa Azala
Ukimennerbioa
Ukimenerrezeptoreak
Mihiko dastamenpapilak
Guruin pituitarioa
Sudurhobiak
Mihia
Hautematea eta zentzumenorganoen osasun ona
Nola funtzionatzen duten ikusmenak eta entzumenak
Ikusmena Entzumena

Ikusmena begien bidez argi-intentsitateak eta argi motak hautemateko gaitasuna da. Begiak kristalino izeneko lente bat du, eta haren zeregina argiizpiak erretinan dauden zelula errezeptoreetara bideratzea da. Erretinak hautemandako informazioa garunera bidaltzen da ikusmen-nerbioaren bidez, eta garun-azalak hura interpretatu eta irudi bihurtzen du.
Entzumena aireko bibrazioak (soinu deritze) hautemateko gaitasuna da. Bibrazio horiek tinpano izeneko mintz sentikor batek hautematen ditu, eta gero belarri barneko hezurtxo-kate batera bideratzen ditu. Hortik, kokleara heltzen dira, bertan baitaude soinuei seinaleak sortuz erantzuten dieten zelula errezeptoreak. Azkenik, seinale horiek entzumen-nerbioaren bidez heltzen dira garunera.


Zentzumen-organoen osasun ona
Hartu ohitura hauek, zure zentzumen-organoak zaintzeko:
• Babestu azala hotzetik, arropa egokia erabilita, eta eguzkitik, eguzki-babesa jarrita.
• Dastamena zaintzeko, saiatu edari edo elikagai beroegiak edo hotzegiak ez hartzen. Otordu bakoitzaren ostean, garbitu hortzak, infekzioak izateko arriskua saihesteko.
• Usaimena zaintzeko, babestu sudurra bufandekin edo antzeko jantziekin sasoi hotzetan, saihestu usain bortitzegiak eta tabakoa, eta aireztatu gelak behar bezala.
• Begiak zaintzeko, saihestu argi biziegia, saiatu pantailen aurrean denbora luzez ez egoten atsedenik hartu gabe, eta zoaz espezialistarengana aldiro, azterketa medikoak egin diezazkizun.
• Belarriak zaintzeko, saihestu soinu ozenegiak, erabili entzumenbabesak inguru zaratatsuetan, eta ez sartu objekturik belarrizuloetan.
3 Adierazi zer egituratan dauden argiaren zelula errezeptoreak begian, eta aireko bibrazioen zelula errezeptoreak belarrian.
4 Noiz erabili ohi dugu «Tinpanoa lehertuko didazu!» lagunarteko esapidea?
5 Erreparatu argazkiari, eta azaldu zer ohitura osasungarri erakusten duen. Eman arrazoiak.

58 2
Tinpanoa Entzunbidea
Koklea
Belarria Entzumennerbioa
Kristalinoa
Irisa
Begininia
Erretina
Ikusmennerbioa
Adi, zentzumenak asaldatu egiten baitira!
Edurnek ordenagailuaren aurrean ordu asko daramatzanez, haren zentzumen-organoak alerta-seinaleak bidaltzen ari dira garunera. Baina Edurnek entzungor egiten die, ezin kontzentratuago dagoelako
Ene! Tinpanoak lehertuko zaizkidala sentitzen dut. Nolako mina!
Ezin dut hainbeste estimulu jasan! Hazkura daukat, gorritzen ari naiz, eta negar ere egiten dut.
Zer aho-zapore txarra utzi didaten patata frijitu horiek!
Hau kiratsa! Auskalo zenbat denbora daramagun gela barruan... aireak ez du ia oxigenorik!
1 Adierazi zer kexu-iruzkin dagokion Edurneren zentzumen-organo bakoitzari, eta azaldu zer arrisku ohartarazten duen iruzkin bakoitzak.
2 Edurne osasun-arazoak izaten ari da azkenaldian: lo gaizki egiten du, buruko, belarriko eta hagineko mina du, oso nekatuta dago beti, eta erraz haserretzen da.
a) Lotu sintoma horietako bakoitza zentzumen-organo zehatz batekin eta hura hautematen ari den estimuluarekin.

b) Bilatu informazioa, pantailek eta soinu ozenegiek loari nola eragiten dioten jakiteko.
c) Ikertu nola eragiten dion gure osasunari gelak ondo ez aireztatzeak.
d) Hankak inurritu egiten zaizkigu eserita edo jarrera berean denbora gehiegi ematen dugunean. Hain zuzen, seinale horrek adierazten dio gure garunari mugitzeko beharra dugula. Ikertu zergatik den kaltegarria osasunarentzat mugitu gabe denbora gehiegi ematea.
e) Zure ustez, zer ohartarazten ari zaio Edurneri aho-zapore txarra? Zer egin beharko luke horri konponbidea emateko?
3 Bildu duzun informazioa baliatuta, idatzi gomendio-zerrenda bat Edurnerentzat, osasuna zaintzen ikas dezan, zentzumenorganoek ohartarazten dizkioten alertei erreparatuta.
Ez dut ezer sentitzen, inurridura arraro bat soilik. Lokarturik banengo bezala nago. Zer daukat? Lagundu!
KONTUZ! Kaltegarria da denbora luzez edonolako pantaila motaren aurrean egotea (mugikorrak, ordenagailuak, telebista eta abar). Horregatik, gailu horiek guztiak neurriz erabiltzea komeni da bai lan egiteko, bai gure aisialdian . Hain zuzen ere, IKTak modu osasungarrian erabiltzen ikasteko, eskuragarri duzu IKT-IET planeko 5. fitxa, anayaharitza.es webgunean.
Gogoan hartu!


Zentzumen-organoek gure inguruan gertatzen denaren berri ematen digute.

59 U3
Koordinazioa eta nerbiosistemaren osasun ona
Jonayk haserrea, apatia eta beldurra sentitzen ditu, eta emozio horiek kudeatzea zaila da edonorentzat. Nola lortzen du gure gorputzak hain sentipen konplexuak eratzea?
Nerbio-sistema


Nerbio-sistemak zentzumen-organoen informazioa jaso eta prozesatzen du, eta agindu jakin bat organo efektoreetara bidaliz erantzuten dio informazio horri.
Nerbio-sistema bi zatitan banatuta dago:
• Nerbio-sistema zentrala: gure gorputzak aldaketei ematen dizkien erantzunak koordinatzeaz arduratzen da. Honako hauek osatzen dute:
- Entzefaloa: garezurraren barruan dago, eta garunak (erantzun konplexuak eratzen ditu), zerebeloak (gorputzaren mugimenduak koordinatzen ditu) eta bizkarrezur-erraboilak (nahi gabeko funtzioak kontrolatzen ditu, hala nola bihotztaupadak) osatzen dute.
- Bizkarrezur-muina: bizkarrezurraren barruan dago, eta ekintza erreflexuez arduratzen da.
• Nerbio-sistema periferikoa. Nerbioz osatuta dago, gorputzaren atal desberdinak nerbio-sistema zentralarekin lotzen dituzten neurona-lokarriz, alegia.


Borondatezko ekintzak eta ekintza erreflexuak
Zentzumen-organoek estimulu bat hautematen dutenean, informazioa nerbio-sistema zentralera bidaltzen dute. Gero, hark informazio hori prozesatu eta organo efektoreei erantzun egokia eman dezaten agintzen die. Erantzunak bi motatakoak dira:
• Borondatezko ekintzak. Erantzun kontzienteak dira; hau da, erabaki bat hartzea eskatzen dutenak (hala nola ibiltzea, hitz egitea edo boligrafo bat eskuan hartzea). Entzefaloan koordinatzen dira.
• Ekintza erreflexuak. Bizkarrezur-muinean sortzen diren erantzun azkarrak, nahi gabekoak eta automatikoak dira. Adibidez, oso beroa dagoen zerbait ukitzean eskua kentzea ekintza erreflexu bat da.

1 Begiratu anayaharitza.es webgunean eskura duzun «Neuronak» izeneko baliabidea, eta azaldu zer funtzio duten zelula horiek.
2 Idatzi borondatezko ekintzen bi adibide eta ekintza erreflexuen beste bi.
60
3
Nerbio-sistema
Garuna Zerebeloa Bizkarrezurerraboila
Bizkarrezurmuina
Nerbioak
Nire lanbidea: neurologoa

Kaixo, Eba dut izena, eta neurologoa naiz. Nire zeregina nerbio-sistemaren gaixotasunak dituzten edo haien nerbio-sistemaren osasuna hobetu nahi duten pertsonak artatzea da.
Nerbio-sistemak osasun ona izango badu, beharrezkoa da hura osatzen duten organoek kalterik ez izatea eta pertsonak ongizate emozionala izatea. Ni nerbio-sistemaren organoen kalteak prebenitzeaz eta artatzeaz arduratzen naiz batik bat.
1 Nerbio-sistemaren organoek izaten dituzten arazo ohikoenak buruan edo bizkarrezurmuinean hartutako kolpe bortitzek eragindakoak izaten dira. Kolpe horien ondorioz, gorpu tzaren za ti zehatz batzuk paralizatu ere egin daitezke. Deskribatu era horretako ondorioak eragin ditzakeen egoeraren bat.
2 Ondoko aholku-zerrendan, nerbio-sistemaren osasuna hobetzen duten jokabide batzuk jaso ditut. Azaldu haietako zein egin ohi dituzun eta zein diren oraindik barneratzeko dituzunak.
3 Zerrendako aholku batzuk nerbio-sistemaren osasun fisikoari buruzkoak dira, beste batzuk, berriz, osasun emozionalari buruzkoak. Sailkatu aholkuak, irizpide hori kontuan hartuta.
4 Amaitzeko, idatzi zure nerbio-sistema hobetzeko eguneroko bizitzan egingo dituzun bost ekintza, eta azaldu ahalik eta xehetasun handienaz nola eta noiz egingo dituzun ekintza horiek.
NERBIO-SISTEMAREN OSASUN ONA
• Saihestu sedentarismoa: egin ariketa fisikoa egunero.
• Eginarazi lana buruari: egin ikastearekin lotutako jarduerak.
• Hobetu kontzentrazioa: ez egin gauza bat baino gehiago aldi berean, eta saihestu distrazioak, zure arreta osoa eskatzen duten gauzak egiten ari zaren bitartean.
• Jan janari osasungarriak.
• Egin lo nahikoa.
• Ez kontsumitu produktu toxikorik: alkohola, tabakoa, drogak...
• Ez hartu medikuak agindu ez dizun medikamenturik.
• Bizi pozez, eta izan umoretsua.
• Landu jakin-mina, naturarekiko eta artearekiko maitasuna eta besteenganako solidaritatea.
Gogoan hartu!


Ez izan erruduntasun-sentimendurik edo lotsarik arazoak izateagatik. Fidatu zaintzen zaituzten pertsonez, eta jo osasun-arloko profesionalengana laguntza behar duzun aldiro.
Hainbat gauza aparta zor dizkiogu gure nerbio-sistemari, hala nola hizkuntza, emozioak, ikasteko gaitasuna, irudimena...
61 U3
Nerbio-sistemari buruz ikas dezazun, haren arazo nagusiak eta hura zaintzeko ohitura osasungarri batzuk jakinaraziko dizkizut orain.
Erantzunak gauzatzea eta organo efektoreen



osasun ona




Guri buruzko iruzkin desatsegin bat entzutean negar
egitea edo, iruzkina atsegina bada, irribarre egitea erantzun normalak dira. Baina zer motatako organoei esker gauzatu ditzakegu halako erantzunak?
Nerbio-sistemak zentzumen-organoetatik iristen zaizkion estimuluak prozesatzen ditu, eta aginduak bidaltzen dizkie organo efektoreei, gauzatu ditzaten. Giza gorputzaren efektore garrantzitsuenetako bat lokomozio-aparatua da.

Lokomozio-aparatua
Mugitzeko aukera ematen diguten organoen multzoa da. Honako hauek osatzen dute:
• Eskeletoa. Hezurrek, giltzadurek eta lotailuek osatutako multzoa da. Mugi gaitezen ahalbidetzeaz gain, gainerako gorputzaren pisuari eusten dion aldamioa da, eta organo delikatuak babesten ditu, hala nola garuna.
• Muskulu eskeletikoak. Lokomozio-aparatua osatzen dute, eta nahita mugitzen dira. Energia asko kontsumitzen duten organoak dira.
Giltzadurak hezurren arteko lotuneak dira. Bertan daude hezur batzuk besteekin lotzen dituzten lotailuak. Horretaz gainera, muskuluak tendoien bidez lotzen zaizkie hezurrei. Lotailuak eta tendoiak oso ehun gogorrez eta elastikoz osatuta daude.
Lokomozio-aparatuaren funtzionamendua
Lokomozio-aparatuak palankaz osatutako multzo gisa funtzionatzen du. Palanka horiei esker, muskuluek indarrak eragiten dizkiete hezurrei, mugi daitezen.
Nerbio-sistemak seinaleak bidaltzen ditu muskuluetako zeluletara, eta, hori dela eta, laburtu edo luzatu egiten dira. Orduan, muskuluek uzkurtzeko edo erlaxatzeko egin behar duten mugimendua hezurrei helarazten diete tendoien bidez. Azkenik, kateatutako hezurrak giltzaduretan mugitzen dira, lotailuek finkatuta baitituzte.
Lokomozio-aparatuaz gain, gizakiok badugu beste sistema efektore garrantzitsu bat. Zein den jakiteko, begiratu «Sistema endokrinoa» baliabidea, anayaharitza.es webgunean. Ukondoko giltzadura
Honela mugitzen naiz
Askotan, mugimendu bera ahalbidetzen duten muskuluek kontrako lana egiten dute; hau da, muskulu bat uzkurtzen denean, bestea erlaxatu egiten da.
Pentsamendu konputazionala aplikatuta, egin eskema bat, beheko mugimendua zertan den urratsez urrats azaltzeko, eta arrazoitu zergatik esaten den bizepsa eta trizepsa muskulu antagonistak direla.
62
4
Humeroa Lotailuak Kubitua Erradioa
Bizepsa uzkurtzen denean, trizepsa
Tendoia trizepsa uzkurtu egiten
Bizepsa erlaxatzen denean,
Begira nola pentsatzen dudan
erlaxatu egiten da.
da.
Organo efektoreen osasun ona
Gure organo efektoreek osasun ona izan dezaten, komenigarria da ohitura hauek izatea:
• Elikadura osasungarria eta orekatua izatea, mantenugaien beharrezko kantitateak hartu ditzagun.
• Pisu egokia izatea. Gehiegizko pisua izatea kaltegarria da hezurrentzat, giltzadurentzat eta zenbait guruinen funtzionamendu onarentzat.
• Egunero ariketa fisikoa egitea, lesioak saihesteko beharrezko neurriak hartuz.
• Jarrera desegokietan ez egotea. Askotan, ordu asko ematen ditugu eserita. Gogoan izan behar dugu ondo esertzeak lokomozio-sistemaren kalteak saihesten dituela.
• Lo nahikoa egitea, jarrera egokian, behar bezalako koltxoi batean eta burko eroso batekin.
Giza gorputzaren hezurrik eta muskulurik garrantzitsuenak gogoratzeko, begiratu «Hezurrak» eta «Muskuluak» izeneko baliabideak, anayaharitza.es webgunean eskuragarri.
1 Erreparatu argazkiari, eta azaldu zer ohitura osasungarri erakusten duen. Eman arrazoiak.
Adituen arabera, bizkar-zorroan eraman behar dugun pisuak gure gorputzaren masaren % 10 izan behar du gehienez.
1 Kalkulatu zenbat kilo pisatzen dituen zure bizkar-zorroak. Beti gauza berdinak eramaten ez dituzunez, batez besteko pisua kalkulatu beharko duzu. Horretarako, kopiatu taula, idatzi egun bakoitzean daramazun pisua, eta kalkulatu batezbestekoa.
Al. As. Az. Og. Or.
Masa
kg-tan
2 Orain, idatzi zure pisua, eta kalkulatu datu horren % 10.
3 Alderatu zure bizkar-zorroaren pisua eta aurreko ariketan eskuratu duzun datua. Gomendatutako pisua gainditzen du?
4 Hitz egin ikasgelan zuen datuei buruz. Zenbatek eramaten duzue pisu gehiegi bizkar-zorroan? Datu horiek kontuan hartuta, zer ondorio ateratzen duzue?

5 Erreparatu ondoko irudiei:
a) Zer irudik erakusten dituzte bizkar-zorroa soinean eramateko ohitura txarrak? Eman arrazoiak.
b) Idatzi hiru gomendio, bizkar-zorroa soinean behar bezala eramateko.
Gogoan hartu! B C






D


63 U3
Zaindu dezagun gure bizkarra behar bezala!
Lokomozio-aparatuari esker, gizakiok era askotako erantzunak eman ditzakegu: ibili, korrika egin, dantzatu, hitz egin, barre egin… Zaindu ezazu, beraz! A
Ugalketa eta ugalketaaparatuaren osasun ona

Ugalketa-funtzioa
Ugalketa-funtzioari esker, ondorengoak izan ditzakegu. Gizakion ugalketa sexu bidezkoa da, eta, hori dela eta, bi gurasok beren ezaugarriak neurri batean heredatzen dituzten ondorengoak izaten dituzte. Horrek esan nahi du ondorengoak gurasoen antzekoak direla, baina...
• ez direla haien berdin-berdinak.
• ez direla elkarren artean berdin-berdinak (bikiak salbu).
Emakumearen ugalketa-aparatua
Giza gametoen tamaina

Obuluak (gameto femeninoak) sortzen ditu obulutegietan. Horretaz gain, ugalketa-aparatu hori prestatuta dago haren baitan hiru prozesu hauek egiteko: ernalketa, enbrioiaren garapena eta erditzea.


Obuluek 1,2 mm-ko diametroa dute. 0,5 mm dituzte luzeran.

Gizonaren ugalketa-aparatua
Barrabil-zorroa
Espermatozoideak (gameto maskulinoak) sortzen ditu barrabiletan.

64
5
Espermatozoidea Obulua
Barrabila
Zakila
Uretra
Prostata
Obulutegia
Bagina
Uteroa
Falopioren tronpa
Alua
Pubertaroan, gizakion gorputza azkar aldatzen hasten da. Hori ezinbesteko baldintza da, besteak beste, ugalketa-funtzioa behar bezala garatzeko.
Ugalketaren prozesua
Ugalketaren prozesuan hiru etapa bereizten dira:
1. Ernalketa: obulu batek eta espermatozoide batek bat egiten dutenean, zigoto bat eratzen da. Gizakion ugalketa emakumearen ugalketa-aparatuaren barnean gertatzen da.
2. Enbrioiaren garapena edo haurdunaldia: zigotoa zatikatu, hazi eta enbrioia eratzen da, uteroaren hormei atxikita. Enbrioiak hazten jarraitzen du umekia eratu arte. Gure espeziean, fase horrek bederatzi hilabete inguru irauten du.
3. Erditzea: umekia amaren uterotik kanpo bizitzeko behar adina garatu denean, erditzea gertatzen da. Erditzean, uteroa etengabe uzkurtzen da, eta amak umekia bultzatu egiten du baginan zehar kanporatzen den arte.
Pubertaroa
Pubertaroa ugalketa-aparatua heltzen den bizitzako garaia da, eta, oro har, hamar eta hamasei urte bitartean gertatzen da. Pubertaroak hainbat aldaketa eragiten ditu maila fisikoan eta psikologikoan.
Pubertaroan gertatzen diren aldaketak
1 Idatzi koadernoan ugalketaprozesuarekin lotutako hiru kontzeptu hauen esanahia: enbrioia, zigotoa eta umekia.
2 Begiratu anayaharitza.es webgunean eskura duzun baliabidea, eta azaldu zer funtzio betetzen duten plazentak eta zilbor-hesteak haurdunaldian.
3 Pubertaroan gertatzen diren aldaketei buruzko eskeman, «heldutasun psikologikoa garatzea» aipatzen da. Zer esan nahi du horrek, zure ustez?
Gizonaren ugalketa-aparatuarekin lotutako karaktereak
Barrabilak espermatozoideak sortzen hasten dira.
Bizarra hazten hasten da.



Ahotsa aldatzen da.
Muskulatura garatzen da eta abar.
Pertsona guztiek izaten dituzten aldaketak
Heldutasun psikologikoa garatzen da.
Biloa hazten da pubisean, besapeetan eta gorputzeko beste atal batzuetan.
Emakumearen ugalketa-aparatuarekin lotutako karaktereak
Bularrak hazten dira.
Aldakak zabaltzen dira.
Obulutegiak obuluak sortzen hasten dira. Lehen hilekoak gertatzen dira.
65 U3
Ugalketa eta ugalketaaparatuaren osasun ona
Hilekoaren zikloa
Hilekoaren ziklo deritzon prozesuen multzoak bi funtzio ditu: obulazioa erregulatzea eta emakumearen ugalketa-aparatua haurdunaldia gertatzeko prestatzea. Zikloa emakumearen lehen hilekoarekin abiatzen da, menarkiarekin, alegia, eta emakumeak berrogeita hamar urte inguru dituenean izaten duen azken obulaziora arte luzatzen da. Gertaera horrexek menopausiari ematen dio hasiera.
Hilekoaren zikloak hogeita zortzi egun inguru irauten du.
Hilekoaren zikloa
Obulua heldu eta uteroaren horma birsortu egiten da
Hilekoaren ondoren, obulu berri bat sortu, garatu eta heldu egiten da, eta uteroaren pareta, aldiz, birsortu egiten da. Zikloaren 1. egunetik 14.era gertatzen da.
4 Josunek azken lau hilabeteetako hilekoaren lehen egunak markatu ditu egutegian: urtarrilaren 26a, otsailaren 24a, martxoaren 25a eta apirilaren 23a.
a) Kalkulatu zenbat egun irauten duen, batez beste, haren hilekoaren zikloak.
b) Maiatzaren zer egunetan etorriko zaio hilekoa ziurrenik?
c) Josuneren datuak kontuan hartuta, kalkulatu zer egunetan gertatu zen obulazioa apirilean.
Obulazioa



Obulutegiak askatutako obulua uterora heltzen da. Haurdun geratzeko aukera handiena obulazioaren aurreko eta ondorengo egunetan gertatzen da. Zikloaren 14. egunaren inguruan gertatzen da.
Askatutako obulua Obulua heldu egiten da (1. egunean hasten da).
Obulua kanporatu egiten da, loditutako uteroaren hormako ehunarekin eta odolarekin batera.
Uteroaren horma birsortu egiten da (6. egunean hasten da).
Menstruazioa edo hilekoa
Ernalketarik ez badago (ezta haurdunaldirik ere, beraz), obulua kanporatu egiten da, uteroaren horma estaltzen duen geruzarekin eta odol pixka batekin batera. Zikloaren 1. egunetik 5.era gertatzen da.
Obulua Uteroaren pareta loditua


Uteroa prestatu egiten da



Uteroaren pareta loditu eta odol-kapilarrez betetzen da. Hala, prestatu egiten da, ernalketa gertatuz gero, enbrioia bertan atxiki dadin. Zikloaren 14. egunetik 28.era gertatzen da.

66 5
Ugalketa-aparatuaren osasun ona
Ugalketa-aparatuaren osasuna zaintzeko, komenigarria da ohitura hauek hartzea:
• Garrantzitsua da kanpoko sexu-organoak behar bezala garbitzea, infekzio eta gaixotasunak saihesteko.
• Gizakiok, oro har, lehenbizi maila sexualean heltzen gara, eta aurrerago garatzen dugu gure heldutasun emozionala. Ezinbestekoa da alderdi hori kontuan hartzea gure emozioak kudeatzeko eta erabakiak hartzeko orduan.
• Sexualitatea norberaren intimitateari dagokio. Beharrezkoa da beste pertsonen intimitatearen zati hori errespetatzea, baita geurea babestea ere, Interneten eta Internetetik kanpo jokabide arriskutsuak saihestuz.
• Espezialistarengana jo behar da, hilekoarekin lotutako alterazioak izanez gero.
• Giza papilomaren birusak gaixotasun larriak eragin ditzake; batik bat, emakumeen ugalketa-aparatuan. Horregatik, garrantzitsua da haren kontrako txertoa hartzea, gure autonomiaerkidegoaren txertatze-egutegiari jarraikiz.

5 Erreparatu argazkiari, eta azaldu zer ohitura osasungarri erakusten duen. Eman arrazoiak.
Zientzia, giza papilomaren birusaren aurka egiteko

Giza papilomaren birusa ugalketa-aparatuaren zenbait gaixotasunekin lotuta dago. Haietako batek emakumeei eragiten die bereziki, hain zuzen, umetoki-lepoko minbiziak.
Erreparatu grafikoari: 2020an, Suedian egin zuten ikerketa baten emaitzak erakusten ditu. Barrek adierazten duten informazioa hauxe da: zenbat emakumeri detektatu zioten umetoki-lepoko minbizia, 100 000 biztanleko.

Zientzialariak bagina bezala aztertuko ditugu grafikoaren emaitzak. Horretarako urratsez urrats erantzungo diegu galdera hauei:
1 Txertatu gabeko zenbat emakumeri detektatu zieten umetoki-lepoko minbizia?
2 Zer gertatzen da emakume txertatuekin? Umetoki- lepoko minbiziaren kasuak gehiago ala gutxiago dira? Idatzi zure lehen ondorioa.


3 Grafikoko zer emakume-taldetan detektatzen dira umetoki-lepoko minbiziaren kasu gehiago? Idatzi zure bigarren ondorioa.
Umetoki-lepoko minbizia duten emakumeak, 100 000 biztanleko
17 urte bete ondoren txertatuak

17 urte bete aurretik txertatuak
Gogoan hartu!
Munduan bizi garen gizaki guztiok ugalketa-funtzioari esker sortu gara. Sinestezina da benetan!
67 U3
Txertatu gabeko emakumeak
Z er ikasi dut?
1 Osatu esaldi hauek zure koadernoan:
a) ...-aparatua eta ... organo efektoreak dira, ...-sistemaren aginduei erantzuten baitiete.
b) ... gizonaren ugalketa-aparatuaren gametoak dira, eta ... emakumearen ugalketa-aparatuarenak.
2 Hautatu erantzun zuzena esaldi bakoitzean:
a) Tendoiek zer lotzen dituzte? hezurrak / hezurrak eta muskuluak
b) Lotailuek zer lotzen dituzte? hezurrak / hezurrak eta muskuluak
3 Egin nerbio-sistemaren atalak jasotzen dituen eskema bat.
4 Lotu bi zutabeak zure koadernoan:

Ernalketa Enbrioiaren garapena
Erditzea
Enbrioia hazi egiten da, eta haren gorputzaren egitura guztiak garatzen dira.
Erabat garatutako umekia amaren sabeletik irteten da.
Zigotoa eratzen da.
5 Adierazi entzefaloaren zer atal arduratzen den prozesu hauetako bakoitza erregulatzeaz:
a) Istorio bat asmatzea.
b) Bizikletaz goazen bitartean, gure mugimenduak koordinatzea.
c) Bihotzaren erritmoa erregulatzea.


6 Azaldu zer diren erreflexuak eta nerbio-sistema zentralaren zer atal dagoen espezializatuta halako erantzunetan.

7 Erantzun gizakion ugalketa-funtzioari buruzko galdera hauei:
a) Zenbat irauten du haurdunaldiak?
b) Zer da ernalketa? Emakumearen ugalketaaparatuaren zer ataletan gertatzen da?
c) Zer da pubertaroa? Zerrendatu bizitzaren aro horretan gorputzean gertatzen diren aldaketa nagusiak.
8 AGA Zergatik elikatu behar dugu ondo ariketa muskularra egiten dugunean (oinez edo bizikletaz ibili, korrika egin eta abar)? Arrazoitu zure erantzuna.
9 Adierazi gizonaren ugalketa-aparatuaren zer atalek osatzen duten iraitz-aparatua. Gauza bera gertatzen da emakumearen ugalketaaparatuarekin?
10 Erreparatu argazkiari, eta erantzun galderei:
a) Zer kalte izan ditzakete neskatilaren ikusmenak eta entzumenak?
b) Neskaren zer beste aparatuk jasan ditzakete kalteak? Zer kalte izateko arriskua dute?
c) Zure ustez, nola saihestu daitezke arrisku horiek? Azaldu.
11 Zergatik da garrantzitsua ohitura hauek hartzea?
a) Eguzki-babesa hondartzan zein igerilekuan erabiltzea.
b) Kirola egin aurretik, beroketa-ariketak egitea.
c) Bizkar-zorroaren uhalak behar bezala estutzea.
d) Ugalketa-aparatuak ondo garbitzea.
Ez ahaztu unitate honetako zure argazki-albuma osatzea, webgunean: anayaharitza.es
Semaforoa. Margotu koadernoan, ariketa
bakoitzaren ondoan, honela: erantzuna badakizu
laguntza behar izan baduzu
erantzuna jakin ez baduzu
68 PORTFOLIOA
HELBURUA AURRERA
Pubertaroan gertatzen diren aldaketak aztertu eta gutun bat idatziko dugu, Jonay animatzeko
1 Irakurri berriz unitate hasieran Jonayk adierazi duen egoera. Gertatzen zaizkion gauzetako zein daude lotuta erlazio-funtzioarekin?
Eta ugalketa-funtzioarekin?
2 Egin talde txikiak, eta bilatu informazioa alderdi hauei buruz:
a) Zein diren pubertarora iristean izaten diren arazo emozional ohikoenak.
b) Nola hobetu eta zaindu daitekeen emozioen osasuna nerabezaroan.
Nahi izanez gero, familiakoei, lagunei eta irakasleei galdetu diezaiekezue zer bizipen izan zituzten pubertaroan eta nerabezaroan.
3 Zure taldekideekin batera, baliatu bildu duzuen informazio guztia, eta idatzi gutun bat, Jonay animatzeko. Azaldu ikuspuntu biologikotik zer gertatzen ari zaion, eta eman aholku batzuk, hobeto senti dadin.
4 Irakurri ikasgelan Jonayri idatzi dizkiozuen gutunak. Ariketa amaitzeko, kopiatu eta osatu antolatzaile grafiko hau.
Nire lehengo iritzia Nire oraingo iritzia Arrazoiak

Unitatea ikasten hasi aurretik, zer uste zenuen pubertaroari, buru-osasunari eta erlazioeta ugalketa-funtzioei buruz?
Zer galdera bururatzen zaizkizu gai horien inguruan?

N ola ikasi dut?
Gai horiei buruz zenituen zer uste edo iritzi aldatu dira unitatean ikasitakoaren ondorioz? Zer iritzi duzu orain?
1 Hausnartu zure portfolioan alderdi hauei buruz:
a) Unitateko zer ariketa gustatu zaizun gehien eta zergatik.
b) Zer gauza berri ikasi dituzun.
c) Nola sentitu zaren unitate hau ikastean.
d) Nolakoa izan den talde-lanetan izan duzun parte-hartzea.
Zer galdera berri sortzen zaizkizu erlazio- eta ugalketafuntzioekin lotutako ohitura osasungarriei buruz?

Gehien gustatu zaidan ariketa hauxe izan da:
Talde-lanetan izan dudan parte-hartzeari dagokionez...
Ikasi ditudan gauza berriak hauexek izan dira:
U3 69
4 Lurra etengabe aldatzen dela ikasiko dugu
Kaixo, Eukene dut izena, eta maite dut aitarekin buztina modelatzea!

Aita buztingilea da, eta zeramikazko objektu zoragarriak egiten ditu; nire ontziak, ordea, desastre hutsa izaten dira. Baina... berriz ere hutsetik hasteko unea izaten da gozagarriena, izan ere, buztinezko munstro erraldoi bat egin eta zanpatu eta marruskatu egiten dut!
A! Gaur eskolan esan digute Lurra ere zanpatu, tolestu, hautsi eta urtu egiten diren arrokaz osatuta dagoela. Baina ez naiz fidatzen... Zerk eragin lezake halako indar eta bero handia?
Zer deritzozu?

Eukenek adierazi bezala, zure ustez, zerk eragin ditzake arrokak deformatu eta hausteko moduko hain indar itzelak?
Erreparatu datuari. Zure ustez, zer aldaketa izan ditu Lurrak hain denbora luzean?
Begiratu argazkiari. Gaur egungo arrokei erreparatuta, iraganean zer gertatu zitzaien jakin dezakegula uste duzu?
Unitate honetarako...
Helburua aurrera
Zenbait paisaiaren maketak egingo ditugu, paisaiak nolakoak diren eta nola zaindu ditzakegun ulertzeko.
Lurra duela 4543 milioi urte inguru sortu zela uste da, eta harrezkero ez dio aldatzeari utzi.
Jarraitu hariari!
Lurraren geruzak, mineralak eta arrokak

1
Zerez osatuta dago eta nola funtzionatzen du Lurrak?
70
Datua
Magmatismoa, lurrazalaren deformazioak eta haien ondorioz eratzen diren arrokak

Erliebea modelatzen duten prozesuak eta arroka
Lurraren historia geologikoa 4 2
Lurraren
barrualdeko beroak
eta indarrek erliebea
aldatzen dute
sedimentarioak 3




Atmosferak, hidrosferak eta grabitateak ere erliebea aldatzen dute
Nola aldatu da Lurra eratu zen geroztik?
71 15
Zerez osatuta dago eta nola funtzionatzen du Lurrak?
Eukenek
egin duen bezala, zuk
ere zeure buruari galdetu diozu inoiz gure planetak nola funtzionatzen duen eta zer elementuk osatzen duten?
Lurra: sistema bat
Lurra sistema bat da; hau da, elkarren artean erlazionatuta dauden hainbat elementu aldakorren multzoa da. Elementu horiek biosfera, atmosfera, hidrosfera eta geosfera dira, hain zuzen.
Biosfera
Lurrean bizi diren izaki bizidun orok osatzen dute, gizakiak barne. Biosfera ekosistemen bidez erlazionatzen da planetaren gainerako elementuekin.
Atmosfera
Lurra inguratzen duen airezko geruza da. Zenbait gasez osatuta dago; besteak beste, arnasten dugun oxigenoz eta landareek fotosintesian baliatzen duten karbono dioxidoz.
Bertan gertatzen dira fenomeno meteorologikoak, hala nola haizeak, hodeiak, prezipitazioak...
Hidrosfera

Lurrean dauden ur-masa guztiek osatzen dute. Ozeanoak, polo eta mendietako izotza, ibaiak, aintzirak, urmaelak eta lurrazpiko urak hartzen ditu barne.
Uraren zikloak hainbat prozesuren bidez erlazionatzen ditu hidrosfera eta atmosfera. Hala nola, lurgaineko uraren lurrunketa, ur tantatxoen kondentsazioa (gero, hodeiak eratzen dira), prezipitazioa (euria, elurra...), jariatzea (ibaiak) eta iragazketa (lurpeko urak).

Geosfera

Arrokaz eta metalez osatutako esfera erraldoia da, eta gainerako elementuak haren gainean daude. Hiru geruza ditu:
• Lurrazala. Geruzarik kanpokoena eta meheena da. Arroka zurrunek osatzen dute.
• Mantua. Tarteko geruza da, eta guztietan lodiena. Arroka beroz osatuta dago. Haiek beroaren beroaz jariatu eta urtu ere egin daitezke.
• Nukleoa. Geruzarik barnekoena da, eta burdinaz eta beste zenbait metalez osatuta dago. Solidoa da barrutik, eta geruza urtu bat du kanpoaldean.
72
1
GEOSFERA Mantua Nukleo jariakorra Nukleo solidoa Ozeanoa Lurrazala Mantua ibaia Jariatzea Haizeak Hodeiak Prezipitazioak
Lurrak osatzen duen sistemaren atalak
ATMOSFERA HIDROSFERA
Erlazioak, Lurrak osatzen duen sisteman
Lurra sistema bat da, haren elementu guztiek, egoki funtzionatuko badute, elkarren beharra dutelako; izan ere, elementuek elkarri eragiten diote.
Elementuen arteko erlazioak prozesuen bidez egiten dira. Esate baterako:
• Uraren zikloa atmosfera eta hidrosfera erlazionatzen dituen prozesu bat da.
• Fotosintesia edo arnasketa izaki bizidunak eta atmosfera erlazionatzen dituzten prozesuak dira.
• Erupzio bolkanikoak geosfera eta atmosfera erlazionatzen dituzten prozesuak dira, gasak airera kanporatzean.
Prozesu horien ondorioz, Lurra etengabe aldatzen da, baina, aldi berean, prozesu horiei esker, sistema osoa orekan mantentzen da.
Sistema baten prozesuak
ATMOSFERA
Fotosintesia
Arnasketa
Oxigenoa kanporatzen du Karbono dioxidoa kanporatzen du Karbono dioxidoa hartzen du Oxigenoa hartzen du
BIOSFERA
Eskema bat egingo dugu Lurrak osatzen duen sistemaren funtzionamenduari buruz
Sistemen funtzionamendua irudikatzeko, hala nola Lurrak osatzen duena, eskemak erabiltzen dira. Haietan, kaxak (sistemaren elementuak), geziak (elementuen arteko erlazioak) eta etiketak (erlazioak ahalbidetzen dituzten prozesuak) ageri dira.
Hemen duzun eskema bakun honetan, Lurrak osatzen duen sistemaren elementuak eta haiek elkarrekin erlazionatzen dituzten geziak ikus ditzakezu. Erlazioak ahalbidetzen dituzten prozesuen etiketei dagokienez, bazterretan daude, desordenatuta.
Uraren zikloa
1 Kopiatu eskema kartoi mehe batean, eta idatzi prozesuei dagozkien etiketak papertxo itsasgarrietan. Saiatu etiketa bakoitza eskeman dagokion lekuan itsasten. Eredu gisa, begiratu arretaz eskeman jada ipinita dagoen etiketari.
2 Pentsatu eskeman ageri ez diren beste hiru prozesu, eta ipini bertan, dagokien lekuan.
3 Hautatu hiru prozesu horietako bat, bilatu informazioa, eta azaldu zertan den ikasgelan.
ATMOSFERA
Izaki bizidunek ura erabiltzen dute
Arrokak aldatu egiten dira uraren eraginez
HIDROSFERA BIOSFERA


Gasak daude uretan


GEOSFERA
Arrokak aldatu egiten dira airearen gasen eta haizearen eraginez
73 U4
Begira nola pentsatzen dudan
Arnasketa Lurpeko urak Fotosintesia Transpirazioa Erupzio bolkanikoak
Zerez osatuta dago eta nola funtzionatzen du Lurrak?
Geosferaren materialak
Gizakiok geosferaren lurrazalean bizi gara. Geruza hori, hain zuzen, arrokaz osatuta dago. Era berean, arrokak mineralez eginak daude.
Mineralak eta mineral motak



Mineral bat jatorri naturaleko material solido bat da, konposizio kimiko jakin bat eta barne-egitura ordenatu bat dituena. Azken ezaugarri horri esker, mineralak kristal geometrikoak eratzen ditu.

Mineral bakoitzak berezko konposizioa eta barneegitura ditu, eta, haien ondorioz, baita propietate bereizgarri batzuk ere. Propietate horiexek balia ditzakegu mineralak elkarren artean bereizteko. Hona hemen mineralen propietate batzuk:
• Kolorea. Mineral bakoitzak kolore bereizgarri bakarra edo gehiago ditu. Aitzitik, mineralek marratzean askatzen duten hautsa ez da kolore horretakoa izaten.
• Distira. Mineralak argia islatzeko duen modua da. Beirakara, metalikoa, zeta edo nakar itxurakoa, matea (distirarik gabea) eta abar izan daiteke.
• Gogortasuna. Mineral batek urraduraren kontra agertzen duen erresistentzia da. Mineralik gogorrena diamantea da, eta bigunenetako bat talkoa.
• Kristalen forma. Mineralen barneegituraren araberakoa da, eta, besteak beste, kubo, prisma, piramide bikoitza eta xafla formakoak izan daitezke.
Mineralen sailkapena
Mineralak konposizio kimikoa kontuan hartuta sailkatzen dira batik bat. Adibidez:
• Mineral natiboak. Hala nola urrea, zilarra, kobrea, sufrea eta diamantea. Egoera puruan (konbinatu gabe) dagoen substantzia bakarraz osatuta daude.





• Silikatoak. Hala nola olibinoa, kuartzoa, ortosa eta mika. Gogorrak dira, eta arroketan oso ohikoak.
• Karbonatoak. Hala nola kaltzita eta aragonitoa. Kareharrien antzeko arroketan ageri dira.
• Osagai gisa metalak dituzten mineralak. Halakoak dira, esaterako, oligistoa eta pirita (burdina dute), galena (beruna du), kalkopirita (kobrea du) eta zinabrioa (merkurioa du).


Mineralen propietate batzuk





Korindoia. Kolore gorria du, oso gogorra da, eta kristal prismatikoak ditu.
Pirita. Urrekolorea du, distira metalikoa, oso gogorra da, eta kristal kubikoak ditu.
Fluorita. Kolore berdea du, tarteko gogortasuna, distira beirakara eta kristal oktaedrikoak ditu.
Talkoa. Kolore zuria du, zeta antzeko distira, eta ez da batere gogorra.
Mika muskovita. Nabarra da, lerro zuriak ditu, ez da oso gogorra, eta xaflatan jarritako kristalak ditu.
Zenbait mineral mota
Mineral natiboak


74 1
Mineral metaldunak
Sufrea Kobrea
Olibinoa Kuartzoa Ortosa
Mika biotita
Silikatoak Karbonatoak Kaltzita Aragonitoa
Oligistoa Galena Kalkopirita Zinabrioa
Arrokak eta arroka motak
Arrokek ezaugarri hauek dituzte: jatorri naturaleko materialak dira, giro tenperaturan solidoak dira, eta mineral mota batez edo gehiagoz osatuta daude.

Arroka motak bereizteko, alderdi hauei erreparatzen zaie:
• Osagaiak; hau da, zer mineralez osatuta dauden. Esate baterako, kareharria mineral bakarraz, kaltzitaz, osatuta dago; granitoa, aldiz, kuartzoz, ortosaz eta mikaz.


• Testura; hau da, mineralek zer forma duten eta arroketan nola ageri diren. Adibidez, granitoaren kristalak begi hutsez ikusten dira; basaltoarenak mikroskopikoak dira; eta arbelarenak, berriz, zapalduta eta norabide berean jarrita daude.



• Jatorria; hau da, arrokak nola sortu ziren. Hori estu lotuta dago arrokek naturan agertzeko duten moduarekin. Alderdi hori kontuan hartuta, hiru motatako arrokak
ditugu:



Magmatikoak. Lurraren barrualdeko arroka urtuetatik sortu ziren. Esaterako, granitoa eta basaltoa.
Metamorfikoak. Aldez aurretik baziren arrokak dira, gerora lurrazaleko gune sakonetan berotu eta zanpatu zirenak. Halakoak dira, besteak beste, arbela, gneisa eta marmola.
Sedimentarioak. Hain zuzen, sedimentuetatik sortzen dira. Sedimentuak itsas eta aintziren hondoetan geruzak osatuz jalkitako beste zenbait arrokaren zatiak edo uretan disolbatutako mineralak dira. Denboraren joanak geruza horiek arroka bihurtu zituen, hala nola konglomeratuak, hareharria, buztina eta kareharria.


Arroken karta sorta bat egingo dugu
Egin lau laguneko taldeak, arrokei buruzko karta-sorta bat egiteko eta harekin jokatzeko.
• Bilatu Interneten arroken izenak eta haien irudiak. Hautatu zazpi arroka magmatiko, zazpi metamorfiko eta beste zazpi sedimentario.
• Egin tamaina bereko txartelak (arroka bakoitzeko bat), eta ipini arrokaren izena eta irudi bat, eta zer motatakoa den. Utzi zurian txartelen atzealdea.
• Bildu hogeita bat kartak, eta prestatu jokatzeko!
Arroka motak
1 Orri birakaria Egin zerrenda bat, mineral hauetako bakoitzaren propietateak jasotzeko: diamantea, pirita, oligistoa, aragonitoa eta mika.

2 AGA Eman arrazoiak leihoetako beira, kozinatzeko gatza eta egurra mineralak ote diren esateko.
3 Deskribatu goialdeko irudietako arroken testura.
1 Banatu bost karta taldekide bakoitzari.
Txanda bakoitzean esku denak karta bat trukatuko du nahi duen taldeki dearekin. Mota be reko bost arroka eskuratzen lehena izango da irabazlea.
Lurra izaki bizidunek, aireak, urak, mineralek eta arrokek osatzen duten multzoa da, eta guztiek batera mekanismo erraldoi gisa funtzionatzen dute.
75 U4
Gogoan hartu!
Arroka magmatikoak
Arroka metamorfikoak
Arroka sedimentarioak
Arbela Konglomeratua
Basaltoa Marmola Kareharria
Granitoa
Lurraren barrualdeko
beroak eta indarrek erliebea aldatzen dute
Eukenek bere buruari galdetzen dio zerk eragin ote dezakeen arrokamasa erraldoiak deformatzeko edo urtzeko moduko hain indar handia. Zer deritzozu zuk?
Nolatan gertatuko ziren aldaketa horiek?
Lurraren barrualdea ezin beroago dagoenez, bertako arrokak mugitu eta jariatu egin daitezke, eta indarrak eragitera ere irits daitezke.
Beroak eta Lurraren barneko indarrek fenomenoak eragiten dituzte lurrazalean, eta fenomeno horiek erliebea aldatzen dute. Magmatismoa eta lurrazalaren deformazioak dira fenomeno esanguratsuenak.

Magmatismoa




Lurraren mantuko zenbait eremutan hain handia da beroa, non arrokak urtu ere egiten diren. Hala, lurrazalean gora egiten duten gasez betetako sekulako arrokamasak eratzen dira. Arrokamasa horiei magma deritze.
Sumendiak eta arroka bolkanikoak
Magma bat lurrazalaren pitzadura batetik lurrazalera iristen bada, sumendi bat eratzen da.

Sumendietan, arroka urtuak indarrez kanporatzen dira, hain zuzen, arrokek dituzten gasek bultzatuta. Prozesu horri erupzio bolkaniko esaten zaio, eta laba izeneko magma oretsua eta beroa kanporatzen da.
Laba bi modutan ager daiteke: batetik, sumendiaren hegaletan behera jaits daiteke, fluxu edo ibai sutsuak eratuz, eta, bestetik, sumendiak airean solidotzen diren tamaina askotako laba zatiak jaurti ditzake. Azken horiei piroklasto deritze.
Arroka bolkanikoak, hala nola basaltoa eta pumita, laba azkar hoztu eta solidotzen denean sortzen dira. Prozesu horretan, begi hutsez ikusi ezin diren kristal txikitxikiak sortzen dituzte haien mineralek.
Arroka bolkanikoek berezko erliebeak eratzen dituzte:
• Kono bolkanikoak. Mendien garaiera izaten dute, eta kraterrak dituzte hegal edo tontorretan.
• Eremua estaltzen duten laba solidotuko fluxuak.
• Piroklastoz estalitako eremuak. Piroklastoak erupzioetan kanporatu ziren, eta hainbat geruza osatu zituzten.
Lurraren barrualdeko beroak eta indarrek eragiten dituzten ondorioak
76
2
Arroka magmatiko bolkanikoak
Indarrak
Mantuko arroken mugimendua
Magmatismoa Deformazioak Indarrak
Basaltoa Pumita
Kono bolkanikoa
Kraterra Laba
Gasak
Plutoiak eta arroka plutonikoak
Lurrazalean gora egiten duten magma batzuk ez dira azaleratzen, eta lurrazalaren barnealdean gelditzen dira, forma esferikoa, obalatua edo zapala duten masa erraldoiak osatuz. Bertan, astiroastiro solidotzen dira, eta plutoiak eratzen dituzte.

Arroka plutonikoak, hala nola granitoa eta sienita, lurrazalaren barnean astiro solidotzen diren magmetatik sortzen dira. Prozesu horretan, begi hutsez ikusten diren kristalak sortzen dituzte haien mineralek.
Denboraren joanak Lurraren gainazala higatzen du. Horren ondorioz, lurrazaleko arroka plutonikoak polikipoliki azaleratu eta, Lurraren gainazala bezalaxe, higatu egiten dira, erliebe mota hauek eratuz:
• Domoak. Mendien garaiera izaten duten bloke trinko erraldoiak dira, obalo formakoak eta pareta laudunak.
• Harritzak. Pitzaduren eta higaduraren eraginez, bloke txikiagoak eta biribilduak osatuz hautsi diren plutoiak dira.
1 Azaldu zer den magma bat, zure hitzak erabiliz.
2 Adierazi termino hauek arroka bolkanikoekin edo arroka plutonikoekin lotuta dauden: Piroklastoa. Harritza. Granitoa. Plutoia. Fluxua. Domoa. Basaltoa. Sumendia.




3 Adierazi arroka bolkanikoek eratu ohi dituzten bi erlieberen izenak.
4 Adierazi arroka plutonikoek eratu ohi dituzten bi erlieberen izenak.
5 Zer da sumendi bat?
Espainiako arroka bolkanikoak eta plutonikoak

77 U4
1 Ikertu, eta adierazi Espainiako mapa batean zer gunetan dauden arroka bolkanikoak. Eremu horietan guztietan sumendiak daude oraindik?
2 Ikertu, eta adierazi Espainiako mapa batean zer gunetan dauden arroka plutonikoek eratutako plutoiak eta domo eta harritza erako erliebeak.
Arroka magmatiko plutonikoak
Granitoa Sienita
Domoa
Harritza
Lurraren barrualdeko beroak eta indarrek erliebea aldatzen dute
Lurrazalaren deformazioak

Mantuko arroken mugimenduek sorrarazten dituzten sekulako indarrek mantso eta etengabe eragiten diete lurrazaleko arrokei.
Indar horiek eta Lurraren barrualdeko beroak bat egiten dutenean, lurrazaleko arrokamasa handiak zanpatu, tolestu edo puskatu ere egin ditzakete.
Indar horien ondorioz, arroka metamorfikoak eta mendikateak eratu eta lurrikarak gertatzen dira.
Nola eratzen dira arroka metamorfikoak?
Lurraren barneko indarrek eta beroak elkarrekin konbinatuta eragiten diete lurrazaleko arrokei, eta urtzen ez dituzten arren, aldaketa jakin batzuk eragiten dizkiete:
• Arrokak zanpatu egiten dira, eta haien mineralek norabide berean jarritako xaflak edo zerrendak osatzen dituzte. Hala, arbela zanpatutako buztina da, eta gneisa, aldiz, zanpatutako granitoa.

• Arrokak trinkotu eta gogortu egiten dira, haien mineralen kristalak hazi egiten direlako. Hala, kuartzita trinkotutako hareharria da, eta marmola, trinkotutako kareharria.
• Batzuetan, arroken zenbait mineralek beren konposizioa aldatzen dute eta bestelako mineral bihurtzen dira.




Arroka metamorfikoak, hala nola arbela, gneisa, kuartzita eta marmola, lurrazaleko arrokak Lurraren barrualdeko indarren eta beroaren eraginez eraldatzen direnean sortzen dira.
Nola eratzen dira mendiak?
Lurraren barrualdeko indarrek lurrazaleko arrokamasa handiei eragiten dietenean, tolestu, zimurtu eta goratu egin ditzakete.
Prozesu horiek milioika urtez gertatzen dira, eta azkenean mendikateak eratzen dituzte. Aldaketa horiek izugarriak dira zinez: horren erakusgarri, itsas hondoetan eratu ziren arrokak menditontorretan aurkitu ditzakegu gaur egun.
Lurrikarak
Batzuetan, Lurraren barrualdeko indarrek lurrazalaren barruko arrokamasak kolpetik hautsarazten dituzte. Gertaera horrek lurrikara deritzon bibrazio bortitz bat ekartzen du berekin. Bibrazio hori Lurraren gainazalera iristen da, kalteak eraginez.
Arroka metamorfikoak
Honela eratzen dira mendiak
Arrokak daude itsas hondoan


Lurraren barneko indarrek lurra bultzatzen dute
Arrokak tolestu eta goratu egiten dira
6 Zer da arroka metamorfiko bat? Idatzi bi adibide.
7 Azaldu zergatik aurkitzen dituzten itsas izakien fosilak zenbait mendiren tontorretan.
8 Nola gertatzen dira lurrikarak?
78 2
Marmola
Kuartzita
Arbela
Arroka magmatikoak eta metamorfikoak baliabide gisa erabiltzen ditugu

Arroka magmatikoak eta metamorfikoak oso desberdinak dira jatorriari erreparatuz gero, baina ezaugarri komun bat dute: bi harri mota horiek baliabide gisa erabiltzeko preziatuak dira, trinkoak eta hauskaitzak izateaz gain, leundu ondoren, oso testura eta kolore ederrak izaten dituztelako.




Horrexegatik dituzte hainbeste erabilera. Adibidez:

• Granitoa eta basaltoa eraikuntzarako, kaleak zolatzeko eta hiri-altzariak, eskulturak eta beste objektu apaingarri batzuk egiteko erabiltzen dira.
• Piroklastoekin estaltzen dituzte lantzeko lur eta lorategiak, lurrak bere hezetasuna gal ez dezan.
• Arbelezko xaflak teilatuak estaltzeko, erretiluak eta plater apaingarriak egiteko... erabiltzen dira.

• Marmola zoruak zolatzeko, paretak estaltzeko eta eskulturetarako erabiltzen da.
• Kuartzita beira egiteko erabiltzen da.
Era berean, aipatu ditugun arroka horiek guztiak artearen eta dekorazioaren arloan erabili ohi dira baliabide gisa. Hain zuzen, Antzinaroan hasi zen ohitura hori gure egunetara ere iritsi da.

1 Erreparatu irudietako eskultura ospetsu hauei. Haietako bakoitza arroka endogeno mota desberdin batez egina dago. Bilatu informazioa, eta idatzi argazki-oin bat irudi bakoitzarentzat, eskulturei buruzko datu hauek jasotzeko:
a) Non dauden.


b) Zer garaitan egin zituzten.
c) Zer motatako arrokaz eginak dauden.
2 Argazki-oinetan, adierazi zergatik aukeratu zituzten, zure ustez, arroka mota horiek eskulturak egiteko.
3 Milaka urte dituzten eskultura batzuek zutik diraute oraindik. Azaldu zergatik den hori horrela.
Lurraren barrualdeko beroak eta indar bortitzek milioika urte daramatzate Lurreko arrokak urtu, tolestu, hautsi eta eratzen.
79 U4
A C B
Granitolauzak
Pikoia (Kanarietako basaltoa)
Marmolxaflak
Arbellauzak
Beira
Samotraziako Garaipena
Ramses II.aren estatua kolosala
Buru olmeka bat
hartu!
Gogoan
Atmosferak, hidrosferak eta grabitateak ere erliebea aldatzen dute
Eukenek ikasi du Lurraren barnealdeko indar handiak ez direla erliebea aldatzen duten bakarrak eta badagoela Lurraren gainazala astiro higatzen duen beste zerbait ere... Zer izango ote da?
Atmosferarekin, hidrosferarekin eta biosferarekin kontaktuan dauden lurrazaleko arrokak polikipoliki aldatzen dira.
Atmosferaren, hidrosferaren, biosferaren eta grabitatearen eraginak aldaketak eragiten ditu lurrazaleko arroketan. Aldaketaeragile nagusiak erliebea modelatzen duten prozesuak eta arroka sedimentarioak eratzea dira.


Erliebea modelatzen duten prozesuak
Atmosferak, hidrosferak eta grabitateak hiru prozesu hauen bidez aldatzen dute Lurraren erliebea: meteorizazioa, garraioa eta sedimentazioa.
Meteorizazioa
Meteorizazio izeneko prozesuak arrokak txikitu edo haien mineralak disolbatzen ditu. Agente geologikoen eraginez gertatzen da, hala nola tenperaturaaldaketak, ura, izotza, airea eta izaki bizidunak.

Arroka meteorizatuen gainean, arroka zati askeen eta mineralen geruza bat eratzen da pixkana. Geruza hori izaki bizidunek kolonizatzen badute, haiek eta prezipitazioek, pixkanaka, eraldatu egiten dute, eta gero eta lurzoru lodiago bihurtzen da. Lurzoruak arroka zatien, airearen eta izaki bizidunen hondakinen nahasketaren emaitza dira. Lurzoruek lurrazalaren eremu handi bat hartzen dute, eta bizitzarako funtsezkoak dira.
Garraioa eta higadura
Meteorizazioaren ondorioz askatutako arroka zatiak jatorrizko eremutik beste eremu batzuetara garraiatzen dituzte agente geologikoek, hala nola grabitateak, glaziarrek, lurgaineko ur-korronteek, lurpeko urek, itsasoak eta haizeak. Garraioaren prozesuan, materialak hautsi, biribildu eta leundu egiten dira.
Meteorizazioren ondorioz askatutako materialen garraioak erliebeak higatzen ditu. Hala, erliebeak sakondu edo lautu egiten dira.
Meteorizazioa

Uraren, airearen, tenperaturaren eta izaki bizidunen eragina.
Gizakiak. Gizakiok gure eraikuntzekin eraldatzen dugu eremua.
Grabitatea. Haren eraginez, material askeak eremu altuetatik eremu baxuetara lekualdatzen dira.
Glaziarrak. Maldetan behera astiro irristatzen diren izotzezko «ibai» ikaragarriak dira. Eremuko arroka zatiak arrastatu eta U formako haran zabalak (sakonuneak) eratzen dituzte.
80
3
Arroka
Arroka
Zati askez osatutako geruza
Garraioa eta sedimentazioa
Sedimentazioa
Garraioagente batek arroka zatiak arrastatzen jarraitu ezin duenean, material horiek dauden lekuan jalkitzen dira.
Sedimentazioa gertatzen da garraioagenteek garraiatzen dituzten materialak lekuren batean uzten dituztenean. Jalkitako materialei sedimentu deritze.
Garraiatutako arroka zatiak ordena jakin batean jalkitzen dira, puskek duten tamainaren eta garraiatzen dituzten agenteen energiaren edo indarraren arabera: handienak eta astunenak txikienak eta arinenak baino lehenago jalkitzen dira. Oro har, sedimentazioa garraioagenteek energia gutxien duten eremuetan gertatzen da, hala nola lautadetan, itsaso eta aintziretako hondoetan, haranetako leku sakonenetan... Denboraren poderioz, eremu horietan, sedimentu mota askotako geruza lodiak metatzen dira.
Lurgaineko ur-lasterrak. Ibaiek tamaina askotako arroka zatiak erauzi eta beren ibilbideetan behera arrastatzen dituzte. Hori egitean, arroilak eta haranak eratzen dituzte. Sedimentuak ibaien zenbait tartetan metatzen dira: astunenak goiibarretan geratzen dira, eta arinenak, aldiz, bokaleetara heltzen dira.
1 Zer hiru prozesuren bidez modelatzen da erliebea?
2 Zer esan nahi dugu arroka bat meteorizatu egin dela diogunean?
3 Izaki bizidunok erliebea modela dezakegula esatea zuzena al da? Eman arrazoiak.
4 Zuen ustez, nola meteoriza dezake izotzak arroka bat?
5 Zer esan nahi dugu mendiak higatu egiten direla diogunean?
Itsasoko olatuek kostaldeko arrokak kolpatu eta pixkana hausten dituzte. Halaxe eratzen dira labarrak. Erauzitako arroka zatiak leundu, biribildu, birrindu eta harea bihurtzen dira azkenean. Harea metatzean, hondartzak sortzen dira.
Lurpeko urak. Lurrean zehar iragazten den urak bidean topatzen dituen arroken mineralak disolbatzen ditu. Hori egitean, arrokak higatzen ditu, haietan barrunbeak eratuz; hala nola leizeak eta haitzuloak.
Haizea. Basamortuetan, haizeak harea eta hautsa arrastatzen dituenez, arrokak higatzen ditu haien kontra jotzean. Haizeak indarra galtzen duen lekuetan, harea eta hautsa metatu egiten dira, dunak eratuz.

81 U4
Atmosferak, hidrosferak
eta grabitateak ere erliebea aldatzen dute
Arroka sedimentarioak



Garraioagenteek uzten dituzten sedimentuek geruzak eratzen dituzte. Arroka sedimentarioak geruza horiek arroka bihurtzean eratzen dira.
Arroka sedimentarioak prozesu honi jarraikiz eratzen dira:
• Geruzak metatu egiten dira. Geruzak elkarren gainean metatzen diren heinean, lehenengo metatu ziren geruzek jasaten duten pisua handitu egiten da, sakonenak baitira.
• Sedimentuak trinkotu egiten dira. Pisuaren eraginez, sedimentu zatiak estutu eta haien artean zegoen ura galtzen dute. Bertan, zementu antzeko bat sortuz kristalizatzen dira mineralak. Zementu horrek sedimentu zatiak soldatzen ditu, eta, hala, sedimentuak arroka bihurtzeko prozesua osatu egiten da.


• Arroka sedimentarioek jatorrizko sedimentuen geruzaantolaera bera gordetzen dute.
Arroka sedimentario motak
Jatorrizko sedimentuak kontuan hartuta, bi motatako arroka sedimentarioak ditugu:
• Beste zenbait arrokaren zatiz osatutako arrokak. Hala nola konglomeratuak (legarrez osatuta daude), harearriak (hareaz osatuta daude) eta buztinak (limoz osatuta daude).
• Uretan disolbatutako mineralen kristalizazioaren bidez sortutako arrokak. Halakoak dira, esaterako, kareharriak (kaltzitaren kristalez osatuta daude) eta ebaporitak (halitaren, igeltsuaren eta abarren kristalez osatuta daude).



Fosilak

Arroka sedimentarioen bereizgarri bat fosilak izan ditzaketela da. Are gehiago, kareharri batzuk ia osorik fosilez eratuta daude.
Fosil bat izaki bizidun baten hondakina edo aztarna da, sedimentugeruza batean lurperatuta geratu eta arroka sedimentarioa eratu zenean hura ere arroka bihurtu zena.
Arroka sedimentario baten fosilak oso garrantzitsuak dira Lurraren iraganaren berri ematen baitigute; izan ere, arroka eratu zuten sedimentuak jalki ziren unean eremu jakin batean zer izaki bizidun bizi ziren jakiteko aukera ematen digute.
Beste zenbait arrokaren zatiz osatutako arrokak
Buztina
Konglomeratua Hareharria
Uretan disolbatutako mineralen kristalizazioaren bidez sortutako arrokak
1. Hildako iraganeko organismo baten hondakinak itsaso baten hondoan geratzen dira.
2. Sedimentuek hondakinak estaltzen dituzte, eta, bat eginda, arroka
3. Higadurak arrokageruzak desagerrarazten baditu, fosila azaleratu egiten da.
82 3
Honela eratzen dira fosilak
bihurtzen dira.
Arroka sedimentario motak
Kareharri fosilduna Igeltsua
Arroka sedimentarioak baliabide gisa erabiltzen ditugu
Arroka sedimentarioak oso baliabide garrantzitsuak dira gizakiontzat. Baliatzen ditugun arroka sedimentarioen eredu batzuk
• Buztina. Xehatu eta urarekin nahasten da modela daitekeen ore bat lortzeko. Gero, ore hori labean egostean, gogortu eta zeramika bihurtzen da. Buztina baliatuta, adreiluak, teilak, baldosak, azulejuak, ontziak eta abar egiten dira.
• Kareharria. Bloketan, eraikuntzarako erabiltzen da, eta, birrinduta eta kiskalita, zementua egiteko. Kareharri motarik ederrenak apaingarri gisa erabiltzen dira, baita artelanetarako eta zoruak eta paretak estaltzeko ere.
• Ebaporitak. Haietatik eskuratzen ditugu, esaterako, halita edo gatz arrunta eta igeltsua.
• Hareharria. Arroka horretatik lortzen den harea eraikuntzan erabiltzen da, zementuarekin eta legarrarekin nahastuta, hormigoia egiteko. Kuartzozko hareharrietatik, berriz, beira lortzen dugu.
1 Ideiabiltzarra Irakurri ondoko informazioa, ikertu, eta azaldu zer arroka behar diren, elementu hauek dituen etxe bat eraikitzeko: hormigoizko zutabeak, adreiluzko hormak, teiladun teilatua, igeltsuzko panelez estalitako barne-paretak eta beirazko leihoak.

2 Arrokak ez diren arren, erregai fosilak arroka sedimentarioekin estu lotuta dauden baliabideak dira.
Ezinbestekoak dira gaur egungo gizakiarentzat, baina aldi berean arazo-iturriak ere badira.
Begiratu erregai fosilei buruzko baliabidea anayaharitza.es webgunean, eta erantzun:
a) Zerrendatu erregai fosilak eta gaur egun dituzten erabilera nagusiak.
b) Zergatik esaten dugu erregai fosilak baliabide berriztaezinak direla?
c) Zer ingurumen-arazo sortzen ditu erregai fosilak erauzteak eta erabiltzeak?
d) Zer egin dezakegu gure egunerokoan baliabide horien erabilera jasangarria egiten laguntzeko?
Gogoan




















Atmosferak, hidrosferak eta grabitateak arrokak astiro higatu eta askatutako material horiek gero metatuko diren lekuetara eramaten dituzte. Bertan, denboraren poderioz, arroka sedimentario bihurtuko dira.







83 U4
hartu!
Buztina Kareharria Igeltsua Harea
Zeramika
Zementua
Hormigoia
Beira
Lauzak
Beroa Plastikoak
Petrolioa Gasa
Ikatza
Nola aldatu da
Lurra eratu zen geroztik?
Zenbat aldaketa eta zer motel gertatu diren Lurrean! Orduan, duela zenbat urte sortu zen gure planeta? Eta zernolakoa zen iraganean?
Mundiala izango litzateke denboran zehar bidaiatu ahal izatea, galdera horiei erantzuteko!
Orain badakizu Lurraren erliebeak aldatu egiten direla, eta aldaketa horietako asko nola gertatzen diren ikusteko aukerarik ez dugula, oso motel gertatzen baitira.
Horrek pentsarazten digu Lurra oso antzinakoa dela. Hain zuzen, zientzialarien ikerketen arabera, Lurra duela 4600 milioi urte inguru eratu zen.
Iraganeko Lurra
Zorionez, Lurrak bere historian zehar izan dituen aldaketek aztarnak utzi dituzte erliebeetan eta Lurraren gainazaleko arroketan. Aztarna horiek aztertuz, Lurraren iragana nolakoa izan zen ondoriozta dezakegu. Adibidez:
• Arroketako aztarnek erakusten dute iraganeko kontinente eta ozeanoak ez zirela gaur egungoak bezalakoak, eta askotan aldatu direla lekuz, tamainaz eta formaz. Horretaz gainera, atmosfera eta planetako klimak ere aldatu dira denbora luze horretan.

• Arrokak zer adinetakoak diren aztertuta, arroka magmatikoen masak noiz sortu ziren jakin dezakegu, baita noiz gertatu ziren mendiak goratu eta arroka metamorfikoak eratu zituzten lurrazalaren deformazioak ere.
• Erliebearen formak eta arroka sedimentarioen geruzak aztertzean, erliebea modelatzeko prozesuek Lurraren gainazaleko arrokak nola aldatu zituzten jakin dezakegu, baita noiz eta nola jalki ziren arroka sedimentarioak eratu zituzten sedimentuak ere.


• Fosilek erakusten dutenez, izaki bizidunak duela 3800 milioi urte inguru agertu ziren, eta orduz geroztik ez diote aldatzeari utzi. Milioika urteko epe luzean, Lurrean espezie berri ugari agertu izan dira, eta beste asko, aldiz, desagertu egin dira.
Lurraren historiaren denbora-lerroa
Lurrak 4600 milioi urte inguru ditu. Urte kopuru hori 4600 kmko distantziarekin alderatuko bagenu (Parisen eta Ipar Poloaren artean dagoena), milioi urte bakoitza 1 km izango litzateke; mila urte 1 m izango litzateke; eta ehun urte, luze bizitako gizaki baten bizitza, alegia, 1 cm baino ez litzateke izango. Zure bizitza osoan halako ibilbide luze baten zentimetro bakarra soilik ikusi ahal izango bazenu, zaila izango litzaizuke gainerakoa imajinatzea, ezta?
Duela 250 milioi urte, kontinenteak bat eginda zeuden. Bizia zegoen ingurune guztietan.
Duela 550 milioi urte, bizia ugaritu egin zen.
Duela 65 milioi urte, meteorito batek Lurra jo zuen, eta espezie asko desagertu egin ziren.
Duela 700 milioi urte, Lurra izoztu egin zen.
Duela 300 000 urte, gure espeziea agertu zen.
Duela 3 800 milioi urte, bizia sortu zen.
Duela 4 000 milioi urte, ozeanoak eratu ziren.
Duela 4 600 milioi urte, Lurra eratu zen.
84
4
Kaixo, Ruper dut izena, eta paleontologoa naiz. Geologia eta biologia ikasi nituen, eta nire zeregina Lurreko bizitzaren iragana ikertzea da. Horretarako, fosilak aztertzen ditut.


Nire lanbidea: paleontologoa



Egunotan, duela 150 milioi urte inguruko arroka batzuetan agertu diren iknita batzuk aztertzen ari naiz. Eremu horretan bertan, arroka horietan, hain zuzen, hemen behean irudikatu ditudan bi dinosauroen eskeletoak aurkitu dituzte. Lagunduko al didazu animalia horiei eta haiek bizi ziren inguruneari buruzko datuak biltzen?
Teropodo haragijalea
Sauropodo belarjalea

1 Erreparatu irudikatutako dinosauroei eta aztertzen
ari naizen iknitak dituen arrokaz egin ditudan ohar eta irudiei. Informazio hori kontuan hartuta:
a) Zer iknita dagokio dinosauro bakoitzari?
b) Azken ikerketek diotenez, dinosauro baten alda karen altuera haren oinatzaren luzera halako lau da, gutxi gorabehera. Hori horrela, zer altueratan egongo litzateke dinosauro bakoitzaren aldaka?
c) Nire oharren arabera, zer dinosauro ibiltzen zen azkarrago?
d) Iknitei begira, jakin genezake dinosauroek taldeak edo samaldak eratzen zituzten? Nola?
2 Zure ustez, zer ingurunetan bizi ziren bi dinosauro horiek? Zergatik?
3 Espainiako zenbait lekutan iknitak aurkitu dituzte. Ikertu, eta adierazi leku horietako hiru.
Dinosauroen fosiletan espezializatuta nago: eskeletoak, arrautzak, gorozkiak eta oinatzak. Bai, halaxe da: badaude oinatz fosilak! Hain zuzen, iknita deritze.
Gaur egungo arrokak
aztertzeak bide ematen digu Lurrak bere historia luzean zehar izan dituen aldaketen berri izateko.

85 U4
IKNITAK, HAREHARRIZKO OHE BATEAN
Iratzefosilatropikal
Itsas uhinen arrasto fosilak
Gogoan
hartu!
Z er ikasi dut?
1 Adierazi zein diren geosferaren zatiak edo geruzak, kanpoaldetik barrualdera.
a) Haietako zein dago metalez osatuta?
b) Zer geruza da lodiena?
c) Eta zein da hotzena?
2 Idatzi definizio bat termino hauetako bakoitzarentzat:
a) Minerala d) Distira





b) Kristala e) Arroka
c) Gogortasuna f) Testura


3 Zer hiru motatako arrokak ditugu, haien jatorria kontuan hartuta? Jarri bakoitzaren adibide bat.
4 Deskribatu, zure hitzak erabilita eta marrazkien bidez, nolakoak diren erliebearen forma hauek:
a) Sumendia.
b) Harritza.
c) Haitzuloa.
d) Duna.
5 Eman arrazoiak, argazkietako paisaietan zer arroka mota aurkituko ditugun azaltzeko.
6 Azaldu zertan diren desberdinak arroka bolkanikoak eta arroka plutonikoak.
7 Sailkatu irudietako arrokak:
8 Azaldu zer den arroken meteorizazioa.
9 Azaldu nola modelatzen duten paisaia...
a) Ibaiek.
b) Itsasoko olatuek.
c) Glaziarrek.
10 Nola eratzen dira arroka sedimentarioak?
11 Aipatu hiru arroka sedimentarioren izenak.
12 Zer dira fosilak? Zergatik dira garrantzitsuak?
Ez ahaztu unitate honetako zure argazki-albuma osatzea, webgunean: anayaharitza.es
Semaforoa. Margotu koadernoan, ariketa
bakoitzaren ondoan, honela:
erantzuna badakizu
laguntza behar izan baduzu
erantzuna jakin ez baduzu
86 PORTFOLIOA
A A B B C
HELBURUA AURRERA
Paisaiak modelatuko ditugu
1 Maketa bat egingo dugu buztinarekin edo plastilinarekin eta birziklatutako materialekin, hala nola kartoiak, kutxak eta bestelako ontziak. Lehenengo, osatu taldeak, eta erabaki zer paisaia mota modelatu nahi duzuen.
2 Bilatu hautatu duzuen paisaia mota irudikatzen duten argazkiak. Erreparatu haiei, eta osatu antolatzaile grafiko hau galderen erantzunekin.
Ikusi Pentsatu Neure buruari galdetu
Zer ikusten duzu argazkietan?
Zer elementu iruditzen zaizkizu deigarriak?
Nolakoak dira elementu horiek?
Nola eratu ziren ikusten dituzun elementuak?
Zure ustez, zer motatako arrokaz daude osatuta?
3 Bilatu informazioa, bururatu zaizkizuen galderei erantzuteko, eta egin zuen maketa.
Ipini azalpen-txartelak maketan, irudikatutako paisaiari buruzko informazio hauek ezagutarazteko: zer motatako arrokak osatzen duten, nola eratu zen, eta nola lagundu dezakegun hura zaintzen. Zeregina amaitutakoan, maketak ikusgai jar ditzakezue, beste pertsona batzuek ere zuen lanaz goza dezaten.
N ola ikasi dut?
1 Ziurrenik, unitatean Lurrari buruz ikasi dituzun gauzetako asko ez zenekizkien aurretik. Egin zerrenda bat, eta jaso bertan orain badakizkizun gauza horiek guztiak.
2 Aipatu harritu zaituen eta ikastea gustatu zaizun gauzaren bat.
3 Baliteke unitateko zenbait eduki ulertzea zaila egin izana. Ondoko fitxa eredu gisa hartuta, idatzi koadernoan zein izan diren zuretzat edukirik zailenak.
Zer galdera berri bururatzen zaizkizu paisaia mota horren osaerari, formari edo historia geologikoari buruz?



Niretzat, hauexek izan dira ulertzeko zailak:
Izan ere... ?



U4 87
Egin Hitzapasa moduko joko bat, hiruhileko honetan zentzumen-organoen inguruan ikasi dituzun zenbait kontzeptu baliatuz. Idatzi esaldi bat hizki-gurpilean jartzen duzun letra bakoitzeko (eredu gisa, begiratu beheko esaldiari):
• K letrarekin hasten da: argi-izpiak zelula errezeptoreetara bideratzen dituen begiko lentea. Erantzuna: kristalinoa.
Hitzapasa jokoa egin eta gero, jokatu zure ikaskideekin. Hitz guztiak asmatzeko denbora gutxien behar izan duenak irabaziko du.
Bilatu arrotza hitz multzo bakoitzean: Askojakin irakaslea gizaki bat diseinatzen ari da ordenagailu-programa baten bidez, baina ez da gai gizaki horrek «funtziona» dezan. Itxura denez, ez daki zer funtzio duen atal bakoitzak. Erreparatu baliatzen ari den «piezei», eta lagundu, haien izenak idatzita.
Barrabil-


Nola funtzionatuko lukete atal horiek guztiek, bat eginda baleude?
Zakila
Haurdunaldia
Uretra










Nire arroka-bilduma txukun sailkatuta nuen kutxa batean, baina erori egin da! Lagunduko al didazu, mesedez, afixa bakoitza dagokion arrokarekin lotzen?

88 REPASO BERRIKUSPENA 1 4 3
2 K F O P N T C G N P C R A B C D E
Zigotoa Ernalketa
Barrabila Prostata Obulua
zorroa
Metamorfikoak Sedimentarioak Magmatikoak Basaltoa Granitoa Arbela Marmola Konglomeratua Kareharria A B C D E F
Falopioren tronpa Obulutegia Uteroa
Testu honetan zenbait akats daude. Aurkitu zein diren, eta zuzendu:
Lurraren barrualdean hain handia da beroa, non arrokak urtu egiten diren, sumendiak eratuz. Material hori kanporatu eta hozten bada, mendi bat eratzen da. Aitzitik, materiala kanporatzen ez bada, lurrazalean astiro hoztu eta arroka sedimentarioak eratzen dira.


Hondartzan zaudela, hareari begiratu, eta nola sortuko ote zen galdetu diozu zure buruari...
Egin koadernoan komiki soil bat, arroka batek mendi-gailurretik zu zauden hondartzara heldu arte egin duen ibilbidea irudikatzeko. Ez ahaztu arroka prozesuan zehar nola eraldatu den ere kontatzea.
Zientzialari misteriotsuaren atzetik...


Irakurri arretaz gure zientzialariari bidali dioten oharra. Horrela, ziur erraz asmatuko duzula nor den. Bestela, hortxe dituzu laguntzak ere.
Rita maitea: Ezin dugu denborarik galdu! Etxean prestatu duzun laborategiaren berri izan dute. Gorde ondo zure laginak: onartezina da zure ikerlana alferrik galtzea. Irin-fabrika zaharraren plano bat marraztu dut. Jarraitu geziei, eta utzi laginak gurutze batekin adierazi dudan biltegian. Gure kide batek jasoko ditu gaur gauean. Kontuz ibili, mesedez.
Sinatuta: Lagun bat

Laguntzak
Italian jaio nintzen, 1909an... eta 103 urte arte bizi izan nintzen!
Neuronei buruz egin nituen ikerke- tak direla eta, Medikuntzako Nobel Saria eman zidaten 1986an.
Eskaneatu, eta ikusi zein den zientzialari misteriotsua.
II. Mundu Gerra ga- raian, ihes egin behar izan nuen, eta nire ikerketak ezkutuan egiten jarraitu.

89 HIRUHILEKOA 1 5 6
sTEAM
3. eta 4. UNITATEA
EZAGUTU DIZIPLINARTEKO PROIEKTUA
Kutxa magikoa eta haren zaintza
KUTXA MAGIKOAREN MISTERIOAK
ITZALAPROIEKTUAK UZTENDUTEN
PROYECTOSHUELLA QUEDEJAN

Ba al zenekiten osasun mentala hobetzea pertsonok bizitzako aro guztietan dugun erronka handia dela?
Garunak dituen gaitasun guztiek liluratuko zaituztete!
Animatuko al zarete osasun mentalari buruzko informaziopilula batzuk egitera?
Ondo dakizue garunak betetzen duen funtzioa oso garrantzitsua dela, baina...
Zertaz arduratzen da? Zer atal ditu, eta zer zeregin dituzte?
Zer da osasun mentala?
Zer dira nahasmendu mentalak?

Zerk adierazten digu gure osasun mentala okertzen ari dela? Nola jokatu behar dugu egoera horretan?
Egin gai horrekin lotutako aholku-zerrenda bat.

Garunari buruz gehiago jakiteko, txoko berezi bat prestatuko duzue. Horrek, haren ezaugarriak ezagutarazteko ez ezik, osasun mentala zaintzeko beharraz sentsibilizatzeko ere balioko du. Izan ere, ongizate fisikoa bezainbeste zaindu behar dugu ongizate mentala ere.
Partekatu ikasgelan egin dituzuen ikerketen emaitzak.
Garunak egin ditzakeen gauza guztiek aho zabalik utziko zaituztete!
90
1 T hink P ENTSATU D esign 2 DISEINA T U
3 M aker
Adostu zereginak nola banatuko dituzuen. Informazio-pilulak modu analogikoan zein digitalean egin ditzakezue.


Erabili informazioa behar bezala irudikatu eta ulertaraziko duten irudiak. Nahi izanez gero, zailtasun-maila desberdineko pilulak egin ditzakezue.
Garuna beti zaindu behar dugu, edozein adin dugula ere!
Lanera!
Iritsi da unerik desiratuena:
«kutxa magikoari» eskaini diozuen txokoa inauguratuko duzue!
Garrantzitsua da txokoa egoki antolatzea, informazio mota bakoitzari (garunaren atalak, funtzioak, bitxikeriak, osasun mentala eta aholkuak...) gune bat eskaintzea, alegia.

Zergatik ez dituzue familiakoak zuen txokora gonbidatzen? Hala, kutxa magikoaren misterioak ezagutu ahal izango dituzte!
Zer ondorio atera dituzue?
Nola zaindu dezakegu osasun mentala?
91 1. HIRUHILEKOA
EGIN
4 PRESENTA S tage AURKEZTU T est EGIAZTAT U 5

Ikasturtean zehar zientzia egiteko erabiliko dituzun STEM tresna guztiak ditugu.
16 Gizakion zenbait «matxura» ikertuko ditugu, zerk huts egiten duen ikusi eta matxura horiek nola konpon daitezkeen jakiteko.
32 Gure ohituren inguruan hausnartu, eta proposamen bat egingo dugu, haiek hobetu eta osasungarriagoak izan daitezen lortzeko.
eta ongizatea
Jonayren egoera ikuspuntu biologikotik aztertuko dugu, eta gutun bat idatziko diogu, anima dadin.
5 Materia ezagutuz
Zenbait paisaiaren maketak egingo ditugu, paisaiak nolakoak diren eta nola zaindu ditzakegun ulertzeko.
Osasuna eta ongizatea






7 Aurrerabidea edo natura? Biak?

92 Gure plater gustukoenen errezetak aztertuko ditugu, haietan materia nola erabiltzen den jakiteko.
ez izatea
Ikastetxea argindarrik gabe gelditu dela imajinatu eta Uxoarena bezalako biziraupen-plan bat egingo dugu.
Energia eskuragarria eta ez-kutsatzailea

126 Sare sozialen bidez, gure erkidegoko herrikideei jakinaraziko diegu zein garrantzitsua den ekoizpen eta kontsumo arduratsuaren aldeko ekintzen berri ematea. Ekoizpen eta kontsumo arduratsua
Gutun bat idatziko diogu Europako Batzordeari, ur-eskasiagatik kezkatuta gaudela jakinarazteko; aldi berean, arazoa arintzeko politiken aldeko sinadura-bilketa bat jarriko dugu martxan.
164
ura eta saneamendua


Turismoarekin lotutako negozio bat irekiko dugula imajinatuko dugu, eta, hura eratzeko, ekonomia-, gizarte-eta ingurumen-jasangarritasuna izango ditugu kontuan. Lan duina eta hazkunde ekonomikoa
Inkesta bat egingo dugu, etxeko lanetan familiako nor aritzen den jakiteko.
Genero-berdintasuna
Medikuntzako aurrerapenei buruz eta osasun-zerbitzuen arloan lan egiten duten profesionalei gure esker ona erakusteko moduei buruz eztabaidatuko dugu. Osasuna eta ongizatea
Energia aurrezteko eta energiaren erabilera arduratsua egiteko ideia-gida bat egingo dugu. Energia eskuragarria eta ez-kutsatzailea


Zer ikasiko dugu? OR. IKASKUNTZA-EGOERA HELBURUA AURRERA GJH DIZIPLINARTEKOA
8 Nire STEM tresna-kaxa
9 Zatoz gu bisitatzera!
XIX. mendean
184 10 Espainia
200 11 Espainia XX. eta XXI. mendeetan
216 12 Ekonomia, gizartea eta kultura
144 8 Ur-eskasia, benetako arazo bat?
Edateko
1 Zerez eginak gauden ikasiko dugu
2 Osasungarria da gure elikadura
54 3
eta ugalketa-
osasun ona 70
Erlazio-
funtzioen
aldatzen dela ikasiko dugu
4 Lurra etengabe
Goserik
106 6 Energia erabiltzen dugu
Lehorreko bizitza Osasuna eta ongizatea Osasuna
• Metodo zientifikoa
• Bizi-funtzioak eta zelulak
• Zelulen ezaugarriak, formak eta tamainak
• Nutrizio-funtzioa eta mantenugaiak
• Elikagaiak eta haien sailkapena
• Dieta eta elikadura osasungarria
• Erlazio-funtzioa eta haren etapak
• Ohitura osasungarriak eta zentzumen-organoen funtzionamendua
• Lurraren geruzak, mineralak eta arrokak
• Magmatismoa, lurrazalaren deformazioa eta haien ondorioz eratzen diren arrokak
• Proiektuetan oinarritutako metodoa
• Ehunak eta zer ehun mota ditugun
• Organoak eta zer organo mota ditugun
• Digestioa, arnasketa, zirkulazioa eta aparatu horien osasun ona
• Iraizpena eta iraitz-aparatuaren osasuna
• Ohitura osasungarriak eta nerbio-sistemaren funtzionamendua
• Ohitura osasungarriak eta lokomozioaparatuaren funtzionamendua
• Erliebea modelatzen duten prozesuak eta arroka sedimentarioak
• Lurraren historia geologikoa
• Pentsamendu konputazionala
• Aparatuak eta sistemak eta zer aparatu eta sistema mota ditugun
Konpetentziak lantzeko ariketak
Konpetentziak lantzeko ariketak
1. hiruhilekoaren berrikuspena: 1. eta 2. u ni tateak. STEAM: Lynn Margulis
• Ugalketa-funtzioa. Pubertaroa
Konpetentziak lantzeko ariketak
Konpetentziak lantzeko ariketak
1. hiruhilekoaren berrikuspena: 3. eta 4. unitateak. STEAM: Rita Levi-Montalcini
DIZIPLINARTEKO PROIEKTUA · Kutxa magikoa eta haren zaintza: Kutxa magikoaren misterioa
• Materia eta haren propietate orokorrak
• Dentsitatea eta flotagarritasuna
• Materiaren egitura. Atomoak
• Energia, haren ezaugarriak, energia motak eta aldaketak
• Energia-iturriak eta energia-iturri motak
• Elektrizitatea eta magnetismoa
• Erliebea eta haren aldaketak
• Espainia: erliebearen kokapena eta ezaugarriak
• Planetako urak: hidrosfera
• Ibaiak eta gainerako ur kontinentalak
• Espainiako hidrografia
• Materiaren egoerak eta haien aldaketak
• Nahasteak, nahaste motak eta haien osagaiak bereizteko metodoak
• Energia behar bezala erabiltzen dugu?
• Aerodinamika, errodadura eta flotagarritasuna: oinarrizko printzipioak
• Proiektuak eta bideojoko bat egiten
• Penintsulako erliebea
• Kostaldeetako erliebea
• EAEko erliebea
• EAEko hidrografia
• Europako hidrografia
• Uraren kontsumo arduratsua
Konpetentziak lantzeko ariketak
Konpetentziak lantzeko ariketak
2. hiruhilekoaren berrikuspena: 5. eta 6. unitateak. STEAM: Hedy Lamarr eta Émilie du Châtelet
• Europa: erliebearen kokapena eta ezaugarriak
Konpetentziak lantzeko ariketak
Konpetentziak lantzeko ariketak
2. hiruhilekoaren berrikuspena: 7. eta 8. unitateak
DIZIPLINARTEKO PROIEKTUA · Orain edo inoiz ez: Nik, zuk, guk... Denok ekin!
• Ekonomia-jarduerak
• Kontsumitzaileak gara
• Enpresak eta enpresa motak
• Aro Garaikidearen hasiera
• Fernando VII.aren erreinaldia. Azkeneko errege absolutista
• Alfontso XIII.aren erreinaldia eta II. Errepublika
• Gerra Zibila eta Francoren diktadura
• xix mendeko ekonomia- eta gizarte-aldaketak
• xix mendeko kultura eta artea
• Ekonomia-sektoreak. Lehen sektorea
• Bigarren sektorea
• Hirugarren sektorea
• Isabel II.a eta Seiurteko Iraultzailea
• Borboiko etxearen Berrezarkuntza
• EAE xix mendean
• Demokrazia iritsi zen
• Espainia Europar Batasunean
• EAE xx eta xxi mendeetan
• xx -xxi mendeetako ekonomia eta gizartea
• xx eta xxi mendeetako kultura eta artea
• Aro Garaikideko gertaerak eta pertsonak
• EAEko ekonomia-sektoreak
• Ekonomia-sektoreak Europan
Konpetentziak lantzeko ariketak
• xix mendeko gertaerak eta pertsonak
Konpetentziak lantzeko ariketak
3. hiruhilekoaren berrikus.: 9. eta 10. unitateak
• xx eta xxi mendeetako gertakari eta pertsona ospetsuak
Konpetentziak lantzeko ariketak
Konpetentziak lantzeko ariketak
3. hiruhilekoaren berrikuspena: 11. eta 12. unitateak
PROYECTO INTERDISCIPLINAR - Aprender de lo natural
DIZIPLINARTEKO PROIEKTUA · Birika berdea: Itzaltzea baino, saihestea hobe
JAKITEA... IKASTEKO, APLIKATZEKO ETA IKERTZEKO
BIZIRAUPEN-PLANA
ZER BEHAR DUT?





IDEIAK




– Bi esku-argi ditut: bata, biradera bati eraginez kargatzen da eta, besteak, eguzki-plakatxo bat du.
– Bainugelan, bost kandela usaindun eta hamasei pospolo dituen kutxa txiki bat dauzkagu.
– Eguzki-argia dugu egunez.
– Gure etxea hondartzatik hurbil dagoenez, laguntza eskatzeko mezuak itsasora jaurti ditzaket. Zorte pixka batekin, olatuek eraman eta baten batek aurkituko ditu. – Kometa handi samar bat daukat, eta haizea dabil. Laguntza-mezu bat idatz dezaket bertan, eta zeruan hegaldarazi.
Despentsako elikagaiak berotzea
– Eguzki-labe bat egin dezaket paperarekinaluminioeta kaxa batekin. Udalekuetan ikasi nuen hori egiten.

Bideojoko bat egingo dut, urratsez Bloke bidezko programazioa 7 Energia eta
Marruskadurari, murgilketari eta errodadurari buruzko proiektu teknologikoak 6 Energia behar bezala erabiltzen dugu? Energiaren erabilerak eragiten dituen arazoak 5 Magnetismoa Imanak eta haien erabilerak 3 4 Energia-iturri etaberriztagarriakberriztaezinak Energia-iturriak eta energia-iturri motak 7
mugimendua
Argia
Laguntza eskatzea
Proiektu honek ikasturteko eduki guztiak eskaintzen dizkizu, bai liburu digitalaren bidez, bai era askotako baliabideen bidez.
Ikasteko beste modu bat ezagutuko duzu, erraza, intuitiboa eta edozein plataforma eta gailurekin bateragarria.
4 Nola sailkatzen dugu materia? Agregazio-egoerak
Materia egoeraz aldatzen da
Materiak aldaketa fisikoak izan ditzake. Halako aldaketetan, materiak jatorrizko itxura aldatzen du, baina ez bere konposizioa.
Aldaketa fisiko ohikoenak materia berotzean edo hoztean gertatzen dira. Hain zuzen, tenperatura-aldaketaren ondorioz, materiaren agregazio-egoera aldatu egiten da.

Materia berotzean edo hoztean, materiaren egoerak (solidoa, likidoa edo gasa) aldaketa itzulgarriak izaten ditu; materiaren egoera-aldaketak dira horiek.

Materiaren egoera-aldaketak itzulgarriak dira. Horrek esan nahi du solido bat, berotzean, likido bihurtuko dela, eta likido hori bera, hoztean, berriz ere solido bilakatuko dela. Horixe bera gertatzen da gainerako egoera-aldaketekin ere. Egoera-aldaketa gertatu bitartean, tenperatura konstante mantentzen da.

Aldaketa-egoeren izenak
Sublimazioa
Izotz solidoa
2 Osatu esaldia koadernoan. ... konstante mantentzen da, ... gertatu bitartean.
Alderantzizko sublimazioa
Atmosferako ur-lurruna
Ur likidoa
haren tenperatura astiro ... da.


6. Tenperatura igotzen den heinean, likidoan burbuilatxo batzuk agertzen hasi dira.
4 Berdina al da Espainiako kostalde osoa?

Nola sartu?
Zure liburuko lehenbiziko orrialdearekin batera aurkituko dituzu proiektu digitalean sartzeko behar dituzun argibide guztiak.


Kostalde atlantikoa
behar da; hau da, urak likido-egoeratik gas-egoerara aldatu behar du.
Kostalde mediterraneoa


136

Espainiako kostaldeak 5 970 km ditu gutxi gorabehera, Iberiar penintsularen, Balear eta Kanaria uharteen, eta Ceuta eta Melilla hirien artean banatuta. Kostalde atlantikoaren eta kostalde mediterraneoaren artean aldeak daude.



Kostaldea Kokapena Ezaugarriak
KantauriarraBidasoa ibaiaren bokalean hasten eta Ortegal lurmuturreraino iristen da.
Galiziakoa Ortegal lurmuturrean hasten eta Miño ibaiaren bokaleraino iristen da.
AndaluziakoaGuadiana ibaiaren bokalean hasten eta Gibraltarko itsasarteraino iristen da.

Hegoaldekoa Gibraltarko itsasartean hasten da eta Murtziako Eskualdearen eta Valentziako Erkidegoaren arteko hegoaldeko mugaraino iristen da.
Ekialdekoa Valentziakoa. Segura ibaiaren ibar beherean hasten eta Ebroren deltaraino iristen da.
Kostalde garaia, malkartsua, harritsua eta zuzena da.
Zer hartu behar dugu aintzat gure kostaldeetan ekonomia- jarduerak garatzeko? rraldeko Ezaugarriak: Balear Kokapena. kostaldearen Ezaugarriak:
Galiziako kostalde atlantikoaren iparraldea Rías Altas da, eta hegoaldea, Rías Baixas. Itsasadarrak tarteko, hain zuzen, kostaldea oso koskatua da, bai eta garaia eta harritsua ere.

Zuzena, baxua eta hareatsua da, eta hondartza handiak ditu.
Kostalde garaia, malkartsua, harritsua eta zuzena izateagatik nabarmentzen da.
Gata eta Palos lurmuturrak. Almeríako golkoa.
Gero eta ohikoagoa da influencerrek bizi garen natura-inguruneen egoera salatzea beren sare so-


Kostalde baxu eta hareatsua da, eta, oro har, hondartza handiak ditu.
Koskatua, garaia, malkartsua eta harritsua da. Creus lurmuturra. Rosesko golkoa.
Nau lurmuturra Kataluniakoa. Ebroren deltan hasten eta Frantziako mugaraino iristen da.
zialetan. Hona hemen, adibide modura, zenbait post, al hauetariko ATLANTIKOA BALEARRAK Major PORTUGAL FRANTZIA ANDORRA Kantauri OZEANO ATLANTIKOA M d t raneo itsa a Melilla itsasartea Almeríako golkoa Sant Jordi golkoa Valentziako golkoa Bizkaiko Cádizko golkoa Gibraltarko Ortegal lurmuturra Matxitxako Ajo Gata lurmuturra Palos lurmuturra lurmuturra Ebroren Trafalgar Ekhi_lore Euskadiko kostaldean pasieran ibili, eta hau aurkitu ez dugu, ba? Oporrak horrela? Gero, zikinkeria hori guztia Kantauri itsasora iritsiko da. #bizitzajasangarria #horrelaez Ekhi_lore Head_JL Hauxe egiten diogu etengabe Baixas maiteari. Bihotzak krak egiten #stopplastikoak #bizitzajasangarria Head_JL Kantauriko kosta Andaluziako kosta atlantikoa Atlantikoko kosta
Honelakoa da zure proiektu digitala 102 103
Kondentsazioa Solidotzea Lurrunketa Urtzea
Kanaria uharteetako erliebea Kokapena. Ozeano Atlantikoan daude, Afrika iparraldeko kostaldearen parean. Ezaugarriak: Erliebea. Menditsua eta sumendijatorrikoa da, eta, hori dela eta, oso paisaia berezia dute. Tenerife uhartean dago Espainiako mendirik altuena: Teide (3 718 m). Kostaldea. Oro har, kostaldea altua, malkartsua eta koska handirik gabea da, baina uharteetako hegoaldean hondartzak daude: ekialdekoak harrizkoak dira, eta mendebaldekoak, hareazkoak.

Balear uharteetako erliebea Kokapena. Mediterraneo itsasoan dago, Valentziako kostaldearen parean. Ezaugarriak: Erliebea. Oro har, menditsua eta Penintsulako erliebearen antzekoa da. Mallorca, Eivissa eta Formenteran, erliebea Mendikate Penibetikoaren luzakin bat da, eta Menorcan, Kataluniako kostaldeko mendikatearena. Uharteetako mendi garaiena, Puig Major (1 445 m), Mallorcan dago, Tramuntana


Nolakoa da?
Erantzun globala era askotako hezkuntza-ingurune baterako.
Intuitiboa
Zuk erraz erabiltzeko modukoa.
Gailu anitzekoa
Edozein gailu motatan (ordenagailuan, tabletan, smartphonean…) egokitzen eta ikusten da, pantailaren edozein tamaina eta bereizmenetan.

Deskargagarria

Aukera ematen du Interneteko konexiorik gabe lan egiteko eta gailu batean baino gehiagotan deskargatzeko.

Sinkronizagarria
Erabiltzaileak egiten dituen aldaketak berez sinkronizatzen dira, lan egiteko erabilitako edozein gailu konektatzean.
Unibertsala
U7 137
Zer eskaintzen dizu?
Era askotako baliabideak ditu; paperezko liburuaren erreprodukzioa baino askoz gehiago da.
Honakoak egiteko aukera izango duzu:

Ariketak egin ariketa elkarreragileak
Aztertu laburpen elkarreragileak, eskemak...
Ikasi
audioak, bideoak, Game Room-ak...
Ebaluatu autoebaluazioa, portfolioa...
Bateragarria da ikastetxeetan gehien erabiltzen diren sistema eragileekin, ikaskuntzako inguru birtualekin (IIB) eta hezkuntza-plataformekin (LMS).
ere Mallorca eta
post, arazo horren berri ematen dutenak. Jakingo zenuke esaten zer kostaldetan atera den argazki hauetariko bakoitza? etengabe gure Rías egiten dit. Princess_cons19 Konponbideak behar ditugu Mar Menor salbatzeko. kostaldeak ez du hau merezi. #bizitzajasangarria #SOSmarMenor Princess_cons19 mediterraneoa: Levantekoa Mediterraneoko
mendilerroan. Kostaldea. Garaia eta koskatua da, eta kalak ditu, batez
Menorca iparraldean.
5 Materia ezagutuz
Aurrera, bada! Aurten plater errazak kozinatzen ikasteko asmoa dut. Hala, gurasoak beste zerbaitetan ari badira, nerau arduratu naiteke egiteko horretaz (eta ez naiz gosez hilko haiek zereginak amaitzen dituzten bitartean...). Sekula platerik kozinatu ez dudanez, errezeta erraz eta jasangarri bat erakusteko eskatu diot aitonari.
Dena gertu dugu errezeta prestatzen hasteko! Ea ez dugun etxea erretzen…
Zer deritzozu?


Kozinatu al duzu inoiz?
Ondo joan zitzaizun? Anderrek hautatu duen errezeta oso-osorik ulertzen duzu?
Zer unitatetan neurtu dituzte osagaien kantitateak? Zergatik ez da beti unitate bera erabiltzen?
Erreparatu datuari. Anderren platera jasangarria dela iruditzen zaizu? Bururatzen al zaizu beste adibiderik?
Datua
Platerik jasangarrienak bertako landare-produktuak erabiltzen dituztenak dira, izan ere, baliabide natural gutxiago behar dira elikagai horiek ekoitzi eta garraiatzeko.

Unitate honetarako...
Helburua aurrera
Gure plater gustukoenen errezetak aztertuko ditugu, haietan materia nola erabiltzen den jakiteko.
Jarraitu hariari!
Masa eta bolumena
1
Materia eta haren propietate orokorrak
Dentsitatea eta flotagarritasuna
2
Materiaren propietate espezifikoak
92
TOMATE-SALTSAREKIN
Osagaiak
Arroza - 100 g




Ura - 500 mL


Gatza - apur bat
Platanoa - ale 1
Tomate-saltsa - 150 mL



Oliba-olio birjina estra - 3 koilarakada
Jarraibideak
1. Jarri ura, arroza eta gatza kazola batean, eta berotu su bizian urak irakin arte.
2. Jaitsi sua, eta utzi arroza su ertainean egosten ura erabat lurrundu arte. Ondoren, bota tomate-saltsa, eta eragin arrozari, osagaiak ondo nahas daitezen.

3. Arroza egiten den bitartean, bota olio txorrotada bat zartagin batean, eta berotu su bizian. Jarri bertan erditik moztutako platanoa, eta frijitu 2 minutuz alde bakoitzetik, bigundu eta horitu dadin.
4. Zerbitzatu arroza platerean, ipini platanoa gainean, eta… jatera!
Materiaren egoerak eta egoera-aldaketak
Nola sailkatzen dugu materia? Agregazio-egoerak
Nahasteak, nahaste motak eta osagaiak bereizteko metodoak
Nola sailkatzen dugu materia?
Substantzia puruak eta nahasteak
93
3
Nolakoa da materia? Atomoak
5
4
ARROZA
ETA PLATANOAREKIN
2
Materia eta haren propietate orokorrak

Edozein errezetako osagaiak materiaz osatuta daude.
Ondo kozinatzeko, osagai horiek nola neurtzen diren eta zer propietate dituzten jakin behar dugu.
Materia





Materia masa eta bolumena dituen gai oro da.
Materia era askotakoa da (ura, airea, burdina eta abar). Materia mota bakoitza aztertzeko, beharrezkoa da materiaren beraren propietateak ezagutzea.
Materiaren propietateak, hain zuzen, neurtzeko tresna edo aparatuen bidez neur daitezkeen ezaugarriak dira.
Materiaren edozein propietate neurtzen dugunean, zenbaki baten bidez eta propietate bakoitzari dagokion unitate baten bidez adierazten den magnitude bat erabiltzen dugu.
Materiak bi propietate mota ditu: orokorrak eta espezifikoak.
Propietate orokorrak
Propietate orokorrak edozein materia motari dagozkie, eta ez dute balio materia motak elkarren artean bereizteko.
Propietate orokorrak, besteak beste, masa, bolumena, luzera, azalera eta tenperatura dira.
Masa eta bolumena
Masa gorputz batek duen materia kantitatearen neurria da.
Balantzak edo baskulak erabiliz neurtzen da, gorputzaren masa ezarritako masa-unitate jakin batzuekin alderatuta, hala nola gramoarekin edo kilogramoarekin.
Bolumena gorputz batek betetzen duen espazio kantitatearen neurria da.
Ontzi graduatuen bidez neurtu eta metro kubikotan (m³), zentimetro kubikotan (cm³) eta abar adierazten da.
Substantziak
Substantzia bat materia mota jakin bat da, konstante mantentzen diren propietateak dituena. Hain zuzen, propietate horiei esker bereizten da gainerako substantzietatik. Esaterako, ura eta gatza bi substantzia desberdin dira, haien propietateak desberdinak direlako.
Edukiera

Ontzi jakin batek izan dezakeen gehienezko bolumena da. Gehienetan, litrotan (L), mililitrotan (mL) eta abar adierazten da. 1 L-eko edukiera eta 1 dm³-eko bolumena baliokideak dira.
1 Begiratu neurtzeko tresnei buruzko baliabidea, anayaharitza.es webgunean. Ondoren, adierazi aparatu hauen izenak, eta azaldu zertarako erabiltzen diren.
94
1
1 2 3
Begira nola pentsatzen dudan
Neurrien algoritmoa




Nola neurtzen da likidoen masa?
Solidoen masa neurtzea nahiko erraza da: balantza bat eskura izatea baino ez dugu behar.
Baina… nola neur dezakegu likido baten masa?
Likidoa balantzan jarriko bagenu, isuri egingo litzateke, ezta?
Hori horrela, likido baten masa neurtzeko pisaldi bikoitzaren metodoa balia dezakegu.
1 Erreparatu prozesuaren urratsak erakusten dituzten irudiei. Ondoren, idatzi prozesuaren algoritmoa.
Objektu irregularren bolumena neurtzea
Forma geometriko erregularrak dituzten objektuen bolumena neurtzea (hala nola kuboak, konoak edo zilindroak) erraza da. Izan ere, badaude formula matematiko batzuk, objektu horien ertzen, altueraren, erradioaren eta abarren balioak jakinda, bolumena kalkulatzeko aplika daitezkeenak.

Hortaz, arazoa forma irregularrak dituzten objektuen bolumena kalkulatzeko orduan sortzen da. Esate baterako, ibai batean topatu dugun harrikoskor baten bolumena neurtu nahi dugunean.
Nola neurtzen da objektu irregularren bolumena?
Irakurri algoritmoa, eta begiratu irudiei, prozesuaren urratsak ezagutarazten baitituzte.
1 Zer bolumen du irudiko harri-koskorrak?
2 Probetetako balioak mL-tan daude adierazita. Cm³-tan baleude, zer balio markatuko luke probeta bakoitzak?
3 Pablok bi kanika ditu, bata, kristalezkoa eta bestea, altzairuzkoa. Haren ustez, biek bolumen eta masa bera dute. Zuzen al dabil Pablo?
Azaldu nola egiaztatuko zenukeen haren ustea zuzena ala okerra den?
Algoritmoa


1. Ontzi graduatu bat (probeta bat) likido batekin beteko dugu (ura izan ohi da) bolumen jakin bateraino. V1 bolumena izango da hori.
2. Objektu irregularra probetan sartu eta urak betetzen duen bolumenaren balio berria idatziko dugu. V2 bolumena izango da hori.
3. Objektu irregularraren bolumena kalkulatzeko, V2 balioari (uraren bolumena + objektu irregularra) V1 balioa (uraren bolumena) kendu behar zaio.
Vobjektua =V2 – V1
Errezeta prestatzeko, Anderrek osagaien masa- eta bolumenneurriak kalkulatu beharko ditu (100 g arroz, 500 mL ur…).

95 U5
1 2 3
Gogoan hartu!
V2 V1
Materiaren propietate espezifikoak
Nola bereizten dira ura eta olioa? Biak likidoak izanik, nola jakin dezakegu zein den zein?
Propietate


espezifikoak
Propietate orokorrez gain, materiak beste propietate mota batzuk ditu, propietate espezifikoak, alegia, eta haiei esker substantziak elkarren artean bereizi ditzakegu.
Propietate espezifikoei esker, substantzia motak bereizi ditzakegu.
Besteak beste, honako hauek dira propietate espezifikoak: dentsitatea, tenperatura (substantzien irakite- edo urtze- tenperatura), gogortasuna, elastikotasuna, biskositatea, kolorea, distira, gardentasuna, eroankortasuna eta abar. Adibidez, burdinaren, granitoaren eta uraren dentsitate-, gogortasun- eta eroankortasun-balioak desberdinak dira.
Dentsitatea
Objektu baten dentsitatea objektu horren masaren eta hark betetzen duen bolumenaren arteko erlazioa da.
Dentsitatea (d) = Masa (m) / Bolumena (V)

Dentsitatea kg/m³-tan, g/cm³-tan... adierazten da.
Substantzia bakoitzak berezko dentsitatea du, eta gainerako substantzien dentsitateaz bestelakoa da.
Esate baterako, burdinaren dentsitatea 7,8 g/cm³ da, eta urarena, berriz, 1 g/cm³. Horrek esan nahi du 1 cm³-eko bolumena betetzen duen burdinak 7,8 gramoko masa duela, eta uraren bolumen horrek berak 1 gramoko masa duela.
1 Osatu esaldia zure koadernoan.
Materiaren propietate espezifikoei esker, ... motak ... ditzakegu.
2 5 cm³-ko bolumena betetzen duen aluminiozko kanika batek 13,5 g-ko masa du. Eta bolumen bera duen urrezko kanika batek, aldiz, 96,5 g-ko masa du. Hori horrela, zer materia motak du dentsitate handiagoa: aluminioak ala urreak?
Honela kalkulatzen da objektu irregularren dentsitatea
Objektu irregular baten dentsitatea jakiteko, haren bolumena eta masa kalkulatu behar ditugu.
Objektu irregularren bolumena kalkulatzen ikasteko baliatu dugun harri-koskor hori bera erabiliko dugu oraingoan ere.
Honako algoritmoa hau aplikatuko dugu:
1. Harri-koskorraren masa kalkulatuko dugu, balantza bat erabilita.
150 g
2. Objektuaren bolumena neurtuko dugu, aurreko orrialdean aplikatu dugun metodoaren bidez.
3. Objektuaren dentsitatea kalkulatzeko, formula hau aplikatuko dugu: d = m / V.
Hauxe da formula gure harri-koskorraren kasuan: d = 150 g / 50 cm³ = 3 g / cm³


96
2
Flotagarritasuna


Aurreko ikasturteetan, beste hainbat propietate espezifiko daudela ikasi zenuen, hala nola gogortasuna, hauskortasuna, elastikotasuna, eroankortasun elektrikoa edo termikoa, biskositatea eta konprimagarritasuna. Beste propietate garrantzitsu bat, hain zuzen, dentsitatearekin lotuta dagoena, flotagarritasuna da.
Flotagarritasuna substantzia edo objektu batek likido edo gas baten gainazalean egoteko duen gaitasuna adierazten duen propietatea da.
Objektu batek likido batean flotatzen du, likidoarena baino dentsitate txikiagoa badu. Arrazoi horrexegatik, objektua hondoratu egiten da, likidoarena baino dentsitate handiagoa badu.
Zenbat eta handiagoa den objektuaren eta likidoaren dentsitateen arteko aldea, orduan eta handiagoa da objektuaren flotagarritasuna.
Biskositatea
Substantzia batek mugitzeari edo jariatzeari egiten dion erresistentzia (edo mugitu edo jariatzeko duen zailtasuna) adierazten du. Likidoegoeran dagoen materiaren propietate esanguratsua da. Likido bat biskosoa da, nekez jariatzen bada.
Konprimagarritasuna
Substantziek presio jakin baten eraginpean haien bolumena txikitzeko duten propietatea da. Substantzia konprimagarri deritze konprimatzeko errazak direnei, hala nola gasei, eta bonbona, andela eta abarretan... gorde daitezke.



Proiektu bat egingo dut: arroza garraiatzen duen baltsa bat
Flotagarritasuna zertan den egiaztatzeko, esperimentu hau egingo dugu. Elementu hauek behar dituzue: palankana bat, beirazko ontzi bat, aluminio-papera, ura, gatza, arroza eta balantza bat.

Errepikatu esperimentua, palankanako urari gatza botaz (segi gatza botatzen harik eta disolbatzen ez den arte).
1 Zer kasutan behar izan dugu arrozaren masa gehiago, baltsa hondoratzen hasteko?


2 Zure ustez, zergatik da hori horrela? Galderari erantzuteko, pentsatu nola aldatu den palankanako uraren dentsitatea bertan botatako gatzaren eraginez.
3 Demagun arroza garraiatzen duen merkataritza-ontzi bateko kapitaina zarela. Non flotatuko du hobeto zure ontziak: ibai batean ala itsasoan nabigatzen?
Urak eta olioak dituzten propietate espezifikoei esker, argi eta garbi bereizi ditzakegu.
97 U5
hartu!
Gogoan
Beste propietate espezifiko batzuk
Jarri baltsa palankanan.
Bota arroza baltsan hondoratzen hasten den arte.
Jaso arroza beirazko ontzian. Kalkulatu arrozaren masa.
Aluminiozko erretilu bat
Nolakoa da materia?
Hain zuzen, arroza, ura eta gatza oso osagai
desberdinak dira. Zerk eragiten ditu haien arteko aldeak? Gauza desberdinez «eginak» ote daude?
Materiaren egitura







Orain arte, materiari buruz aritzeko, haren propietate orokorrak aztertu ditugu. Baina zerez osatuta dago materia?

Materia gero eta zatitxo txikiagotan zatikatuko bagenu, azkenean partikula txiki-txiki batzuk eskuratuko genituzke. Partikula horiei atomo deritze.
Materia atomo deritzen partikula ezin txikiago batzuez osatuta dago.
Hori horrela, atomoa materia osatzen duen oinarrizko unitatea dela esan dezakegu.
Berdinak al dira materia osatzen duten atomo guztiak?
Airea, mendiak, ura, frutak... Gure unibertsoa osatzen duen materia oro atomoz egina dago.

Kontua da atomo guztiak ez direla berdinak: hain zuzen, atomo mota asko daude, eta hamaika modutan konbina daitezke. Arrazoi horregatik da hain desberdina eta hain propietate anitzekoa inguratzen gaituen materia.
1 Osatu zure koadernoan esaldi hau:
Atomoa ...ren ... gordetzen dituen haren ...rik txikiena da.
2 Batu Gizakiok atomoz osatuta gaude? Arrazoitu zuen erantzunak.


Atomoei buruz gehiago jakiteko, «Berehala kontatuko dizut», anayaharitza.es webgunean.
Gogoan hartu!
Askotariko materia motak era askotako atomoen konbinazioek osatzen dituzte.
98
3
Irudiko eraztuna osatzen duten atomoak desberdinak dira…
… minerala (kuartzoa) osatzen duten atomoekin alderatuta...
… eta brontzeko estatua osatzen duten atomoekin alderatuta.
Nola sailkatzen dugu materia?
Agregazio-egoerak
Kozinatzean, osagai solidoak eta likidoak erabiltzen ditugu batez ere. Baina… bururatzen al zaizu egoeraz aldatzen den osagairen bat?
Materiaren egoerak







Materia agregazio-egoera kontuan hartuta sailkatu daiteke. Alderdi horri begira, materia solidoa, likidoa edo gasa izan daiteke.
Halere, gaur egungo adituek aurkitu dute materia beste agregazio-egoera batzuetan ere egon daitekeela, hala nola plasmaegoeran.
Materia sailkatzeko beste irizpide batek substantzia mota bakarrez (substantzia puruak) edo substantzia mota bat baino gehiagoz (nahasteak) osatuta dagoen hartzen du kontuan.

1 AGA Zure ustez, zergatik da errazagoa gasak konprimatzea solidoak baino?
Solidoek berezko forma eta bolumena dituzte. Horrek esan nahi du, solido bat ontzi batean sartuz gero, haren forma eta bolumena ez direla aldatuko.
Solidoak ez dira hedatzen, ezta konprimatzen ere. Solidoak osatzen dituzten atomoak elkarri oso lotuta daudelako gertatzen da hori.
Likidoek berezko bolumena dute, baina ez berezko formarik, eta, hori dela eta, likido bat ontzi batean isurtzen badugu, ontziaren formara moldatuko da.
Likidoek hedatu eta konprimatzeko gaitasuna dute, baina aldaketa horiek nekez antzeman daitezke.
Likidoak osatzen dituzten atomoen arteko loturak ez direlako oso sendoak gertatzen da hori.
Gasek ez dute ez berezko formarik, ez berezko bolumenik. Hortaz, gas bat ontzi batean sartuz gero, haren forma eta bolumena ontziaren formara eta bolumenera moldatuko dira.
Gasek espazioak erabat betetzeko joera dute: horrexegatik hedatzen eta konprimatzen dira hain erraz. Gasak osatzen dituzten atomoen arteko loturak oso ahulak direlako gertatzen da hori.

99 U5
Solidoen, likidoen eta gasen ezaugarriak
4
Nola sailkatzen dugu materia?
Agregazio-egoerak
Materia egoeraz aldatzen da
Materiak aldaketa fisikoak izan ditzake. Halako aldaketetan, materiak jatorrizko itxura aldatzen du, baina ez bere konposizioa.
Aldaketa fisiko ohikoenak materia berotzean edo hoztean gertatzen dira. Hain zuzen, tenperatura-aldaketaren ondorioz, materiaren agregazio-egoera aldatu egiten da.

Materia berotzean edo hoztean, materiaren egoerak (solidoa, likidoa edo gasa) aldaketa itzulgarriak izaten ditu; materiaren egoera-aldaketak dira horiek.
Materiaren egoera-aldaketak itzulgarriak dira. Horrek esan nahi du solido bat, berotzean, likido bihurtuko dela, eta likido hori bera, hoztean, berriz ere solido bilakatuko dela. Horixe bera gertatzen da gainerako egoera-aldaketekin ere.
Egoera-aldaketa gertatu bitartean, tenperatura konstante mantentzen da.
Aldaketa-egoeren izenak
Sublimazioa
2 Osatu esaldia koadernoan. ... konstante mantentzen da, ... gertatu bitartean.
Izotz solidoa

100 4
Kondentsazioa Solidotzea Lurrunketa Urtzea Alderantzizko sublimazioa
Ur likidoa Atmosferako
ur-lurruna
Nire lanbidea: fisikaria
Laborategian, Eduk esperimentu bat diseinatu du Lehen Hezkuntzako 6. mailako ikasleentzat, oso ohiko substantzia baten egoera-aldaketak deskribatzeko. Erreparatu arretaz egoera-aldaketei buruzko grafikoari, eta osatu zuen koadernoan Eduren laborategiko oharrak.

Kaixo, Edu dut izena, eta fisikaria naiz. Fisikariok materiaren zale amorratuak gara, eta hari buruzko hainbat gai aztertzen ditugu: zer egitura duen, nola mugitzen den, nola erlazionatzen den energiarekin, nola jokatzen duen aldaketa fisikoak gertatu bitartean eta abar. Gure aurkikuntzei esker, izaki bizidunon, Lurraren eta unibertsoaren funtzionamenduaren alderdi asko azaldu daitezke.
1. Aztergai dugun substantzia –20 °C-an dagoen izozkailu batetik atera dugu. Substantzia ...-egoeran dago.

2. Substantzia berotu dugu, eta, hori dela eta, haren tenperatura astiro ... da.
3. Substantzia 0 °C-ra iritsi denean, solidoegoeratik ...-egoerara aldatzen hasi da. Horixe da substantziaren ...-tenperatura.


4. Egoera-aldaketa hori gertatu bitartean, tenperatura ez da ... .
5. Orain substantzia guztia likido-egoeran dago. Substantzia berotzen jarraitu dugu, eta haren tenperatura astiro ... da.
6. Tenperatura igotzen den heinean, likidoan burbuilatxo batzuk agertzen hasi dira.
7. Substantzia 100 °C-ra iritsi denean, ... bihurtzen hasi da. Horixe da, hain zuzen, substantziaren ...-tenperatura.
8. Egoera-aldaketa hori gertatu bitartean, tenperatura ez da ... .
9. Substantzia berotzen jarraitu dugu.
10. 120 °C-an, substantzia guztia ...-egoeran dago.


Anderren errezetaren arabera, ura, irakin ondoren, lurruntzen utzi behar da; hau da, urak likido-egoeratik gas-egoerara aldatu behar du.

101 U5
hartu!
Gogoan
Denbora 100 0 Solidoa Solidoa eta likidoa Likidoa Likidoa eta gasa Gasa
Solidoa Likidoa Gasa
Nola sailkatzen dugu materia? Substantzia puruak eta nahasteak
Bizkotxo bat, entsalada bat edo patata-tortilla bat era askotako osagaiez osatutako nahasteak
baino ez dira.
Substantzia puruak
Substantzia puruak materia mota bakar batez osatutakoak dira.
Substantzia puruek osagai bakarra dutenez, haien propietate espezifikoak (dentsitatea, gogortasuna eta abar) berdin-berdinak izango dira substantziaren edozein pusketa aztertuta ere.
Gainera, haien propietate espezifikoei esker, beste materia mota batzuetatik bereizi ditzakegu. Substantzia puruen adibide batzuk dira oxigenoa, karbonoa, ura eta gatza.

Nahasteak
Nahasteak bi substantzia pururen edo gehiagoren arteko konbinazioak dira.
Materiaren propietate espezifikoak, hala nola dentsitatea, materia osatzen duten osagaien proportzioaren arabera aldatzen dira.

Nahaste motak
Nahasteak bi motatakoak dira: homogeneoak eta heterogeneoak.
• Nahaste homogeneoetan, osagaiak ez dira begi hutsez hautematen. Halako nahasteei disoluzio ere esaten zaie.

• Nahaste heterogeneoetan, osagaiak begi hutsez hautematen dira.
Nahasteak hiru agregazio-egoeretan egon daitezke:
• Nahaste gaseosoak, hala nola airea.
• Nahaste likidoak, hala nola itsasoko ura.
• Nahaste solidoak, hala nola brontzea, bi metalen (kobrea eta eztainua) nahastea baita. Metalez osatutako nahasteei aleazio deritze.
Nahasteak Homogeneoak Heterogeneoak





1 Erreparatu gaineko eskemari, eta azaldu zergatik diren substantzia puruak kobrea eta gatz arrunta, eta zergatik diren nahasteak hondartzako harea eta brontzezko estatua.
2 Bilatu odolari buruzko informazioa, eta esan nahaste homogeneoa ala heterogeneoa den.
102
5
Substantzia puruak
Gatz arrunta Kobrea
Brontzezko estatua
Hondartzako harea
Nahaste bateko osagaiak bereizteko metodoak
Hainbat metodo daude nahaste bat osatzen duten substantziak bereizteko.
Nola bereizi daitezke nahaste bateko osagaiak?
Iragazketa


Paperezko filtroa
Inbutua

Solido batez eta likido batez osatutako nahastea
Solidoa
Lurrunketa
Solido batez eta likido batez osatutako nahastea
Lurruna
Lurrunketa

Solidoa
Likidoa
Osagaiak bereizteko, nahastea osatzen duten partikulen tamaina desberdinak baliatzen ditu. Oro har, solido batez eta likido batez osatutako nahaste bateko osagaiak bereizteko erabiltzen da.
Dekantazioa
Dekantazioinbutua
Olioaren eta uraren nahastea
Osagaiak bereizteko, nahastearen osagaien lurrunketatenperatura desberdinak baliatzen ditu. Likido batean solido bat disolbatuta duen disoluzio bat bereizteko erabiltzen da. Nahastea berotzean, likidoa lurrundu egiten da, eta osagai solidoa geratzen da.
Destilazioa
Olioa
Osagaiak bereizteko, nahastea osatzen duten partikulen dentsitate desberdinak baliatzen ditu. Dentsitate desberdinekoak eta elkarren artean disolbaezinak diren bi likido bereizteko erabiltzen da, hala nola, olioa eta ura.
Nahastea


Hozgarria
Lurruna
Likido purua
Osagaiak bereizteko, nahastearen osagaien lurrunketatenperatura desberdinak baliatzen ditu. Likidoen disoluzio bateko osagaiak bereizteko erabiltzen da, hala nola petrolioaren osagaiak bereizteko. Horretaz gain, likido puruak eskuratzeko erabiltzen da, hala nola, ur destilatua.
3 Nola bereiziko zenituzke nahaste hauetako osagaiak?
Ura eta kafe ehoa; itsasoko ura; alkohola eta ura.

Gogoan hartu!
Zure ustez, zer da arrozaren eta tomate-saltsaren arteko nahastea: homogeneoa ala heterogeneoa?
103 U5
Ura
Z er ikasi dut?
1 Zertan dira desberdinak materiaren propietate orokorrak eta espezifikoak?
2 Osatu taula termino hauekin:
Metro kubikoak, balantza, materia kantitatea, betetzen duen espazioa, kilogramoak, probeta

7 Erreparatu argazkiari, eta erantzun galderei.
3 Adierazi esaldi hauek zuzenak ala okerrak diren, eta zuzendu koadernoan okerrak direnak.
a) Masa materiaren propietate espezifiko bat da.
b) Bolumena objektu batek duen materia kantitatea da.
c) Bolumena matraze aforatuen bidez neurtzen da.
d) Kilogramoa bolumena neurtzeko unitatea da.


e) Gogortasuna, kolorea, distira eta abar materiaren propietate orokorrak dira.
4 Erreparatu irudi hauei:
a) Zure ustez, zer dela eta flotatzen du arrautzak B irudian? Zer gertatu da?
b) A irudian, zer elementuk du dentsitate handiagoa: arrautzak ala urak? Eta B irudian?
5 Substantzia baten 12 gramok 4 cm³-ko bolumena betetzen dutela jakinik, kalkulatu substantziaren dentsitatea.
6 Objektu baten dentsitatea 1,3 g/cm³ dela eta 5 cm³-ko bolumena betetzen duela jakinik, zein da objektuaren masa?
a) Zer egoeratan dago ura?
b) Egoera-aldaketaren bat gertatzen ari da? Hala bada, azaldu zein den/diren.
8 Adierazi substantzia hauetako zein diren puruak, eta zein diren nahasteak.
a) Ura.
b) Itsasoko ura.

c) Airea.
d) Urrea.

e) Sufrea.
9 Demagun nahaste hauetako osagaiak bereizi behar dituzula. Zer metodo erabiliko zenuke kasu bakoitzean?
a) Dentsitate desberdinak dituzten bi likidoz osatutako nahaste heterogeneo bat.
b) Urez eta hareaz osatutako nahaste heterogeneo bat.
c) Lurrunketa-tenperatura desberdinak dituzten bi likidoz osatutako nahaste homogeneo bat, hala nola ura eta alkohola.
d) Urez, hareaz eta gatzez osatutako nahaste heterogeneo bat.
Ez ahaztu unitate honetako zure argazki-albuma osatzea, webgunean: anayaharitza.es
Semaforoa. Margotu koadernoan, ariketa bakoitzaren ondoan, honela:
erantzuna badakizu
laguntza behar izan baduzu
erantzuna jakin ez baduzu
104 PORTFOLIOA
Masa Bolumena
A B
HELBURUA AURRERA


Gure plater gustukoenen errezetak aztertuko ditugu, materia hobeto ulertzeko
1 Bilatu gustuko duzun plater baten errezeta. Ziurtatu haren jarraibide eta xehetasun guztiak ondo ulertzen dituzula. Inprimatu edo kopiatu errezetaren testua. Aukera baduzu, jaso bertan ageri diren irudiak ere.
2 Irakurri errezeta arretaz, eta saiatu unitate honetan ikasi dituzun kontzeptu zientifikoak hartan identifikatzen. Aztertu errezetaren bost alderdi hauek:
a) Bertan ageri diren masa-, bolumen- eta edukiera-neurriak.
b) Neurri horiek kalkulatzeko erabiltzen diren tresnak.
c) Bertan aipatzen diren materiaren propietateak eta egoerak.
d) Gertatzen diren egoera-aldaketak eta nola eragiten diren.
e) Nahaste homogeneoak eta heterogeneoak.
3 Ondoren, bikoteka, partekatu hautatu duzun errezeta zure kidearekin, eta azaldu bertan identifikatu dituzun kontzeptu zientifikoak. Erabili antolatzaile grafiko hau eredu gisa, kontzeptu bakoitzari buruz diozuna arrazoitzeko.
Deskribatu unitate honetako zer kontzeptu identifikatu dituzun zure errezetan.
Zer dela eta diozu hori?
Azaldu errezetaren zer ezaugarri direla eta (testua, argazkiak...) diozun hori.

Animatuko al zarete hautatu dituzuen errezetetako batzuk prestatzen eta platerak ikasgelara eramaten? Materiaz gozatzeko modu gozo-gozoa da hori!


N ola ikasi dut?
1 Seguru asko, unitatea lantzean, zenbait gauza erraz
ikasi dituzu, eta beste batzuk, berriz, gehiago kostatu zaizkizu. Idatzi zure portfolioan zer hiru gauza iruditu zaizkizun zailenak, eta azaldu zergatik.

2 Eskatu taldekideei talde-lanean nola aritu zaren ebaluatzeko, 1etik 10 era bitartean:
a) Kontuan hartu dituzu zure taldekideen iritziak eta iradokizunak, eta taldean hobeto aritzeko baliatu dituzu?
b) Hitz egiteko txandak errespetatu dituzu?
Ikastea gehien kostatu zaidana: Izan ere, ...
U5 105
?
6 Energia erabiltzen dugu
Egoera larria da benetan! Argindarra joan egin da! Etxea ilunpetan dago, ez dabil aparatu bakar bat ere, ez daukat telefono mugikorrik, eta, gauza guztietan okerrena, ez dugu Internetik!
Larrialdi honek pentsarazi egin dit... Zer egingo nuke, argindarra itzuliko ez balitz? Eta egoera horretan bakarrik banengo?
Biziraupen-plan bat behar dut! Badaezpada ere…
Zer deritzozu?


Elektrizitaterik gabe bizi behar izan duzu inoiz? Zertarako erabiltzen duzu argindarra zure egunerokoan?

Zer iruditzen zaizkizu elektrizitaterik gabe bizitzeko Uxoak idatzi dituen ideiak? Zure ustez, zein dira hobeak? Zergatik? Erreparatu datuari. Zure ustez, zergatik da hain handia herrialdeen arteko aldea, elektrizitatearen kontsumoari dagokionez?
Espainian, pertsonako batezbesteko elektrizitatearen kontsumoa, gutxi gorabehera, Brasilgo kontsumoaren bikoitza da, eta Indiakoa baino bost aldiz handiagoa.
Unitate honetarako...
Ikastetxea argindarrik gabe gelditu dela imajinatu eta Uxoarena bezalako biziraupen-plan bat egingo dugu.
Jarraitu hariari!
Energia, energia motak eta transformazioak Zer da energia?


1
Korronte elektrikoa 2
Elektrizitatea
106
Helburua aurrera
BIZIRAUPEN-PLANA
IDEIAK









– Bi esku-argi ditut: bata, biradera bati eraginez kargatzen da eta, besteak, eguzki-plakatxo bat du.
– Bainugelan, bost kandela usaindun eta hamasei pospolo dituen kutxa txiki bat dauzkagu.
– Eguzki-argia dugu egunez.
– Gure etxea hondartzatik hurbil dagoenez, laguntza eskatzeko mezuak itsasora jaurti ditzaket. Zorte pixka batekin, olatuek eraman eta baten batek aurkituko ditu.

– Kometa handi samar bat daukat, eta haizea dabil. Laguntza-mezu bat idatz dezaket bertan, eta zeruan hegaldarazi.
– Eguzki-labe bat egin dezaket aluminiopaperarekin eta kaxa batekin. Udalekuetan ikasi nuen hori egiten.
107 Bideojoko bat egingo dut, urratsez urrats Bloke bidezko programazioa 7 Energia eta mugimendua Marruskadurari, murgilketari eta errodadurari buruzko proiektu teknologikoak 6 Energia behar bezala erabiltzen dugu? Energiaren erabilerak eragiten dituen arazoak 5 Magnetismoa Imanak eta haien erabilerak 3 4 Energia-iturri berriztagarriak eta berriztaezinak Energia-iturriak eta energia-iturri motak 7
ZER BEHAR DUT? Argia
elikagaiak berotzea
Laguntza eskatzea Despentsako
Zer da energia?
direnean jabetzen gara benetan energia hainbat gauzatarako behar dugula, ezta? Baina zeri esaten diogu energia zehatz-mehatz?
Itzalaldiak gertatzen
Energia eta haren ezaugarriak
Ondo dakizun bezala, materia aldatu daiteke, baina aldaketa horiek gertatuko badira, ezinbestekoa da energia.
Energia esaten zaio materian aldaketak eragiteko gaitasuna duen orori.
Energiaren ezaugarriak



• Energia era askotara ager daiteke. Energia mota batzuk beste energia mota bihurtu daitezke. Esate baterako, lanpara bat pizteko etengailua sakatzen dugunean, energia elektrikoa eraldatu eta argi-energia bilakatzen da.
• Energia sortu, metatu eta garraia daiteke gizakiek xede horretarako eratutako gailuetan, hala nola piletan eta baterietan.
Energia eta energia motak
Hona hemen energiak agertzeko dituen modu batzuk:
• Energia zinetikoa. Mugitzen ari diren objektuek duten energia da, hala nola, auto batek, haizeak edo urak ibai-laster batean behera.
• Energia elektrikoa. Modu naturalean sortzen da ekaitzetan, tximistak eratuz. Artifizialki ere sortu daiteke, zentral elektrikoetan, hain zuzen; eta, gero, gure etxeetara, fabriketara eta abarretara garraiatzen da kableen bidez. Eskala txikian, piletan eta baterietan sortu eta metatu daiteke.

• Energia termikoa. Bi objekturen artean bero gisa transferitzen da: tenperatura altuena duen objektutik tenperatura baxuagoa duen objektura, alegia. Egoera- aldaketak, dilatazioak eta abar eragiten ditu.
• Argi-energia. Modu naturalean sortzen da Eguzkian eta era askotako substantziak erretzean eragiten ditugun suetan. Energia kimikotik eta elektrikotik ere lortu dezakegu.
• Energia kimikoa. Elikagaiek, ikatzak, petrolioak eta abarrek duten energia da, eta substantzia horiek eraldatzen ditugunean lortzen dugu. Energia mota hori argi eta bero gisa agertzen da.
• Energia nuklearra. Izarren barruan sortzen da edo substantzia erradioaktiboetatik askatzen da, uraniotik adibidez.
1 Zer energia mota aurkitzen dituzu zure eguneroko bizitzan, altxatzen zarenetik ikastetxera heltzen zaren arte?
2 Zer energia motarekin lotzen duzu hitz bakoitza?
Ekaitza, sugarra, ordenagailua, bizikleta, Eguzkia.
3 Erreparatu irudiei, eta adierazi zer energia mota ikusten dituzun haietan.

108
1
A B
Energiaren transformazioa



Energia mota batzuk beste energia mota bihurtu daitezke hainbat prozesuren bitartez. Hemen, adibide batzuk dituzu, baina ziur zuri beste asko bururatzen zaizkizula.





Energiaren transformazioaren adibide batzuk



Eguzkiaren argi-energia
Energia kimiko bihurtzen da, landareek hazteko egiten duten fotosintesiaren bidez, eta kaleak argiztatzeko energia elektriko bihurtzen da plaka fotovoltaikoei esker.
Haizearen energia zinetikoa

Gure etxeetara iristen den energia elektriko bihurtzen da zentral eolikoetan.

Erregaien energia termikoa

4 Ideiabiltzarra Zer berokuntza mota duzue ikastetxean? Azaldu zer energia mota sortzen duen, eta zer energia mota bihurtzen den erradiadoreetara heltzean.
Elikagaien energia kimikoa
Energia zinetiko bihurtzen da, mugi gaitezen; baita energia termiko eta beste energia kimiko mota batzuk ere, hazteko eta bizi-funtzioak egiteko bide ematen digutenak.

Gure etxeetara iristen den energia elektrikoa
Esate baterako, energia termiko bihurtzen da labeetan eta argi-energia lanparetan.






Adibidez, gurpiletara transmititzen den energia zinetiko bihurtzen da autoen motorraren bidez.
Biradera bati eraginez kargatzen diren esku-argiek energia zinetikoa argienergia bihurtzen dute. Baduzu antzeko transformazioak egiten dituen aparaturik?

109 U6
Gogoan hartu!
Elektrizitatea
Elektrizitatea gauza askotarako erabiltzen dugu: telebista ikusteko, etxeak argiztatzeko, telefonoz deitzeko... Baina ba al dakizu nola funtzionatzen duen?
Zer da elektrizitatea?
Elektrizitatea zer den azaltzeko, beharrezkoa da materiaren propietate jakin bat ezagutzea: karga elektrikoa, alegia.

Karga elektrikoa
Propietate horixe hartzen du, adibidez, hagaxka batek oihal batekin igurzten dugunean; izan ere, hagaxkak paper txikiak erakartzeko gaitasuna lortzen du. Hori materia elektrizatu egin delako gertatzen da; hau da, karga elektrikoa hartu duelako.
Karga elektrikoa materiak baldintza zehatz batzuetan hartzen duen propietate bat da.
• Objektuek karga positiboa edo karga negatiboa hartu dezakete.
• Aurkako kargak dituzten objektuek (positiboa edo negatiboa) elkar erakartzen dute.
• Zeinu bereko kargak dituzten objektuek (negatiboanegatiboa edo positiboa-positiboa) elkar aldaratzen dute.


Korronte elektrikoa
Karga elektrikoa objektu batzuetatik beste batzuetara transferi daiteke, elkarren ondoan jartzen baditugu eta karga desberdinak badituzte.
Esate baterako, ekaitz-hodeiek eta Lurraren gainazalak oso karga desberdinak dituzte: bata, oso positiboa da eta, bestea, berriz, oso negatiboa. Horregatik, bi gorputz horien artean karga-mugimendu bat gertatzen da haien artean dagoen airean zehar: tximista da korronte elektriko hori.
Gizakiok karga desberdinen arteko mugimendua erabiltzen dugu, elektrizitatea zentral energetikoetatik gure etxeetara modu seguruan (kableen bidez) garraiatzeko.
Korronte elektrikoa karga elektrikoari igarotzen uzten dioten objektuen artean gertatzen den karga-mugimendua da; esaterako, kableen bidez.
Materia nola elektrizatzen den erakusten duen adibide bat
Beirazko hagaxka bat artilezko oihal batekin igurzten badugu, elektrizatu egiten da. Hori dela eta, hagatxoa paper zatitxo batzuetara hurbilduz gero, erakarri egiten dituela eta itsatsita geratzen zaizkiola ikusiko dugu.
1 Zer gertatuko da karga positiboa duten bi objektu hurbilduz gero? Eta karga positiboa duen objektu bat eta karga negatiboa duen beste bat hurbiltzean?


110
2
Materialak eta korronte elektrikoa
Korronte elektrikoari igarotzen uzten dioten kontuan hartuta, materialak bi motatakoak izan daitezke:
• Material isolatzaileak. Ez diete korronte elektrikoari igarotzen uzten. Halakoa da, esaterako, kableak babesten dituen plastikoa.
• Material eroaleak. Korronte elektrikoari igarotzen uzten diote. Halakoak dira, adibidez, kableen barnealdean egoten diren metalak; hala nola kobrea.
Nire lanbidea: elektrikaria
Zirkuitu elektriko bat elkarren artean konektatuta dauden elementuen multzo bat da, eta, horri esker, korronte elektrikoa sortu eta garraia daiteke, eta elektrizitatea beste energia mota bat bilakatu; hala nola energia termikoa (labea), argi-energia (lanpara)... Hauek dira elektrikariek erabiltzen dituzten ikurrak:

+ –



Niko dut izena, eta elektrikaria naiz. Nire zeregina etxeetako gailu eta etxetresna elektrikoak eta lanparak funtzionarazteko beharrezkoak diren zirkuitu elektrikoak muntatzea da. Zirkuitu bat muntatzen hasi aurretik, marrazki bat egiten dut beti, nolakoa izango den irudikatzeko. Zirkuituaren elementu bakoitza ikur jakin baten bidez adierazten da, eta ikur horiek berdinak dira elektrikari guztiontzat.
Bonbilla Pila Etengailua Kablea
Zirkuitu elektrikoek honako elementu hauek dituzte:
• Sorgailua: korronte elektrikoa sortzen duen gailua da. Esate baterako, pila bat.
• Eroalea: hari bat da, eta korronte elektrikoa hari horretan zehar higitzen da.
• Etengailua: korronte elektrikoa eteteko eta berriz abiarazteko gailua da.
• Hartzailea: aparatu edo gailu bat da, eta elektrizitatea hartu eta beste energia mota bat bilakatzen du, hala nola argia (bonbilla), soinua (irratia), beroa (erradiadore elektrikoa) eta abar.
1 Elektrikariek erabiltzen dituzten ikurrak baliatuta, marraztu irudiko zirkuitu elektrikoa.
Gogoan hartu!
Kableen bidez, karga elektrikoa korronte elektriko gisa transferitzen da gure etxeetaraino.

111 U6
Hartzailea
Eroalea Sorgailua
Etengailua
Magnetismoa

Ba al zenekien korronte elektrikoak eremu magnetikoak sortu ditzakeela, imanek egiten duten bezala? Zer berezitasun dituzte imanek?

Imanak


Ziur imanak askotan ikusi dituzula; adibidez, jostailu magnetikoenak edo hozkailuan itsasten direnak. Objektu batzuek (metalikoak izaten dira) elkar erakartzeko edo aldaratzeko duten propietate horri magnetismo deritzo, eta hura duten objektuei, imanei, alegia, magnetiko esaten zaie. Imanen ezaugarri nagusia burdinez osatutako objektuak erakartzea da.
Nolakoak dira imanak?
Imanak naturalak izan daitezke, hala nola magnetita izeneko minerala, baita artifizialak ere, gizakiek burdinarekin eta beste metal batzuekin egiten dituztenak.


Imanek bi polo dituzte (iparra eta hegoa), eta eremu horiexek dira burdina eta objektu metalikoak erakartzeko ahalmen handiena dutenak. Oro har, poloak imanen muturretan egoten dira.
1 Pentsatu eta binaka jarrita komentatu Esperimentu zientifikoen denda batean, arazo bat dute imanak direla eta. Ferra forma duen imanean poloak adierazita daude; ez, ordea, barra forma duten beste bietan: ez urdinean,

Ez dago polo bakarra duen imanik. Iman bat erdibituko bagenu ere, iman zati berriek ipar polo bat eta hego polo bat izango lituzkete.
Bi iman hurbiltzen baditugu, eta elkar ukituko duten poloak izen desberdinekoak badira, imanek elkar erakarriko dute.
Aldiz, bi iman hurbiltzen baditugu, eta elkar ukituko duten poloak izen berekoak badira, imanek elkar aldaraziko dute.
Izen bereko poloek (iparra-iparra) elkar aldaratzen dute.
Izen desberdineko poloek (iparra-hegoa) elkar erakartzen dute.
Izen bereko poloek (hegoa-hegoa) elkar aldaratzen dute.
112
3
Iman baten poloak
Zertarako erabiltzen dira imanak?
Egunerokoan, hainbat gauzatarako erabiltzen dira imanak. Adibidez, hozkailuetako iman apaingarrietan, poltsen itxigailuetan, jostailu batzuetan, klipak gordetzeko ontzietan... aurkitu ditzakegu. Gainera, ordenagailuetan eta banku-txarteletako banda magnetikoetan (informazioa gordetzeko), lebitazio magnetikozko trenetan eta abarretan ere erabiltzen dira.
Lurra bera iman erraldoi bat da (haren nukleoan dagoen burdina dela eta). Lurraren ipar polo magnetikoa ipar polo geografikotik oso hurbil dago.
Hori horrela delako, iparra non dagoen jakiteko, orratz imandu bat erabil dezakegu, iparra seinalatuko baitu beti. Horrelaxe funtzionatzen dute, hain zuzen, iparrorratzek!
Tren magnetiko bat egingo dugu
Ba al zenekien leku batzuetan trenek lebitatu egiten dutela (hau da, lurretik altxatuta daudela) eta halaxe higitzen direla, iman kantitate handi bati esker? Lebitazio magnetikozko trenak dira horiek. Ariketa honetan, tren magnetiko baten bertsio soil bat egingo dugu, eta, horretarako, korronte elektrikoek elektroimanak sortzeko duten gaitasuna baliatuko dugu.
Materialak


Pila bat



Bi iman
Kobre-hariz egindako espiral bat, pilaren diametroa duena

2 Erreparatu irudiari, eta azaldu zergatik den Lurra iman erraldoi bat bezalakoa.
Hego polo magnetikoa
Ipar polo geografikoa

Ipar polo magnetikoa
Elektroimana
Hego polo geografikoa
Elektrizitatea eta magnetismoa estu lotuta daude. Burdinazko barra batean hari eroale bat biribilkatu eta hari horretatik korronte elektriko bat pasarazten badugu, burdinazko barrak objektu metalikoak erakartzen dituela ikusiko dugu; hau da, elektroiman deritzon iman bat bilakatu dela.
Muntaia



Ipini iman bakoitza pilaren muturretan.
Sartu imanak dituen pila harian. Hortxe duzu zure trena!
Gogoan hartu!
Magnetismoa, hozkailua dekoratzeko ez ezik, informazioa gordetzeko, gauzei indar handiz heltzeko, eta beste hamaika gauzatarako erabil daiteke!
113 U6
H I
Elektrizitateari eta magnetismoari buruz gehiago jakiteko, «Berehala kontatuko dizut», anayaharitza.es webgunean.
1 Zer sortu duzu pilari imanak jartzean?
2 Tren bat egin duzu, pilari imanak jarrita. Azaldu zergatik higitzen den kobre-harian zehar.
Energia-iturriak eta energia-iturri motak
Gure etxeetan edo ikastetxean erabiltzen dugun
energia elektrikoa era askotan sortu daiteke. Baina era guztiak ez dira berdinak: batzuk jasangarriagoak dira, potentzia handiagoa dute...
Energia-iturriak
Gizakiok energia-iturrietatik eskuratzen dugu behar dugun energia.
Energia-iturri esaten zaie naturan dauden eta gizakiak energia lortzeko erabiltzen dituen hainbat baliabideri.
Energia-iturriak bi multzotan sailkatzen dira: berriztagarriak eta berriztaezinak.
Energia-iturri berriztaezinak
Energia-iturri berriztaezinak agortu daitezkeenak dira; izan ere, oso azkar erabiltzen direnez, naturak ezin du denbora berean berriz ere energia-iturri horiek sortu.
Energia-iturri berriztaezin nagusiak
Alde onak


Energia kantitate handia sortzen dute prezio baxuan. Gainera, energia hori garraiatzea eta biltegiratzea merkea da.

Alde txarrak
1 Begiratu «Energia berriztaezinak» baliabidea, anayaharitza.es webgunean, eta idatzi koadernoan:

a) nondik sortzen diren ikatza, gas naturala eta petrolioa.
b) nondik sortzen den erregai erradioaktiboen energia.
Agortu daitezke; oso kutsagarriak dira ingurumenerako; kaltegarriak dira gizakion osasunarentzat; eta haiek erauzteak ingurumen-arazoak eragin ditzake.
114
4
Ikatza. Zentral termikoetan erretzen da.
Petrolioa eta gasa
Zentral termikoa
Erregai nuklearrak
Energia-iturri berriztagarriak
Energia-iturri berriztagarri esaten zaie erabili arren agortzen ez diren edo modu naturalean leheneratzen diren energia-iturriei.

Energia-iturri berriztagarri batzuk
Alde onak

Agorrezinak dira; ez dute erregai fosilek bezainbeste kutsatzen; eta biomasa erabiltzeak landareen hondakin organikoak deuseztatzeko bide ematen du.
Alde txarrak
Batzuetan, energia-errendimendu baxukoak izaten dira; ez dute beti energia sortzeko beharrezko baliabiderik izaten (eguzkia, haizea...); eta instalazioak ingurumenerako kaltegarriak izan daitezke.
2 Begiratu «Energia berriztagarriak» baliabidea, anayaharitza.es webgunean, eta azaldu zure koadernoan nola erabiltzen den ura energia-iturri berriztagarri gisa.
3 Adierazi zein diren energia-iturri hauen alde onak eta alde txarrak.
a) Ikatza b) Haizea

Gogoan hartu!
Energia-iturri berriztaezinak potentzia handikoak dira, baina epe luzera agortu daitezke. Kontuz erabili behar ditugu, beraz!
115 U6
Haizea
Ura
Biomasa. Energia basoetako eta nekazaritzako hondakinak errez lortzen da.
Eguzki-plaken bidez, Eguzkiaren argi-energia eta energia termikoa hartzen dira.
Energia behar bezala erabiltzen dugu?
Energiaren erabilerak eragiten dituen arazoak
Energia-baliabideen erabilera jasangarria egiteko, jokabide hauek hartu behar ditugu kontuan energia kontsumitzean:
• Ekosistemak ez kaltetzea (ingurumen-jasangarritasuna).
• Beste gizaki batzuk ez kaltetzea (gizarte-jasangarritasuna).



• Energiaren erabilera jasangarria egiteko ekintzarik eraginkorretako bat energia-kontsumoa murriztea da.
1 Adierazi esaldi hauek zuzenak ala okerrak diren, eta zuzendu koadernoan okerrak direnak.
a) Ikastetxera, autobusez joan beharrean, kotxez joatea energia aurrezteko modu bat da.
b) Etxetresna elektrikoak erabiltzen ari ez garenean itzaltzeak ez du energiarik aurrezten.



Erabili arduraz gailu elektronikoak.
Deskonektatu erabili behar ez dituzun aparatu elektronikoak, kargagailuak eta gailu elektronikoak.

Itzali telebista ikusi behar ez baduzu, eta ez utzi etxeko argiak alferrik piztuta.

Erabili ur beroa neurriz, ura berotzeak energia asko kontsumitzen baitu: bainatu beharrean, hartu dutxa, eta esan etxekoei garbigailua ur hotzarekin erabiltzeko.
Ahal izanez gero, zoaz ikastetxera oinez, bizikletaz edo erabili garraio publikoa.
Gomendatu etxekoei kontsumo baxuko etxetresna elektrikoak eta bonbillak erostea.
116
5
Gaur egun, mundu osoko pertsonen bizimoduak gero eta energia gehiago eskatzen du. Hori horrela, egun dugun erronkarik garrantzitsuena guztiontzako nahikoa energia sortzea da.
Energiaren erabilera jasangarria egiteko aholku batzuk
Proiektua: Ikastetxe jasangarriagoa eraikiz: elektrizitatea nola aurreztu
Dakizunez, energiaren erabilera jasangarria abian jartzeko egin dezakegun ekintza garrantzitsuetako bat energia aurreztea da.
Hain zuzen, ariketa honen bidez, gure ikastetxeak energia aurrezteko orduan behar bezala jokatzen duen ebaluatuko dugu.
Taldeak osatu eta ondoko inkestan ageri diren alderdiak ebaluatuko ditugu.
Litekeena da inkesta betetzeko egun bat baino gehiago behar izatea eta, informazioa eskuratzeko, irakasleei edo zuzendaritzako langileei galdetu behar izatea. Ez izan galdetzeko lotsarik.
1 Batu erantzun guztien puntuak, eta ondorioztatu zer kolore dagokion zuen ikastetxeak lortu duen emaitzari.
7-20 p
Gure ikastetxeak energia aurrezteko neurriak hartu behar ditu.
Zer da jasangarritasuna? Natura eta beste gizaki batzuk kaltetu gabe, gure beharrak asetzeko bide ematen digun bizimodua da.
Gure ikastetxean/gelan...


Argiztapen naturala ona da.
Kontsumo baxuko bonbillak eta fluoreszenteak erabiltzen dira.
Jolas-orduan, gelako argiak itzaltzen ditugu.
Giro-tenperatura egokia dugu: ez dugu berorik ez hotzik izaten.
21-28 p
Gure ikastetxeak ez du energiarik xahutzen. Dena den, ez legoke gaizki energia aurrezteko zenbait neurri abian jartzea.

Leihoak ondo isolatuta daude, eta ez dugu aire-korronterik nabaritzen haien ondoan.
Eguzki-panelak erabiltzen dira, elektrizitatea sortzeko edo ura berotzeko.

29- 35 p
Gure ikastetxeak energiaren erabilera jasangarria egiten du. Bejondeigula! Orain arte bezala jarraitu behar dugu!
2 Ikastetxearen emaitza 29tik 35era bitartekoa ez bada, egin energia aurrezteko hobekuntzaproposamen bat. Horretarako, inkestan jasotako ekintzak kontuan hartu ditza kezue edo proposamen berriak asmatu.
3 Partekatu zuen proposa menak.
Eskola-orduak amaitzean, aparatu elektronikoak deskonektatu egiten dira.
Eman puntuak 1etik 5era bitartean (1 = erabat kontra; 5 = erabat ados)
Gogoan hartu!
Etorkizun jasangarriagoa izango badugu, ezinbestekoa da energia aurreztu eta energia-iturri berriztagarriei gero eta onura handiagoa ateratzea.

117 U6
Ondorioztatu emaitza
Energia aurrezteko modu gehiago ikasteko, «Berehala kontatuko dizut», anayaharitza.es webgunean.
Energia eta mugimendua
Laguntza eskatzeko mezu bat bidaltzeko,
kometa bat
erabiltzea bururatu zaio Uxoari. Baina... nola liteke kometek hegan egitea, oihal zatiak besterik ez badira?
Marruskadura

Gizakiok, besteak beste, mugimendua sortzeko erabiltzen dugu energia. Horren erakusgarri dira, hain zuzen, ibilgailu motordunak.
Mugitzeko, ibilgailu batek etengabe aurrera egin behar du higitzen den ingurunean. Ingurune hori airea izan daiteke (hegazkin bat bada), ura (itsasontzi bat bada) edo lurzorua (auto bat bada). Ibilgailuek ingurunean aurrera egiten dutenean, marruskadura jasaten dute, eta, horren eraginez, energia galtzen dute; energia galtzearen ondorioz, abiadura ere galtzen dute.






Marruskadura, mugimenduan dagoen objektu batek aurrera egiten duen bitartean, inguruneak (airea, ura, lurzorua) egiten duen erresistentzia da.
Nola mugitzen diren ibilgailuak ingurune desberdinetan
1 Erreparatu arretaz autoen argazkiei.
Zure ustez, bi ibilgailuetako zeinek du forma egokiagoa, abiadura handiagoan higitzeko? Eman arrazoiak.
Hegan egiten duten ibilgailuek airearen erresistentzia gainditu behar dute. Horretarako, erresistentzia hori konpentsatzeko, bultzada deritzon indarra sortzen duen motor bat dute. Motor horren beste zeregin bat hegazkinaren pisuaren aurkako indar bat sortzea da, euste-indarra, alegia.

Hegan egiteko, bultzadak erresistentzia baino handiagoa izan behar du, eta euste-indarrak pisua baino handiagoa.
Uretako ibilgailuek, uraren erresistentzia gainditu ez ezik (airearena baino handiagoa da), flotatu egin behar dute. Ibilgailuaren flotagarritasuna haren pisuaren eta urak azalean egiten duen bultzadaren arteko orekaren araberakoa da (bultzadak pisuaren aurkako noranzkoa du). Dakizunez, oreka horri eragiten dion beste alderdi bat ibilgailuaren dentsitatea da.
Lurreko ibilgailu askok gurpilak dituzte, lurzoruak eragiten dien marruskadura ahalik eta txikiena izan dadin.
Gurpilen mugimendu bereizgarriari errodadura deritzo, eta biraketaren eta aurrerantz egindako higiduraren arteko konbinazioa da. Lurreko ibilgailuek bi erresistentzia gainditu behar dituzte: higitzen diren lurzoruarena eta airearena.
Airearekiko erresistentzia
Lurzoruarekiko erresistentzia
Begiratu «Airea eta objektuen forma», bi elementu horien arteko erlazioa zertan den jakiteko, anayaharitza.es webgunean.
118
6
Aireko ibilgailuak Uretako ibilgailuak Lurreko ibilgailuak
Erresistentzia Bultzada
Euste-indarra
Pisua
Pisua
Bultzada
Errodadura
Bultzada Pisua
Proiektuak egingo ditut, urratsez urrats
Kanikarik onenak, ontzirik onena eta kometarik onena egingo ditugu
k anikarik O nenak
Helburua: hainbat material eta tamainatako kanikak egitea, eta zein biratzen diren azkarrago egiaztatzea.
Materialak: plastilina, buztina, paper-orea, pintura, berniza eta abar.
Kanikak nola egin: modelatu materialekin ahalik eta esferarik leunenak, eta apaindu, pintura erabilita. Egin akabera askotako kanikak (bernizatuak, bernizatu gabeak, etab.).

Jolastu kanikekin, eta egiaztatu zein biratzen diren ondoen, eta nola eragiten dion kaniken akaberak haien biratze-abiadurari.
O ntzirik O nena
Helburua: hainbat diseinu dituzten itsasontziak egitea, eta uretan zein higitzen den ondoen egiaztatzea.
Materialak: platerak, supermerkatuko frutaontziak, edalontziak, plastilina, makilak, plastikozko poltsa bat (bela egiteko), zinta itsasgarria...
Ontzia nola egin: bilatu benetako ontzien diseinuak (baltsak, kanoak, txalupak ...), eta hartu haiek eredu gisa. Begiratu diseinuak, anayaharitza.es webgunean.
Egiaztatu zer ontzik flotatzen eta aurrera egiten duen ondoen.
k O metarik O nena
Helburua: hainbat diseinu dituzten kometak egitea, eta airean zein higitzen den ondoen egiaztatzea.
Materialak: bi alanbre edo egurrezko bi makila fin, plastikozko poltsa bat, soka bat, zinta itsasgarria, kometetarako kordela, helduleku bat...
Kometa nola egin: begiratu muntaiaren urratsak, anayaharitza.es webgunean.
Jarri kometari isats mota desberdinak, aldatu haren forma eta tamaina…, eta egiaztatu diseinu guztietatik zein hegaldatzen den ondoen!
Gogoan





Zenbait objektuk eta izaki bizidunek hegan egin dezakete, euste-indarrak airean eusten dituelako. Sinestezina da!

119 U6
hartu!
Begira nola pentsatzen dudan
Begira nola pentsatzen dudan
Bideojoko bat egingo dut,





urratsez urrats
Energia elektrikoa hainbat gauzatarako erabil dezakegu, baina gure gustukoenetako bat bideojokoak programatu eta haiekin jokatzea da!
Dagoeneko jakingo duzunez, Scratch izeneko tresnaren bidez, istorioak, animazioak eta jokoak egin daitezke. Orain, tresna hori baliatuko dugu, bideojoko txiki bat egiteko.
Aurreko ikasturteetan, animazio bat, istorio bat eta galdera bat egiten ikasi zenuen, baita bideojoko txiki bat egiten ere. Scratch-en bidez nola programatzen den gogoratzeko, begiratu anayaharitza.es webgunean eskuragarri duzun informazioa.


Aurten, istorioa garatzen jarraitu eta bi bideojoko berri egingo dituzu.
Nire bideojokoa
Zer egin behar duzu?

Avery-ren eta txakurraren istorioa garatu.
Gogoan duzunez, gure istorioan, Avery-ren eta txakurraren arteko
elkarrizketa bat asmatu genuen. Hartan, txakurrak galdera bat
egin zion Avery-ri, eta hark bi aukeraren artean hautatu behar zuen erantzun zuzena. Zuzen erantzunez gero, Avery-k opari bat (bideojoko bat zen) jasotzen zuen; oker erantzunez gero, berriz, txakurrak Zer lastima! zioen, eta istorioa berriz ere hasten zen. Orain, galdera gehiago eta galdera horien erantzunak prestatuko ditugu. Avery-k zuzen erantzunez gero, irabazitako opariak aurreko ikastaroan programatu genuen bideojokoan jokatzeko aukera emango dio («Animaliak salbatu»), baita programatuko ditugun beste bi bideojokoetan jokatzeko ere.
«Itzali argi guztiak» bideojokoa. Jokoa gela bateko argi guztiak itzaltzean datza, etengailuak sakatuz. Jokoa bonbilla guztiak itzaltzean amaitzen da.
Bideojoko hori egiteko, elementu hauek hautatu eta programatu behar dituzu: eszena eta bonbillen eta etengailuen kopurua. Ondoko irudiek programazio horien adibide batzuk erakusten dituzte.
120
7
ETENGAILU BATEN PROGRAMAZIOA
BONBILLA BATEN PROGRAMAZIOA
Hasi baino lehen, begiratu anayaharitza.es webgunean nola erabiltzen den Scratch.
anayaharitza.es webgunean, bideojokoa osorik aurkituko duzu.
ESZENAREN PROGRAMAZIOA
Ordenagailuan segurtasunez eta arduraz jokoan aritzeko, irakurri IKT-IET planeko 6. fitxa, anayaharitza.es webgunean eskuragarri.
«Animaliak aurkitu» bideojokoa. Jokoa eszena batean ezkutatu diren animalia guztiak aurkitzean datza.
Jokoaren arauak honako hauek dira: animalia bat aurkitu dela adierazteko, klik egin behar da haren gainean. Orduan, animalia hori eszenatik desagertuko da. Aitzitik, objektu baten gainean klikatuz gero, soinu bat entzungo da.
ANIMALIA BATEN PROGRAMAZIOA (HARTZA)


Jokoa animalia guztiak aurkitzean amaitzen da. Bideojokoa egiteko, elementu hauek aukeratu eta programatu behar dituzu: eszena, animaliak (hartza, ahatea, gizakia...) eta animaliak ez diren objektuak (sagarra, danborra...). Ondoko irudiek programazio horien adibide batzuk erakusten dituzte.
JOKOAREN ARAUAK
OBJEKTU BATEN PROGRAMAZIOA (SAGARRA)
Dibertigarriak izateaz gain, bideojokoek mundu hobea eraikitzen laguntzen dute, bide ematen baitute helburu hori lortzeko istorioak kontatzeko eta mezuak helarazteko.
anayaharitza.es webgunean, programazio horri buruzko azalpenbideo bat aurkituko duzue.






121 U6
Gogoan hartu!
Z er ikasi dut?
1 Aipatu energia termikoa lortzeko lau energia-iturri.
2 Barazkiak eta frutak jatean kontsumitzen dugun energia Eguzkitik datorrela esan genezake? Eman arrazoiak.
3 Nondik sortzen da bizikleta baten pedalei eragiteko erabiltzen duzun energia?
4 Azaldu zergatik gertatzen diren tximistak ekaitz elektrikoetan.
5 Zer gertatuko da, iman baten ipar poloa eta beste iman baten hego poloa hurbiltzen badituzu?
6 Adierazi objektu hauetako zein erakarriko lituzketen imanek:
a) iltze bat
b) boligrafo bat

c) kable bat


d) klip bat
e) grapa bat
7 Erreparatu argazkiei.
a) Zure ustez, bi hegazkin hauetako zeinek du formarik egokiena airean aurrera egiteko, marruskadura txikiagoa jasanez? Zer hegazkinek du formarik aerodinamikoena, alegia?


b) Forma horietako zeinek du hegan ari den hegazti baten antz handiena? Zure ustez, zergatik da hori horrela?
c) Gogoratu nolako forma duten espazio-suziriek. Zure ustez, zergatik dute ardatz forma eta ez, adibidez, zilindro edo prisma forma?
8 Sailkatu energia-iturri hauek, berriztagarriak ala berriztaezinak diren kontuan hartuta: Ikatza, ura, Eguzkia, haizea, petrolioa, substantzia erradioaktiboak, biomasa, gas naturala.
9 Azaldu zure koadernoan nola erabiltzen den ura energia-iturri berriztagarri gisa.
10 Adierazi koadernoan nondik sortzen den erregai erradioaktiboen energia.
11 Zer da marruskadura?
12 Adierazi esaldi hauek zuzenak ala okerrak diren:
a) Iman guztiek bi polo dituzte.
b) Iman bat erdibituz gero, imana izateari uzten dio.
c) Elkar ukituko duten bi imanen poloak izen berekoak badira, imanek elkar erakarriko dute.
13 Erreparatu energia elektrikoari esker funtzionatzen duten aparatu hauei, eta adierazi zer beste energia mota bihurtzen duten energia elektrikoa.
Ez ahaztu unitate honetako zure argazki-albuma osatzea, webgunean: anayaharitza.es

Semaforoa. Margotu koadernoan, ariketa
bakoitzaren ondoan, honela:
erantzuna badakizu
laguntza izan baduzu
erantzuna jakin ez baduzu
122 PORTFOLIOA
A B
HELBURUA AURRERA
Uxoarena bezalako biziraupenplan bat egingo dugu ikastetxerako

Imajinatu zuen ikastetxea argindarrik gabe gelditu dela, eta denbora luze batez halaxe geldituko dela. Uxoarena bezalako biziraupen-plan bat behar duzue!
1 Taldeka jarrita, kopiatu eta osatu antolatzaile grafiko hau, zuen proposamena egiteko.
2 Partekatu egin dituzuen biziraupen-planak. Zer ideia iruditzen zaizkizue onenak? Zergatik? Idatzi gehien gustatzen zaizkizuen ideiak.
LABURBILDU:
Zer ondorio ateratzen duzue?
Zuen proposamenak egokiak direla iruditzen al zaizue oraindik? Edo aldatu egin beharko lirateke?
N ola ikasi dut?
Ariketak egin bitartean jarri dudan arreta.
3 Zorionez, litekeena da zuen ikastetxeak argindarra izatea. Halere, ondo dakizuenez, ezinbestekoa da energia elektrikoa aurreztea, etorkizun jasangarriago bat izan dezagun. Hori horrela, irakurri berriz ere idatzi dituzuen ideiak. Zuen ustez, baliagarria da haietakoren bat ikastetxeko elektrizitate-kontsumoa murrizteko? Animatu ideia erabilgarrienak eta benetan gauzatu daitezkeenak praktikan jartzera!
ARRAZOITU:

Energia elektrikoa behar duten zer ekintza egiten dituzue ikastetxean? Nola egin zenitzakete ekintza horiek bestela?
Gure biziraupen-plana

ERANTZUN:
Nola egingo zeniekete aurre jarri dituzuen oztopoei?
Nola eutsiko diezue zuen proposamenei?
OZTOPATU:
Zer arazo izango lituzkete zuen proposamenek?
Motelak dira? Zailak? Behar bezain eraginkorrak eta erakargarriak?...
Taldekideei eman diedan laguntza.
Zenbat ahalegindu naizen, zeregina aurrera ateratzeko.
Neroni zegozkidan lanak garaiz egin ditudan.
U6 123
1 Balioetsi zure talde-lana. Horretarako, kontuan hartu lau alderdi hauek:
7 Aurrerabidea edo natura? Biak?
Azken ikerketek aspaldi genekiena berretsi dute: gure planeta ez dela gai izango gaur egun daramagun bizi-estiloari eusteko, baldin eta herritarrok oraingo erritmoan kontsumitzen jarraitzen badugu. Zer egin dezakegu guk, Lur planetako biztanleak garen aldetik? Badakizu zer diren kontsumo eta ekoizpen jasangarriak? Hona hemen, labur-labur azaldurik: ekonomia-hazkundeak ingurumenaren hondamenik eragin beharrik ez izatea halabeharrez, baliabideen eraginkortasuna handitzea, eta bizi-estilo jasangarriak sustatzea, gure inguruko natura-baliabideekin begirunetsuak izan daitezen.
Pentsa zeinen garrantzitsua den gaur egungo ekoizpen- eta kontsumoeredua aldatzea. Urte batzuk barru, zu eta zure ikaskideak helduak zaretenean, zuek izango zarete ekoizle eta kontsumitzaileak. Geroa, beraz, zuen esku dago.

Zer deritzozu?


Pentsatu duzu inoiz balitekeela bizi zaren modua gure planetari kalte egiten aritzea? Ezagutzen duzu gure bizi-estiloarengatik hondatzen ari den naturagunerik zure inguruan? Zure ustez, Europako erakundeek egiten al dute zerbait arazoari aurre egiteko?

Datua
Baldin eta munduan
Unitate honetarako...
Helburua aurrera
Sare sozialen bidez, jakinarazi zure erkidegoko herrikideei zein garrantzitsua den ekoizpen eta kontsumo arduratsuaren aldeko ekintzen berri ematea.
Jarraitu hariari!
9 600 milioi biztanle izatera iritsiko bagina 2050erako, gure planeta halako hiru beharko genituzke oraingo bizi-estiloei eusteko behar diren naturabaliabideak lortzeko.
Erliebea eta haren aldaketak
1
Nola aldatzen da erliebea?
2
Espainia: erliebearen kokapena eta ezaugarriak Zergatik da den bezalakoa Espainiako erliebea?
126
Penintsulako erliebea
3
Zer erliebe forma daude Penintsulan?
Kostaldeetako erliebea
4
Berdina al da Espainiako kostalde osoa?

EAEko erliebea
5
Zer ezaugarri ditu gure erkidegoko erliebeak?
Europa: erliebearen kokapena eta ezaugarriak
6




Nolakoa da Europako erliebea?

127 12
Nola aldatzen da erliebea?
Gizakiok al gara inguruan dugun erliebearen aldaketaeragile nagusia?
Erliebea Lurraren gainazalak dituen formen multzoa da (mendiak, lautadak, sakonuneak…). Barne- eta kanpo-eragileak direla tarteko, erliebea aldatu egiten da.
Barne-eragileek lurra altxatzea, hondoratzea eta lekualdatzea eragiten dute. Zenbaitetan, aldaketa mota horiek oso modu bortitzean gertatzen dira.
Barne-eragile nagusiak



Lurrazalaren bat-bateko higidurak dira, lurra dardaratzen, pitzatzen eta lekualdatzen dutenak eta kalte handiak eragin ditzaketenak (jendea hil, eraikinak bota eta beste asko.). Lurrikaren intentsitatea neurtzeko, Richter eskala erabiltzen da.
Itsas hondoan sortzen diren lurrikarak dira. Kostaldera hurbildu ahala, olatuen tamaina handitu egiten da.
Olatu erraldoiak sortzen dituzte, eta suntsipen eta kalte handiak eragiten kostaldeko herri eta hirietan.
1 Alderagarriak al dira naturak eragindako erliebe-aldaketak eta gizakiok eragindakoak? Arrazoitu zure erantzuna.
2 Bilatu informazioa Espainian eta Europan azken urteetan barne-eragileen ondorioz izan diren erliebe-aldaketei buruz, eta egin fitxa bana. Gutxienez informazio hau aipatu behar duzu: erliebea aldarazi duen barne-eragilea; kokapena (herria/hiria eta herrialdea); urtea; gizakiongan eta naturan eragindako efektuak. Beste datu batzuk ere gehitu ditzakezu, interesgarriak iruditzen bazaizkizu.
«Berehala kontatuko dizut»: unitatearen laburpena eskuragarri duzu anayaharitza.es webgunean.
Lurrazalean sortzen diren pitzadurak dira; handik kanpora laba ateratzen da (tenperatura handia duen harri urtua), bai eta Lurraren barneko gasak ere. Erupzioa itsas hondoan gertatzen bada, laba lurgainera ateratzen da, eta uharteak eratu daitezke.


Barne-eragileek eragindako erliebe-aldaketak

128
1
Lurrikarak
Sumendiak
Tsunamiak
Eragile mota Non gertatu zen? Noiz gertatu zen? Efektuak ?
Paisaiaren aldaketa


Bizi- estilo jasangarri bat lortzeari dagokionez, eztabaidatu ikaskideekin lerroburu honetan esaten denak zer-nolako abantailak eta desabantailak izan ditzakeen:
«Iragarri dutenez, 23 000 milioi euro baino gehiago inbertituko dira Espainiako abiadura handiko trenbide-sarea hedatzeko lanak egiteko».
Kanpo-eragileek erliebea higatzen dute, eta materialak garraiatzen eta aldarazten dituzte, material edo jalkin horiek bazterretan utziz. Kanpo-eragileek barne- eragileek baino mantsoago eta leunago aldatu ohi dute erliebea.

Kanpo-eragile nagusiak
Tenperatura-aldaketek harriak haustea eragiten dute; izan ere, harriak uzkurtu egiten dira hotzaren ondorioz, eta dilatatu, berriz, beroaren ondorioz.
Urteen joanean, prezipitazioek erliebea higatzen dute; erliebea azkarrago ere aldaraz dezakete, erauntsi modura erortzen badira. Haizeak harriak higatzen ditu, eta, horren ondorioz, askotariko erliebe formak sortzen dira.
3 Egin eskema bat edo kontzeptu-mapa bat, eta eman paisaiak aldatzen dituzten barneeta kanpo-eragile guztien berri.
Ibai, itsaso eta ozeanoetako urek erliebea higatzen dute. Hondartzetan, adibidez, olatuek itsaslabarrak higatzen eta hondartzen formak aldarazten dituzte. Ibaiek harriak higatzen, garraiatzen eta atzera ere puska txikiak bazterretan jalkitzen dituzte.


Animaliek eta landareek mantsomantso hausten dituzte harriak beren sustrai edo mugimenduen bitartez. Gizakiok azkarrago eta modu iraunkorragoan aldarazten dugu erliebea. Aldaketa horien eragileak askotarikoak dira: eraikuntza, meatzaritza, nekazaritza…
Ura naturan dago, baina baliabide hori kudeatzeko behar diren azpiegiturak garestiak dira, eta erliebea aldaraz dezakete.



U7 129
Gogoan hartu!
Ura
Fenomeno atmosferikoak
Izaki bizidunak
? ?
Aldeko argudioak Aurkako argudioak
Zergatik da den bezalakoa Espainiako erliebea?
Zer ezaugarri geografiko ditu Iberiar penintsulak, Espainiako natura-baliabideen aniztasuna hain handia izateko?

uharteek, Ozeano Atlantikoan dauden Kanaria uharteek, eta Afrika iparraldean dauden Ceuta eta Melilla hiri autonomoek osatzen dute.


Iparraldean, Kantauri itsasoa, Andorra eta Frantzia.
Hegoaldean, Ozeano Atlantikoa eta Mediterraneo itsasoa.
Ekialdean, Mediterraneo itsasoa.

• Mendebaldean, Portugal —Iberiar penintsulan hori ere— eta
Ozeano Atlantikoa.
Balear uharteak bost uharte nagusik osatzen dituzte, eta Mediterraneo itsasoan daude, Penintsularen ekialdean.


Kanaria uharteak zazpi uharte nagusik osatzen dituzte; Ozeano Atlantikoak bustitzen ditu, eta Penintsularen hegoalde samarrean daude, Afrikatik gertu.
Balear uharteak
Mallorca, Menorca, Eivissa, Formentera eta Cabrera dira uharte nagusiak, baina txikiagoak ere badaude, hala nola Dragonera, Conejera…
Kanaria uharteak
Administrazio beregaina duten zazpi uhartek —La Palma, Hierro, Gomera, Tenerife, Kanaria Handia, Lanzarote eta Fuerteventura uharteek—, Graciosa uharteak, eta Alegranza, Lobos, Montaña Clara, Roque del Este eta Roque del Oeste irlatxoek osatzen dituzte.

130 2
Gibraltarko itsasartea ATLANTIKOA Mediterraneo itsasoa EUROPA AFRIKA ESPAINIA ASIA Kantzer tropikoa 10°M 0° 10°E 20°E 10°M 0° 10°E 20°E 30°E 40°E 30°I 40°I 50°I ANDORRA MAROKO ALJERIA PORTUGAL FRANTZIA Melilla Ceuta Kanariak Balearrak Iberiar penintsula Kantauri itsasoa OZEANO ATLANTIKOA M editerraneo itsasoa OZEANO ATLANTIKOA EUROPA AFRIKA ASIA Ekuatorea
hemisferioa
Hego
Ipar hemisferioa
Zer ezaugarri ditu Espainiako erliebeak?
Espainiako erliebea askotarikoa da. 650 metroko batez besteko altitudea du, eta hura da, Suitzaren ondoren, batez besteko altitude handiena duen Europako bigarren herrialdea.
Penintsulako erliebeak hiru elementu nagusi ditu: mendikate handiak; Iberiar goi-lautada, lurraldearen zati handi bat hartzen duena; eta sakonuneak.
Kanaria uharteetako erliebea sumendi-jatorrikoa da, eta, beraz, Penintsulako erliebeaz bestelakoa.
Balear uharteetako erliebea Iberiar penintsulako Mendikate Betikoen luzakin bat da.
Salgaien garraioan diharduten itsasontzi handien itsas istripuek, baldin eta erregai-isurpenak badaude tartean, oso modu larrian kaltetu ditzakete itsasoko natura-baliabideak.
1 Esan esaldi hauetako zein diren egia, eta zuzendu oker daudenak.
a) Espainia Hego hemisferioan dago.

b) Iberiar penintsularen zati batek, bi uhartedik eta Afrika iparraldean dauden bi hirik osatzen dute Espainia.

c) Europan altitude handiena duen laugarren herrialdea da Espainia.


d) Mediterraneo itsasoak soilik bustitzen ditu Espainiako kostaldeak.
2 Marraztu Europako mapa bat koadernoan, eta nabarmendu Espainia ondo ikusteko moduan. Europan non dago Espainia?
azpiegiturak sortzeaz arduratzen da, besteak beste, Sustapen Ministerioa.
Bi geografoek errepide bidezko komunikaziosare bat jarri nahi dute martxan botikak mendi aldeko herrietaraino eramateko.
Espainiako mapan ageri den legendari erreparatuz, adierazi, geografoen esku-hartzea errazteko, zein diren altitude handieneko hiru puntuak.
U7 131
AFRIKA EUROPA ASIA Escandinaviakomendiak A L P E A K M e d i t e r r a n e o i t s a s o a Itsaso Beltza OZEANO ARTIKOA OZEANO ATLANTIKOA Ipar itsasoa Kaspiar itsasoa Norvegiako itsasoa E u r o p a k o O r d oki H a ndi a Altitudea (m) 4 000 3 000 2 000 1 000 500 200 0 Itsas mailaren azpian
Gogoan hartu! Guadalquivirren sakonunear Ebrorensakonunea KANTAURIAR MENDIKATEA P I R I N I O A K IBERIAR SISTE M A E RDIALDEKO SISTEMA S I E R R A M O R E N A IPAR GOI-LAUTADA HEGO GOI-LAUTADA MENDIKATE BETIKOAK Melilla Ceuta BALEARAK KANARIA K Kantauri itsasoa OZEANO ATLANTIKOA M e d i t e r r a n e o i t s a s o a O Z E A N O A T L A N T I K O A Altitudea (m) 3 500 2 000 1 500 1 000 700 400 0
Zer erliebe forma daude Penintsulan?

Espainiak goi-lautada handi bat du erdialdean, Iberiar penintsularen % 45 inguru betetzen duena. Erliebearen gainerako unitateak goi-lautada horren inguruan antolatzen eta bi multzo handitan banatzen dira: batetik, barnealdeko unitateak daude, eta, bestetik, Iberiar goi-lautadaz kanpokoak.
Goi-lautadaren barnealdeko unitateak
Kokapena. Gaztela eta Leon, Gaztela-Mantxa, Madril eta Extremaduran barrena hedatzen da.
Ezaugarriak. Goi-lautada bat da, eta, batez beste, 650 metroko altitudea du.
Iberiar goi-lautadan bi mendigune daude: Erdialdeko Sistema eta Toledoko mendiak.
Goi-lautadaren ertzeko unitateak
Leongo mendiak, Kantauriar mendikatea, Iberiar sistema eta Sierra Morena dira Iberiar goi-lautadaren ertzeko unitateak.
Erdialdeko Sistema
Kokapena. Goi-lautadaren erdian dago.
Ezaugarriak. 600 km-ko luzera duen mendikatea da. Goi-lautada bitan banatzen du: iparraldeko goi-lautada, Duero ibaiaren arroan; eta hegoaldeko goi-lautada, Tajo eta Gua diana ibaien arroetan.
Mendilerro nagusiak. Somosierra, Guadarrama, Gata eta Gredos; azken horretan dago mendi garaiena, Almanzor mendia.


Toledoko mendiak
Kokapena. Hegoaldeko goi-lautadan dago.
Ezaugarriak. Erdialdeko Sistemak baino altitude txikiagoa du; bi haran ditu alde banatan: Tajorena (iparraldean) eta Guadianarena (hegoaldean).
Mendilerro nagusiak. San Pedro eta Guadalupe dira nabarmenenak; hantxe dago mendi garaiena, Villuercas mendia (1 601 m).
132 GUADIANA Almanzor 2 592 Las Villuercas 1 601 KANTAURIAR ERDIALD R R A M O Leongo mendiak Teleno ml. Segundera ml. Europako Gredos ml. Gml. ata ml. Guadalupe San Pedro ml. Aracena ml.Hornachuelos ml. Duer oren Tajoren ibarra Guadianaren ibarra PORTUGAL Ibaia Tontorra Urtegia Altitudea (m) 3 500 2 000 1 500 1 000 700 400 0 Iberiar goi-lautadako mendiak eta haranak 3
Zer erlieberen berri jakin behar dugu, Iberiar penintsulan ekonomia-jarduerak modu arduratsuan aurrera atera nahi baditugu?
1 Zein dira Iberiar goi-lautadaren ezaugarri nagusiak?
2 Zertan dira desberdinak Erdialdeko Sistema eta Toledoko mendiak?
3 Zein da Iberiar goi-lautadaren barnealdeko mendirik garaiena? Eta ertzekoa? Zer altitude-alde dago bi mendien artean?
Leongo mendiak
Kokapena. Goi-lautadaren ipar-mendebaldeko ertzean daude.
Ezaugarriak. Hainbat mendi garai dira. Mendilerro nagusiak. Segundera mendilerroa da nagusi; hantxe dago mendi garaiena, Teleno (2188 m).
Kantauriar mendikatea
Kokapena. Penintsulako iparraldean dago, eta Iberiar goi-lautada eta Kantauri itsasoaren kostaldea bereizten ditu.
Ezaugarriak. 480 kilometro inguruko luzera du, eta Europan mendebaldeen dagoen mendikatea da.
Mendilerro nagusiak. Gailurrik garaiena, Torre cerredo (2648 m), Europako mendietan dago.
Iberiar sistema

Kokapena. Goi-lautadaren ekialdeko ertzean dago, haren eta Ebroren sakonunearen artean. Mendilerro nagusiak. Hona hemen nabarmenenak: Urbión mendiak, eta Albarracín eta Moncayo mendilerroak; azken horretan, Moncayo (2 313 m) da mendi garaiena.
Kokapena. Penintsulako hegoaldean dago, eta Iberiar goi-lautada eta Guadalquivirren sakonunea bereizten ditu.
Mendilerro nagusiak. Hornachuelos, Aracena eta Sierra Madrona; hantxe dago mendi garaiena, Bañuela (1 323 m).

4 Egin landu dituzun erliebe-unitateei buruzko fitxa bana.
Mendikatearen izena ?
Kokapena ?
Mendilerro nabarmenenak ?
Mendi garaiena ?
U7 DUERO TAJO Torrecerredo 2 648 Moncayo 2 313 Bañuela 1 323 MENDIKATEA IBERIAR SIS T E M A EKO SISTEMA R E N A IPAR GOI-LAUTADA HEGO GOI-LAUTADA Toledoko mendiak mendiak Guadarrama Somosierra Urbión mendiak ml . Albarracín Madrona ml. ibarra 0100200km
Sierra Morena
Zer erliebe forma daude Penintsulan?
Goi-lautadaz kanpoko unitateak
Galiziako mendigunea
Kokapena. Penintsularen ipar-mendebaldeko muturrean dago.
Ezaugarriak. Erliebea koska gutxikoa da, eta mendiek tontor biribildua eta altitude txikia dute.
Mendilerro nagusiak. Cabeza de Manzaneda (1 778 m) da mendiguneko mendi garaiena.
Goi-lautadaz kanpoko unitateak
Euskal Mendiak Pirinioak
Kokapena. Penintsulako iparraldean daude, Kantauriar mendikatearen eta Pirinioen artean.
Ezaugarriak. Lerrokatu gabeko mendi multzo bat da, eta erliebe aldakorra dute.
Mendilerro nagusiak. Altueragatik, Aizkorri (1 528 m) bereizten da.
Kokapena. Penintsulako ipar-ekialdean daude, eta Bizkaiko golkotik Creus lurmuturreraino hedatzen dira. Espainiaren, Andorraren eta Frantziaren arteko muga naturala da.
Ezaugarriak. Mendi gazteak dira, eta altitude handia dute.
Mendilerro nagusiak. Aneto (3 404 m) da mendi garaiena.
Kataluniako kostaldeko mendikatea Mendikate Betikoak
Kokapena. Pirinioen eta Ebro ibaiaren bokalearen artean dago, eta Kataluniako kostalde osoan barrena hedatzen da.

Ezaugarriak. Altuera txikiko mendilerroen paisaia bat eratzen du. Mendilerro nagusiak. Turó de l’Home (1 712 m) da mendi garaiena.
Kokapena. Penintsulako hego-ekialdean daude, eta Gibraltar itsasartetik Nau lurmuturreraino hedatzen dira.
Ezaugarriak. Bata bestetik ia paraleloki lerrokatuta dauden bi mendikate bereizten dira: Mendikate Penibetikoak eta Mendikate Subbetikoak.
• Mendikate Penibetikoa. Kostaldetik gertuen dagoena da, bai eta garaiena ere. Sierra Nevadan dago Mendikate Betikoetako eta Penintsulako mendi garaiena: Mulhacén (3 479 m).

• Mendikate Subbetikoa. Barnealdean dago, Sierra Morenatik eta Iberiar goilautadaren hegoaldeko ertzetik gertuago.
1 Zein dira Iberiar goi-lautadaz kanpoko erliebearen unitateak?
2 Binaka, bildu orain arte landutako erliebearen unitateak identifikatzen laguntzeko moduko pistak. Listo zaudetenean, bikotekide bakoitzak aukeratu dezala unitate bat, eta hasi dadila pistak banan-banan esaten. Pista bakarra aski baduzu erliebe-unitatea zein den asmatzeko, hiru puntu irabaziko dituzu; bi behar badituzu,
bi puntu irabaziko dituzu; hiru pista edo gehiago behar badituzu, puntu bat irabaziko duzu.
3 Zertan dira antzekoak Ebroren sakonunea eta Guadalquivirrena?
4 Bisitatu duzu noizbait Iberiar penintsulako barnealdeko erliebe-unitateren bat? Egin aurkezpen labur bat zure bidaiaren irudiekin, eta azaldu ikaskideei ikusitakoaren nondik norako guztiak.
134 3
Gogoan



Guadalquivirren sakonunea Ebroren sakonunea Mulhacén 3 479 Veleta 3 396 Aneto 3 404 Cabeza de Manzaneda 1 778 Aizkorri 1 528 Turó de l’Home 1 712 P I R I N I O A K MENDIKATE SUBBETIKOA MEN D I K A T E P E N I B E TIKOA Kataluniakoitsasertzeko mendikatea Galiciakomendigunea Euskal mendiak Baza ml. La Sagra ml. Sierra Nevada Cazorla ml. Seguraml. a Kantauri itsasoa Ajo lurmuturra Estaca de Bares lurmuturra Gata lurmuturra Palos lurmuturra Nao lurmuturra Creus lurmuturra Ebroren delta V a l e n tz iako golkoa Peñas lurmuturra Bizkaikogolkoa Gibraltarko itsasartea Cádizko golkoa Finisterre lurmuturra Doñanako M e d i t e r r a n eo its a s o a OZEANO ATLANTIKOA FRANTZIA PORTUGAL ANDORRA MAROKO ALJERIA 0100200300km Iberiar goi-lautadaren kanpoko mendiak eta ibarrak Ibaia Tontorra Urtegia Altitudea (m) 3 500 2 000 1 500 1 000 700 400 0
Plastikozko poltsen batez besteko erabilera 12 minutukoa da; erabat degradatzeko, baina, 5 hamarkada behar dituzte. Aurkitu duzu noizbait halako hondakinik naturan? hartu!
Berdina al da Espainiako kostalde osoa?
Zer hartu behar dugu aintzat gure kostaldeetan ekonomiajarduerak garatzeko?
Espainiako kostaldeak 5 970 km ditu gutxi gorabehera, Iberiar penintsularen, Balear eta Kanaria uharteen, eta Ceuta eta Melilla hirien artean banatuta. Kostalde atlantikoaren eta kostalde mediterraneoaren artean aldeak daude.


Kostaldea Kokapena Ezaugarriak
Kantauriarra Bidasoa ibaiaren bokalean hasten eta Ortegal lurmuturreraino iristen da.
Kostalde garaia, malkartsua, harritsua eta zuzena da.
Elementu nagusiak
Matxitxako, Ajoko eta Peñas lurmuturrak. Bizkaiko golkoa.
Galiziakoa Ortegal lurmuturrean hasten eta Miño ibaiaren bokaleraino iristen da.
Andaluziakoa Guadiana ibaiaren bokalean hasten eta Gibraltarko itsasarteraino iristen da.



Galiziako kostalde atlantikoaren iparraldea Rías Altas da, eta hegoaldea, Rías Baixas. Itsasadarrak tarteko, hain zuzen, kostaldea oso koskatua da, bai eta garaia eta harritsua ere.

Zuzena, baxua eta hareatsua da, eta hondartza handiak ditu.
Itsasadarrak: Arousa, Vigo eta Pontevedra. Fisterra lurmuturra.
Dunak eta padurak ditu. Cádizko golkoa. Trafalgar lurmuturra.
Hegoaldekoa Gibraltarko itsasartean hasten da eta Murtziako Eskualdearen eta Valentziako Erkidegoaren arteko hegoaldeko mugaraino iristen da.
Ekialdekoa Valentziakoa. Segura ibaiaren ibar beherean hasten eta Ebroren deltaraino iristen da.
Kataluniakoa. Ebroren deltan hasten eta Frantziako mugaraino iristen da.
Kostalde garaia, malkartsua, harritsua eta zuzena izateagatik nabarmentzen da.
Gata eta Palos lurmuturrak. Almeríako golkoa.
Kostalde baxu eta hareatsua da, eta, oro har, hondartza handiak ditu.
Nau lurmuturra
Koskatua, garaia, malkartsua eta harritsua da. Creus lurmuturra. Rosesko golkoa.
136 4
Kostalde atlantikoa
Kostalde mediterraneoa
Atlantikoko kosta
Kantauriko kosta
Galiziako kosta atlantikoa
Andaluziako kosta atlantikoa


Mediterraneoko kosta
Hegoko kosta mediterraneoa
Ekialdeko kosta mediterraneoa: Levantekoa
Ekialdeko kosta mediterraneoa: Kataluniakoa
Kanaria uharteetako erliebea
Kokapena. Ozeano Atlantikoan daude, Afrika iparraldeko kostaldearen parean.

Ezaugarriak:
Erliebea. Menditsua eta sumendi-jatorrikoa da, eta, hori dela eta, oso paisaia berezia dute. Tenerife uhartean dago Espainiako mendirik altuena: Teide (3 718 m).
Kostaldea. Oro har, kostaldea altua, malkartsua eta koska handirik gabea da, baina uharteetako hegoaldean hondartzak daude: ekialdekoak harrizkoak dira, eta mendebaldekoak, hareazkoak.
Balear uharteetako erliebea
Kokapena. Mediterraneo itsasoan dago, Valentziako kostaldearen parean.
Ezaugarriak:

Erliebea. Oro har, menditsua eta Penintsulako erliebearen antzekoa da. Mallorca, Eivissa eta Formenteran, erliebea Mendikate Penibetikoaren luzakin bat da, eta Menorcan, Kataluniako kostaldeko mendikatearena. Uharteetako mendi garaiena, Puig Major (1 445 m), Mallorcan dago, Tramuntana mendilerroan.


Kostaldea. Garaia eta koskatua da, eta kalak ditu, batez ere Mallorca eta Menorca iparraldean.
Gero eta ohikoagoa da influencerrek bizi garen natura-inguruneen egoera salatzea beren sare sozialetan. Hona hemen, adibide modura, zenbait
post, arazo horren berri ematen dutenak. Jakingo al zenuke esaten zer kostaldetan atera den argazki hauetariko bakoitza?
Princess_cons19 ●●●
kostaldean pasieran ibili, eta hau aurkitu ez dugu, ba? Oporrak horrela? Gero, zikinkeria hori guztia Kantauri itsasora iritsiko da. #bizitzajasangarria #horrelaez
Head_JL Hauxe egiten diogu etengabe gure Rías Baixas maiteari. Bihotzak krak egiten dit. #stopplastikoak #bizitzajasangarria
Princess_cons19 Konponbideak behar ditugu Mar Menor salbatzeko. ORAIN! Murtziako kostaldeak ez du hau merezi.
#bizitzajasangarria #SOSmarMenor
U7 137
Teide 3 718 OZEANO ATLANTIKOA KANARIA K BALEARRAK Puig Major 1 445
FRANTZIA ANDORRA Kantauri itsasoa OZEANO ATLANTIKOA
Ceuta
PORTUGAL
M editerraneo itsaoa
Melilla itsasartea Almeríako golkoa Sant Jordi golkoa Rosesko golkoa
Valentziako golkoa
Bizkaiko Golkoa Mar Menor
Cádizko golkoa
Matxitxako lurmuturra
lurmuturra Ajo lurmuturra
Nau lurmuturra
Gibraltarko Peñas lurmuturra Ortegal lurmuturra
Creus lurmuturra Finisterre
Gata lurmuturra Palos lurmuturra
Ebroren delta Trafalgar lurmuturra
Ekhi_lore ●●●
Ekhi_lore Euskadiko
Head_JL ●●●
Zer ezaugarri ditu gure erkidegoko erliebeak?
Zer ekoizpen- eta kontsumo-jarduera egiteko
aukera ematen du Euskadiko erliebeak?
Kostako erliebea
Gure kostaldea koskatsua da, sargune eta irtengune ugarikoa, Bizkaian batez ere.
• Sargune horien artean aipatzekoak dira Bilboko eta Debako itsasadarrak, Donostiako Kontxako badia, bai eta Zarautz, Mundaka eta Plentziako hondartzak ere.
• Irtengune aipagarrienak, berriz, hauek dira: Matxitxako, Villano, Ogoño, Plata eta Higer lurmuturrak eta Getariako San Anton mendia, besteak beste
Ibarrak
Erkidego osoan daude.




• Kostako ibarretatik, urak Kantauri itsasora isurtzen dituzten ibaiak igarotzen dira; horrelakoak dira, esaterako, Nerbioi, Deba eta Oria ibaien ibarrak.
• Hegoaldeko ibarren artean, aipatzekoak dira Zadorrarena eta Ebrorena.
Lautadako erliebea
Euskal mendiek hegoaldera eratzen duten lerroak bi lautada handi bereizten ditu.
• Arabako Lautadak Arabako lurraldearen ia erdialde osoa hartzen du. Zadorra ibaiak zeharkatzen du lautada, eta bertan dago Arabako hiriburua: Gasteiz.
• Arabako Errioxa lurraldearen hegoaldeko muturrean dago, eta Ebro ibaiak bustitzen ditu inguruok, gure erkidegoan barrena egiten duen ibilbidean.

Mendiko erliebea
Aipatzekoak dira Aralar, Urkilla eta Aizkorri mendilerroak , eta Gorbeia eta Gorobel mendiguneak . Mendilerro horietan daude Euskal Autonomia Erkidegoko mendirik altuenak: Aketegi (1 551 m), Aizkorri (1 523 m) eta Gorbeia (1 481 m).
Iparrera Oiz mendia eta Ernio mendia daude; hegoaldera, Euskal mendiak, eta tartean Urbasa eta Arkamo mendilerroak eta Gasteizko mendiak, besteak beste.
Euskal kostaldeko flyscha (labaingarri esan nahi duen jatorri alemaneko hitza da) munduko garrantzitsuenetakoa da. Harri gogorren geruzak (kareharriak, arbelak edo hareharriak) eta material bigunagoko geruzak (tuparriak eta buz- tinak) tartekatzean sortzen da gure itsaslabarren forma berezi hori.
Bereziki ikusgarriak dira Zumaia eta Deba arteko kostaldeko flyschak

1 Erlazionatu zure herria erliebeetako batekin eta deskribatu ezaugarri nagusiak.
2 Zer desberdintasun dago kostaldeko sarguneen eta irtenguneen artean?
3 Erreparatu eskuineko orrialdeko lau argazkiei eta egin honako ariketa hauek:
a) Adierazi bakoitzeko erliebe mota.
b) Adierazi zer esku-hartze izan duen gizakiak paisaian eta nola aldatu duen.
c) Zer barne- edo kanpo-eragilek aldatu dute argazki bakoitzeko paisaia?
138 5
Zumaiako flyscha
Ingurumena, gizartea eta ekonomia errespetatzen dituzten turismoekimen asko daude Euskadin. Urdaibaiko Biosferaren Erreserba, esaterako, Euskadiko lehen helmuga jasangarri izendatu zuen Europarc nazioarteko agentziak.






Tontorra Euskadiko erliebea Probintziaren hiriburua Erakunde batzuen egoitza Ibaia Autonomia-erkidegoaren muga Probintziaren muga Altitudea (m) 1500 1000 700 400 200 0 1 Aketegi 1551 2 Aizkorri 1523 3 Gorbeia 1481 0 25 50 km E U S K A L M E N D I A K Urbasa mendilerroa mendilerroaDurangaldeko G asteizko mendiak Aralar ml. Arkamo ml . Urkilla ml. Elgea ml. Toloño mendilerroa ml . Árcenamendilerroa Gorobel Ordunteko mendiak Gorbeia mendigunea Aizkorriml . Sollube 684 Oiz 1026 Anboto 1331 Ernio 1078 1 2 3 Z a dorrarenibarra Ebroren ibarra Arabako Errioxa Arabako Lautada N erbioi-Ibaizabalen ibarra Ori aren i arrab Urolaren i ba r r a De ba r e n i b a r r a Donostia Bilbo Gasteiz NAFARROAKO FORU ERKIDEGOA GAZTELA ETA LEON ERRIOXA KANTABRIA BIZKAIA GIPUZKOA ARABA Kantauri itsasoa BilbokoitsasadarraPlentziako itsas Debakoitsasadarra Oriokoitsasadarra Mundakako itsasadarra Villano lurmuturra Higer lurmuturra Matxitxako lurmuturra Ogoño lurmuturra San Anton mendia Pasaiako lurmuturra
Getaria
Gorbeiako Parke Naturala
Arabako Lautada Tolosa, Oriaren ibarra
Gogoan hartu!
Nolakoa da Europako erliebea?
Alde handiak al daude Espainiako erliebearen eta Europakoaren artean?
Europa
Kokapena. Gure kontinentea Ipar hemisferioan dago. Hedadura. Ozeaniaren ondoren, bigarren kontinente txikiena da, eta 10 530 751 km2-ko hedadura du. Europak eta Asiak Eurasia izeneko eremu edo superkontinentea osatzen dute.



Mugak. Iparraldean, Ozeano Artikoa; hegoaldean, Mediterraneo itsasoa; ekialdean, Ural mendiak, Kaspiar itsasoa, Kaukaso eta Itsaso Beltza; mendebaldean, Ozeano Atlantikoa.
Barnealdeko erliebea
• Mendigune eta mendi zaharrenak. Ez dira oso mendi garaiak, tontor biribildua dute, eta kontinentearen iparraldean eta erdialdean daude. Nabarmenenak: Frantziako Erdialdeko Mendigunea, Eskandinaviako mendiak, eta Ural mendiak, Europaren eta Asiaren arteko muga naturala.
• Mendi gazteak. Oso garaiak dira, eta kontinentearen hegoaldean daude. Nabarmenenak: Pirinioak, Alpeak, Apeninoak, Karpatoak eta Kaukaso; azken horretan dago Europako mendirik garaiena, Elbrus (5 642 m).

• Lautadak. Lur-eremu lau handi-handiak dira, eta kontinentearen erdialdean daude. Europako Ordoki Handia da nabarmenena.
Kostaldeko erliebea
Europako kostaldea nahiko koskatua da: penintsula
ugari ditu, hala nola iberiarra, italiarra eta Balkanetakoa, bai eta lurmuturrak ere, hala nola Ipar eta Fisterra, eta golkoak ere bai, hala nola Genovakoa eta Bizkaikoa.
Uharteak ere asko dira:
• Ozeano Atlantikoan: Islandia, Britainia Handia, Irlanda, Azoreak, Madeira, Kanariak…
• Mediterraneo itsasoan: Korsika, Sardinia, Sizilia, Malta, Kreta, Zipre, Balearrak…

140 6
Mulhacén 3 478 Pirinioak A Erdialdeko Mendigunea Iberiar penintsula Finisterre lurmuturra San Vicente lurmuturra Balearrak Madeira uhartedia Kanariak Azoreak Islandia Groenlandia Irlanda Britainia Handia Liongo golkoa Valentziako golkoa Gibraltarko itsasartea Bizkaiko golkoa M OZEA
Ipar itsasoa Kantauri itsasoa Norvegiako itsasoa Ibaia Aintzira Tontorra Altitudea (m) 4 000 3 000 2 000 1 000 500 200 0 –500 02004006008001000km EUROPA AFRIKA ASIA Ekuatorea Frantziako Erdialdeko Mendigunea
OZEANO ATLANTIKOA
1 Idatzi gure kontinentearen hiru ezaugarri.
2 Kalkatu Europako mapa bat. Legenda honi jarraituz, inguratu edo adierazi:

• Horiz: Atlantikoko uharteak
• Urdinez: Mediterraneo itsasoko uharteak

• Berdez: mendigune eta mendi zaharrenak
• Laranjaz: mendi gazteak
• Morez: penintsulak

• Gorriz: 4 lurmutur
• Arrosaz: 4 golko

3 Zein dira Europako mugak?
4 Zerk bereizten du Europa Asiatik eta Afrikatik? Erabili mapa.
5 Rakel, Samuel eta Xabier zientzialariak dira, eta Europako inguru menditsuetan ekoizpenak eta kontsumoak zer-nolako ondorioak dituen neurtu nahian ari dira. Lanari Eskandinaviako mendietan ekiten badiote, zer ibilbide egin beharko dute handik abiatu eta Mendikate Betikoetaraino iritsi arte? Adierazi mapa batean zer ordenatan kanpatuko duten mendikate bakoitzean.
Europak munduko aztarna ekologiko handienetako bat du.
Gainerako kontinenteetan Europan bezala biziko balira, gurearen moduko bi planeta baino gehiagotako baliabideak beharko lirateke hori jasateko.
U7 141 E u r o p a k o O r d o k i H a n d i a Mont Blanc 4 810 Elbrus 5 642 A L P E A K U R A L M ENDI A K K A U K A S O K a r p a toak Eskandinaviako mendiak Apeninoak Eskandinaviako penintsula Italiar penintsula Balkanetako penintsula Peloponeso penintsula Jutland penintsula Kola penintsula Ipar lurmuturra Sizilia Sardinia Malta Korsika Kreta Zipre Botniakogolkoa Genovako golkoa Itsaso B a l t i k o a M e d i t e r r a n e o i t s a s o a I t s a s o B e l t z a Kaspiaritsasoa NO
Norvegiako itsasoa
ARTIKOA
Gogoan hartu!
Alpeak Europako Ordoki Handia
1 Esplikatu zure koadernoan nola aldarazten dituzten paisaiak barne- eta kanpo-eragileek. Idatzi eragile mota bakoitzaren adibide bat.
2 Marraztu Iberiar penintsulako mapa bat, eta adierazi han Espainiak zer muga dituen iparraldean, hegoaldean, ekialdean eta mendebaldean.
3 Aurreko jardueran marraztutako mapan, adierazi non dauden erliebearen unitate hauek:
Pirinioak, Iberiar sistema, Kantauriar mendikatea, Galiziako mendigunea, Leongo mendiak, Fisterra lurmuturra, Creus lurmuturra, Kantauri itsasoa, Iberiar goi-lautada, Erdialdeko Sistema, Toledoko mendiak, Mendikate Betikoak, Sierra Morena, Cádizko golkoa, Gata lurmuturra, Kataluniako kostaldeko mendikatea, Tramuntana mendilerroa, Guadalquivirren sakonunea, Ebroren sakonunea.
4 Ordenatu altuenetik baxuenera Espainiako lau mendi garaienak, eta esan zer mendikatetan dagoen bakoitza.
5 Aukeratu erantzun zuzena kasu bakoitzean:
• Hauetako zeinek banatzen du Iberiar goi-lautada bi multzotan?
a) Iberiar sistemak
b) Erdialdeko Sistemak
c) Sierra Morenak
• Zer mendi daude Leongo mendien eta Iberiar sistemaren artean?
a) Galiziako mendigunea
b) Toledoko mendiak
c) Kantauriar mendikatea
• Zein da Iberiar penintsularen barnealdeko hegoaldean hasten eta Mallorca uharteraino iristen den mendikatea?
a) Mendikate Penibetikoa
b) Pirinioak
c) Kataluniako kostaldeko mendikatea
• Zer sakonune dago Pirinioen eta Iberiar sistemaren artean?
a) Guadalquivirren sakonunea

b) Ebroren sakonunea
6 Lotu kostalde hauek bakoitzaren ezaugarri nagusiekin:
Kostalde kantauriarra
Galiziako kostalde atlantikoa
Andaluziako kostalde atlantikoa
Hegoaldeko kostalde mediterraneoa
Ekialdeko kostalde mediterraneoa
Garaia, hareatsua eta, itsasadarrak tarteko, koskatua
Zuzena, baxua eta hareatsua
Zuzena, garaia, malkartsua eta harritsua
Eskualdearen arabera, baxua eta hareatsua izan daiteke, edo garaia, koskatua, malkartsua eta harritsua
Zuzena, garaia eta malkartsua, baina tarte lauekin
7 Konparatu Kanaria eta Balear uharteak. Eman informazio hau: uharte kopurua (eta izenak), zer itsaso edo ozeanotan dauden, erliebearen eta kostaldearen ezaugarriak, etab.
8 Aurkitu hitz arrotza Europako erliebeari buruzko zerrenda hauetan, eta jarri dagokion multzoan.
• Penintsulak: italiarra, iberiarra, Irlanda, Kola, Eskandinaviakoa eta Balkanetakoa.
• Mendi gazteak: Pirinioak, Apeninoak, Karpatoak eta Ural mendiak.
• Mendigune eta mendi zaharrak: Frantziako Erdialdeko Mendigunea, Kaukaso eta Eskandinaviako mendiak.
• Uharteak: Britainia Handia, Jutlandia, Islandia, Malta eta Sizilia.
9 Gizakiok erliebean esku hartzen dugun moduetatik zein dira, zure ustez, ingurumena gehien kaltetzen dutenak? Azaldu arrazoia. Gero, hitz egin zure erantzunaz ikaskideekin
Semaforoa. Margotu koadernoan, ariketa bakoitzaren ondoan, honela:
erantzuna badakizu
laguntza behar izan baduzu
erantzuna jakin ez baduzu
142 PORTFOLIOA
Z
er ikasi dut?
HELBURUA AURRERA
Jakinarazi zein garrantzitsua den ekoizpen eta kontsumo arduratsuaren aldeko ekintzak martxan jartzea
1 Ekoizpen eta kontsumo arduratsuaren aldeko ekintzek zer-nolako garrantzia duten aztertzeko, Iparrorratza edo puntu kardinalak: E-M-I-H pentsamendu-teknika erabil daiteke. Ikasleek landutako ideia bakoitzaren ertz guztiak aintzat hartu beharko dituzte, antolatzaile grafikoan proposatzen zaienarekin bat etorriz. Jarduera bakarka egitekoa da, baina gero, amaitzean, ikaskideek galderak egin beharko dizkiote elkarri.

E = Gogo handia/Zirrarak: Zertan gogoberotzen zaitu proposatutako ideiak edo egoerak? Zer alderdi on ditu? Zerk pizten dizu zirrara?
M = Oztopoa/Kezka: Zer oztopo edo zailtasun ditu proposatutako ideiak edo egoerak? Zer-nolako kezka eragiten dizu? Zer alderdi txar ditu?
I = Beharrizana: Zer besterik jakin behar duzu? Zer informazio behar duzu gaia hobeto ulertzeko?


H = Iradokizunak/Jarrerak: Zein da zure jarrera edo zer iritzi duzu proposatutako ideiaz edo egoeraz? Zer iradokizun edo ekimen proposatuko zenituzke egoera hobetzeko?
Ideia guztiak, bai bakarka eta bai taldean proposatutakoak, oso aproposak gertatuko zaizkizue zuen deialdia sare sozialen bidez zabaltzeko. Horretan, zuen erkidegoko jendearengana iristeko zenbanahi baliabide erabil ditzakezue, hala nola irudien argitalpena, bideoak, testu luzea duten postak, tweetak, etab.
Galdetu hau zeure buruari!
N ola ikasi dut?
1 Ikasi duzu lehen ez zenekien zerbait? Zer irudi gogoratzen dituzu? Ikasi duzunetik zer gustatu zaizu gehien? Zertarako da baliagarria ikasi duzuna?
Zertarako balioko dizu zure eguneroko bizitzan?
2 Pentsatu zertan hobetzen jarraitu dezakezun aurrerantzean eta egin horri buruzko gogoeta. Hausnarketa zabaltzeko, pentsatu zer hobetu dezaketen ikaskideek.
Zure ustez, gure planetako biztanleek badute kontzientziarik gaur egungo gure bizimoduak dakartzan arazoez eta ingurumenari egiten diogun kalteaz?
Sare sozialek badute ahalik, zure ustez, lehen baino pertsona gehiagorengana iritsi eta jendea arazoez kontzientziatzeko? Ba ote dago ideiak komunikatzeko modu hoberik?
Litekeena al da gure ekintzek ingurumenean eragiten dituzten ondorioen benetako kalteez ez konturatzea, eta, beraz, ondorio larriagoak behar izatea horretaz jabetzeko?
U7 143
Beharrizana
Iradokizunak/Jarrerak
Oztopoa Kezka
Gogo handia Zirrarak
Ur-eskasia, benetako arazo bat?
Txikiak garenetik, ura bizitzarako oinarri-oinarrizko elementua dela ikasten dugu; hain da garrantzizkoa, batzuek urre urdina deitzen baitiote. Azken hamarkadetan, munduko biztanle kopurua hazi eta natura-baliabideak gaizki kudeatu izanaren ondorioz, ustekabeko arazo bati egin behar izan diogu aurre: ur-eskasiari. Eta zer da, bada, ur-eskasia? Bada, ureskaria ase ezin izatea, izugarri handia delako eta horrek kalitateari eta horniketari eragiten dielako.
UNESCO Hezkuntza, Zientzia eta Kulturarako Nazio Batuen Erakundearen arabera, ur-eskasiak 5 000 milioi laguni erasango omen die hemendik 2050. urtera bitartean. Klima-aldaketa, eskariaren gorakada eta hornitzekoa den uraren kutsadura: horra hor, besteak beste, arazoaren eragile nagusiak.

Zer deritzozu?
Pentsatu duzu noizbait giza kontsumorako urik gabe gera gaitezkeela? Zer-nolako arazoei egin behar diete aurre, zure ustez, gaur egun ataka horretan dauden gizon eta emakumeek? Guri ere eragin al diezaguke arazoak?



Datua
Unitate honetarako...
Helburua aurrera
Idatzi gutun bat Europako Batzordeari, eta jakinarazi ur-eskasiagatik kezkatuta zaudela; aldi berean, martxan jarri arazoa arintzeko politiken aldeko sinadura-bilketa bat.
Jarraitu hariari!
Ur-eskasiak munduko biztanleen % 40ri baino gehiagori eragiten die. Gaur egun, mundu osoan 1700 milioi lagun inguru bizi dira beren premiak asetzeko adina ur ematen ez duten ibaien arroetan.
Planetako urak: hidrosfera
1
Gure planetaren zer zati estaltzen du urak?
Ibaiak eta gainerako ur kontinentalak
2
Nolakoak dira urmasa gezak?
144
8
Espainiako hidrografia
3
Zein dira Espainiako ibai eta aintzira nagusiak?
EAEko hidrografia






4
Nolakoak dira gure erkidegoko urak?
Europako hidrografia
5
Nolakoak dira Europako urak?
6
Uraren kontsumo arduratsua Zer hartu behar dugu aintzat ura erabiltzen dugunean?
145 6
Gure planetaren zer zati estaltzen du urak?
Lurreko ur guztia giza kontsumorako egokia al da?
Uraren zer ehuneko da erabiltzeko modukoa?
Hidrosfera


Lurreko ur-masa guztien multzoa da: lurgaineko urena (itsasoak, ozeanoak, ibaiak, aintzirak…), lurpeko urena eta atmosferan lurrundurik dauden urena. Ur horrek guztiak Lurraren gainazalaren % 70 inguru estaltzen du, eta, kalkulu batzuen arabera, planetan 1 400 trilioi ur daude.

Ezaugarri nagusiak
• Hidrosfera oinarri-oinarrizkoa da planetako izaki bizidun guztientzat.


• Etengabe ari da fisikoki eta kimikoki aldatzen: uraren egoerak eta uraren zikloa.
• Ura oinarri-oinarrizko elementua da itsasoko eta lehorreko ekosistemetan.
• Urak eta lurrazalak elkarri eragiten diote; zehazki hitz eginda, urak Lur planetaren egitura aldatzen du higaduraren bidez.
• Ehuneko txiki bat baino ez da egokia (% 1, gutxi gorabehera) gizakion eta beste izaki bizidun batzuen kontsumorako.
Uren sailkapena
Lurgainekoak
Lurraren gainazalean ikusteko moduan dauden ur-masak dira. Bi multzo handi bereiz daitezke:
• Ur kontinentalak. Ibaiak, aintzirak, errekak, urmaelak, elurra, poloetako izotz-masak… Ur-masa horiek guztiak (planetako uraren % 2,5) gezak izan ohi dira.
• Itsasoko urak. Ozeano eta itsasoetako urak dira. Ur-masa horiek handi-handiak dira, eta Lurraren gainazalaren % 97,5 estaltzen dute.
Lurpekoak
Euri-ura eta lurgaineko urak lurzoruan barrena iragazten eta lurraren barnealdean pilatzen dira akuifero izeneko metakinetan. Lurpean, urek leizeak eta zuloak sortzen dituzte, eta batzuetan gainazalera ateratzen dira, eta iturburu edo ur-begiak sortzen dituzte. Ur hori lortzeko beste modu bat ere badago; hots, lurra zulatu eta putzuak sortzea.
«Berehala kontatuko dizut»: unitatearen laburpena eskuragarri duzu anayaharitza. es webgunean.
Ur gazia % 97,5
Ur
% 2,5
20
Lurgaineko ur geza % 1

146 1
Planetako ura, guztira
Ur geza, guztira
geza
Izotza % 79 Lurpeko urak %
Lurgaineko urak
Lurpeko urak
Hidrosferaren garrantzia


• Lurraren tenperatura erregulatzen laguntzen du, ibai eta itsasoetako urak eguzki-beroa xurgatzen baitu; izan ere, ura airea baino askoz mantsoago berotzen eta hozten da.
• Ura zelula bizien parte da. Urik gabe, zelulak ez lirateke beren ohiko funtzioak egiteko gai izango, eta, beraz, ezinezkoa litzateke bizitza egotea.
• Ura oinarri-oinarrizko elementua da landareek fotosintesia egiteko; prozesu horren bidez, hain zuzen, arnasa hartzeko ezinbestekoa den oxigenoa sortzen da.

• Uretako ekosistemetan izaki bizidunen erreinuetako ezin konta ahala espezie bizi dira.
• Gizon-emakumeok egunero erabiltzen dugu ura garbitzeko, aisialdirako, industriarako, garraiorako, etab.
Uraren banaketa Lur planetan

Gure planetan ura nola banatzen den erakusten duen grafikoan oinarriturik, erantzun galdera hauei:
• Lur planetako ur gezaren zer ehuneko dago likido-egoeran?
• Uraren zer ehuneko da lurgaineko ur geza?

• Zer hausnarketa pizten dizute datu horiek?
1 Nola sailkatzen dira hidrosfera osatzen duten urak?
2 Bilatu informazioa eta erantzun. Zergatik da gazia itsaso eta ozeanoetako ura? Nolakoa da ozeanoetan flotatzen duten izozmendietako ura, gazia ala geza?
Lurreko ur geza gehiengehiena izoztuta dagoenez, giza kontsumorako egokia den ur likidoa % 1 besterik ez da.

U8 147
Ihintz tantak landareetan Uretako ekosistema
Gogoan hartu!
Nolakoak dira ur-masa gezak?
Ibaiak
Ibaiak ur gezako ur-lasterrak dira, mendietan sortzen eta itsasora, ozeanora edo beste ibaietara isurtzen direnak. Urak beste ibaietara isurtzen dituztenei ibaiadar esaten zaie.
Ibaien elementuak
• Iturburua. Ibaia sortzen den lekua. Euri-ura edo urtzaldietako ura pilatzeagatik sortu daitezke ibaiak, edo lurpeko urak lurgainera ateratzeagatik.
• Ibilbidea. Ibaiak sortzen denetik isurtzen den arte egiten duen bidea.
– Goiko ibilbidea. Iturburutik gertuen dagoen tartea, malda handia izan ohi duena; horren ondorioz, urak bizi-bizi jaisten dira.
– Erdiko ibilbidea. Goiko eta beheko ibilbideen arteko tartea. Malda oso gorabeheratsua denez, bidearen tarte batzuk higadura handikoak dira, eta beste batzuetan, berriz, ibaiak materialak jalkitzen ditu.
– Beheko ibilbidea. Bokaletik gertuen dagoen tartea. Ia ez du maldarik, eta ibaia mantso-mantso iragaten da, meandro izeneko bihurgune itxiak eginez.
• Bokalea. Ibaiak itsasoarekin edo ozeanoarekin bat egiten duen tartea. Jalkin-pilaketaren ondorioz, deltak edo estuarioak eratu daitezke.

• Ibilgua. Ibaiak bere ibilian sortzen duen bidea.


• Arroa. Itsaso edo ozeano berera isurtzen diren ibaiak biltzen dituen lurraldeen multzoa.

Ibaien ezaugarriak
• Luzera. Ibaia sortzen den iturburuaren eta urak isurtzen dituen bokalearen artean dagoen distantzia.

• Emaria. Ibaiak tarte eta denbora jakin batean daraman ur kantitatea.
• Erregimena. Urtean zeharreko emari-aldaketa. Erregimen erregularrekoak dira urtearen joanean emaria gutxi aldatzen zaien ibaiak, eta erregimen irregularrekoak, berriz, urteko sasoi batzuetan ia erabat lehortzen direnak eta beste batzuetan emaria asko handitzen zaienak.
148 2
Kontuan izaten al dugu ur-eskasia baliabide hidrikoak kudeatu behar izaten ditugunean?
Goiko ibilbidea
Erdiko ibilbidea
Beheko ibilbidea
Lurreko ur-masa gezak
Ikertu planetako ur gezaren zer ehuneko dagokion ur-masa hauetariko bakoitzari:
• Ibaiak.
• Aintzirak.


• Lurpeko urak edo akuiferoak.
• Glaziarrak.
Ibaietan eragina duten faktoreak
• Erliebea. Ibaiaren luzeran eta uren abiaduran du eragina. Ibai bat sortzen den mendia haren urak isurtzen diren bokaletik zenbat eta urrunago egon, ibaia orduan eta luzeagoa izaten da.
• Klima. Ibaien emarian eta erregimenean du eragina. Etengabe euri asko egiten duen klimetan, ibaiak erregularrak izaten dira, eta klima lehorragoetan, berriz, irregularrak.
Bestelako ur kontinentalak
• Aintzirak. Sakonune batean pilatuta geratutako ur-masak dira aintzirak. Euri-urez, lurpeko urez edo ibai bat edo gehiagotako urez osatuta egon daitezke. Txikiak badira, urmael esaten zaie. Aintzirak ur gezakoak izan ohi dira, baina ur gazikoak ere badaude.

• Akuiferoak. Lurpeko urez osatutako ur-masak dira. Lurgaineko urak lurzoruan barrena iragazi eta ur gezako metakin handiak eratzean sortzen dira akuiferoak.
• Glaziarrak. Izoztuta dauden ur-masa geza handiak dira. Bi poloetan edo altitude handiko mendi-tontorretan egon daitezke. Gaur egun, Lurraren gainazal osoaren % 10 glaziarrek estaltzen dute.

1 Zer elementu dituzte ibaiek?
2 Zertan dira desberdinak erregimen erregularreko ibaiak eta erregimen irregularrekoak?
3 Zer faktorek dute eragina ibaietan? Zer-nolako eragina dute? Azaldu.
4 Ikertu taldeka, eta ea asmatzen duzuen nola eratzen diren deltak eta estuarioak.
Ibai, erreka, aintzira eta urmaelak hondakin toxikoen ondorioz kutsatuta egotea da ur-eskasiaren eragileetako bat, kutsadurak giza kontsumorako desegoki bihurtzen baitu ura.
U8 149
Gogoan hartu!
Zein dira Espainiako ibai eta
aintzira nagusiak?
Badaude Espainian baliabide hidrikoak behar bezala
erabiltzearen aldeko neurriak?
Espainiako ibaiak
Oro har, Espainiako ibaiak erregimen irregularrekoak eta gutxi-asko laburrak dira. Bost ibaik bakarrik gainditzen dute 500 km-ko luzera.
Ibaiak zer ozeano edo itsasotara isurtzen diren, Espainian hiru isurialde hidrografiko bereizten dira:
1 Ordenatu ibai hauek luzeenetik laburrenera, eta, gero, adierazi mapan: Guadiana: 818 km; Duero: 897 km; Guadalquivir: 657 km; Tajo: 1 007 km; Ebro: 930 km.
Espainiako isurialde hidrografikoak

Isurialde kantauriarra Isurialde honetako ibaiak Kantauri itsasora isurtzen dira. Ibai laburrak dira, inguruko mendiak itsasotik gertu baitaude, bai eta emaritsuak eta erregimen erregularrekoak ere, isurialde honetako klimaren ezaugarrietako bat urtearen joanean euri asko egitea baita. Ibai nagusiak, ekialdetik mendebaldera: Bidasoa, Deba, Ibaizabal, Pas, Saja, Besaya, Sella, Nalón —eta haren ibaiadarra, Narcea—, Navia eta Eo.
Isurialde atlantikoa Isurialde honetako ibaiak Ozeano Atlantikora isurtzen dira. Bi multzotan bereizten dira:
• Galiziako ibaiak. Ibai labur, emaritsu eta erregularrak dira, inguruko klima eta erliebea direla tarteko. Ibai nagusiak: Eume, Tambre, Ulla, Miño eta haren ibaiadarra, Sil.
• Iberiar goi-lautadako eta Guadalquivirren sakonuneko ibaiak. Ibai luzeak dira, haien iturburua bokaletik urrun dauden mendietan baitago, bai eta emaritsuak eta erregimen irregularrekoak ere, udazkenean eta udaberrian baizik ez baitu euria egiten. Ibai nagusiak, iparraldetik hegoaldera: Duero, Tajo, Guadiana, Guadalquivir eta haien guztien ibaiadarrak.
Isurialde mediterraneoa Mediterraneo itsasora isurtzen diren ibaiek osatzen dute.

• Hegoaldeko ibaiak. Laburrak dira, denak ere Mendikate Penibetikoan sortuak, emari txikikoak eta erregimen irregularrekoak, inguruan euri gutxi egiten baitu. Ibai nagusiak, mendebaldetik ekialdera: Guadiaro, Guadalhorce, Guadalfeo, Andarax eta Almanzora.
• Ekialdeko ibaiak. Ebro eta Ter izan ezik, gainerako ibaiak emari txikikoak, erregimen irregularrekoak eta luzera gorabeheratsukoak dira. Ibai nagusiak, iparraldetik hegoaldera: Ebro, Ter, Llobregat, Júcar eta Segura. Ebro Espainiako ibai emaritsuena da, bai eta luzeena ere: 930 km ditu, eta ibaia Espainian bertan sortzen eta itsasoratzen da.



150 3
Ibaizabal
Duero ibaia
Ebro ibaia
Espainiako ibaiak
Isurialde kantauriarra
Isurialde atlantikoa
Isurialde mediterraneoa

Uhartediak
Ibaia


Lurpeko ibaia
Uharrak eta sakanak
Estatuaren muga
Ibai nagusiaren iturburua
Ibai nagusiaren bokalea
Aintzirak eta urmaelak
Espainian aintzirak eta urmaelak ere badaude, asko jatorri glaziarrekoak, natura-aniztasun handia dutenak, eta hori dela eta, hain zuzen, zaintzea eta mirestea merezi dutenak.
Hona hemen aintzira eta urmael nabarmenenak:
• Sanabriako aintzira (Zamora). Espainiako eta Europako jatorri glaziarreko aintzira handiena da. Haren inguruan hareazko eta harrizko hondartzak daude.
• Covadongako aintzirak (Europako Mendiak, Asturias) ere jatorri glaziarrekoak dira, eta 1 000 metroko altitudean daude.
• Gallocantako urmaela (Zaragoza), Espainiako ur gaziko urmael handientzat jotzen dena. Garrantzi handiko babesgunea da hegazti migratzaileentzat.
• Laguna Negra (Urbión mendiak, Soria) aintzira glaziar bat da, pinudiz eta ura belzten duten granitozko paretaz inguraturik dagoena.
• Ruiderako urmaelak (Albacete eta Ciudad Real). Urjauzi eta lurpeko ubideen bidez bata besteari lotutako urmaelak dira.
Kalkulu batzuen arabera, 2030ean Espainiako biztanleen % 65ek jasango omen ditu ureskasiaren ondorioak.
Espainiako lurpeko urak
Joan den 2022. urtean, Trantsizio Ekologikorako eta Erronka Demografikorako Ministerioa (Miteco) uraren krisiari aurre egiteko estrategia bat prestatzen hasi zen. Ministerioak argitara emandako dokumentu batean adierazten denez, Espainian lurpeko uren % 48 egoera txarrean daude, eta ibaietako uraren kalitatea ere okertu egin da. Informazio horretan oinarriturik, egin bilaketa bat Interneten, eta idatzi zer neurri jarri beharko liratekeen martxan Espainian arazo horri aurre egiteko.
2 Zein dira Espainiako ibaien ezaugarri nagusiak?
3 Zein dira eta non daude Euskadiko aintzira eta urmael nagusiak?
U8 151
Tambre MIÑO E s l a DUERO DUERO Tormes TAJO J a r a m a Henares GUADIANA GUADIANA Cigüela Zújar Genil Pisuerga Alagón Alberche GUADALQUIVIR Adaja Tiétar Záncara Sil TAJO Jabalón Tinto Odiel Nalón Bidasoa ENavia o Saj a Ibaizabal SEGURA Ter L l o b r e gat Segre G á l l e g o Aragoi Cinca Cabriel JÚCAR EBRO TURIA Jalón EBRO Guadalfeo Guadalhorce Almanzora Melilla Ceuta Narcea Naviako itsasadarra A Guarda Porto Ayamonte Cullera Sanlúcar de Barrameda Guardamar del Segura Lisboa Bilboko itsasadarra Ebroren delta Kantauri itsasoa M e d i t e r r a n e o i t s a s o a OZEANO ATLANTIKOA
ATLANTIKOA KANARIAK Balearrak FRANTZIA ALJERIA MAROKO ANDORRA PORTUGAL KANTAURIAR MENDIKATEA IBERIAR SISTE M A MENDIKATE BE T I K O A K P I R I N I O A K E R D IALDEKO SISTEMA Ruiderako urmaelak Sanabriako aintzira Gallocantako urmaela Covadongako aintziraka Laguna Negra
OZEANO
0100200300km
Gogoan hartu!
Nolakoak dira gure erkidegoko urak?
Klimari eta kokapen geografikoari erreparatuta, urarekin
lotutako zer arazo sortu daitezke Euskadin?
Ebro ibaia kenduta, Euskal Autonomia Erkidegoko ibaiak laburrak, emari handikoak, erregimen erregularrekoak eta malda handikoak dira, prezipitazioak ugariak eta erregularrak direlako urte osoan, eta itsasotik hurbil dauden mendietan jaiotzen direlako.



Kantauriar isurialdeko ibaiak
Aipatzekoak dira hauek:
• Nerbioi ibaia isurialde honetako luzeena da. Arabako Gibijo mendilerroan jaiotzen da, baina ibilbidearen zati handiena Bizkaian egiten du. Nerbioiren ibaiadar garrantzitsuena Kadagua da.
• Ibaizabal Anboto mendian jaiotzen da. Basaurin bat egiten du Nerbioi ibaiarekin, eta bi ibaiek elkarrekin egiten dute bidea, Bilboko itsasadarrean Bizkaiko golkora isurtzen diren arte.


• Beste ibai garrantzitsu batzuk hauek dira: Bidasoa, Nafarroan jaiotzen da eta Frantziako estatuko muga markatzen du; Oria, Aizkorrin jaiotzen da; Urumea, Donostian itsasoratzen da; Urola eta Deba.
Isurialde mediterraneoko ibaiak
EAEko ibai batzuk Ebroren adarrak dira eta Mediterraneoan itsasoratzen dira.
Isurialde honetako ibaiak luzeagoak eta emari handiagokoak dira, baina ez dira horren erregularrak. Emaria asko goratzen da udaberrian eta udazkenean, euri gehiago egiten duenean. Gainera, malda txikiagokoak dira. Garrantzitsuenak hauek dira:
• Ebro Kantabrian jaiotzen da eta Araba hegoaldetik igarotzen da.

• Gure erkidegotik igarotzen diren ibaien artean, emari handiena duena da.
• Zadorra Entzian jaiotzen da (Araba).
• Baia ibaia Gorbeia mendigunean jaiotzen da.

152 4
Ibaizabal ibaia
Zadorra ibaia
Baia ibaia
Ebro ibaia
Urumea ibaia
Bidasoa ibaia
Euskadiko urtegiak
Urtegiak gizakiak egindako ur-biltegiak dira, inguruko herri eta hirietako etxeak, fabrikak, nekazaritza-, abeltzaintza-eremuak... urez hornitzeko. Gure autonomia-erkidegoko zenbait ibaitan ere badaude urtegiak. Zein ezagutzen dituzu?
• Taldeka jarrita, aukeratu hiru urtegi, eta aipatu zer ibaitan eraikita dauden, noiz egin ziren, zer edukiera duten, non dauden...

• Inguruko herriak urez hornitzeaz gain, badute beste erabilerarik urtegiek? Zein?

Gogoan hartu!
Noizbehinka lehorteak eta ur-eskasia ere izaten ditugun arren, uholdeak dira Euskadin historikoki kalte material eta giza galera gehien eragin dituzten arrisku naturalak.

153 Deba Arakil Bidasoa Nerbioi Altub e EBRO EBRO Oria Oiartzun Leitzaran Oria Ega Ega A r t i bai Zadorra Cadagua Baia Zadorra Deba Lea Ibaizabal Omecillo gA u e r a Urumea U r o l a Ok a Zalla Urrunagako urtegia Uribarri Ganboako urtegia Ihuda Butroe KANTAURIAR ISURIALDEA
Kantauri itsasoa uren banalerroa 01530km BIZKAIA GIPUZKOA ARABA
ISURIALDE MEDITERRANEOA
Nolakoak dira Europako urak?
Europa al da hurrengo urteetan ur-eskasia sufritzeko joera handiena duen kontinenteetako bat?
Ozeanoak eta itsasoak
Europa ia alde guztietatik dago itsasoz eta ozeanoz inguratuta. Kontinentearen iparraldeko kostaldeak Ozeano Artikoak bustitzen ditu; mendebaldekoak, berriz, Ozeano Atlantikoak.
Hona hemen Europako itsasoetako batzuk: Norvegiako itsasoa, Itsaso Baltikoa, Kantauri itsasoa, Mediterraneo itsasoa, Itsaso Adriatikoa, Tirreniar itsasoa eta Egeo itsasoa. Barnealdeko bi itsaso ere badaude: Itsaso Beltza eta Kaspiar itsasoa.
Aintzirak



Europan aintzira ugari daude; handienak iparraldean daude: Ladoga eta Onega, biak ere Errusian.

Erdialdeko Europako aintzirak, hala nola Lemán (Frantzia eta Suitza artean) eta Konstantzako aintzira (Alemania, Austria eta Suitza artean), Alpeetan daude. Txikienak, hala nola Veneziako urmaela (Italian) eta Prespa aintzira (Grezian), Mediterraneo aldean daude.

Ibaiak
Europako ibaien ezaugarriak eskualde bakoitzeko erliebearen eta klimaren arabera aldatzen dira.

Isurialde artikoko eta atlantikoko ibaiak
Ibai luzeak izan ohi dira, eta arro handi samarretan daude.
• Isurialde artikoko ibaiak. Ozeano Artikora isurtzen diren ibaiak, hala nola Ipar Dvina eta Petxora, emaritsuak eta erregimen irregularrekoak dira.
• Isurialde atlantikoko ibaiak. Gehienak ibai emaritsu eta erregimen erregularrekoak dira. Vistula, Oder, Elba, Rhin, Sena, Loira, Duero, Tajo eta Guadalquivir ibaiak dira nabarmenenak.
Isurialde mediterraneoko ibaiak
Klima eta erliebea direla tarteko, ibai laburrak, emari txikikoak eta irregularrak dira. Ibai nagusiak: Ebro, Rodano, Tiber eta Po.
• Barnealdeko itsasoetara isurtzen diren ibaiak. Ibai luze, emaritsu eta nabigagarriak dira.
• Itsaso Beltzera isurtzen diren ibaiak. Danubio, Dnieper, Dniester eta Don.
• Kaspiar itsasora isurtzen diren ibaiak. Ural eta Volga; azken horrek 3 530 km ditu, eta Europako ibai emaritsuena eta luzeena da.
154 5
Lemán aintzira
Petxora ibaia
Europako baliabide hidrikoak
Erreparatu mapari, eta erantzun:


Gurea kontinente idorra ez den arren, Europar Batasuneko herritarren erdiak, gutxi gorabehera, ur-horniketagatik kezkatuta daude gaur egun.
1 Marraztu Europako mapa bat, eta adierazi han gure kontinentea bustitzen duten itsaso eta ozeanoak.


Zein da Europako ibai luzeena? Bilatu Interneten zer herrialde zeharkatzen dituen ibai horrek sortzen denetik itsasoratzen den arte.
Nola sailkatzen dira Europako aintzira eta urmaelak?
Aukeratu zure arreta gehien erakarri duen Europako ibaia, eta egin kartel bat hari buruzko informazioarekin eta irudiekin. Azaldu non sortzen den, zer luzera duen, zer herrialdetatik igarotzen den, zer egoeratan dagoen, harekin lotutako bitxikeriak, etab.
U8 155 Rhi n Dnieper Vistula Dniester Danubio Danubio Sena Ebro Tajo Duero Tamesis Po Tíb er Elba Oder R o dano Loira Garona Mendebaldeko Dvina Maritsa Vardar Ipar Petxora ODvina nega Volga Volga Ural Volga Don Don Vänern aintzira Ladoga aintzira Léman Konstantzako aintzira Onega aintzira Guadalquivir Sizilia Balearrak Madeira uharteak Kanariak Azoreak Islandia Groenlandia Sardinia Irlanda Britainia Handia Korsika Kreta Zipre Itsas o B a l t i k o a Mediterrane o itsas o a I t s a s o B e l t z a Kaspiar itsasoa OZEANO ARTIKOA OZEANO ATLANTIKOA Ipar itsasoa Norvegiako itsasoa Azoveko itsasoa Mantxako kanala Kantauri itsasoa ItsasoAdriatikoa Egeoitsasoa Tirreniar itsasoa Itsaso Jonikoa Ibaia Aintzira Tontorra I E M H Altitudea (m) 4000 3000 2000 1000 500 200 0 – 500 02004006008001000km
Urtero kontsumitzen den uraren ehunekoa 40tik gora: egoera larria 21etik 40ra: arazo ugari 11tik 20ra: arazo gutxi 0tik 10era: arazorik ez 02507501000km
Gogoan hartu!
Zer hartu behar dugu aintzat ura erabiltzen dugunean?





Gure esku al dago ur-eskasiaren arazoari aurre egiteko neurriak hartzea?
Ura bizitza da
Ikusi duzunez, ura bizitzarako ezinbesteko baliabidea da, izaki bizidunak ezin baitaitezke urik gabe bizi.
Hona hemen datu batzuk, ura modu arduratsuan erabiltzea zeinen garrantzitsua den frogatzen dutenak:
• Munduan 2 000 milioi lagun baino gehiago daude edateko ura erabili ezin dezaketenak. Hori osasunerako oso arrisku larria da.
• Lurreko uraren % 97,5 gazia da; hortaz, % 2,5 baino ez da ur geza. Ur geza horren % 1 soilik lortu daiteke lurgaineko uretan, hala nola ibai eta aintziretan.
• Munduan 20 segundoz behin hiltzen da haur bat edateko modukoa ez den ura kontsumitzeagatik edo gaizki elikatuta egoteagatik.

• Herrialde azpigaratuetan, jende askok egunean bost ordu eman behar izaten ditu oinez ura lortzeko.
• Ura modu arduratsuan erabiltzea zeinen garrantzitsua den jakinarazte aldera, 1993an Uraren Mundu Eguna jarri zuten martxan.

Uraren erabilerak
Gizon-emakumeok egunero erabiltzen dugu ura. Uraren erabilerak honela sailkatu ditzakegu:
Kontsumo pribatua. Ura gure ongizaterako erabiltzea da; adibidez, etxea garbitzeko, elikatzeko, arropa garbitzeko, edo higiene eta garbitasun pertsonalerako.
Lehen sektoreko kontsumoa. Lehen sektoreko jardueretan, hala nola nekazaritzan eta abeltzaintzan, ura soroak ureztatu eta animaliei edaten emateko erabiltzen da.
Industria-arloko kontsumoa. Fabrika gehienek ura behar dute beren produktuak ekoizteko.

Kontsumo publikoa. Gure herri eta hirietan ere erabiltzen da ura herritar guztien mesederako: iturriak hornitzeko, kale eta eraikin publikoak garbitzeko, parkeak ureztatzeko…
Ura energia-iturri gisa. Gizakiok energia elektrikoa eta energia zinetikoa sortzeko ere erabiltzen dugu ura, makina astunak mugitzeko.
Dibertimenduzko erabilera. Ura erabiltzen da, besteak beste, igerileku eta ur-parkeak betetzeko, kirola egiteko, aisialdiaz gozatzeko…

156 6
Nola kudeatzen dugu planetako ur edangarria
Erreparatu mapa honi. Kontinente bakoitzean industriarako, nekazaritzarako eta etxerako uraren zer ehuneko erabiltzen den erakusten du.

• Uraren erabilerari dagokionez, zein da egoera gure kontinentearen zati handienean?
• Zer ehuneko dagokio Europan uraren erabilera mota bakoitzari?
• Zertarako erabiltzen da ur gutxien kontinente bakoitzean?
• Zer kontinentetan erabiltzen dute ur gehien nekazaritzarako? Eta industriarako?
• Zer ondorio ateratzen dituzu informazio horretatik?
Ura aurrezteko neurriak eta kontsumo arduratsua
Ezinbestekoa da ura modu arduratsuan erabiltzea, haren garrantzia aintzat hartzea eta neurri arduratsu eta eraginkorrak aplikatzea, orain eta etorkizunean edateko ura edukiko dugula bermatzeko.
• Etxean, ura ixteko giltzak ondo daudela berrikusi tartean behin. Batzuetan ur-ihesak egon daitezke, eta hori gogoan edukitzeak garrantzi handia du.
• Dutxatu, ez bainatu. Familiako norbait bainatzen bada, erabili ur hori etxeko beste lan batzuk egiteko.
• Euri-ura bildu, loreak ureztatzeko edo etxea garbitzeko.
• Gutxi kontsumitzen duten komunak jarri. Andela askok duten botoi bikoitzari esker, ur gehiago edo gutxiago erabili nahi duzun aukeratu dezakezu.
• Ez erabili komuna zakarrontzia balitz bezala. Papera, toallatxoak eta antzeko hondakinak botatzean, zabor hori guztia hodietan zehar joaten da, hodiak buxatzen dira eta zaborrak ura kutsatzen du.
• Estali erabiltzen ez diren igerilekuak, ura lurrundu ez dadin, eta erabili berriz hurrengo urtean.
• Ureztatzeko, erabili aspertsoreak edo tanta bidezko sistemak.
• Itxi txorrota dutxatu bitartean, edo eskuak, hortzak eta ontziak garbitzen ari zaretela.
• Guztiz beteta daudenean bakarrik jarri martxan ontzi- eta arropagarbigailuak.
• Ez bota txorrotatik behera ura kutsa dezaketen hondakinak, hala nola olioa, disolbatzaileak, garbiketa-produktuak, etab.
1 Ura aurrezteko zer neurri dira garrantzizkoenak, zure ustez? Zein jar daitezke martxan etxean eta zein eskolan?
Gogoan hartu!


Ur-eskasiaren eragile nagusietako bat kontsumo-ereduak dira; izan ere, ura ez berrerabiltzeak berebiziko desorekak eragiten ditu.

U8 157
Etxerako % 13,3 Etxerako % 19,0 Etxerako % 15,2 Etxerako % 8,6 Etxerako % 6,9 Etxerako % 7,3 Industriarako % 48,0 Industriarako % 10,3 Industriarako % 52,4 Industriarako % 7,3 Industriarako % 5,5 Industriarako % 11,4 Nekazaritzarako % 38,7 Nekazaritzarako % 70,7 Nekazaritzarako % 32,4 Nekazaritzarako % 84,1 Nekazaritzarakoa % 87,6 Nekazaritzarako % 81,3
Z er ikasi dut?
1 Zer da hidrosfera? Zein dira haren ezaugarri nagusiak?
2 Sailkatu hidrosferan dauden urak. Eskema bat ere egin dezakezu, edo kontzeptu-mapa bat, edo visual thinking metodoa erabil dezakezu…
3 Aipatu eta definitu zer ezaugarri dituzten ibaiek. Gero, jarri ezaugarri horiek betetzen dituzten edo betetzen ez dituzten Espainiako ibaien adibideak. Adibidez: Tajo ibaia Penintsulako luzeena da.

4 Kopiatu Espainiako ibaien mapa mutu bat, eta adierazi han ibai hauek: Bidasoa, Nalón, Miño, Tambre, Ulla, Duero, Tajo, Guadiana, Guadalquivir, Segura, Guadalhorce, Andarax, Ter eta Ebro.
5 Lotu ibai bakoitza bere ibaiadarrarekin:

8 Egin zuen ikastetxean ura modu arduratsuan erabiltzeko aholkuen zerrenda bat.
9 Osatu hiru multzo hauek, bakoitzean bi adibide gehiago jarrita.
• Europako itsasoak: Kantauri itsasoa, Mediterraneo itsasoa, Tirreniar itsasoa, Egeo itsasoa…
• Europako aintzirak: Ladoga, Lemán, Prespa…




• Isurialde atlantikoko Europako ibaiak: Oder, Elba, Tajo, Sena…
10 Erreparatu irudiei, eta esan uraren zer erabilera mota ikus daitekeen bakoitzean.
6 Esan zein diren Espainiako aintzira eta urmael nagusiak, eta idatzi bakoitzaren ezaugarri garrantzitsu bat.
7 Irakurri pista hauek, eta ea asmatzen duzun Europako zer ibairi buruz ari den bakoitza.
• Marina: «Europako ibai luzeena eta emaritsuena da, eta Kaspiar itsasora isurtzen da».
• Andoni: «Frantziako iparraldean dago, eta Ozeano Atlantikoan itsasoratzen da, Mantxako kanalean».
• Koldo: «Ibai emaritsu eta nabigagarria da, eta haren bokalea Itsaso Beltzaren mendebaldean dago».
• Kristina: «Europan iparraldeen dagoen ibaia da, eta Ozeano Artikoan itsasoratzen da».
Semaforoa. Margotu koadernoan, ariketa bakoitzaren ondoan, honela:
erantzuna badakizu
laguntza behar izan baduzu
erantzuna jakin ez baduzu

158 PORTFOLIOA
A C E B D F
Duero Tiétar Ebro Genil Guadiana Zadorra Tajo Jabalón Guadalquivir Guadalentín Segura Pisuerga
HELBURUA AURRERA
Idatzi gutun bat Europako Batzordeari
1 Lotu-Sakondu-Galdetu pentsamendu-teknikaren bidez, Europako Batzordeari bidaltzekoa den gutunaren oinarrizko puntuak planteatu beharko dituzte ikasleek. Neska-mutilek (irakurtzean, entzutean, behatzean) ikasi berri duten informazioa eta lehendik zekitena aktiboki erlaziona dezaten erraztea da estrategiaren asmoa, gure pentsamendua zabaltzen duten ideia berriak identifikatu edo jasotako informazioari buruz ditugun ideiak zalantzan jarri beharko dituztenez gero; hau da, informazioa modu aktiboan prozesatzen lagunduko die ikasleei.
Jarduera bakarka egitekoa da, baina ikastalde osoak ere parte hartu dezake horretan, bakoitzaren ikuspuntuak besteena aberastu dezan.
Neska-mutilek ingurumen-arazo bati aurre nola egin landu beharko dute, baina zenbait hizkuntza-trebetasun ere bai aldi berean, hala nola ahozko eta idatzizko adierazpena.
LOTU


Zer-nolako loturak ditu informazio edo esperientzia ikasi berriak lehendik zenekienarekin?
SAKONDU

Zer ideia edo pentsamendu zabaldu edo sakondu dituzu esperientzia edo informazio ikasi berriaren ondorioz?
GALDETU
Zer galdera edo erronka datozkizu gogora gaiari buruz, ikasi berri duzun informazioa edo bizi berri duzun esperientzia dela tarteko?
Galdetu hau zeure buruari!
Zure ustez, Espainiako eta nazioarteko erakundeek beren esku dagoen guztia egiten al dute ur-eskasiaren arazoari konponbide egokia aurkitzeko?
1 Ikasi duzu lehen ez zenekien zerbait? Zer irudi gogoratzen dituzu? Ikasi duzunetik zer gustatu zaizu gehien? Zertarako da baliagarria ikasi duzuna? Zertarako balioko dizu zure eguneroko bizitzan?
2 Pentsatu zertan hobetzen jarraitu dezakezun aurrerantzean eta egin horri buruzko gogoeta. Hausnarketa zabaltzeko, pentsatu zer hobetu dezaketen ikaskideek.
Herritarrek badakite, zure ustez, arazoa benetan larria dela eta urteen joanean okertuz joango dela?
Urarekin dugun harremanari dagokionez, zure ustez, nork jarri behar ditu martxan aurreneko aldaketak?
U8 159
N
?
ola ikasi dut? ? ?
L agundu zalantzak argitzen
Sumendi honen erupzioak inguruko erliebea aldatuko du. Zer beste barne- eta kanpo-eragilek aldaraz dezakete paisaia?


Madrilgo Puerta del Sol plazan dago Espainiako sei errepide erradialen erdigune edo jatorria, baina ez dut gogoan… Zein dira Espainia penintsularraren mugak lau puntu kardinaletan?

Oporretan, Iberiar goi-lautadaren ertzeko erliebearen lau unitateak bisitatu genituen. Zein dira?
Ikasturte amaierako bidaian, hainbat kirol-jarduera egingo ditugu Espainiaren, Frantziaren eta Andorraren arteko muga naturalean. Nora joango gara?



Datozen oporretan, kostalde baxu eta hareatsu bateko ostatu batean egin nahi dugu erreserba. Espainiako zer kostaldetara joan gaitezke?
Lur-globo honetan, Europako erliebearen bi unitate ageri dira: Ural mendiak eta Kaukaso. Zertan dira desberdinak?

1 3 5 2 4 6
160 BERRIKUSPENA Erliebea
Elurra hidrosferaren parte da, baina… zer da hidrosfera? Lur planetaren zer ehuneko dagokio, gutxi gorabehera, hidrosferari?

Hidrografia

Aitona, atzo amak esan zidanez, ibaiaren emaria eta erregimena izan behar omen ditugu kontuan arrantzara joan nahi badugu. Zer dira ibaien emaria eta erregimena?
Ebro ibaia ezagutzeko gogo handia nuen. Zergatik da hain garrantzitsua ibai hau, eta zer isurialdetan dago?


Hurrengo asteburuan, isurialde atlantikoan itsasoratzen den ibai batera joan nahi dut piraguismoa egitera. Zer ibaitara joan naiteke?
Europa bustitzen dituzten itsaso eta ozeanoen izenak idatzi behar ditut gure kontinentearen mapa batean. Zer izen idatzi behar ditut?

Badakizu honela energia sortzea lortzen dugula? Baina… zer beste modutan erabil dezakegu ura?

161 TRIMESTRE 1 HIRUHILEKOA 2 7 9 11 8 10 12
7. ETA 8. UNITATEAK
Ebro ibaia
ITZALAPROIEKTUAK UZTENDUTEN
EZAGUTU DIZIPLINARTEKO PROIEKTUA
Orain edo inoiz ez
NIK, ZUK, GUK... DENOK EKIN!
Zer egin dezakegu gure aztarna ekologikoa txikitzeko?
Mendi-ibili bat egiten dugunean, leku horretako iragana, kultura eta beste ezaugarri asko ere aurkitzen ditugu.
Zer dakigu horretaz guztiaz?
Badago monumentu naturalik?
Begiratokiren bat, iturriren bat, haitzuloren bat…?

Egin ideia-jasa bat, eta ikusi zenbat dakizuen gaiaz eta zer besterik ikertu behar duzuen.
Taldeka antola zaitezkete, informazio mota batean espezializatzeko.
Zuen gaia zein den argi jakitea eta ikertzea da garrantzitsuena. Informazioak argia izan behar du, eta, batez ere, zuen herri inguruko leku bateko historia, ohiturak eta monumentu naturalak identifikatzen lagundu behar dizue.

Lortu argazki errealak Interneten, edo atera zuk zeuk bertatik bertara, horretarako aukerarik baduzu.
Informazioarekin eta irudiekin informazio-panel bat egin dezakezue.

162
Antolatu ekintzarako estrategia bat!
1 T hink P ENTSATU D esign 2 DISEINA T
U
Interpretazio-txango bat egitera animatu nahi zaituztegu.
Informazio-panela ikastetxeko sarreran jar dezakezue, horrek aisialdi-eskaintza osasungarri baten berri emango baitie ikasleei, irakasleei, senitartekoei... Blog batean edo web-orri batean ere jar dezakezue panel digitala.
Informazio-panela egiteko, erabili papera, kartoi mehea, paper jarraitua… Edo egin panela euskarri digitalean.

Garrantzi handikoa da informazioa argi eta txukun aurkeztea; gehitu argazkiak, horrek interpretazioa erraztuko baitizue mendi-ibilia egiten ari zareten bitartean.
U 5


Lana egin ondoren, azaldu nola sentitu zaren ikerketa-lanean.

163 2. HIRUHILEKOA
3
EGIN 4 PRESENTA
tage
T est EGIAZTAT
M aker
S
AURKEZTU

Ikasturtean zehar zientzia egiteko erabiliko dituzun STEM tresna guztiak ditugu.
16 Gizakion zenbait «matxura» ikertuko ditugu, zerk huts egiten duen ikusi eta matxura horiek nola konpon daitezkeen jakiteko.
32 Gure ohituren inguruan hausnartu, eta proposamen bat egingo dugu, haiek hobetu eta osasungarriagoak izan daitezen lortzeko.

eta ongizatea
Jonayren egoera ikuspuntu biologikotik aztertuko dugu, eta gutun bat idatziko diogu, anima dadin.
Zenbait paisaiaren maketak egingo ditugu, paisaiak nolakoak diren eta nola zaindu ditzakegun ulertzeko. 4 Lurra
Osasuna eta ongizatea







7 Aurrerabidea edo natura? Biak?

92 Gure plater gustukoenen errezetak aztertuko ditugu, haietan materia nola erabiltzen den jakiteko.
5 Materia ezagutuz Goserik ez izatea
Ikastetxea argindarrik gabe gelditu dela imajinatu eta Uxoarena bezalako biziraupen-plan bat egingo dugu.
Energia eskuragarria eta ez-kutsatzailea

126 Sare sozialen bidez, gure erkidegoko herrikideei jakinaraziko diegu zein garrantzitsua den ekoizpen eta kontsumo arduratsuaren aldeko ekintzen berri ematea. Ekoizpen eta kontsumo arduratsua
Gutun bat idatziko diogu Europako Batzordeari, ur-eskasiagatik kezkatuta gaudela jakinarazteko; aldi berean, arazoa arintzeko politiken aldeko sinadura-bilketa bat jarriko dugu martxan.
saneamendua

Turismoarekin lotutako negozio bat irekiko dugula imajinatuko dugu, eta, hura eratzeko, ekonomia-, gizarte-eta ingurumen-jasangarritasuna izango ditugu kontuan. Lan duina eta hazkunde ekonomikoa
Inkesta bat egingo dugu, etxeko lanetan familiako nor aritzen den jakiteko.
Genero-berdintasuna
Medikuntzako aurrerapenei buruz eta osasun-zerbitzuen arloan lan egiten duten profesionalei gure esker ona erakusteko moduei buruz eztabaidatuko dugu. Osasuna eta ongizatea
Energia aurrezteko eta energiaren erabilera arduratsua egiteko ideia-gida bat egingo dugu. Energia eskuragarria eta

Zer ikasiko dugu? OR. IKASKUNTZA-EGOERA HELBURUA AURRERA GJH DIZIPLINARTEKOA
8 Nire STEM tresna-kaxa
gu
164 9 Zatoz
bisitatzera!
184
Espainia XIX. mendean
10
11 Espainia XX. eta XXI. mendeetan
200
ez-kutsatzailea 216 12 Ekonomia, gizartea eta kultura
144 8 Ur-eskasia, benetako arazo bat? Edateko
ura eta
1 Zerez eginak gauden ikasiko dugu
2 Osasungarria da gure elikadura
54 3
eta ugalketa-
osasun ona 70
aldatzen dela ikasiko dugu
Erlazio-
funtzioen
etengabe
106 6 Energia erabiltzen dugu
Lehorreko bizitza Osasuna eta ongizatea Osasuna
• Metodo zientifikoa
• Bizi-funtzioak eta zelulak
• Zelulen ezaugarriak, formak eta tamainak
• Nutrizio-funtzioa eta mantenugaiak
• Elikagaiak eta haien sailkapena
• Dieta eta elikadura osasungarria
• Erlazio-funtzioa eta haren etapak
• Ohitura osasungarriak eta zentzumen-organoen funtzionamendua
• Lurraren geruzak, mineralak eta arrokak
• Magmatismoa, lurrazalaren deformazioa eta haien ondorioz eratzen diren arrokak
• Proiektuetan oinarritutako metodoa • Pentsamendu konputazionala
• Ehunak eta zer ehun mota ditugun
• Organoak eta zer organo mota ditugun
• Digestioa, arnasketa, zirkulazioa eta aparatu horien osasun ona
• Iraizpena eta iraitz-aparatuaren osasuna
• Ohitura osasungarriak eta nerbio-sistemaren funtzionamendua
• Ohitura osasungarriak eta lokomozioaparatuaren funtzionamendua
• Erliebea modelatzen duten prozesuak eta arroka sedimentarioak
• Lurraren historia geologikoa
• Aparatuak eta sistemak eta zer aparatu eta sistema mota ditugun
Konpetentziak lantzeko ariketak
Konpetentziak lantzeko ariketak
1. hiruhilekoaren berrikuspena: 1. eta 2. u ni tateak. STEAM: Lynn Margulis
• Ugalketa-funtzioa. Pubertaroa
Konpetentziak lantzeko ariketak
Konpetentziak lantzeko ariketak
1. hiruhilekoaren berrikuspena: 3. eta 4. unitateak. STEAM: Rita Levi-Montalcini
DIZIPLINARTEKO PROIEKTUA · Kutxa magikoa eta haren zaintza: Kutxa magikoaren misterioa
• Materia eta haren propietate orokorrak
• Dentsitatea eta flotagarritasuna
• Materiaren egitura. Atomoak
• Energia, haren ezaugarriak, energia motak eta aldaketak
• Energia-iturriak eta energia-iturri motak
• Elektrizitatea eta magnetismoa
• Erliebea eta haren aldaketak
• Espainia: erliebearen kokapena eta ezaugarriak
• Planetako urak: hidrosfera
• Ibaiak eta gainerako ur kontinentalak
• Espainiako hidrografia
• Materiaren egoerak eta haien aldaketak
• Nahasteak, nahaste motak eta haien osagaiak bereizteko metodoak
• Energia behar bezala erabiltzen dugu?
• Aerodinamika, errodadura eta flotagarritasuna: oinarrizko printzipioak
• Proiektuak eta bideojoko bat egiten
• Penintsulako erliebea
• Kostaldeetako erliebea
• EAEko erliebea
• EAEko hidrografia
• Europako hidrografia
• Uraren kontsumo arduratsua
Konpetentziak lantzeko ariketak
Konpetentziak lantzeko ariketak
2. hiruhilekoaren berrikuspena: 5. eta 6. unitateak. STEAM: Hedy Lamarr eta Émilie du Châtelet
• Europa: erliebearen kokapena eta ezaugarriak
Konpetentziak lantzeko ariketak
Konpetentziak lantzeko ariketak
2. hiruhilekoaren berrikuspena: 7. eta 8. unitateak
DIZIPLINARTEKO PROIEKTUA · Orain edo inoiz ez: Nik, zuk, guk... Denok ekin!
• Ekonomia-jarduerak
• Kontsumitzaileak gara
• Enpresak eta enpresa motak
• Aro Garaikidearen hasiera
• Fernando VII.aren erreinaldia. Azkeneko errege absolutista
• Alfontso XIII.aren erreinaldia eta II. Errepublika
• Gerra Zibila eta Francoren diktadura
• xix mendeko ekonomia- eta gizarte-aldaketak
• xix mendeko kultura eta artea
• Ekonomia-sektoreak. Lehen sektorea
• Bigarren sektorea
• Hirugarren sektorea
• Isabel II.a eta Seiurteko Iraultzailea
• Borboiko etxearen Berrezarkuntza
• EAE xix mendean
• Demokrazia iritsi zen
• Espainia Europar Batasunean
• EAE xx eta xxi mendeetan
• xx -xxi mendeetako ekonomia eta gizartea
• xx eta xxi mendeetako kultura eta artea
• Aro Garaikideko gertaerak eta pertsonak
• EAEko ekonomia-sektoreak
• Ekonomia-sektoreak Europan
Konpetentziak lantzeko ariketak
• xix mendeko gertaerak eta pertsonak
Konpetentziak lantzeko ariketak
3. hiruhilekoaren berrikus.: 9. eta 10. unitateak
• xx eta xxi mendeetako gertakari eta pertsona ospetsuak
Konpetentziak lantzeko ariketak
Konpetentziak lantzeko ariketak
3. hiruhilekoaren berrikuspena: 11. eta 12. unitateak
PROYECTO INTERDISCIPLINAR - Aprender de lo natural
DIZIPLINARTEKO PROIEKTUA · Birika berdea: Itzaltzea baino, saihestea hobe
JAKITEA... IKASTEKO, APLIKATZEKO ETA IKERTZEKO
BIZIRAUPEN-PLANA
ZER BEHAR DUT?





IDEIAK




– Bi esku-argi ditut: bata, biradera bati eraginez kargatzen da eta, besteak, eguzki-plakatxo bat du.
– Bainugelan, bost kandela usaindun eta hamasei pospolo dituen kutxa txiki bat dauzkagu.
– Eguzki-argia dugu egunez.
– Gure etxea hondartzatik hurbil dagoenez, laguntza eskatzeko mezuak itsasora jaurti ditzaket. Zorte pixka batekin, olatuek eraman eta baten batek aurkituko ditu. – Kometa handi samar bat daukat, eta haizea dabil. Laguntza-mezu bat idatz dezaket bertan, eta zeruan hegaldarazi.
Despentsako elikagaiak berotzea
– Eguzki-labe bat egin dezaket paperarekinaluminioeta kaxa batekin. Udalekuetan ikasi nuen hori egiten.

Bideojoko bat egingo dut, urratsez Bloke bidezko programazioa 7 Energia eta
Marruskadurari, murgilketari eta errodadurari buruzko proiektu teknologikoak 6 Energia behar bezala erabiltzen dugu? Energiaren erabilerak eragiten dituen arazoak 5 Magnetismoa Imanak eta haien erabilerak 3 4 Energia-iturri etaberriztagarriakberriztaezinak Energia-iturriak eta energia-iturri motak 7
mugimendua
Argia
Laguntza eskatzea
Proiektu honek ikasturteko eduki guztiak eskaintzen dizkizu, bai liburu digitalaren bidez, bai era askotako baliabideen bidez.
Ikasteko beste modu bat ezagutuko duzu, erraza, intuitiboa eta edozein plataforma eta gailurekin bateragarria.
4 Nola sailkatzen dugu materia? Agregazio-egoerak
Materia egoeraz aldatzen da
Materiak aldaketa fisikoak izan ditzake. Halako aldaketetan, materiak jatorrizko itxura aldatzen du, baina ez bere konposizioa.
Aldaketa fisiko ohikoenak materia berotzean edo hoztean gertatzen dira. Hain zuzen, tenperatura-aldaketaren ondorioz, materiaren agregazio-egoera aldatu egiten da.

Materia berotzean edo hoztean, materiaren egoerak (solidoa, likidoa edo gasa) aldaketa itzulgarriak izaten ditu; materiaren egoera-aldaketak dira horiek.

Materiaren egoera-aldaketak itzulgarriak dira. Horrek esan nahi du solido bat, berotzean, likido bihurtuko dela, eta likido hori bera, hoztean, berriz ere solido bilakatuko dela. Horixe bera gertatzen da gainerako egoera-aldaketekin ere. Egoera-aldaketa gertatu bitartean, tenperatura konstante mantentzen da.

Aldaketa-egoeren izenak
Sublimazioa
Izotz solidoa
2 Osatu esaldia koadernoan. ... konstante mantentzen da, ... gertatu bitartean.
Alderantzizko sublimazioa
Atmosferako ur-lurruna
Ur likidoa
haren tenperatura astiro ... da.


6. Tenperatura igotzen den heinean, likidoan burbuilatxo batzuk agertzen hasi dira.
4 Berdina al da Espainiako kostalde osoa?

Nola sartu?
Zure liburuko lehenbiziko orrialdearekin batera aurkituko dituzu proiektu digitalean sartzeko behar dituzun argibide guztiak.


Kostalde atlantikoa
behar da; hau da, urak likido-egoeratik gas-egoerara aldatu behar du.
Kostalde mediterraneoa


136

Espainiako kostaldeak 5 970 km ditu gutxi gorabehera, Iberiar penintsularen, Balear eta Kanaria uharteen, eta Ceuta eta Melilla hirien artean banatuta. Kostalde atlantikoaren eta kostalde mediterraneoaren artean aldeak daude.



Kostaldea Kokapena Ezaugarriak
KantauriarraBidasoa ibaiaren bokalean hasten eta Ortegal lurmuturreraino iristen da.
Galiziakoa Ortegal lurmuturrean hasten eta Miño ibaiaren bokaleraino iristen da.
AndaluziakoaGuadiana ibaiaren bokalean hasten eta Gibraltarko itsasarteraino iristen da.

Hegoaldekoa Gibraltarko itsasartean hasten da eta Murtziako Eskualdearen eta Valentziako Erkidegoaren arteko hegoaldeko mugaraino iristen da.
Ekialdekoa Valentziakoa. Segura ibaiaren ibar beherean hasten eta Ebroren deltaraino iristen da.
Kostalde garaia, malkartsua, harritsua eta zuzena da.
Zer hartu behar dugu aintzat gure kostaldeetan ekonomia- jarduerak garatzeko? rraldeko Ezaugarriak: Balear Kokapena. kostaldearen Ezaugarriak:
Galiziako kostalde atlantikoaren iparraldea Rías Altas da, eta hegoaldea, Rías Baixas. Itsasadarrak tarteko, hain zuzen, kostaldea oso koskatua da, bai eta garaia eta harritsua ere.

Zuzena, baxua eta hareatsua da, eta hondartza handiak ditu.
Kostalde garaia, malkartsua, harritsua eta zuzena izateagatik nabarmentzen da.
Gata eta Palos lurmuturrak. Almeríako golkoa.
Gero eta ohikoagoa da influencerrek bizi garen natura-inguruneen egoera salatzea beren sare so-


Kostalde baxu eta hareatsua da, eta, oro har, hondartza handiak ditu.
Koskatua, garaia, malkartsua eta harritsua da. Creus lurmuturra. Rosesko golkoa.
Nau lurmuturra Kataluniakoa. Ebroren deltan hasten eta Frantziako mugaraino iristen da.
zialetan. Hona hemen, adibide modura, zenbait post, al hauetariko ATLANTIKOA BALEARRAK Major PORTUGAL FRANTZIA ANDORRA Kantauri OZEANO ATLANTIKOA M d t raneo itsa a Melilla itsasartea Almeríako golkoa Sant Jordi golkoa Valentziako golkoa Bizkaiko Cádizko golkoa Gibraltarko Ortegal lurmuturra Matxitxako Ajo Gata lurmuturra Palos lurmuturra lurmuturra Ebroren Trafalgar Ekhi_lore Euskadiko kostaldean pasieran ibili, eta hau aurkitu ez dugu, ba? Oporrak horrela? Gero, zikinkeria hori guztia Kantauri itsasora iritsiko da. #bizitzajasangarria #horrelaez Ekhi_lore Head_JL Hauxe egiten diogu etengabe Baixas maiteari. Bihotzak krak egiten #stopplastikoak #bizitzajasangarria Head_JL Kantauriko kosta Andaluziako kosta atlantikoa Atlantikoko kosta
Honelakoa da zure proiektu digitala 102 103
Kondentsazioa Solidotzea Lurrunketa Urtzea
Kanaria uharteetako erliebea Kokapena. Ozeano Atlantikoan daude, Afrika iparraldeko kostaldearen parean. Ezaugarriak: Erliebea. Menditsua eta sumendijatorrikoa da, eta, hori dela eta, oso paisaia berezia dute. Tenerife uhartean dago Espainiako mendirik altuena: Teide (3 718 m). Kostaldea. Oro har, kostaldea altua, malkartsua eta koska handirik gabea da, baina uharteetako hegoaldean hondartzak daude: ekialdekoak harrizkoak dira, eta mendebaldekoak, hareazkoak.

Balear uharteetako erliebea Kokapena. Mediterraneo itsasoan dago, Valentziako kostaldearen parean. Ezaugarriak: Erliebea. Oro har, menditsua eta Penintsulako erliebearen antzekoa da. Mallorca, Eivissa eta Formenteran, erliebea Mendikate Penibetikoaren luzakin bat da, eta Menorcan, Kataluniako kostaldeko mendikatearena. Uharteetako mendi garaiena, Puig Major (1 445 m), Mallorcan dago, Tramuntana


Nolakoa da?
Erantzun globala era askotako hezkuntza-ingurune baterako.
Intuitiboa
Zuk erraz erabiltzeko modukoa.
Gailu anitzekoa
Edozein gailu motatan (ordenagailuan, tabletan, smartphonean…) egokitzen eta ikusten da, pantailaren edozein tamaina eta bereizmenetan.

Deskargagarria

Aukera ematen du Interneteko konexiorik gabe lan egiteko eta gailu batean baino gehiagotan deskargatzeko.

Sinkronizagarria
Erabiltzaileak egiten dituen aldaketak berez sinkronizatzen dira, lan egiteko erabilitako edozein gailu konektatzean.
Unibertsala
U7 137
Zer eskaintzen dizu?
Era askotako baliabideak ditu; paperezko liburuaren erreprodukzioa baino askoz gehiago da.
Honakoak egiteko aukera izango duzu:

Ariketak egin ariketa elkarreragileak
Aztertu laburpen elkarreragileak, eskemak...
Ikasi
audioak, bideoak, Game Room-ak...
Ebaluatu autoebaluazioa, portfolioa...
Bateragarria da ikastetxeetan gehien erabiltzen diren sistema eragileekin, ikaskuntzako inguru birtualekin (IIB) eta hezkuntza-plataformekin (LMS).
ere Mallorca eta
post, arazo horren berri ematen dutenak. Jakingo zenuke esaten zer kostaldetan atera den argazki hauetariko bakoitza? etengabe gure Rías egiten dit. Princess_cons19 Konponbideak behar ditugu Mar Menor salbatzeko. kostaldeak ez du hau merezi. #bizitzajasangarria #SOSmarMenor Princess_cons19 mediterraneoa: Levantekoa Mediterraneoko
mendilerroan. Kostaldea. Garaia eta koskatua da, eta kalak ditu, batez
Menorca iparraldean.
9 Zatoz gu bisitatzera!
Bazenekien 2021ean 31 milioi turistak baino gehiagok bisitatu zutela Espainia? Izan ere, Espainia munduko helmuga turistiko hautatuenetako bat da, dela bere kulturaren eta paisaien aberastasunagatik, dela bere klimagatik, dela bere azpiegitura eta zerbitzuengatik…
Turismoak enplegua sortzea ekartzen du, eta herrialde bateko ekonomia hobetzen. Gure ekonomiaren zutabe nagusietako bat da. Pentsatu duzu inoiz zenbat establezimendu eta zerbitzuri egiten dien mesede turismoak? Jatetxeek, ostatuek, dendek, bidaia-agentziek… Tartean diren guztiek irabazten dute.
Sortzen den lana, baina, ez da beti kalitate onekoa izaten, eta halako jardueretako batzuek, gainera, ingurumena hondatzen dute. Herritar arduratsuak garen aldetik, beraz, turismo jasangarria sustatu beharko genuke, sortzen diren enpleguak kalitate onekoak izan daitezen.
Zer deritzozu?


Turismoarentzat beharrezkoa al da beste sektore batzuetan, hala nola nekazaritzan, aritzen den jendearen lana?

Zer-nolako neurriak jar ditzakete martxan herriek turismoa erakarri eta lanpostuak sortzeko? Zenbait lekutan mugatua dute egunean har ditzaketen turisten kopurua.

Zer dela eta? Zer da turismo jasangarria?
Zer-nolako lotura dute turismoak eta diruak?
Datua
Unitate honetarako...
Helburua aurrera
Pentsa turismoarekin lotutako
negozio bat ireki nahi duzula zure herri edo hirian lanpostuak sortzeko. Horretan, kontuan izan ekonomia-, gizarteeta ingurumenjasangarritasuna!
Jarraitu hariari!
8. helburuko datuen arabera, 2016tik 2030era munduan 470 milioi lanpostu sortu beharko lirateke, lan-merkatura lehen aldiz sartzera doazenek non lan egin izan dezaten.
Ekonomiajarduerak Zer dira ekonomia-jarduerak?
1
Kontsumitzaileak gara Zer da kontsumitzea?
2
164








165 8
Enpresak eta enpresa motak Badakizu zer enpresa mota dauden? 3
Ekonomiasektoreak. Lehen sektorea Nondik lortzen dira lehengaiak? 4 Bigarren sektorea Non eraldatzen dira lehengaiak? 5 Hirugarren sektorea Nork eskaintzen dizkigu zerbitzuak? 6 Ekonomiasektoreak Europan Nolakoak dira Europako ekonomiasektoreak? 8 EAEko ekonomiasektoreak Nolakoak dira gure erkidegoko ekonomiasektoreak? 7
Zer dira ekonomia-jarduerak?
Badakizu zer diren ekonomia-jarduerak, zer elementu
dituzten eta zer-nolako lotura duten diruarekin?
Zer dira ekonomia-jarduerak?
Gizakion premiak asetzeko, eta elikagaiak, arropa eta zerbitzuak (hezkuntza, osasungintza…) bermatzeko, zeregin jakin batzuk egiten dira. Halako zereginei ekonomia-jarduera esaten zaie.
Ekonomia-jardueretan, batetik, haien elementuak bereizi behar dira, eta, bestetik, jarduerak nork egiten dituen.
Ekonomia-jardueren elementuak
Ondasunak eta zerbitzuak dirurik erabili gabe aldatzea du oinarri trukeak. Antzinaroan, trukea zen jendeak behar zuena lortzeko erabiltzen zuen sistema, baina oso zaila zen produktu bakoitzak zenbat balio zuen zehaztea.

Ekoitzitakoak barnean hartzen duen guztia da (lehengaiak lortu, produktuak landu…)



Produktuak ekoizten dituzten lekutik kontsumituko dituztenengana eramateko prozesua da.

Ekoizpen-prozesuan sortutako produktuak erabiltzea, kontsumitzea eta probetxua ateratzea da.
Ekonomia-jardueren protagonistak
Pertsonak edo familiak Enpresak Sektore publikoa (estatua)
Kontsumitzaileak dira.
Beren premiak asetzeko erosten dituzte produktu eta zerbitzuak.
Horretarako, soldata baten truke lan egiten dute enpresetan, eta ordainsari hori erabiltzen dute produktuak eta zerbitzuak erosteko.
Ondasun eta zerbitzuak eskaintzen dituzten erakundeak dira. Pertsona batek edo gehiagok osatzen dituzte. Enpresek behar duguna ekoizten, banatzen eta saltzen dute.

Era askotakoak dira, jarduera mota, kapitala eta tamaina aintzat hartuta.
Ekonomia-jardueretan tartean dauden eragile nagusiak familiak, enpresak eta sektore publikoa (estatua) dira. Azken horrek, ekonomia-jardueretarako arauak ezartzeaz gain, aberastasuna banatzen du zergen bidez, bai eta gastua ere.
Zer ekonomia-jarduera mota sustatu behar da?
Ekonomia berdea sustatu behar da. Ekonomia mota horrek ingurumenaren babesa eta gizarte osoaren ongizatea aintzat hartuz eramaten ditu aurrera ekoizpena, banaketa eta kontsumoa.
Ekonomia-jardueretarako arauak ezartzen ditu.
Gainera, ondasun eta zerbitzuak ekoizten ditu enpresa publikoen bidez, eta enpresa pribatuetako ondasunak kontsumitzen ditu.

166 1
Ekoizpena Banaketa Kontsumoa
Zer behar da? Dirua eta gastuak


Behar ditugun produktuak eta zerbitzuak ordaintzeko, dirua erabiltzen dugu.
Gizon-emakumeok, gure premiak asetzeko, denetariko gastuei egin behar izaten diegu aurre egunero. Hiru gastu mota bereizi ditzakegu:
Finkoak Ustekabekoak Aldakorrak
Hilero ordaindu behar direnak: ura, argia, gasa, telefonoa…
Aurreikusi gabekoak: autoaren edo etxetresnen konponketa, adibidez.
Hilero aldatzen direnak, hala nola aisialdiari eskaintzen dizkiogunak.
Nola bihurtzen da nire negozioa ekonomia-jardueraren parte?
Mirarik negozio bat sortu nahi du. Turistei bere herriko produktuak saltzea da asmoa, baina zalantzak ditu. Lagunduko al diozu zuk biderik egokiena aukeratzen?
Irakurri albistea, eta erantzun:
• Zer gastu mota izango ditu nire negozioak hilero?
Finkoak.
Aldakorrak.
Ustekabekoak.
Erantzun guztiak dira zuzenak.
• Nola sortu dezaket nire negozioa?
Familien interesak hartu behar ditut aintzat.
Zergak eta ekonomia-jarduerak
Pertsona edo familiek eta enpresek osasuna, hezkuntza, parkeak, liburutegiak eta gainerako zerbitzuak izatearen truke administrazioari ematen dizkieten ordainak dira zergak.
Bi zerga mota daude:


• Zuzenekoak. Pertsonek eta enpresek beren lanagatik edo dauzkaten ondasunengatik beren soldatatik zuzenean ordaintzen dituztenak dira.
• Zeharkakoak. Ondasun eta produktuak erostean ordaintzen direnak dira; adibidez, produktu bat erostean BEZa (balio erantsiaren gaineko zerga) ordaintzen dugu, eta horrek produktuaren prezioa igotzen du.
1 Bete hutsuneak, esaldi hauetariko bakoitza egia izateko moduan:
a) Ekonomia-jarduera guztiek hiru elementu dituzte: ....., ....., ..... eta ..... .

b) Ingurumenaren babesa eta gizarte osoaren ongizatea aintzat hartzeko, ekonomia ..... sustatu behar da.
c) ....., ..... eta ..... eramaten dituzte aurrera ekonomia-jarduerak.
Estatuari zergak ordaindu behar dizkiodala jakin behar dut.
Nire enpresako langileei soldata bat ordaindu behar diet.
Erantzun guztiak dira zuzenak.
Produktuak eta/edo zerbitzuak ekoizteko, banatzeko eta kontsumitzeko erabiltzen dute dirua familiek eta enpresek.
2 Talde txikitan jarrita, idatzi hiru minutuko tartean gastu finkoen, gastu aldakorren eta ustekabeko gastuen adibideak. Adibide egoki gehien zeinek idazten dituen, talde horrek irabaziko du!
3 Erantzun galdera hauei: a) Zer dira zergak?
b) Zer zerga mota daude, eta zein dira zerga mota horien arteko desberdintasunak? c) Zer esan nahi du BEZ siglak?
U9 167
Gogoan hartu!
Zer da kontsumitzea?
Ba al dakizu kontsumitzaile gisa eskubideak eta betebeharrak ditugula?
Nola kontsumitu?
Gure premiak asetzeko produktuak erostea edo erabiltzea da kontsumoa. Horretarako, dirua behar dugu, eta dirua lortzeko, esfortzu bat egin behar da: lana, alegia. Hori dela eta, zenbait irizpide hartu behar ditugu aintzat kontsumoa bere neurrian balioetsi eta kontrolatzeko.

Kontsumo arduratsurako irizpideak
Arduraz kontsumitu
«Berehala kontatuko dizut»: unitatearen laburpena eskuragarri duzu anayaharitza. es webgunean.

Diruari, soldatari eta aurrezkiei buruz gehiago jakiteko, joan anayaharitza.es webgunera, eta ikusi han dagoen bideoa
Prezioa eta kalitatea alderatu
Arduraz kontsumitzeko, benetan ezinbesteko a dena soilik erosi behar da.
Aurreztu




Aurreztu beharra dago, gero, premia dagoenean, dirua edukitzeko.
Publizitatea eta haren estrategiak
Produktuen prezioa eta kalitatea alderatu behar dira, eta, gero, onena aukeratu.


Publizitatea kritikoki aztertu
Publizitatearen bidez, enpresek produktuen berri ematen digute, haiek kontsumi ditzagun.
Hona hemen, urratsez urrats, kontsumitzaileok produktu baten beharraz eta ontasunaz konbentzitzeko prozesua:
1 Erakarri
Jendearen arreta era kartzen da iragarki deigarri baten bidez.
2 Gogoa piztu
Produktua pertsonei hurbiltzeko, zenbait sentsazio eta zirrara pizten dira haiengan.
3 Konbentzitu
Merkatuan produktu hoberik ez dagoela konbentzitzen saiatzea da xedea.
4 Kontzientziatu
Haren beharraz kontzientziatzeko, iragarkia hedabidez hedabide zabaltzen da.
168 2
Kontsumitzaileon eskubide eta betebeharrak
Beren premiak edo nahiak asetzeko produktuak erosten edo zerbitzuren bat kontratatzen dituzten pertsonak dira kontsumitzaileak.
Kontsumitzaile gisa, gizon-emakumeok inork urratu ezin dituen eskubideak ditugu; esate baterako:
• Informazio egokirako eskubidea. Etiketek, publizitateak eta prezioak zuzen adierazita egon behar dute.

• Kalte-galeren ordainerako eskubidea. Erositako produktuak akatsen bat badu edo adierazia betetzen ez badu, kontsumitzaileak produktua itzultzeko edo konpontzeko eskubidea du.
• Babeserako eskubidea. Legea justiziaz aplikatzeko eskubidea izango du kontsumitzaileak, baldin eta bere eskubideak bete ez direla edo abusuren bat egon dela uste badu.
• Osasunerako eta segurtasunerako eskubidea. Erositako produktuek osasun- eta segurtasun-arauak bete behar dituzte; beraz, jarraibide- edo argibide-orri eta guzti saldu behar dira.

• Kontsumoaren alorreko hezkuntza eta prestakuntzarako eskubidea, kontsumitzaileek legeak zertan laguntzen dien eta nola babesten dituen jakin dezaten.
Kontsumitzaileok betebeharrak ere baditugu. Establezimenduetako arauak errespetatu eta produktuak behar bezala erabiltzeaz gain, kontsumitzaileok gure zergak ordaindu behar ditugu, aurreko orrialde bikoitzean ikusi dugun bezala.
Kontsumoa eta baliabideak
Gizakiok produktu eta energia kantitate handia kontsumitzen dugu egunaren joanean gure premiak asetzeko: elikatzeko, berotzeko, lanerako, aisialdirako... Gero eta gehiago kontsumitzen dugu, eta horrek, ingurumena aldarazten eta planetako bizia arriskuan jartzen duenez gero, ondorio kaltegarriak izan ditzake. Jokabidez aldatzeak, ordea, arazoa galaraz dezake, eta etorkizuneko belaunaldien baliabideak ez agortzea lortu dezakegu.
Bazenekien…?

Giza jarduerek planetan duten eragina neurtzen duen adierazlea da aztarna ekologikoa. Eragin hori adierazteko, gure eguneroko jardueretan erabiltzen ditugun baliabideak ekoizteko eta jarduera horiek sortzen dituzten hondakinak asimilatzeko zenbat lur biologikoki produktibo behar den hartzen da aintzat.

Pertsona bakoitzari 1,8 hektarea globaleko (gha) azalera dagokigu. Bangladeshen (Asia), batez besteko aztarna ekologikoa 0,5 gha-koa da biztanleko; Espainian, 3,7 gha-koa; eta Ameriketako Estatu Batuetan, 9,6 gha-koa. Hortaz, Ameriketako Estatu Batuetan edo Espainian adina kontsumituko bagenu denok, gutxienez gurea halako hiru planeta beharko genituzke. Zure aztarna ekologikoa kalkulatu nahi baduzu, jo webgune honetara: www.footprintcalculator.org/home/es
1 Aukeratu ardura gutxienaz jokatzen duen kontsumitzailea:
a) Patziku. Interneten web-orri batetik bestera aritu da oinetako berberen bila, harik eta merkeenak aurkitu dituen arte.
b) Marta. Beste kontsumitzaile batzuek idatzitako komentarioak irakurri ditu produktuaren kalitateaz informazioa eskuratzeko. c) vImanol. Telebistan iragarri duten alkandora erosi du, telebistan iragarri badute nahitaez ona izan behar duelakoan.
2 Bilatu iragarkiak Interne ten, eta aztertu zer publizitateteknika erabiliz eginda dauden.
3 Bilatu zer den Facua. Enpresa bat sortzean, kontsumitzaile guzti-guztien eskubideak bermatu behar direla kontuan izan behar da.

U9
Gogoan hartu!
Badakizu zer enpresa mota dauden?
Modu desberdinean sailkatu al daitezke produktu bera eskaintzen duten enpresak?
Enpresa motak
Gorago esan dugunez, pertsona batek edo gehiagok osatutako elkartea da enpresa bat, ondasunak eta zerbitzuak ekoizten eta, gero, irabaziak lortzeko saltzen dituena.

Kontsumitzaileok behar ditugun produktuak ekoizteaz, banatzeaz eta saltzeaz arduratzen dira enpresak, eta, alde horretatik, honela sailkatu daitezke:
Jarduera motaren arabera
Natura-baliabideak lortzen eta baliabide horiek produktu bihurtzen dituzte. Erauzketa- eta manufaktura-industria dira nagusi.

Zerbitzuak eskaintzen dituzte, gure hezkuntza-, osasun-, finantza-, garraioeta kultura-premiak eta beste premia asko asetzeko.
Produktuak salerosten dituzte. Handizkariak (beste enpresei saltzen dietenak) edo txikizkariak (kontsumitzaileei saltzen dietenak) izan daitezke.
Tamainaren arabera

10 lagun baino gutxiago. 50 lagun baino gutxiago. 50 eta 250 lagun artean. 250 lagun baino gehiago.

Toki-mailakoak
Tokian-tokian jarduten dute, eta herri eta hirietatik gertu saltzen dituzte beren produktu eta zerbitzuak.

Jarduera-eremuaren arabera

Nazio-mailakoak Multinazionalak



Beren jarduera-eremua herrialde osoa da, eta nazio mailan saltzen dituzte beren produktuak.
Beren jarduera-eremua mundu osoa da, eta nazioartean saltzen dituzte beren produktuak.
170 3
Industrialak Zerbitzuetakoak Komertzialak
Mikroenpresak Txikiak Ertainak Handiak
Kapitalaren jatorriaren arabera
Pribatuak Publikoak Mistoak
Kapitala edo dirua partikularrena da. Kooperatibak badira, kapitala bertan lan egiten duten gizon-emakumeen esku dago.
Estatuaren, erkidego baten edo udal baten esku daudenak dira. Herritarren premiak asetzea da halakoen xedea, ez dirua irabaztea.
Badakizu enpresek gizartearen eta ingurumenaren gaineko erantzukizuna ere badutela?
Enpresek, zeinahi motatakoak direla ere, beren jardueretan ingurumena zaintzeko eta babesteko ahaleginak egin behar dituzte, eta horren aldeko ekintzak martxan jarri. Horretarako, ezinbestekoa da beren produktu eta zerbitzuak sortzeko zer baliabide behar dituzten ebaluatzea: uraren erabilera, energia-kontsumoa, paketatze-sistema…
Gainera, lanpostu seguru eta kalitate onekoak izango dituztela bermatu behar diete beren langileei.

Zer enpresa mota da?
Xabierrek aitarekin eta arrebarekin batera egiten du lan orain dela hamar urte beren amonak bizitza osoko aurrezkiekin sortu zuen enpresan. Ibilaldiak antolatzen dituzte beren herrira, eta kirol-jarduerak ere bai; negu oro, turista asko eta asko erakartzen dituzte.
• Azaldu zer enpresa mota den Xabierrena, haren tamaina, jarduera-eremua, kapitala eta langile kopurua aintzat hartuta.
• Gero, eztabaidatu ikaskideekin zer enpresa mota den, zuen ustez, sortzen errazena.
Partikularrek eta estatuak erdibana jarritako kapitala dutenak dira.
Enpresak tamainaren, jarduera-eremuaren, kapitalaren eta langile kopuruaren arabera sailkatu daitezke.

1 Binaka, aukeratu enpresa bat, bilatu informazioa hari buruz eta bete fitxa hau:
Enpresaren izena: .....

Egoitza nagusiaren helbidea: .....
Enpresa mota, tamainaren arabera: .....
Enpresa mota, jarduera-eremuaren arabera: .....

Enpresa mota, kapitalaren jatorriaren arabera: .....
Enpresa mota, jardueren arabera: .....
2 Adierazi esaldi hauek egia ala gezurra diren:
a) 35 langilez osatutako enpresak mikroenpresak dira.
b) Enpresa batek Espainian, Portugalen eta Frantzian saltzen badu, enpresa mota horri multinazional esaten zaio.
c) Poltsak saltzen dituzten enpresak enpresa industrialak dira.
U9 171
Gogoan hartu!
Nondik lortzen dira lehengaiak?
Badakizu zer lanbide dauden loturik lehen sektorearekin?
Ekonomia-jardueren artean era askotako zereginak daude, ezaugarri komunen arabera sektoreka sail katzen direnak. Hiru sektore daude: lehen sektorea, bigarren sektorea eta hirugarren sektorea.
Lehen sektorea
Naturatik lehengaiak ateratzeaz arduratzen dira lehen sektoreko lanbideak: nekazaritza, abeltzain tza, arrantza, basolana eta meatzaritza.
Nekazaritza

• Zer egiten du? Lurra eta landareak lantzen ditu, produktu begetalak lortzeko.
• Nola sailkatzen da? Behar duen ur kantitatearen arabera, bi nekazaritza mota bereizten dira:
– Lehorrekoa: ur gutxi behar du; euri-ura aski du (zerealak, mahatsondoak eta olibondoak).
– Ureztatua: ur asko behar du; soroak modu arti fizialean ureztatu ohi dira (frutak eta barazkiak).
Espainian, lehorreko nekazaritza da nagusi.
Abeltzaintza

• Zer egiten du? Etxeko animaliak hazten, erosten eta saltzen ditu, elikagaiak eta beste produktu batzuk lortzeko.
• Nola sailkatzen da?
Azienda motaren arabera:


– Hegazti-azienda: oilasko, indioilar, ahate eta an tzarak; ahuntz-azienda: ahuntzak; zaldiak; ardi-azienda: ardiak; txerri-azienda: txerriak; behi-azienda: behi eta zezenak.
Animalia-dentsitatearen arabera:

– Estentsiboa: animalia gutxi lur-eremuko.
– Intentsiboa: animalia asko lur-eremuko.
Azienda mota nagusiak, hurrenez hurren, ardi- eta behi-aziendak dira, eta Penintsularen erdialdean eta iparraldean lantzen dituzte nagusiki.
172 4
Balearrak
Mediterraneo 0100200300km
Balearrak
Kantauri itsasoa
OZEANO ATLANTIKOA
Kanariak
Kantauri itsasoa OZEANO
ATLANTIKOA
OZEANO ATLANTIKOA
Mediterraneo itsasoa
Nekazaritza ureztatua Arroz-soroak Berotegiak Fruta-arbolak Beste ureztatze batzuk
Lehen sektoreaBigarren sektorea Hirugarren sektorea
Espainiako ekonomia-jarduerak sektoreka, 2021ean % 76 % 4 % 20
Arrantza



• Zer egiten du? Arrainak eta bestelako animaliak harrapatzen ditu ibaietan eta itsasoan.
• Nola sailkatzen da? Kostaldearekiko distantziaren arabera:
– Itsas zabalekoa: kostaldetik urrun dagoen itsaso zatian egiten den arrantza mota da, itsasontzi handiak erabiltzen dituena arraina izozteko (legatza, antxoa, bakailaoa).
– Itsasbazterrekoa: kostaldetik gertu dagoen itsaso zatian egiten den arrantza mota da (atuna, sardina, krustazeoak).

Arrantza-portu nagusiak Espainiako kostalde osoan barrena banatuta daude.
Zuhaitzen zura erabiltzen duten jardueren multzoa da basolana; zur hori, gero, altzariak, papera eta
inguru baso dago; % 40, gutxi gorabehera,
1 Zer lan mota egiten dituzte lehen sektoreko jarduerek? Nola sailkatzen dira?
2 Lotu naturari eragiten dioten arazoak eta lehen sektoreko jarduerak: nekazaritza, abeltzaintza, arrantza eta basolana. Esate baterako: a) ongarri kimikoen erabilerak lurpeko urak kutsa tzen ditu; b) altzarien fabrikazioaren ondorioz, basoak soiltzen ari dira; c) itsas hondoetan arrastearran tza egiteak itsas ekosistemak suntsitzen ditu; d) abereen gas-isurpenek airea kutsatzen dute.

Zer-nolako lotura du lehen sektoreak turismoarekin?
Gontzal jatetxe bat irekitzear da, turistak bere herrira erakartzeko. Ez du zuzenean lehen sektoreko inorekin lan egiten, baina, hala eta guztiz ere, aipatu zenbait adibide, Gontzalek sektore horretako langileen lana behar duela agerian uzten dutenak. Esate baterako, arrantzaleen lana behar du, haiek arrantzatutako arraina jatetxean saltzeko.
Gogoan hartu!
Nekazaritza, abeltzaintza, arrantza eta basolana, den-denak lehen sektoreko
U9
100200300km Kanariak Balearrak
Baso-ustiapena Arrantza Arrantza-portu nagusiak Arrantzaguneak
ATLANTIKOA OZEANO ATLANTIKOA Mediterraneo
Kanariak Balearrak
OZEANO ATLANTIKOA
ATLANTIKOA Mediterraneo itsasoa
Abeltzaintza Behiak Txerriak Ardiak Ahuntzak
Kantauri itsasoa
itsasoa
Kantauri itsasoa
OZEANO
0100200300Km
Non eraldatzen dira lehengaiak?
Energia-iturriak eta industria bigarren sektorearen parte dira. Zer dela eta?


Lehengaiak eraldatu eta produktu landu edo erdilandu bihurtzeaz arduratzen da bigarren sektorea.
Meatzaritza
• Zer egiten du? Harriak, mineralak eta erregai fosilak ateratzen ditu Lurraren barnetik.
• Nola sailkatzen da? Erauzketa motaren arabera:
– Lurpekoa: materialak sakonera handiko lekuetan daude, eta meazulo handiak induskatu behar dira lehengaiak ateratzeko.
– Aire zabalekoa: materialak lurgainean daude.
Energia-iturriak
• Zer dira? Naturak berak dituen baliabideak dira, eta baliabide horien bidez lortu dezakegu gero erabiliko dugun energia.
• Nola sailkatzen dira? Bi iturri mota daude:


– Tradizionalak edo berriztaezinak: kantitate mugatua dutenak dira energia berriztaezinak, eta agortu egin daitezke (ikatza, gasa eta petrolioa).
– Alternatiboak edo berriztagarriak: agorrezinak dira, eta ez dute kutsatzen (eguzkia, ura eta haizea).
Energia-iturriak
Meatze-ekoizpenaren balioa 2020an
Mineral metalikoakMineral industrialak
Harrobiak Harri apaingarriak
% 11
% 31
% 23
% 35
Energia-ekoizpenaren banaketa 2020an, energia motaren arabera
% 0,07 % 0,04
Tradizionalak Alternatiboak
% 27,04
% 22,38

% 0,42
% 50,05
Ikatza Petrolioa Gas naturala Energia nuklearra Berriztagarriak Hondakin berriztaezinak
174 5
Nork eskaintzen dizkigu zerbitzuak?
Hirugarren sektoreari zerbitzuen sektore ere esaten zaio. Zergatik?
Hirugarren sektoreko jarduerek ez dute produkturik lantzen; jarduera mota horiek zerbitzuak eskaintzen dituzte, hala nola hezkuntza eta osasun-zerbitzuak.
Merkataritza, garraioa eta turismoa nabarmentzen dira.
Espainian, 2022an lanean aritu ziren 100 lagunetik 76 hirugarren sektoreko langileak izan ziren. Espainiako ekonomia-sektore garrantzitsuena da.
Merkataritza
• Zer egiten du? Salgaiak erosten, saltzen edo trukatzen ditu, irabaziak lortzeko.
• Nola sailkatzen da? Aurrera eramaten duen merkataritzajardueraren arabera:
– Esportaziokoa: produktuak eta ondasunak beste leku edo herrialde bati saltzea. Plastikoa, botikak, ekipamenduondasunak, oinetakoak eta elikagaiak (oliba-olioa, etab.) dira Espainiak esportatzen dituen produktu nagusiak.
– Inportaziokoa: beste herrialde bateko produktuak eta ondasunak erostea. Espainiak, batik bat, produktu ener getikoak (petrolioa) eta ekipamendu-ondasun ugari erosten dizkie kanpoko herrialdeei.
Aurrera eramaten duen merkataritza motaren arabera:
– Barne-merkataritza herrialde barruko merkataritza da.
– Kanpo-merkataritza esaten zaio zenbait herrialderen arteko merkataritza-jarduerari.
Garraioa



• Zer egiten du? Gizon-emakumeak eta salgaiak leku ba tetik bestera lekualdatzen ditu.
• Nola sailkatzen da? Garraio-eremuaren arabera:

– Itsasokoa: itsasoz egiten da, eta gizon-emakumeak eta salgai astunak urrutira eramateko erabiltzen da.
– Lehorrekoa: errepidez edo trenbidez egiten da.
– Airekoa: airez egiten da, eta gizon-emakumeak eta salgai txikiak azkarren lekualdatzen dituen garraio mota da.
esker kanpokoari esker baino.
2 Gurera inportatzen diren produktu asko eta asko edukiontzietan iristen dira. Zer garraiobidek ekartzen ditu?
176
6
Autobiak eta autobideak Bestelako errepideak 0100200300km OZEANO ATLANTIKOA OZEANO ATLANTIKOA M e d i t e r r a n e o i t s a s o a kantauri itsasoa Kanariak Balearrak Santa Cruz de Tenerifekoa Las Palmas de Kanaria Handikoa Santiago de Compostela Palma Gasteiz Bartzelona Valentzia Melilla Oviedo Valladolid Logroño Santander Iruñea Madril Sevilla Zaragoza Murtzia Toledo Ceuta Mérida 75 70 65 60 55 50 45 40 35 30 25 20 15 10 5 0 milioi euro 57,0 39,6 21,3 46,6 8,3 12,5 35,5 26,6 53,7 58,8 70,9 40,5 32,5 5,3 9,9 30,5 38,6 5,8 2,2 63,5 Produktu energetikoak Lehengaiak Semimanufaktura ez-kimikoak Produktu kimikoak Ekipamendu- ondasunak Autogintzaren sektorea Kontsumo- ondasun iraunkorrak Kontsumo- manufakturak Elikagaiak, edariak eta tabakoa Bestelako salgaiak Esportazioak Espainiako kanpo-merkataritza sektoreka, 2021ean Inportazioak
Turismoa
• Zer egiten du? Dibertimenduzko jarduera da, eta aisialdi edo atseden bila bidaiatzea du oinarri. Espainian era askotako turismoa dago.
• Nola sailkatzen da? Aurrera ateratzen duen merkataritza-jardueraren arabera:
– Hondartzako turismoa: kostaldean edo uharteetan egiten dena da. Batez ere udan egiten da.
– Turismo kulturala: kultura-ondare aberatsa duten herri eta hirietan egiten dena da. Urte osoaren joanean egiten da.
– Mendiko turismoa: mendi aldean egiten dena da, eta eskia, mendi-ibiliak eta antzeko jarduerak egitea du helburu. Mendiko turismoa neguan egiten da nagusiki.
– Landa-giroko turismoa: natura betean dauden leku lasaietan egiten dena da. Landa-giroko turismoa urte osoaren joanean egiten da.
3 Zer da turismoa? Idatzi jarduera horrekin loturik dauden bost lanbide.
4 Bilatu Interneten zer turismo mota egiten den leku hauetan: a) Sierra Nevada. b) Laguardia. c) Bilbo. d) Santa Cruz Tenerifekoa. e) Bartzelona.
5 Esplikatu zertan datzan aurreko jardueran aipatutako turismo mota bakoitza, eta bilatu turismo mota horien irudiak.
6 Zein dira grafikoan Espainiak inportatzen eta esportatzen dituen hiru produktu nagusiak?
Hirugarren sektoreko zer lanbide daude loturik turismoarekin?
Kantauri itsasoa
industria, Merkataritza eta Kontsumo Ministerioaren prentsa-bulegoak, Turespaña institutuak enpleguari buruz emandako datuetan oinarriturik, albiste hau argitaratu zuen 2022ko abuztuaren 19an: https://www.mincotur.gob.es/es-es/GabinetePrensa/NotasPrensa/2022/Paginas/El-sector-turC3%ADstico-continua-liderando-la-creaci% C3%B3n-de-empleo-en-julio-con-143.524-ocupados -m%C3%A1s-que-hace-un-a%C3%B1o.aspx. Albisteak lerroburu hau zeraman: «Turismoaren sektoreak nagusi izaten jarraitu du uztailean, eta 143 000 lanpostu gehiago sortu ditu».
Irakurri albistea, eta, gero, erantzun honako galdera hauei:
• Zer lanbidetan sortu da lanpostu gehien?
• Zer-nolako laguntzak eman ditzake gobernuak turismoa sustatzeko?
OZEANO ATLANTIKOA
Kanariak
Mediterráneo itsasoa

• Zein dira enplegu gehien sortu dituzten au tonomia-erkidegoak?
handia



Tarteko turismo-densitatea
Turismo-densitate txikia
Hiri historikoak
U9
León Salamanca Burgos Valladolid Bilbo Granada Kordoba Zaragoza Segovia Alcalá de Henares Mérida Santiago de Compostela Ávila Toledo Madril Cuenca Eivissa Cáceres Bartzelona Donostia Tarragona Málaga Sevilla Valentzia Palma San Cristóbal de La Laguna La Manga Rias Baixas Rias Altas 0100200300km
turismo-eremuak Turismo-dentsitate
Espainiako
Balearrak
OZEANO ATLANTIKOA
Hirugarren sektorearen barruko turismoa da Espainian herritarrei lanpostu gehien eskaintzen dizkien jarduera.
Gogoan hartu!
Nolakoak dira gure erkidegoko
ekonomia-sektoreak?
Zein dira Euskadiko ekonomia-jarduera nagusiak?
Lehen sektorea
Nekazaritza eta arrantza tradizio handiko jarduerak izan dira beti gure erkidegoan. Hala ere, egin diren azkeneko azterketen arabera, ehun pertsonatik batek lan egiten du lehen sektorean euskal herritarren artean.
Lehen sektoreko jarduera nabarmenenak hauek dira:
Nekazaritza
Gure erkidegoko zati handi bateko orografia malkartsua denez, nekazaritza, batez ere, Araban da nagusi. Garia, garagarra, barazkiak eta mahatsa lantzen dira.
Gipuzkoan eta Bizkaian, nekazaritza baserrietan egiten da, eta artoa, barazkiak, patatak, bazkarako landareak eta mahatsa lantzen dira.
Abeltzaintza
Abeltzaintzak garrantzi handia izan du beti. Ardiazienda eta behi-azienda dira nagusi; dena dela, azken urteetan goraldia izan dute txerrien eta hegaz tien haztegiek.

Arrantza



Arrantzak tradizio handia izan du beti Euskal Herrian. Baxurako arrantzan antxoak, hegaluzeak, txitxarroak, etab. harrapatzen dira; alturakoan, berriz, bakailaoak, hegalaburrak eta hegaluzeak.
Getaria, Ondarroa, Hondarribia eta Pasaia dira portu nagusietako batzuk.

Meatzaritza eta basogintza

Meatzaritzan aipatzekoak dira Nerbioi-Ibaizabal arroan dauden burdin meak, eta Anboto mendilerroan, Mañarian eta Abadiñon dauden marmolharrobiak.
Basoen ustiapena lurraldearen zati handi batean egiten da. Hazkunde nabarmena izan du azken urteetan, eta koniferoak eta eukaliptoak erabiltzen dira batik bat zura lortzeko.
178 7
Nekazaritza
Arrantza
Abeltzaintza
Meatzaritza
Bigarren sektorea

Euskal Herriak industria-tradizio handia du. Industria garrantzitsuenak oinarrizkoa eta kontsumo-ondasunena dira.



Inguru industrializatuenak Bizkaia eta Gipuzkoa dira. Bizkaian,

Gogoan hartu!

Antzina industriarako egindako eraikin ikusgarriak daude EAEn, eta horietako batzuk bestelako erabileretarako egokitu dira. Bilboko alondegia, adibidez, diziplinarteko gunea da orain.
Gure erkidegoko sektore garrantzitsuena da, biztanleria aktiboaren % 60k baino gehiagok arlo honetan lan egiten baitu. Hirugarren merkataritza eta banka, hezkuntza eta osasuna, administrazio publikoa eta
turismoak garrantzi
Hiru ekonomia sektoreetako zeinetan lan egiten du jende
Zergatik du nekazaritzak garrantzi handiagoa Araban beste probintzietan baino? Zein dira Arabako uzta nagusiak?
Inguratu, Euskal Autonomia Erkidegoaren mapa batean,
Ikertu eta idatzi gure autonomia-erkidegoko bost leku

U9 179
handiko trena proiektuan Bide zabaleko trenbidea Autopistak eta autobideak Errepide nazionalak Portuak Aireportuak Euskadiko garraioa 01530km Loiu Foronda Pasaiako portua Bilboko portua Bermeoko portua Irun Durango Plentzia Santurtzi Mungia Laudio Eibar Elgoibar Arrasate Azpeitia Deba Gasteiz Donostia Bilbo Merkataritza
Abiadura
Osasuna eta hezkuntza Administrazioa
Nolakoak dira Europako ekonomia-sektoreak?
Zein dira Europako ekonomia-jarduera nagusiak?
Europan sektore bakoitzean lanean aritzen diren herritarren kopurua eta Espainian aritzen direnena paretsukoa da.
Lehen sektorea
Europan, gutxi gorabehera, biztanleen % 4 aritzen da lanean lehen sektorean.

Hona hemen sektore horren ezaugarri nagusiak:
• Nekazaritza modernoagoa eta mekanizatuagoa da iparraldean; han, bazka eta zerealak lantzen dira nagusiki. Hegoaldean, nekazaritza ez da hain modernoa, eta zerealak, olibondoak eta mahatsondoak dira nagusi.
• Abeltzaintza intentsiboa da kontinentearen iparraldean eta erdialdean, eta behi-, txerri- eta ardi-aziendak nabarmentzen dira. Mediterraneo aldean, abeltzaintza estentsiboa lantzen dute, eta behi- eta ardi-aziendak dira nagusi.



• Arrantza aski garrantzitsua da, Europa munduko hirugarren arrantza-eskualde nagusia baita; zehazki, Errusia, Norvegia, Danimarka, Islandia eta Espainia dira munduko arrantzaeskualde garrantzitsuenetakoak.
• Basolana Europa iparraldean da bereziki garrantzizkoa, han baso ugari baitaude. Basoetatik ateratako lehengaia altzariak eta papera egiteko erabiltzen da.
Bigarren sektorea
Europarren % 30 inguru aritzen da lanean bigarren sektorean.
Hauek dira industria nagusiak:

• Tradizionalak —siderurgia, ehungintza eta ontzigintza—, Errusian, Ukrainan, Erresuma Batuan, Italian eta Espainian daude.
• Aktiboak, hala nola elikagai-industria edo industria kimiko, mekaniko eta elektrikoa, eskari handikoak dira. Halakoak Alemanian, Espainian, Frantzian, Herbehereetan, Erresuma Batuan eta Italian daude.
• Goi-mailako teknologiakoak, hala nola aeronautikakoak, telekomunikazioetakoak eta industria elektrikoa, hazi eta hazi ari dira etengabe, eta Frantzian, Alemanian eta Erresuma Batuan daude nagusiki.
180 8
Behi-azienda, Herbehereetan.
Botika-industria, Erresuma Batuan.
Lehen sektorea
Bigarren sektorea Hirugarren sektorea
Espainiako ekonomia-jarduerak sektoreka, 2021ean
% 66 % 30 % 4
Hirugarren sektorea
Europan, gutxi gorabehera, herritarren % 66 aritzen da lanean hirugarren sektorean.
Sektore horretako jardueren artean, hona hemen nabarmenenak:
• Merkataritza: trukeen kopuruagatik da hain garrantzi handikoa. Mundu osora esportatzen dira produktu kimiko eta metalurgikoak, bai eta teknologiaren eta garraioen alorreko materialak ere, eta petrolioa eta denetariko lehengaiak inportatzen dira beste herrialde batzuetatik.
• Garraioa:


– Itsasokoa: salgai-bolumen handiko portuak daude Europan, hala nola Rotterdam, Anberes…

– Lehorrekoa: gure kontinenteak trenbide eta errepide bidezko komunikazio-sare trinko eta modernoa du.
– Airekoa: planetako aireportu garrantzitsuenetako batzuk (Londres, Frankfurt) Europan daude.

• Turismoa: bisitari gehien dituzten herrialdeak Frantzia, Espainia, Italia, Alemania eta Erresuma Batua dira; izan ere, Europa munduko helmuga turistiko nagusietako bat da.

1 Adierazi ea esaldi hauek egia (E) ala gezurra (G) diren:

a) Europa iparraldeko nekazaritza iparraldekoa baino mekanizatuago dago.
b) Europa iparraldean, abeltzaintza intentsiboa da.
c) Arrantza garrantzi handiko jarduera da Europan.
d) Basolana jarduera garrantzitsuagoa da Europa iparraldean hegoaldean baino.
2 Erantzun galdera hauei:
a) Zure ustez, merkataritza jarduera garrantzitsua al da Europan?
b) Zein dira Europako industria nagusiak?
3 Bilatu Interneten zein diren Europan gehien bisitatzen diren monumentuak.
4 Zein dira Europako herrialde turistikoenak? Bilatu informazioa Interneten, eta egin helmuga turistiko horietariko bakoitzean bisitari gehien jasotzen dituzten lekuen zerrenda.
Europan, langile gehienak hirugarren sektorekoak dira; gero, bigarrenekoak; eta, azkenik, lehen sektorekoak.
U9
Gogoan hartu!
Hanburgoko portua, Alemanian.
Merkataritza
Charles de Gaulle aireportua, Parisen.
Garraioa Turistak Erroman (Italia).
Turismoa
Z er ikasi dut?
1 Zer dira ekonomia-jarduerak? Definitu. Gero, jarri ekonomia-jardueren hiru elementuekin lotura duen produktu baten adibidea.
2 Erreparatu tiket honi, eta erantzun:


11 Zergatik lot daiteke irudi hau ekonomiaren hiru sektoreekin?
• Nor egon da tartean erosketa horretan: familia bat, enpresa bat edo estatua?
• Zer dira zergak?
3 Zer gastu mota egin dugu kasu bakoitzean?
• Etxeko argindarra ordaindu.
• Zulatuta dagoen autoko gurpila aldatu.
• Familiarekin afaltzera joan.
4 Egin horma-irudi bat, eta idatzi han kontsumitzaile arduratsua izateko aholkuak.
5 Kontsumitzaile gisa, produktuetako etiketa zuzen idatzita egoteko eskubidea dugu. Ikertu Interneten informazioa ematen eta/edo arriskuren batez ohartarazten diguten zer-nolako ikurrak dituzten produktuek.

6 Luzia turismo-gidari dabil enpresa pribatu batean, eta Kerman, enpresa publiko batean. Zein da aldea?
7 Enpresak sailkatzeko zer lau modu ezagutzen dituzu?
8 Definitu honako kontzeptu hauek: a) Nekazaritza. b) Arrantza. c) Abeltzaintza. d) Basolana.
9 Lehen sektoreko zer jarduerarekin lotuko zenituzke ahuntz-, zaldi- eta txerri-aziendak?
10 Aldatu esaldi hau, egia izan dadin:
«Ideala energia tradizionalak kontsumitzea da; izan ere, halakoek hondakin gutxiago sortzen dituzte, ingurumena gutxiago kaltetzen dute, eta ez dira agortzen».
12 Aukeratu esaldi zuzena:
a) Mendiko turismoan kirol-jarduerak egiten dira, hala nola eskia eta mendi-ibiliak.
b) Turismo gastronomikoa udan egiten da.
c) Gurean ez dago landa-giroko turismorik.
13 Osatu garraio motei buruzko eskema hau:
? ? ?
14 Sortu telebistan emateko moduko eslogan bat, eta ahalegindu haren bidez turistak zure erkidegoa ezagutzera etor daitezen konbentzitzen.
15 Egin proposamenak turista bati, urtaroz urtaro zure erkidegoan nora joan eta zer turismo mota egin jakin dezan.
16 Nolakoak dira Europako ekonomia-jarduerak Espainiakoen aldean?
Semaforoa. Margotu koadernoan, ariketa bakoitzaren ondoan, honela: erantzuna badakizu laguntza behar izan baduzu
erantzuna jakin ez baduzu
182 PORTFOLIOA
Garraio motak
HELBURUA AURRERA
Turismoarekin lotutako enpresa bat sortzea
1 Aztertu eta lotu pentsamendu-giltza erabiliz, ikasleek unitatean ikasitako alderdiak aztertu beharko dituzte ekintza jakin baten bidez: turismoarekin lotutako negozio bat sortuz, zehatz esatera. Horretarako, antolatzaile grafiko bat erabili eta oinarrizko sei galderari erantzun beharko diozue, lekuarekin, denborarekin, jatorriarekin, kausekin, baliagarritasunarekin, lanarekin, eta auzi etiko eta sozialekin loturiko alderdiak argitzeko.

Zure ustez, zertan egingo dio mesede zure negozioa sortzeak zure herriari?
Zuzeneko eta zeharkako zer lanpostu sortzea erraztuko du zure enpresak?
Zer ezaugarri izan beharko lituzkete lanpostu horiek?
Nola sustatu beharko zenuke zure negozioa, turistek haren berri izan dezaten?
Zatoz eta bisitatu nire negozioa!

Zer gastu mota izango ditu zuen enpresak? Zergak ordaindu beharko dituzu?
Zure negozioak urteko sasoi guztietan erakarriko al du jendea, zure ustez?
Zer-nolako loturak izango ditu negozioak hiru ekonomia-sektoreekin?
Jarduera hau talde txikitan egitekoa da, baina emaitzak ikastalde osoari jakinarazi beharko dizkiezue. Horrek bakoitzaren ideiak ikaskide guztien ekarpenekin aberasteko modua emango dizue.
Galdetu hau zeure buruari!
N ola ikasi dut?
1 Ikasi duzu lehen ez zenekien zerbait? Gustatu zaizu ekonomiarekin lotutako alderdiak ezagutzea?
Zertarako da baliagarria ikasi duzuna? Zertarako balioko dizu zure eguneroko bizitzan?

2 Pentsatu zertan hobetzen jarraitu dezakezun aurrerantzean eta egin horri buruzko gogoeta. Hausnarketa zabaltzeko, pentsatu zer hobetu dezaketen ikaskideek.
Zure ustez, enpresek baldintza eta kalitate bereko lanpostuak eskaintzen al dizkiete beren langile guztiei?
Zer egin dezake estatuak, zure ustez, enpleguaren sorrera sustatu eta ekonomia-jarduera bizkortzeko?
Zure ustez, ekonomiaren hiru sektoreetan aurrera eramaten diren lanen ezaugarriak berdinak al dira munduko leku guztietan?
U9 183
1
2
6
4
3
5
10 Espainia XIX. mendean
Estamentu-gizartea, sortzez estamentu jakin bateko kide izatea oinarri zuen sistema, xix . mendearen joanean amaitu eta, haren ordez, klasegizartea sortu zen, hiru klase sozialetan (goikoa, erdikoa eta behekoa) eta pertsonen ekonomia-ahalmenean oinarritutako sistema.
xix . mendeko Espainian, jende gehiena klase apalekoa zen (jornalariak, enplegatuak, langileak…). Jende horrek soldata mendre baten truke lan egiten zuen etxetik kanpora. Gainera, emakumeak ziren, batik bat, etxeko lanak egin eta familiakoak zaintzen zituztenak. Dena den, etxeko lanak (kozinatu, garbitu…) ez ziren orain bezala egiten. Izan ere, kontuan izan behar da garai hartako etxeetan ez zutela ez argindarrik, ez urik eta ez etxetresna elektrikorik.

Zer deritzozu?


Zein dira etxeko lanak gaur egun? Nola egiten ote zituzten etxeko lanak etxean ez argindarrik eta ez txorrotako urik ez zegoen garaian? Gaur egun, zure ustez, zenbat denbora behar izaten da halako lanak egiteko? Zuen etxean nor arduratzen da lan horiek egiteaz? Badute balioespen nahikorik etxeko lanek, zure ustez?

Unitate honetarako...
Helburua aurrera
Egin inkesta bat, etxeko
lanetan familiako nor aritzen den jakiteko, eta idatzi txosten bat lortutako emaitzei buruz.
Jarraitu hariari!
Datua
INEren arabera, emakumeek gizonek baino ia bi aldiz denbora gehiago ematen dute ordaindu gabeko lanak egiten (etxeko lanak eta familia-zaintzak, adibidez):
emakumeek astean 26,5 ordu ematen dituzte; gizonek, berriz, 14 ordu.
Fernando VII.aren erreinaldia.
Azkeneko errege absolutista
1
Zer gertaera historikok eman zion hasiera Aro Garaikideari?
2
Zer gertatu zen Espainian eta Amerikan Fernando VII.aren erreinaldian?
184
Aro
hasiera
Garaikidearen
Isabel II.a eta
Seiurteko Iraultzailea
3
Zer ekarri zioten Espainiari
Isabel II.aren erreinaldiak eta
Seiurteko Iraultzaileak?
Borboiko etxearen
Berrezarkuntza
4
Zein zen
Espainiaren egoera
xix. mendearen amaieran?





EAE
xix. mendean
5
Zer gertakari izan
ziren xix . mendean
gure erkidegoan?
xix. mendeko gertakari eta pertsona ospetsuak
6
Zer pertsona ospetsu eta
gertakari nabarmendu ziren xix . mendean?

185 5
Zer gertaera historikok eman zion hasiera Aro Garaikideari?
Bai munduan eta bai Espainian, xix . mendea aldaketen mendea izan zen. Gauzak ez ziren herrialde guztietan ez modu berean eta ez aldi berean aldatu, baina ondorioak antzekoak izan ziren: gatazka armatuak, gerra zibilak eta estatu-kolpeak.
Frantziako Iraultza
1789an, Frantziako herritarrak armetan altxatu ziren monarkia absolutuaren eta erregearen pribilegioen kontra. Asanblea Nazionala bildu ondoren, Gizakiaren eta Herritarraren Eskubideen Adierazpena idatzi zuten, hiru printzipio oinarri hartuta: askatasuna, berdintasuna eta senidetasuna. Monarkia erorarazi zuten, eta Errepublika aldarrikatu; 1793an, Luis XVI.a erregea prozesatu eta gillotinatu zuten. 1799an, Napoleon Bonaparte militarrak boterea bereganatu zuen, eta, iraultza zabaltzeko asmoz, inperio handi bat sortu zuen armadaren laguntzaz.
Espainia. Karlos IV.a (1788-1808)
Frantziako Iraultza piztu zen urtean (1789), Espainian Karlos IV.a zen errege. Ideia iraultzaileak Espainiara iritsi eta monarkia eroraraziko zuten beldur zirenez, Godoyk, erregearen balido eta konfiantzazko pertsonak, Espainiaren eta Frantziaren arteko muga itxiarazi zuen, baina gero, 1808an, ildo politikoa aldatu eta ituna egin zuen Napoleon Bonaparterekin.

Gerraren aurrekariak

1808an, Godoyk eta Napoleonek Fontainebleauko Ituna sinatu zuten, eta Espainiak Penintsula zeharkatzen utzi zion Frantziako armadari, Portugal inbadi zezan.
Aranjuezko Matxinadaren ondorioz, Karlos IV.ak Godoy kargugabetu eta boterea bere seme Fernando VII.aren esku utzi zuen. Espainia barruko borrokak aprobetxatuz, Napoleonek Frantziara joan zitezen eskatu zien Karlos IV.ari eta Fernando VII.ari, eta Espainiako tronua Josef Bonaparteren esku geratu zen Baionako abdikazioetan.
«Berehala kontatuko dizut»: unitatearen laburpena eskuragarri duzu anayaharitza.es webgunean.
1 Zer izan zen Frantziako Iraultza? Zer-nolako ondorioak eragin zituen Espainian?
2 Zer eragilek piztu zuten Espainiako Independentzia Gerra? Zer da gerrillagerra?
3 Egin gogoeta eta formulatu galderak gertaera hauetariko bakoitzari buruz. Horren ondoren, eskatu ikaskideei planteatutako galderei erantzuteko: a) Fontainebleauko Ituna; b) Josef I.a; c) Bailéngo Gudua; d) 1812ko Konstituzioa; e) Fernando VII.a.



Gerra piztu aurreko garaia. Frantsesen okupazioa eta matxinadak
Portugalera bidean, 1808an, Napoleonek Espainiako hainbat leku okupatu zituen, eta horrek espainiarrak altxarazi zituen frantsesen okupazioaren kontra (Aranjuezko Matxinada).
Baionako abdikazioak. Beste errege bat Espainian
186 1
Iturri historikoak, hala nola margolan eta testuak, oso lagungarriak dira xix. mendeko gertaerak eta gizartea ulertzeko.
1 2 3
Fontainebleauko Ituna (1808)
1. Fernando VII.a. 2. Karlos IV.a. 3. Josef I.a.
Independentzia Gerra
Independentzia Gerra 1808an hasi eta 1814an amaitu zen, eta bi ondorio izan zituen: alde batetik, Espainia eta Frantzia aurrez aurre aritu ziren, eta, bestetik, iraultza hasi zen monarkia absolutistaren kontra.



Hasiera 1808ko maiatzaren 2an, Frantziako armada Madrilen sartu zen, eta horrek madrildarren eta beste hiri eta herri batzuetako jendearen matxinada piztu zuen. Frantziako armadak oso gogor ito eta zapaldu zituen matxinada horiek guztiak.
Garapena Hirietan matxinadak izan ziren, jendeak aurre egin baitzion Frantziako armadaren okupazioari. 1808an, Napoleonen armadak estreinako aldiz egin zuen porrot Bailéngo Guduan.

Landa-eremuan, inguruaren ezagutza erabiltzen zuten etsaiari ustekabean erasotzeko, eta, hala, etsaiak lurraldea bereganatzea galarazten zuten; horri gerrilla-gerra esaten zaio. Frantsesek aurrera egiterik ez zutenez, Napoleonek tropa gehiago bidali behar izan zituen.
Cádizko Gorteak eta gerraren amaiera
Erregeak abdikatu egin zuen, eta, beraz, herritarrak batzordetan antolatu ziren gerra zuzentzeko. Cádizko Batzorde Nagusiak hartu zuen bere gain boterea, eta gerra koordinatzeari eta erreformak egiteari ekin zion. Gorteak bildu ziren (1810), eta Espainiako lehen Konstituzioa egin zuten 1812an; lege-testu hartan, botere-banaketa ezarri eta burujabetza herriari zegokiola onetsi zuten, eta legearen aurreko berdintasuna, iritziaskatasuna eta beste eskubide batzuk aitortu zituzten.
Napoleonen armadak bi urtez setiatu zuen Cádiz lehorrez eta itsasoz, baina ez zuen hiria okupatzea lortu. Azkenean, 1814an, frantsesek atzera egitea lortu zuen Espainiak Ingalaterraren laguntzaz, eta Napoleonek Espainiako erregetzat onartu zuen Fernando VII.a.
Nola aldatu diren etxeko lanak!
Emakumezko eltzegile eta urketariek, hala nola María Bellidok, oso lan nabarmena egin zuten Bailéngo Guduan: gudariei adorez beterik eramaten zieten ura putzu eta ubideetatik.
Horrek agerian uzten du lehen mundu deritzonean zeinen garrantzitsua zen iraganean ura egunero-egunero etxez etxe banatzea, xix mendeko etxeetan ez baitzuten ez txorrotako urik eta ez argindarrik.
• Gai zara gaur egungo etxeetan egunero-egunero egiten diren lan guztiak zerrendatzeko?
• Ikertu eta alderatu taula batean ikasgai honetan lantzen ari zaren garaiko etxeko lanak eta gaur egungoak.
Gogoan hartu!



Espainiako hirietako zenbait etxetan, xx . mendearen hasieran jarri zuten
txorrotako ura. Izugarrizko luxua, inondik ere!
U10 187
Zer gertatu zen Espainian eta Amerikan
Fernando VII.aren erreinaldian?
Zer gertatu zen Cádizko Konstituzioak aitortu zituen eskubide eta askatasunekin?
Espainian

Independentzia Gerraren ondoren, Fernando VII.a Espainiara itzuli zen; haren erreinaldiak 1814tik 1833ra arte iraun zuen, eta fase hauek izan zituen:
Seiurteko Absolutista: absolutismoaren itzulera (1814-1820)


Fernando VII.ak 1812ko Konstituzioa eta hari esker lortutakoa abolitu zuen absolutisten babesarekin, eta liberalei jazarri zitzaien.

Aldi horretan, Fernando VII.ak errege absolutu gisa gobernatu zuen. Errege absolutu batek bi ezaugarri ditu: batetik, botere guztia du bere esku, eta, bestetik, ez du onartzen herritarren eskubide eta betebeharrak jasotzen dituen konstituzio baten aginterik.


Hirurteko Liberala: liberalak absolutisten aurka (1820-1823)
1820an, Rafael del Riego militar eta politikari liberalaren altxamendu edo jazarraldi militarraren ondorioz, Fernando VII.ak 1812ko Cádizko Konstituzioaren zina egin behar izan zuen. Horrenbestez, Cádizko Gorteek promulgatutako erreformak berreskuratu zituzten liberalek.
Fernando VII.ak herrialde absolutisten babesa bilatu zuen (Austriarena, Prusiarena eta Errusiarena), denek ere absolutismoaren aldeko itun bat baitzuten sinatua: Aliantza Santua, alegia. 1823an, aliantzako kideek armada bat bidali zuten Fernando VII.ari absolutismoa berrezartzen laguntzeko.
Hamarkada Doilorra (1823-1833)
Absolutismoa berrezarri ondoren, 1823an, ideia liberalak zituzten pertsona ugari zigortu eta espetxeratu zituzten. Egoera, ordea, aldatu egin zen erregearen alaba Isabel printzesa jaio zenean, 1830ean. Ondorengotzaren auziak arazoak sortu zituen, Espainian lege salikoak tronura iristea galarazten baitzien emakumeei. Fernando VII.ak legea indargabetu zuen, bera hil ondoren haren alaba Isabel izan zedin erregina. Artean Fernando VII.aren anaia Karlos zen erregegaia, eta ez berak eta ez absolutistek ez zuten erabakia onartu. Erregea gaixotzean, boterea haren emazte Maria Kristinaren esku gelditu zen, eta Maria Kristina liberalengana hurbildu zen, liberalek haren alaba Isabel babesten baitzuten erregina izateko. Hala, 1833an, Fernando VII.a hiltzearekin batera, Isabel erregina bihurtu zen.
188 2
Fernando VII.a
Fernando VII.aren itzulera Espainiara.
Fernando VII.a Konstituzioaren zina egiten.
Fernando VII.aren heriotza.
Nork kozinatzen du etxean?
❒ Aitak


❒ Amak




❒ Seme-alabek laguntzen dute
❒ Beste norbaitek

Inkesta, ikerketarako baliabide apropos-aproposa
Espainiako etxeetako bizi-kalitateak aurrera egin du xix. mendeaz geroztik. Gaur egun, erdimailako klaseko familia batzuek soldataren zati bat ordaintzen dute etxeko lan batzuk egingo dizkien norbait kontratatzeko.
Amerikan
Fernando VII.aren erreinaldian, Espainiaren kolonia askok independentzia eskuratu zuten.
Eragileak
Kausen artean, hona hemen nabarmenenak:
• Espainiari gero eta zerga gehiago ordaindu behar izatea.
• Espainiako kolonoen ondorengo edo kreoleen nahigabea, Espainiak abandonaturik eta gutxietsirik zituela sentitzen baitzuten.
• Ideia liberalen zabalkundea; liberalek, batetik, legearen aurreko berdintasuna babesten zuten, eta, bestetik, konstituzioak idatzi eta onetsi beharra, botere legegilearen, betearazlearen eta judizialaren arteko banaketan oinarriturik.
Etapak
Independentzia-prozesuan, bi etapa bereizi behar dira:
1. Independentzia Gerraren garaian (1808-1814)
Frantziaren aurkako gerran, kolonietan, Espainian bezalaxe, batzorde iraultzaileak sortu zituzten beren independentzia aldarrikatzeko. Batzorde horiek Fernando VII.a boterera itzultzean desegin zituzten.
2. Fernando VII.aren erreinaldian (1814-1833)
Koloniek beren gobernuak antolatzeko autonomia eskatzen zioten erregeari, baina erregeak ez zuen eskaera onartu. Ideia liberalak zituzten militarrek, hala nola Simón Bolívarrek eta José San Martínek, armada handiak eratu zituzten, eta Espainia garaitu eta independentzia lortu zuten Britainia Handiaren eta Estatu Batuen babesarekin.
Espainiak hiru koloniari eutsi zien: Kubari eta Puerto Ricori (Amerikan), eta Filipinei (Asian).
• Etxean zer-nolako lanak egin behar izaten diren kontuan izanda —aurreko ikerlanean zerrendatu behar izan dituzue lan horiek—, egin galderak eta bilatu datuak etxean partekatzen ditugun lanei buruz. Eman ikastaldeari zure galderen berri, denon artean inkesta bakarra egiteko.
• Egin inkesta ahalik eta jende gehienari. Gero, eman elkarri bildutako datuen berri taula edo grafiko baten bidez.
1 Egin ardatz kronologiko bat, eta adierazi han Fernando VII.aren erreinaldiko data eta gertaera nagusiak.
2 Ikertu. Badago lege salikorik Europako herrialderen batean? Hitz egin horri buruz ikaskideekin. Zer aldatuko luke gaur egungo Espainian halako lege bat egoteak?
3 Asmatu lerroburu bat eta idatzi albiste bat Fernando VII.aren erreinaldian Espainiak Ameriketan zituen kolonietan gertatutako pasadizoren bati buruz.
Joan anayaeducacion.es webgunera, eta ikusi Ameriketako herrialdeen independentziari buruzko mapa.
Gogoan hartu!
Etxeko lanak egunero egiten dituztenen artean, emakumezkoak % 77,5 dira, eta gizonezkoak, % 32,9 . Iturria: INE.www.epdata.es
U10 189
Zer ekarri zioten Espainiari Isabel II.aren erreinaldiak eta Seiurteko Iraultzaileak?
Hobetu al zen herritarren bizimodua?

Isabel II.a (1833-1868)

Erregeordetzaren garaia (1833-1843)
Isabel II.a hiru urterekin iritsi zen tronura. Adin txikikoa zenez, bi erregeorde izan ziren, haren izenean erreinatu zutenak: haren ama, Maria Kristina Borboi-Bi Sizilietakoa, 1833tik 1839ra bitartean; eta Espartero jeneral liberala, 1840tik 1843ra bitartean.
Maria Kristinaren erregeordealdian lehen karlistaldia (1833-1839) piztu zen. Aurreko orrialdeetan ikusi dugunez, Fernando VII.aren ondorengotzaren auzian bi alderdi sortu ziren: bat, karlistena, absolutisten babespean Fernando VII.aren anaia Karlos errege izatearen aldekoek osatzen zutena; bestea, liberalena, tronua Fernando VII.aren alaba Isabelentzat izatearen aldekoek osatzen zutena. Gerra liberalek irabazi zuten 1839an.

Isabel II.aren erreinaldia (1843-1868)
Isabel II.aren erreinaldia 1843an hasi zen, eta horrek aldi liberala sendotu zuen Espainian. Aldi hori ideia liberalak zituzten alderdi politikoen sisteman oinarritzen zen; bi alderdi zeuden: moderatua eta progresista. Alderdi horiek txandaka gobernatu zuten, eta, boterea lortu ahala, bakoitza bere ideiak ezartzen eta bere konstituzioa egiten ahalegindu zen.

• 1844tik 1854ra bitartean, alderdi moderatua egon zen boterean. Erregeak eta herriak boterea partekatzearen aldekoak ziren moderatuak. Haien agintaldian 1854ko Konstituzioa onetsi eta bigarren karlistaldia (1846-1854) piztu zen, baina orduko hartan ere Karlos erregegaiak ez zuen errege izatea lortu.
• 1854tik 1856ra bitartean, alderdi progresistak gobernatu zuen. Alderdi horrek herriaren boterea edo burujabetza nazionala babesten zuen, eta 1856ko Konstituzioa onetsi zuen.
• 1856tik 1868ra bitartean, bi alderdi iritsi ziren boterera: alderdi moderatua eta alderdi berri bat, Batasun Liberala. Beste alderdi batzuk ere sortu ziren, hala nola demokratak eta errepublikanoak, monarkia indargabetu nahi zutenak.
Isabel II.aren erreinaldiak krisi ekonomikoari eta uzta txarreko zenbait urteri egin behar izan zien aurre. Horrek guztiak herritarrak haserrearazi zituen, eta 1868an iraultza piztu zen: «La Gloriosa» ezaguna. Horren eraginez, erreginak alde egin behar izan zuen, eta, horrenbestez, beste etapa bat hasi zen Espainiako historian.
Alderdi Moderatua
Botere ekonomiko handiko pertsonek osatzen zuten
Erreginak eta herriaren ordezkariek boterea partekatzearen alde zeuden. Erreginaren boterea sendotzea zen haien asmoa.
Ramón María Narváez zen alderdiaren ordezkari nagusietako bat.
Alderdi Progresista

Hiri- eta langile-giroko erdi-mailako klaseek osatzen zuten. Boterea eta burujabetza nazionala herritarren ordezkariei zegokielako ideia babesten zuten.
Erreginaren boterea mugatu nahi zuten.
Bi ordezkari nagusi: Baldomero Espartero eta O´Donnell.
1 Berehalako zer ondorio izan zuen Isabel II.a tronura iristeak? a) Iraultza bat: «La Gloriosa» ezaguna. b) Krisi ekonomikoa eta uzta txarreko zenbait urte, herritarrak haserrearazi zituena. c) Lehen karlistaldia piztu izana.
190 3
Isabel II.a
Narváez. Espartero.
Seiurteko Iraultzailea (1869-1874)
Isabel II.ak alde egitean, behin-behineko gobernu bat eratu zen. Gobernu horrek 1868ko Konstituzioa egin zuen.
Beste errege bat Espainian, Amadeo Savoiakoa (1870-1873)
Beste errege bat bilatzeari ekin zioten Espainian. Erregegaien artean, Gorteek Amadeo Savoiakoa italiarra hautatu zuten 1870ean. Haren erreinaldi laburrean, erregeak alderdi errepublikanoa, militarrak eta Borboiko etxearen aldekoak izan zituen aurrean. Hiru urte boterean egon ondoren, erregeak 1873an abdikatu zuen, eta Lehen Errepublika aldarrikatu zuten.
Lehen Errepublika (1873-1874)
Errepublikanoak zatituta zeuden: batzuek estatu zentralista nahi zuten, eta besteek estatu deszentralizatua, boterea Espainia osatzen zuten lurraldeen artean banaturik egon zedin.
Garai horretan, gainera, hirugarren karlistaldia (18721876) piztu zen; Kubak kolonia izateari uzteko independentzia-gerrari ekin zion; eta zenbait udalerrik, hala nola Cartagenak, errepublika edo kantoi independente izendatu zuten beren lurraldea.

Horrek guztiak Lehen Errepublika amaitzea eragin zuen, eta halaxe itzuli zen boterera Borboiko etxea: 1874an, Alfonso XII.a errege bihurtu zen.
Etxeko lanaldia
Etxeetan etxetresnak erabiltzen hasi izanak etxeko lanak erraztu zituen, familiek xix mendean baino denbora gutxiago eman behar izaten baitzuten halako lanak egiten. Hala eta guztiz ere, etxeko lanak aparteko lanaldi bat izaten dira familia askotan: eguna lanean eman ondoren, askok etxeko lanak egin behar izaten dituzte.
• Ikertu. Gutxi gorabehera zenbat denbora eman ohi dugu egunero etxeko lan bakoitza egiten? Gutxi-asko zenbat denbora ematen dugu guztira etxeko lanak egiten?
• Hausnartu eta hitz egin ikaskideekin. Harritu al zaituzte emaitzek? Arrazoitu zure erantzuna.
Gogoan hartu!


Gaur egun, familia eta lana bateragarri egiteko zailtasunak dituzte etxe askotan; arazo nagusia lanorduak dira, batez ere lanaldi etenak.
2 Karlisten eta liberalen arteko gerrei karlistaldi esaten zaie. Zergatik?
3 Bete beheko taula hau, eta alderatu alderdi moderatuak eta alderdi progresistak babesten zituzten ideiak.
Jarrera edo ideia nagusiak Alderdi moderatua Alderdi progresista
Burujabetza nazionala ? ?
Erreginaren boterea ? ?
Alderdikideak ? ?

4 Lehen Errepublikan, alderdiak ez zetozen bat Espainiak estatu zentralista edo estatu deszentralizatua izan behar zuen. Zertan dira desberdinak bi estatu mota horiek? Zein da egoera gaur egun?
5 Dado-jokoa. Binaka jarrita, formulatu bost galdera ikasi berri duzun historiaren aldiko gertaera eta pertsona nagusiei buruz, eta jarri zenbaki bat galdera bakoitzari. Horren ondoren, eskatu beste bikote batzuei dadoa botatzeko, eta erantzun diezaietela egin berri diezuen galderei. Zenbat galderari erantzungo ote diote zuzen?
U10 191
Zein zen Espainiaren egoera xix . mendearen amaieran?

Zer-nolako eragina izan zuen garai hartan klase apaleneko gizon-emakumeak analfabetoak izateak?
Borboiko etxea 1875ean itzuli zen boterera, eta Isabel II.aren seme Alfontso XII.ak (1875-1885) monarkia berrezarri zuen. Cánovas del Castillo politikariaren bitartekotzak egin zuen posible Berrezarkuntza:



• Isabel II.ak bere seme Alfontso XII.aren mesedetan tronuari uko egitea lortu zuen.
• Bere garaiko indar politikoek erregea onar zezaten lortu zuen, eta monarkia konstituzionala agindu zien ordainetan.
Zer izan zen Berrezarkuntza?
Berrezarkuntzaren oinarriak
Sistema politikoak bi oinarri izan zituen: 1876ko Konstituzioa eta txandakako gobernu-sistema baketsua.
1876ko Konstituzioa

Konstituzio moderatua eta irekia zen, eskubideak zabaldu edo murriztu egin baitzitezkeen, gobernuan zer alderdi zegoen aintzat hartuta. Ezaugarri nagusiak:
• Burujabetza (boterea) Gorteek (herriaren ordezkariek) eta erregeak partekatzen zuten.
• Botere-banaketa onesten zuen.

• 25 urtetik gorako gizonek bakarrik bozkatu zezaketen.
• Merkataritza-askatasuna aldarrikatu zen, baina argitalpenak mugatu ziren (zentsura).
Berrezarkuntzaren funtzionamendua
Txandakako sisteman, gobernuan zegoen alderdia ahultzen zenean, oposizioak beste gobernu bat eratzen zuen erregearen aginduz, eta hauteskunde-deialdia egiten zuen, zer alderdik irabaziko zuen aurrez jakinda.
Horretarako, botoak manipulatzen ziren: boto-paperak gogara gehitzen edo kentzen ziren hautetsontzietatik, eta landa-eremuan, botere ekonomiko eta sozial handia zutenek, jauntxoek, boto-emaileei zer bozkatu agintzen zieten (gizonek bakarrik bozkatu zezaketen). Horri kazikismo esaten zitzaion.
Txandakako gobernu-sistema baketsua
Alderdi Kontserbadorea, moderatuen ondorengoa, eta Alderdi Liberala, progresisten ondorengoa, boterean txandakatzea zuen oinarri txandakako gobernu-sistemak.
Alderdi Kontserbadorea. Ideologia kontserbadorea zuen, eta goi-mailako klaseak ordezkatzen zituen. Cánovas del Castillo zen alderdiko buruzagia.
Alderdi liberala. Ideologia liberal progresista zuen, eta erdi-mailako klaseak ordezkatzen zituen. Sagasta zen alderdiko buruzagia.
192 4
Txandakako gobernu-sistema
Cánovas buruzagi kontserbadorea. Sagasta buruzagi liberala.
Alfontso XII.a
Berrezarkuntzaren aurkako oposizioa
Sistemaren aurkako oposizioa honela osatzen zen:
• Alderdi politikoak. Hona hemen Berrezarkuntzaren aurka zeuden alderdiak: Alderdi Karlista, monarkia absolutuaren itzulera babesten zuena; Alderdi Errepublikanoa, estatu forma gisa errepublika proposatzen zuena; eta PSOE (Espainiako Alderdi Sozialista Langilea), 1879. urtean sortua.
• Langile-mugimendua. Langileen mugimenduak bi lekutan izan zuen indarra: Kataluniako fabrika-giroan, eta Andaluziako nekazari-jendearen artean. Ideia sozialistak eta anarkistak babesten zituzten, eta gizarteko desberdintasunei aurre egiten zieten.
• Mugimendu nazionalistak. Euskadiko, Kataluniako eta Galiziako nazionalismoak nabarmendu ziren, hirurak ere Berrezarkuntza garaiko zentralizazio-politiken kontra sortuak. Beren hizkuntza, historia, ohiturak eta tradizioak erreibindikatzen zituzten.
Berrezarkuntzaren amaiera
Alfontso XII.a 1885ean hil zen, haren seme Alfontso XIII.a jaio baino hilabete batzuk lehenago. Errege izendatu berria adinez nagusi izan zen arte, haren ama Maria Kristina Habsburgokoa izan zen erregeorde. Barne-gatazkek, Espainiak Kuban eta Filipinetan zituen azken koloniek independentzia lortu izanarekin batera, krisi ekonomiko eta ideologiko handia eragin zuten: «98ko krisia», alegia. Horren ondorioz, ustelkeria politikoari aurre egin eta Espainiako arazoak konpondu nahirik, erregenerazionismo izeneko mugimendua sortu zen.
1 Zer esan nahi du berrezarkuntza hitzak? Zergatik erabiltzen da hitz hori ikasi berri duzun Espainiako aldi historikoa izendatzeko?
2 Zer zen txandakako gobernu-sistema? Zer legeren ondorioz jarri zuten martxan?
3 Irakurri arretaz 1876ko Konstituzioaren ezaugarri nagusiak. Idatzi, labur-labur, zer iritzi duzun ezaugarri horiei buruz. Onak ala txarrak iruditzen zaizkizu? Zer dela eta?
xix mendearen bigarren erdian, Ameriketako Estatu Batuetan feminismoa sortu zen, emakumeen eta gizonen arteko berdintasuna babesten zuen mugimendua. Ideia feministak Europan barrena zabaldu ziren gerora.

4 Nola kontrolatzen ziren hauteskundeak txandakako gobernu-sistema baketsuaren garaian?
5 Zer gertaeraren ondorioz piztu zen «98ko krisia» esaten zaiona?
6 Zer-nolako jarrera zuten Berrezarkuntza garaiko alderdi eta mugimenduek taula honetan aipatzen diren ideiei buruz?
✓ Alde ✘ Kontra ● Ez dut argi
Alfontso XII.a erregea ? ? ? ? ?

Errepublika estatu forma gisa ? ? ? ? ?
Boterea goi-mailako klaseentzat ? ? ? ? ?
Boterea erdi-mailako klaseentzat eta langileentzat ? ? ? ? ?
U10 193
Ideia Alderdi Kontserbadorea Alderdi Liberala Alderdi Karlista Alderdi Errepublikanoa Langilemugimenduak
Gogoan hartu!
Zer gertakari izan ziren
XIX. mendean gure erkidegoan?

Garrantzitsuak iruditzen zaizkizu xix mendean gure autonomia-erkidegoan izandako gertakariak?
Frantziako Iraultza
Frantziako Iraultzan, soldadu frantziarrak Espainiako estatuan sartu ziren eta gure lurraldearen zati bat okupatu zuten. Gipuzkoako probintzia Frantziako Errepublikara batzeko asmoa ere agertu zuten.
Independentzia Gerra
1807an, Frantziako tropak Iberiar penintsulan sartu ziren eta Donostia hartu zuten, eta armadaren zati bat hirian geratu zen gerra osoan zehar.


Frantsesek Gasteizko Gudua galdu zutenean, armada frantziarra Gipuzkoako hiriburuan gotortu zen, eta han egon ziren ingelesek eta portugesek ezarritako setioaren ondorioz 1813an errenditu ziren arte. Setio horrek iraun zuen bitartean, hiriak kalte handiak izan zituen.

Foruen abolizioa
1876an, Hirugarren Karlistaldia amaitu zenean, foruak abolitu ziren.
Euskal lurraldeek administrazioaren arloan nolabaiteko autonomia izaten jarraitu bazuten ere, euskal herritarrei onura fiskal guztiak kendu zitzaizkien eta, horrez gain, soldaduska egitera derrigortu zituzten.
Foruen abolizioa



Emakumeak gerran
Gerra imajinatzean, ziur asko gizonezko gudariak etorriko zaizkigu burura. Binaka jarrita, erantzun:
• Parte hartuko zuten emakumeek xix . mendeko gerretan? Zer lanetan arituko ziren, batik bat?
• Bilatu nor izan zen Martina Ibaibarriaga eta zer ibilbide izan zuen Independentzia Gerran.

194 5
Independentzia Gerra
Hondarribiko ikuspegia, 1786.
Frantziako Iraultza Gasteizko Gudua, 1813.
Alegoria honek Espainiako Errepublika irudikatzen du Gernikako arbola mozten, haren fruituak, foruak, karlismoarekin lotzen zirelako.
Gogoan hartu!


Industrializazioaren hasiera
xix. mendearen erdialdetik, gure eskualdea oso bizkor industrializatu zen; batez ere, burdingintzaren, ontzigintzaren, banku-industriaren, tren-industriaren eta metalurgiaren bultzadak eraginda.

• 1856an Norteko Konpainia sortu zen (gaztelaniaz, Compañía de los Caminos de Hierro del Norte de España), Madril eta Irun trenbidez lotzeko.

• 1857an Bilboko Bankua sortu zen, eta TuteraBilbo burdinbidea eraikitzea finantzatu zuen.
Bilbo eta Bilboko itsasadarra euskal industrializazioaren eragile bilakatu ziren. Hirian garapen ekonomiko eta sozial handia gertatu zen, baina alde txarrik ere ekarri zuen horrek: airearen eta uraren kutsadura areagotu egin zen, eta inguruko naturapaisaiak erabat aldatu ziren.
Hiriak hirurogei mila biztanle zituen 1857an, eta ia berrehun mila xix . mendearen amaieran. Hazkunde horrek bazterreko auzoak sortzea ekarri zuen.
Industrializazioa eta lan-baldintzak
Beharginen lan-baldintzak penagarriak ziren: hamabi orduko lanaldiak egiten zituzten, eta oso soldata txikia kobratu; batez ere, emakumeek eta umeek.
Kasu askotan, emakumeek etxean bertan lan egiten zuten, josten, lisatzen, garbitzen, etab. Hori dela eta, haien lana ikusezina izaten zen sarritan.
Aldi horretan, langile-klasearen lan-baldintzak hobetzeko asmoz, langile-elkarte sozialista batzuk sortu ziren, eta lehen grebak deitu ziren.
1 Ikertu eta laburtu ingeles eta portugesek 1813an Donostian ezarri zuten setioa. Urteko zer egunetan gogoratzen da gertakari hura?
2 Erantzun karlistaldiei buruzko galdera hauei:
a) Zer izan ziren karlistaldiak?
b) Nor zeuden aurrez aurre?

c) Zer ondorio izan zituen gure herriarentzat Hirugarren Karlistaldiaren amaierak?
3 Aipatu Bilboko industrializazioak izan zituen bi alde on eta bi alde txar.
4 Bilatu Interneten Bizkaiko emakumeen lanbideak eta zereginak. Atzoko eta gaurko irudiak dokumentua, eta laburtu Bizkaiko emakumeek xix . mendean izan zuten rola, bai hirian eta bai landa-eremuan ere.
5 Zer saiakera egon ziren langile-klasearen lanbaldintzak hobetzeko?
U10 195
Burdin fabrika, altzairu-fabrika eta labe garaiak, Barakaldon.
Neskatoa ehungintza-fabrika batean.
Langile-klasearen baldintzak hobetzeko testuinguruan, sufragismoa eta emakumeen eskubideen aldarrikapena ere indartu ziren.
Zer pertsona ospetsu eta gertakari nabarmendu ziren XIX. mendean?
Zer gertaeratan egon ziren tartean xix mendeko pertsona ospetsu hauek, eta gertakari horietako zein izan ziren erabakigarriak?

«¡Viva la Pepa!» deiadarra ezagun bihurtu zuten absolutisten kontra 1812ko Konstituzioaren aldarrikapena ospatzen zuten liberalek. Deiadar hori erabili zuten, halaber, Fernando VII.a errege zela Espainian izan ziren bi jazarraldietan (1814-1820 eta 18231833).



Espainiako Independentzia Gerrako heroi gisa gogoratzen naute. Aurre egin nien Napoleonen tropen erasoei, eta Zaragozako herritarrak mobilizatu nituen. Erasoetako batean hiriko ateetako bat babesten ari zirenak nola hiltzen zituzten ikustean, kanoikada bat jaurti nien frantses tropei. Segada bat jarri zietelakoan, frantsesek atzera egin zuten, eta espainiarrak atera joan ahal izan ziren, sarbidea babesteko.
Zuzenbidea ikasi nuen, eta artikuluak idatzi nituen La Iberia egunkari liberalean. 1860an, semearen izenpean, Ongintza, filantropia eta karitatea argitaratu nuen, Zientzia Moral eta Politikoen Akademiak saritutako liburua. Benetan nor nintzen jakitean, Akademiak saria kendu zidan lehenbizi, baina azkenean zegokidan aitortza egin zidan. Gizonek eta emakumeek arlo guztietan (hezkuntzan, lanean…) berdinak izan behar dutelako ideia defendatu nuen.
Concepción Arenal (1820-1893)
Galegoz eta gaztelaniaz idazten zuen espainiar idazle gisa igaro naiz historiara. Lan handia egin nuen Galiziak bere nortasuna, kultura, historia eta hizkuntza berreskuratzearen alde. Nire lan nabarmenenak Cantares gallegos eta Follas novas dira.




196
6
¡Viva la Pepa! (1812)
Agustina Aragoikoa (1786-1857)
Rosalía de Castro (1837-1885)
Erregina eta erregeorde izan nintzen nire seme Alfontso XIII.a adin txikikoa izan zen bitartean. 1886an, nire senar Alfontso XII.a hiltzean, boterea hartu nuen 1902ra arte. Erregeorde izan nintzen hamazazpi urteetan, alderdi liberalak eta alderdi kontserbadoreak txandaka eta modu baketsuan gobernatzeko ituna egin zuten.
Espainiako erregina izan nintzen 1833tik 1868ra bitartean. Nire erreinaldian aldaketa politiko handiak egin ziren, liberalismo politikoa ekarri eta Espainia estatu liberal bihurtu zutenak. Hasieran, absolutismoaren kontrakoek modernitatearen eta liberalismoaren sinbolotzat hartu ninduten; gero, ordea, baztertu egin ninduten, friboloa izatea egotzita. 1868ko iraultza nagusitu ondoren, tronua galdu eta Frantziara alde egin nuen.






1 Ikusi noiz jaio eta noiz hil ziren orriotan ageri diren pertsona ospetsuak, eta ordenatu denak ardatz kronologiko batean zaharrenetik gazteenera. Nor bizi izan zen xx . mendera arte?

2 Unitatearen joanean, xix. mendeko beste espainiar ospetsu asko ere ezagutu dituzu. Aukeratu bat edo beste, eta azaldu txosten labur batean pertsona ospetsu horiek zer gertaeraren ondorioz igaro ziren historiara.
1868ko iraultzaren izenetako bat da. Iraultza horretan, Isabel II.a Espainiatik alde egitera behartu zuten, bere seme Alfontso XII. arekin. Iraultzaren garaipenak 1869ko Konstituzioa ekarri zuen, xix. mendeko liberalena, eta horrek Seiurteko Demokratikoa izeneko aldiari hasiera eman zion. Aldi hori Espainian demokrazia ezartzeko estreinako saiakera izan zen: aurrena, monarkia parlamentario moduan, Amadeo Savoiakoaren garaian; hurrena, errepublika moduan, Lehen Errepublikaren garaian.



Erregimen politiko horretan, gobernua ez dago errege edo erregina baten esku, baizik eta Gorteek hautatutako pertsona baten esku. Lehen Errepublikak lau presidente izan zituen, hainbat erreforma egiten ahalegindu zirenak, baina arazoak ere izan zituen: karlistaldi bat, errepublikanoen arteko borrokak, Espainiaren eta Kubaren arteko gerra, eta borboien monarkia berrezartzearen aldeko konspirazioak.

U10 197
Isabel II.a (1830-1904)
Maria Kristina HabsburgoLorrenakoa (1858-1929)
Lehen Errepublika (1873ko otsaila-1874ko abendua)
La Gloriosa (1868ko iraila)
1 Zer izan zen Fontainebleauko Ituna? Zer egiteko ahala eman zion itun horrek Frantziari? Zer gertatu zen ituna sinatu ondoren?
2 Zer eginkizun izan zuten pertsona hauek Baionako abdikazioetan?
7 Zer zen kazikismoa? Zer-nolako rola zuen kazikismoak txandakako gobernu-sistema baketsuaren garaiko hauteskundeetan?
8 Sailkatu gertaera hauek, xix. mendeko zer alditan gertatu ziren aintzat hartuta:
a) Independentzia Gerra.
b) Riegoren altxamendua.
c) Alderdien txandakako gobernu-sistema.
d) Lege salikoa.
e) Aliantza Santua.
f) Langile-mugimenduaren gorakada.
g) 1876ko Konstituzioa.
3 Idatzi komentario labur bat gertaera eta leku hauek Espainiako Independentzia Gerran izan zuten garrantziari buruz:
• Maiatzaren 2ko matxinada.
• Bailén.
• Gerrilla-gerra.
• Cádiz.
4 Idatzi koadernoan Fernando VII.aren erreinaldiko zer aldi falta den taulan. Gero, idatzi aldi bakoitzeko gertaera garrantzitsu bat.


Absolutismoaren itzulera ? Hamarkada Doilorra ? ? ?
5 Zer gertatu zen Espainiak Ameriketan zituen kolonietan Fernando VII.aren erreinaldian?
6 Lotu.
I. Errepublika


Alfontso XII.a
Amadeo Savoiakoa
Hirugarren karlistaldia piztu. Kubako gerra hasi, eta kolonia hartako jendeak independentzia eskatu.
Aita hiltzean, lehen karlistaldia hasi; gero, 1843an, tronura iritsi.
Urteetako erreinaldiaren ondoren, abdikatu eta Espainiatik alde egin.
Sistema politikoaren oinarriak: 1876ko Konstituzioa eta txandakatze-sistema baketsua
h) La Gloriosa.
i) Maria Kristinaren erregeordetza.
Fernando VII.aren erreinaldia Isabel II.aren erreinaldia Alfontso XII.aren erreinaldia ? ? ?


9 Espainiak zituen azken koloniek 1898an eskuratu zuten independentzia.
a) Zer koloniak lortu zuten independentzia? Adierazi munduko mapa batean.
b) Zer izen ipini zioten Espainiako historiaren gertaera horri?
c) Zer mugimendu sortu zen Espainiak xix mendean izandako arazoei aurre egiteko?
Semaforoa. Margotu koadernoan, ariketa bakoitzaren ondoan, honela:
erantzuna badakizu
laguntza behar izan baduzu
erantzuna jakin ez baduzu
198 PORTFOLIOA
Z er ikasi dut? A B C D
Isabel II.a
Napoleon Fernando VII.a Karlos IV.a Josef I.a
HELBURUA AURRERA
Egin inkesta bat, etxeko lanetan familiako nor aritzen den jakiteko, eta idatzi txosten bat lortutako emaitzei buruz

1 Alderdi guztiak aztertu pentsamendu-teknikaren bidez, aztertu etxeko lanei buruzko inkestan lortutako emaitzak, eta egin gogoeta. Honelako galderak egin ditzakezu: Zergatik…? Zer arrazoiren ondorioz…?
Zer kausa direla medio…?... Horrela, etxeko lanetan laguntzea zeinen beharrezkoa den konturatuko zara, eta horrek etxean ardurak banatzen lagunduko dizue.
Gero, idatzi txosten bat lortutako emaitzei buruz.
Datuak 1
Galdera: Zergatik? Zer arrazoiren ondorioz? Zer kausa direla medio? Zeri zor zaio? …
Datuak 2
? ?
Datuak 5
?
Ekintza edo gertaera
Datuak 4
Datuak 6 ? ?
Datuak 3


Galdetu hau zeure buruari!
N ola ikasi dut?
1 Ikasi duzu lehen ez zenekien zerbait? Zer irudi gogoratzen dituzu? Ikasi duzunetik zer gustatu zaizu gehien? Zertarako da baliagarria ikasi duzuna?
Zertarako balioko dizu zure eguneroko bizitzan?
2 Pentsatu zertan hobetzen jarraitu dezakezun aurrerantzean eta egin horri buruzko gogoeta. Hausnarketa zabaltzeko, pentsatu zer hobetu dezaketen ikaskideek.
Zer egin dezakezu etxeko lanen gaineko erantzukizuna partekatu beharra sustatzeko?
Ideia hauek ikasitakoa aplikatzen eta ekintzetara eramaten lagunduko dizute:
• Onartu zure erantzukizunak, eta lagundu etxeko lanetan.
• Nabarmendu etxean lan egiten duten pertsonen ahalegina.
• Eman egindako lanaren eta ikasitakoaren berri ikastetxean.
U10 199
L agundu zalantzak argitzen
Handitan garraiolari izan nahi dut, oso lanbide garrantzitsua baita banaketarako. Zein dira ekonomiajardueren beste bi elementuak? Nor aritzen dira jarduera horietan?
Ekonomia eta ekonomia-sektoreak

Faktura honi begira nago, eta erosi ditugun bi produktu hauek % 10eko BEZa dute. Zergatik igo da prezioa, eta nori eragiten dio gorakadak?

Egiaz ez dut beste elastikorik behar. Arduraz kontsumitu beharko nuke. Zer esan nahi dut arduraz kontsumitu behar dudala diodanean?
Amaren enpresak 300 langile baino gehiago ditu, eta beren produktuak mundu guztian online saltzen hasi izana ospatzen ari dira. Zer enpresa mota da, tamaina eta jardueraeremua aintzat hartuta?


Hemen, lan-zerbitzuen bulegoan, hautagai gehienek hirugarren sektorean lortuko dute lana. Zer ezaugarri ditu sektore horrek eta zer lanbide hartzen ditu barnean?

Soro hauek oso modernizatuta daude. Non daude, Europa iparraldean ala Europa hegoaldean?


200 REPASO 1 3 5 2 4 6
BERRIKUSPENA
Hemengo hau Madrilgo Dos de Mayo plaza da. Badakizu zer adierazten duen maiatzaren 2ak? Zer gertaera historikorekin dago lotuta?
Historia garaikidea. xix. mendea

Goyak Fernando VII.a marraztu zuen. Nor zen? Zer fase izan zituen haren erreinaldiak?


A zer alderdi politiko pila dagoen gaur egun! Isabel II.aren erreinaldian, ideia liberalak zituzten bi alderdi txandakatzen ziren gobernuan. Zer alderdi ziren? Zertan ziren desberdinak?

Herri honetan, bertakoek alde egin baino lehen, ideologiaz errepublikanoa zen jende asko zegoen. Zergatik hasi eta amaitu zen Lehen Errepublika Espainian?
Gurean jende asko dago antzinako ohiturak berrezartzearen alde. Hitzak zer esan nahi duen begiratu dut hiztegian. Badakizu zer izan zen Espainiako Berrezarkuntzaren sistema politikoa?
PSOE 1879an sortu zuten, eta Berrezarkuntzaren aurka zeuden alderdietako bat izan zen. Badakizu zer beste alderdi eta mugimendu zeuden haren aurka?


201 HIRUHILEKOA 3 9 10 12 11
7 8
9. ETA 10. UNITATEAK
11Espainia XX. eta XXI. mendeetan
Gaur egun, mundu osoan, bizi-itxaropena 67 urte ingurukoa da, eta Espainian, 80 urte ingurukoa. xx . mendearen hasieran, berriz, 31 urte ingurukoa zen. Aldaketa hori osasunarekin lotutako aurrerapenei esker izan da, eta, batez ere, haurren eta gazteen heriotza-tasa asko jaitsi delako medikuntzako aurrerapenengatik.
xviii mendearen amaieran lehen txertoa aurkitu zuten, eta xx mendean milioika pertsonaren bizitza salbatu zuten beste txerto batzuen abiapuntua izan zen hura, hala nola tuberkulosiaren eta gripearen txertoenak. Halaber, xx . mendean beste aurrerapen batzuk egon ziren; besteak beste, organo-transplanteak, odol-transfusioak eta gizartesegurantza ezartzea. xxi mendean, baina, medikuntzak baditu beste erronka batzuk; esate baterako, gaixotasun infekziosoak deuseztatzea, minbizia sendatzea eta arreta mediko unibertsala lortzea, besteak beste.
Zer deritzozu?


Inoiz gaixotu al zara? Nola sendatu zinen? Ezagutzen al duzu medikuntzan xx. mendean izandako aurrerapenen bat? Zein? Zertarako balio izan dute? Badakizu zer den Gizarte Segurantza? Garrantzitsua dela uste duzu?
Datua
Unitate honetarako...

Helburua aurrera
Medikuntzako aurrerapenek
biztanleentzat duten garrantziari

buruzko eztabaidan parte hartu, osasun-zerbitzuak babesteko eta hobetzeko ideiak proposatuz.
Jarraitu hariari!
Gobernuek jaitsi egin dituzte osasun-arloko inbertsioak, eta, horregatik, profesional gutxiago ari dira lanean; horrek osasungintza arriskuan jarri du. 2030erako, munduan osasuneko 18 milioi profesional beharko dira.
Alfontso XIII.aren erreinaldia eta II. Errepublika
1
xx . mendearen hasiera: krisi-garaia ala aurrerapen-garaia?
Gerra Zibila eta Francoren diktadura
2
Zein izan ziren Gerra Zibilaren zergatiak eta ondorioak?
200
Demokrazia iritsi zen
3
Nola egin zen Espainian demokraziarako trantsizioa?
Espainia Europar Batasunean
4
Zer aldatu da Espainia Europar Batasunean sartu zenetik?
EAE xx. eta xxi mendeetan
5
Zer gertatu zen gure erkidegoan?

Pertsona ezagunak eta gertaerak
6




xx . eta xxi . mendeak: zer pertsonak eta gertaerak izan dute eragina?

201 3
xx. mendearen hasiera: krisi-garaia ala aurrerapen-garaia?

Gizartean zer aurrerapen eta atzerapen garrantzitsu gertatu
ziren mendearen lehen herenean?
Alfontso XIII.aren erreinaldia (1902-1931)

Alfontso XIII.ak 1902an ekin zion bere erreinaldiari, Berrezarkuntzaren aro politikoan. Garai hartan Espainia krisian zegoen.
Alfontso XIII.aren erreinaldia


98ko krisiak Kuba eta Filipinetako kolonien galera ekarri zuen.
Kazikismoak edo boterean alderdien txandakatze baketsua izateak (kontserbadorea eta liberala) sortutako ustelkeria.
Espainiako Armadak Marokoko eremu bat okupatu zuen, Rif harana, eta horrek bi herrialdeen arteko gerra ekarri zuen.
Hala, bada, jende asko behartu zuten armadan borrokatzeko izena ematera, eta horrek gizarte-egonezin handia sortu zuen.
Horri Marokoko gerra gehitu zitzaion
«Berehala kontatuko dizut»: unitatearen laburpena eskuragarri duzu anayaharitza.es webgunean
Egoera horretan, 1923an, Primo de Rivera jeneralak estatu-kolpea eman zuen, eta diktadura ezarri. Alfontso XIII.a erregeak diktadura babestu zuen.

Primo de Riveraren diktadura (1923-1930)

Primo de Rivera jeneralak gobernu militarra ezarri zuen; Gorteak bertan behera utzi, 1876ko Konstituzioa eten, eta alderdi politikoak eta sindikatuak debekatu zituen.


Lehen Mundu Gerraren (1914-1918) ondoren munduko ekonomia ondo zihoala aprobetxatu zuen eta Marokoko gerrari amaiera eman zion. Hala ere, ez zuen babes sozialik ez politikorik izan, eta 1930ean dimititu zuen.
Alfontso XIII.a sistema parlamentarioa berrezartzen saiatu zen, baina ez zuen lortu, izen ona galdua baitzuen diktadura babesteagatik. 1931n udal-hauteskundeak egin ziren, eta alderdi errepublikanoak irabazi zituen. Erregeak Espainiatik alde egin behar izan zuen, eta apirilaren 14an Bigarren Errepublika aldarrikatu zuten.
Arazoek gizartean zabaldutako nahigabearen ondorioz, erregenerazionismoa sortu zen. Mugimendu horrek herrialdeko arazoak konpontzeko asmoa zuen.
Alfontso XIII.a erregea monarkia parlamentarioaren sistemara bueltatuko zen gobernu bat eratzen saiatu zen, baina, diktadura babestu zuenez, izen ona eta herritar gehienen konfiantza galdua zuen.
202 1
Garai hartako arazoak
Alfontso XIII.a
Alfontso XIII.a
Primo de Rivera
Balizko konponbidea
Filipinetako auzia
Filipinak
Constitución


Adierazteko, biltzeko eta elkartzeko askatasuna.
Gizon eta emakumeen sufragio unibertsala Elizaren eta Estatuaren arteko bereizketa Eskualdeen autonomia-eskubidea
Bigarren Errepublika (1931-1936)
Ezaugarri nagusiak
Erregeak alde egin eta, Bigarren Errepublika aldarrikatu ondoren, konstituzio berri bat idatzi zuten; 1931n onartu zuten konstituzio hura.
Konstituzioa onartuta, Niceto Alcalá Zamora aukeratu zuten presidente, eta Manuel Azaña gobernuburu. Zenbait erreforma jarri ziren martxan, herritarren arteko gizarte- eta ekonomia-desberdintasunak deuseztatzeko.
Erreformak
Sozialak Ekonomikoak Kulturalak
Hauek onartu ziren:
• Emakume baten eta gizon baten arteko ezkontza zibila.

• Dibortzioa.
• Emakumeek botoa emateko eskubidea.
Nabarmentzekoa:
• Nek azaritza-erreforma. Gaizki ustiatutako lurrak nekazarien esku utzi zituzten.
Hau sustatu zen:
• Hezkuntza laikoa edo ez-erlijiosoa, mistoa (neskak eta mutilak), derrigorrezkoa eta doakoa.
Erreforma horiek martxan jartzeak nahigabea eta mobilizazioak eragin zituen, bai eskuineko indar politikoen aldetik, bai ezkerrekoen indarren aldetik.
• Eskuineko indar politikoen eta Elizaren ustez, egindako erreformak gehiegizkoak ziren; izan ere, berdintasunik eza saihetsezina zen haientzat.
• Ezkerreko indar politikoen eta langile-mugimenduen ustez, ordea, ez ziren nahikoak, gizarte-berdintasuna defendatzen baitzuten.
Bigarren Errepublikaren bilakaera
1933: hauteskundeak
Eskuineko alderdi politiko kontserbadoreek irabazi zituzten, eta hasitako erreforma gehienak gerarazi zituzten. Herri-altxamenduak gertatu ziren.
Espainiako 1931ko Konstituzioaren ezaugarri nagusiak.
1 Ikertu eta eztabaidatu ikaskideekin batera honako termino hauen esanahiaren inguruan: kazikismoa, estatu-kolpea, diktadura.
2 Zer gertaerak eragin zuten Primo de Rivera jeneralaren diktaduraren hasiera eta amaiera?
3 Zein izan ziren Bigarren Errepublikan aurrera atera nahi izan zituzten erreforma nagusiak?
4 Taldeka jarrita, ikertu Espainian nork sustatu zuten emakumeek botoa emateko eskubidea, eta emakumeek zein hauteskundetan baliatu zuten lehenengo aldiz eskubide hori.
1936: hauteskundeak
Ezkerreko alderdi politikoek irabazi zituzten, eta gobernua eratu zuten. Erreformak berriz martxan jarri zituzten. Liskarrak izan ziren ezkerreko eta eskuineko herritarren artean, hau da, erreformen aldekoen eta kontrakoen artean.
Armadako sektore kontserbatzaileenek estatu-kolpea eman zuten 1936. urteko uztailean, eta halaxe hasi zen Espainiako Gerra Zibila.
Ikerketa medikoan baliabideak inbertitzeak aurrerapenak dakartza herritarren osasunean. Denentzat bizimodu osasungarria ziurtatzeak konpromiso sendoa eskatzen du, baina onurek orekatu egiten dituzte gastuak. Pertsona osasuntsuak dira ekonomia osasuntsuen oinarri.
U11 203
Gogoan hartu!
Zein izan ziren

Gerra Zibilaren zergatiak eta ondorioak?
Zergatik du garrantzia gure historiako gertaerak ikasteak?
Gerra Zibila (1936-1939)
Errepublikako gobernuaren kontrako altxamendua
1936ko uztailaren 18an, Afrikan zeuden Espainiako Armadako jeneral batzuek, Errepublikaren kontra altxatu, eta estatu-kolpea eman zuten .
Estatu-kolpeak arrakasta izan zuen herrialdeko zenbait lekutan, eta, horregatik, Espainia bitan zatituta geratu zen: altxatuen mende eta errepublikanoen mende.
Bilakaera
Altxatu ziren tropak berehala Madril hiriburua hartzen saiatu ziren, baina ez zuten lortu. Hala, lehenengo, Andaluzia hartu zuten; gero, Kantauri itsasoko ertza eta, azkenik, Mediterraneoko kostaldea. Halako batean, Madril hartu zuten, eta, horrekin batera, gerra amaitu zen, 1939ko apirilaren 1ean.

Armada altxatuaren garaipena eta gerraren ondorioak
• Errepublikaren aldekoen arteko batasun eta antolaketa falta.
• Altxatutako armada militarki gehiago zen, bai armei, bai taktika militarrei zegokienez.
Armada altxatuaren garaipenaren zergatiak
• Altxatuen mendeko eremuak babes handiagoa jaso zuen beste herrialdeetatik, hala nola nazien Alemaniatik eta faxisten Italiatik.

• Errepublikaren mendeko eremuak Sobietar Batasunaren eta Brigada Internazionalak osatu zituzten boluntarioen laguntza jaso zuen soilik.
• Biztanle kopurua jaitsi egin zen, gerran jende asko hil baitzen, eta beste askok herrialdetik irten behar izan baitzuten.
Gerraren ondorioak

• Ekonomian galerak izan ziren, industriak eta azpiegiturak suntsituta geratu baitziren.
• Diktadura ezarri zuten. Horretarako, Francok sektore kontserbadoreen, armadaren eta Elizaren babesa izan zuen.
• Errepublikaren aldeko asko jazarri, atxilotu eta exekutatu zituzten.
Matxinoak 1936ko uztaila 0100200300km
Errepublikanoak
Espainia bitan zatitu zen, eta horrek Gerra Zibila ekarri zuen. Hiru urte iraun zuen: 1936ko uztailaren 18tik 1939ko apirilaren 1a arte.
1 Erreparatu 1936. urteko altxamendu-garaiko Espainiako mapari. Zer eremu geratu ziren altxatu zirenen mende, eta zein Errepublikaren mende?

2 Laburbildu Gerra Zibilaren ondorioak.
3 Gai honi buruz hausnartu, gutxienez bi argudio idatzi eta ikaskideekin eztabaidatu: Zer dakar berekin adierazteko, biltzeko eta elkartzeko debekuak?
4 Azaldu frankismoaren bi etapa.
204 2
Oviedo
Salamanca Zaragoza Cartagena
Madril
Toledo
Ceuta Melilla
Sevilla
Bartzelona Valentzia
Burgos Iruñea Badajoz
Granada
Badira pertsona apartak! Merezi duten aitortza jasotzen al dute?
Espainiako Gerra Zibilak iraun zuen bitartean mundu osoko osasun-langileak beren borondatez heldu ziren Espainiara, zaurituak artatzera eta biziak salbatzera.
Gaur egun ere osasun-profesional batzuek, aisialdian, gutxi garatutako herrialdeetara bidaiatzen dute, eta boluntario-kanpainetan laguntzen dute, gaixoei arreta emateko.
Diktadura frankista (1939-1975)


• Ezagutzen al duzu kanpaina horietan parte hartzen duen pertsonarik edo elkarterik? Zure ustez, garrantzitsua al da haien lana? Zergatik? Gizartearen aitortza eta esker ona merezi dutela uste duzu?
• Nola lagundu diezaiekezu pertsona edo elkarte horiei? Zure ustez, nola lagundu dezakete herrialde garatuek?
Gerra Zibila amaitu zenean, Franco jeneralak bereganatu zituen estatuko botere guztiak, eta diktadura militarra ezarri zuen.
Ezaugarriak


• Alderdi politikoak debekatuta geratu ziren, baita adierazteko, biltzeko eta elkartzeko askatasuna ere.
• Erregimen autoritarioa, katolikoa eta kontserbadorea ezarri zuten.
• Espainia, Bigarren Mundu Gerran Alemaniaren eta Italiaren alde agertu zenez, bakartuta geratu zen nazioartean.


Diktaduraren etapak
Bi etapa bereizten dira:
Kronologia. 40ko (gerraostea) eta 50eko hamarkadetan garatu zen.
Ezaugarri ekonomikoak. Espainia bakartuta geratu zen Nazioartean eta, horregatik, autohornikuntzan oinarritutako ekonomia ezarri zuten. Produktuen eskasia, elikagaien errazionamendua eta gosea ziren nagusi.
Ezaugarri politikoak. Jazarpenaren eta errepresioaren politika ezarri zuten; ideia politiko eta sozialengatik jendea kartzelatu eta, zenbaitetan, heriotza-zigorra ezartzen zitzaien; erbesteratzeak, zentsura...
Espainian bertan frankismoaren kontrako oposizioa ahula izan zen, eta mendialdeko eremuetan sakabanatuta zegoen. Oposizio klandestinoa ere egon zen, zenbait greba bultzatu zituena.
gertatu zen. Ezaugarri ekonomikoak. Ekonomia-garapeneko planak jarri ziren martxan, herrialdearen industrializazioa eta modernizazioa bultzatzeko eta turismoa indartzeko. Halaber, emigrazio handia gertatu zen landa-eremutik hirietara eta Europako zenbait herrialdetara; adibidez, Alemaniara.
Ezaugarri politikoak. Espainiak amaiera eman zion bakartzeari, baina artean ere erregimen autoritarioa zegoen. Oposizioak garrantzi handiagoa hartu zuen, ezkutuko langile-sindikatuei esker (UGT, CCOO eta CNT), eta ETA eta GRAPO talde terroristen eraginez. Langileek eta ikasleek greba asko egiten zituzten, eta erregimen frankistak gogor zapaltzen zituen.
U11 205
Autarkia (1939-1959)
Nola egin zen Espainian demokraziarako trantsizioa?
Espainiako herritarrek zer oinarrizko eskubide berreskuratu
zituzten Trantsizioan?
Trantsizioa eta demokraziaren finkatzea
1969. urtean, Francok Juan Carlos I.a izendatu zuen bere ondorengo izateko. Horrela, haren erregimenak aurrera egingo zuen, monarkia modura.
Franco 1975ean hil zen, eta Juan Carlos I.a erregeak Adolfo Suárez izendatu zuen presidente Trantsiziorako. Trantsizioa mugimendu eta alderdi politikoen arteko negoziazio, kontsentsu eta akordioen bidez egin zen.
Adolfo Suárez erreformista zen, eta zenbait lege onartu zituen alderdi politikoak legeztatzeko eta diktadura frankista erregimen demokratiko bihurtzeko. 1977. urtean, errepublika-garaitik egingo ziren lehen hauteskunde demokratikoetarako deia egin zuten, eta UCDk (Zentro Demokratikoaren Batasuna) irabazi zuen. Hautatutako Gorteek 1978ko Konstituzioa idatzi zuten, eta, gerora, 1978ko abenduaren 6an, herritarrek Konstituzioa onartu egin zuten erreferendum batean. Ordutik, hauteskundeak egiten dira lau urtetik behin, eta gobernu kontserbadoreak, progresistak eta koaliziokoak txandakatu izan dira.
Zein alderdik gobernatu duten demokrazia ezarri zenetik
Ordezkariak: Adolfo Suárez eta Leopoldo Calvo Sotelo.
Zentro Demokratikoaren Batasuna (UCD)
Ordezkariak: Felipe González, José Luis Rodríguez Zapatero eta Pedro Sánchez.
Espainiako Alderdi Sozialista Langilea (PSOE)
Ordezkariak: José María Aznar, Mariano Rajoy eta Alberto Núñez Feijóo.
Alderdi Popularra (PP)
Zer da Trantsizioa?
Franco hil ondoren aldaketa politikorako izandako prozesua da, Espainia estatu demokratiko bihurtzeko helburuz egina bi talderen arteko adostasunaren bidez:
Erreformistak
Erregimen frankistaren barruan erreformak egitearen aldeko kontserbadoreak.
Hausleak Erregimen frankista amaitzearen aldeko oposizioko kideak.
1 Nor izan zen Adolfo Suárez? Zerrendatu zer egin zuen Trantsizioan.
2 Irakurri 1978ko Konstituzioaren ezaugarri nagusiak. Aukeratu zure ustez garrantzitsuenak diren hiru. Eztabaidatu ikaskideekin zure aukerari buruz.
3 Osatu Espainiako antolaketa politikoari buruzko taula hau.
Unidas Podemos (Podemos-IU)
Ordezkariak: Pablo Iglesias eta Yolanda Díaz. Koalizio-gobernua: PSOE-Unidas Podemos. Gobernu-presidentea: Pedro Sánchez. Gobernuko bigarren presidenteordea: Yolanda Díaz.
?

Zeregin nagusiak Erregea Gorteak Gobernua Epaileak

206 3
Ezaugarri nagusiak
1978ko Konstituzioa
1981ean, militar-talde armatu bat Kongresuan sartu zen. Haien helburua Espainian berriz diktadura ezartzea zen. Ekintzak porrot egin zuen eta, azkenean, atxilotu egin zituzten.

1978ko Konstituzioa
• Subiranotasuna (boterea) herrian datza, eta Estatuaren eredu politikoa monarkia parlamentarioa da.
• Botere-banaketa aitortzen da: legegilea, betearazlea eta judiziala.


• Espainiaren batasuna, eta Espainia osatzen duten nazionalitate eta herrialdeen autonomia-eskubidea.
• Elkartzeko, biltzeko eta adierazteko askatasuna.
• Askatasun ideologikoa eta erlijiosoa.
• Heriotza-zigorra indarrik gabe geratzen da.
• Espainiarrak berdinak dira legearen arabera; ezin da inolako bereizkeriarik egin jaiotza, arraza, sexu, iritzi edo erlijioagatik.
• Hezkuntzarako eskubidea; oinarrizko hezkuntza nahitaezkoa eta doakoa da.
• Jabetza pribaturako, lanerako, etxebizitza duina izateko eta osasun- eta gizarte-laguntzarako eskubidea.
• Betebeharrak: gastu publikoei aurre egiten lagundu zergen bidez, Espainia defendatu eta legeak bete.
Antolaketa politikoa
Espainiako eredu politikoa monarkia parlamentarioa da; Felipe VI.a da estatuburua. Haren kargua hil artekoa eta oinordetzakoa da. Zereginak: erakundeen moderatzaile izatea eta atzerrian herrialdea ordezkatzea.
Zenbait erakunderen artean banatzen dira botere legegilea, betearazlea eta judiziala.
Gizarte Segurantza. Gure osasunaren babesle handia
Lehen gizarte-asegurua xx mendearen hasieran sortu zen, eta hori Lan Istripuen Legea izan zen. Hortik aurrera, herritarrentzako hainbat babes-mekanismo sortuz joan dira egoera hauetarako: gaixotasuna, lan-istripua, langabezia, ezintasuna eta erretiroa.
Botere legegilea


Botere judiziala
Gorte Nagusien esku, haiek egiten baitituzte legeak.
Gorteen elementuak:
• Kongresua.
• Senatua.
Auzitegien esku, legeak betetzen direla zaintzen baitute.
Auzitegi garrantzitsuenak:
• Auzitegi Gorena.
• Auzitegi Konstituzionala.
Botere betearazlea


Gobernuaren esku, legeak hark zuzentzen eta betearazten baititu.
Hauek osatua:
• Presidenteak
• Ministroek
• Ikertu. Zer da Gizarte Segurantza, eta nola funtzionatzen du Espainian? Nork du gizarte-segurantzarako eskubidea? Sistema publikoa da? Nondik dator prestazioetarako dirua?
• Hausnartu galdera hauen inguruan. Zer aldatuko litzateke Gizarte Segurantzarik ez balego? Zure ustez, munduko herrialde guztiek dute Gizarte Segurantza? Zergatik zaindu behar dugu Gizarte Segurantza? Nola kontzientziatu dezakegu jendea Gizarte Segurantzaren garrantziaz? Sistema hori hobetu dezakegu? Nola hobetu dezakegu?
Osasunak eta bizimodu osasungarriak duten garrantziari buruzko kontzientzia zabaldu dezakegu gure inguruan, baita pertsona guztiek kalitatezko osasun-zerbitzuak izateko duten eskubidearen berri eman ere.
U11 207
Gogoan hartu!
Estatuaren botereak eta erakundeak
Antonio Tejero teniente koronela.
Zer aldatu da Espainia Europar Batasunean
sartu zenetik?
Trantsizioa erabat funtsezkoa izan zen Espainia
Europar Batasunean sartu ahal izateko. Zergatik?
Europar Batasunaren eraketa
Bigarren Mundu Gerra amaitu zenean (1939-1945), Europako herrialde batzuek ekonomia- eta politika-elkarte bat osatzea erabaki zuten, Europan arlo horien suntsipena eragozteko. Europar Batasunaren sorrerak fase hauek izan zituen:
Europar Batasunaren sorrera eta bilakaera
Europako Ekonomia Erkidegoa (EEE) sortu zen



1957an, Alemaniak, Belgikak, Frantziak, Herbehereek, Italiak eta Luxenburgok EEE sortu zuten, Erromako Ituna sinatu ondoren. Merkatu erkide bat ezarri zuten, eta salgaiek libreki zirkula zezaketen, estatu kideetako aduanetan zergarik ordaindu behar izan gabe.
Europar Batasunak izandako hedapenei buruzko mapa ikus dezakezu anayaharitza.es webgunean
Kide gehiago sartu ziren

1957tik aurrera kide gehiago sartu ziren EEEn. Espainia 1986an sartu zen, herrialdean demokrazia ezarri ondoren. Horretarako, herritarren artean erreferenduma egin zen.
EEEtik EBra
1992an, Maastricht-eko Ituna sinatu ondoren, Europako Ekonomia Erkidegoak Europar Batasuna (EB) izena hartu zuen. Hainbat erakunde eta politika komun sortu zituzten, Europako herritarrentzat zenbait lege ezartzeko, askatasun- eta justizia-eremu bat sortzeko eta EBko estatu kideetan ekonomia- eta gizarte-garapena bultzatzeko.
Hauek dira erakunde nagusiak: Europako Parlamentua, Europar Batasuneko Kontseilua, Europako Batzordea eta Europako Justizia Auzitegia.
Diru bakarra: euroa
2002. urteko urtarrilaren 1ean, Europar Batasuneko hamabi herrialdek euroa hartu zuten ditu bakartzat, eta, hala, eurogunea eratu zen.

208 4
Espainia Europar Batasunean sartzeak izandako ondorioak
Ondorioak hauek izan dira, besteak beste:
• Politika-ondoriak. Eredu demokratikoa eta par lamentarioa sendotu egin zen.
• Ekonomia-ondoriak. Ekonomia-garapena ger tatu zen, eta azpiegiturak eraiki eta hobetu ziren (errepideak, aireportuak, portuak…).



• Gizarte-ondorioak. Estatuak hainbat baliabide erabiltzen ditu herritarren ongizaterako eta hez kuntza eta osasun unibertsala eta doakoa ber matzeko.
1 Zerk bultzatu zituen herrialde batzuk elkartzera eta gerora Europar Batasuna izango zena osatzera?
2 Erabili Europako mapa mutu bat, eta egin ariketa hauek.

a) Idatzi Europar Batasuna osatzen duten 27 herrialdeen izena.
b) Margotu 1957an Erromako Ituna sinatu zuten herrialdeak.
3 Egin eskema labur bat, Espainiarentzat Europar Batasunean sartzeak izan zituen ondorio nagusiak azaltzeko.
4 Espainian noiz ezarri zuten euroa? Europar Batasuneko zein herrialdetan ez dute erabiltzen euroa? Espainian zer diru erabiltzen zen euroaren aurretik?
5 Imajinatu Espainia ez dagoela EBn. Zer gertatuko litzateke egoera hauetan?:
• Frantziara kamioi bat salgaiekin eraman beharko bazenu, han saltzeko.
• Turismoa egiteko asmoz, Portugalgo mugara iritsiko bazina.
• Italiara bizitzera eta ikastera joan nahiko bazenu.
Gure profesionalek aitortza behar dute!
2020. urtean, koronabirusaren pandemia zela eta, Gobernuak etxeko konfinamendua dekretatu zuen herritar guztientzat. Ospitaleetako egoera oso gogorra izan zen; izan ere, egunero-egunero ehunka pertsona hiltzen ziren. Osasun-arloko profesionalek ahalegin handia egin zuten pazienteei arreta emateko eta haien bizitza salbatzeko.
• Gogoratzen duzu herritarrek egunero nola eskertzen zuten osasun-arloko profesionalen lana?
• Zure ustez, nola aitortu eta hobetu daiteke langile horien lana? Eman zure ideiak, eta saiatu beste ideia batzuk sortzen.
Osasun- eta ongizate-zerbitzuak eskura izatea giza eskubide bat da, eta, horregatik, Garapen Jasangarrirako Agendak aukera ematen du pertsona guztiek ahalik eta osasun onena eta osasun-arreta egokiena izan dezaten, eta ez soilik horretarako bitartekoak dituztenek.

U11 209
ERRUSIA
Sizilia
Kreta
Sardinia
Korsika
Balearrak
Azoreak
Kanariak
ESTONIA LETONIA HUNGARIA LITUANIA ZIPRE MALTA BULGARIA ERRUMANIA ESLOVENIA ESLOVAKIA TXEKIAR ERREP. POLONIA PORTUGAL ESPAINIA FRANTZIA BELGIKA IRLANDA ITALIA GREZIA AUSTRIA LUXENBURGO KROAZIA ALEMANIA HERBEHEREAK ERRESUMA BATUA DANIMARKA FINLANDIA SUEDIA OZEANO ARTIKOA Itsaso Baltiko a Ipar itsasoa Norvegiako itsasoa Itsaso Beltza M e d i t e r r a neo its a s o a OZEANO ATLANTIKOA 02505007501000km
Madeira uharteak (PORTUGAL)
Ceuta (ESPAINIA) Melilla (ESPAINIA)
(ITALIA)
(GREZIA)
(ITALIA)
(FRANTZIA)
(ESPAINIA)
(PORTUGAL)
(ESPAINIA)
Gogoan hartu!
Europar Batasuna
Euroa diru bakartzat hartua duten estatuak
Europar Batasuneko estatu kideak
Zer gertatu zen gure erkidegoan?
Euskal Autonomia Erkidegoa
xx. mendearen lehen herenean



xx . mendearen lehen herenean, gure erkidegoak
Espainiako estatuko industriaren motor nagusienetakoa izaten jarraitu zuen.
• 1902an, Bizkaiko Labe Garaiak sortu ziren; enpresa hark burdina eta altzairua esportatzen zituen Europa osora.
• Gipuzkoan, nabarmentzekoak dira metalurgia eta arma- eta paper- industriak, besteak beste.
Hala eta guztiz ere, xx . mendeko lehenengo urteetan, gatazkek eta langileen grebek jarraipena izan zuten.
Bilbo, xx mendearen hasieran
Errepideak
Burdinbideak
Zubiak
Bigarren Errepublika eta Gerra Zibila
Bigarren Errepublika aldarrikatu eta 1931ko Konstituzioa promulgatu ondoren, Euskal Autonomia Erkidegoak autonomiaerregimen berria eskatu zuen.

Eskakizun hori ez zen 1936ra arte onartu, eta Gerra Zibila amaitu arte bakarrik egon zen indarrean. Gauza bera gertatu zen Jose Antonio Agirreren gobernu autonomikoarekin. Jose Antonio Agirre lehen lehendakari aukeratu zuten, gerra hasi eta gutxira.
Armada matxinatuaren altxamenduak arrakasta izan zuen Araban, oso arin; ez, ordea, Bizkaian eta Gipuzkoan, eta gobernu errepublikanoari leial izan zitzaizkion.
1937ko apirilaren 26an, altxamendu militarra babestu zuten alemanen eta italiarren aireindarrek Gernika bonbardatu zuten. Kaleak estuak izanda, eta etxeak bata bestearen ondoan eraikita zeudenez, sua oso bizkor eta erraz zabaldu zen, eta herria ia guztiz suntsituta gelditu zen. Zifra ofizialik ez badago ere, eraso horretan 250 pertsona hil zirela uste da.
Altxatuen nagusitasun militarra agerikoa zen, eta, azkenean, 1937an, armada frankistako tropek Bilbo hartu zuten.
Oinazea artelanetan
Ikertu eta bilatu Pablo Picassoren zer artelanek islatzen duen Euskadin gerran izandako gertaera lazgarri bat. Gero, laburbildu gertakari hartan jazo zena.

210 5
Zer bilakaera izan du euskal gizarteak xx. mendearen hasierarik gaur egun arte?
19001910 Alfontso XIII.aren
Espainia
Espainiako
II.
Primo de Riveraren diktadura 19201930194019501960 1970 19801990200020102020Oraina Herriak eta hiriak
erregealdia
EBn sartu Francoren diktadura
Gerra Zibila
Errepublika Trantsizio demokratikoa
Industria-eremuak Meatze-eremuak Fabrikak Portuak Mineral-zamalekuak
Euskal Autonomia Erkidegoa diktaduran
Gerra amaitutakoan, erregimen frankistak saritu egin zuen Araba, bando irabazlearen alde agertu zelako. Bizkaia eta Gipuzkoa, berriz, probintzia traidoretzat hartu zituen.
Bestalde, euskal industriak, eta, bereziki, metalurgiak, burdingintzak, industria kimikoak, papergintzak, ontzigintzak eta arma-industriak, onura atera zuten gerra amaitutakoan, suntsitutako herriak, komunikabideak, etab. berreraikitzeko egin behar izan ziren lanekin. Horrez gain, Bilboko bankak garrantzi handia hartu zuen.
Ondorioz, gure lurraldea ekonomiagune inportantea bilakatu zen, eta horrek biztanleriaren hazkunde sendoa ekarri zuen.
Bestalde, hirurogeiko hamarkadako garapen ekonomikoak langilemugimendua eta diktaduraren aurkako oposizioa berrindartu zituen. Liskar- eta errepresio-testuinguru horretan, ETA sortu zen; eta frankismoaren kontra egiteko estrategia gisa, borroka armatua martxan jarri zuen.
Euskal Autonomia Erkidegoa gaur egun
Autonomia-estatutua 1979ko abenduaren 18an onartu zen. Lege horri esker, gure erkidegoak autogobernu-maila nahiko handia lortu zuen. Euskal erakunde gorena Legebiltzarra da, eta legeak egiteaz eta Eusko Jaurlaritzaren jarduna kontrolatzeaz arduratzen da.
xxi . mendearen hasieratik, EAEk aldakuntza- eta hobekuntzaprozesua bizi du: komunikabideetan, autobia berriak eta abiadura handiko trena eraikitzen ari dira; hiriek garatzen jarraitzen dute; eta osasun, kultura- eta hezkuntza-arloko zerbitzuen eskaintza zabaldu da.
Euskal gizarte modernoa


xxi . mendeko euskal gizartea modernizatuta dago, eta Espainiako autonomia-erkidegorik garatuenetako bat da, baita aberatsenetako bat ere. Egin bi sarrerako taula bat, honako hauek laburbiltzeko:
a) Gaur egun Euskadin bizitzeak dituen onurak.
1 Zer euskal enpresak esportatzen zituen burdina eta altzai rua Europara xx . mendearen hasieran?
2 Europako zer herrialdek egin zuten armada frankistaren alde gerran?
3 Zergatik hartu zituzten Bizkaia eta Gipuzkoa probintzia traidoretzat gerraren ostean?
4 Egin zerrenda bat gure lurraldean xx. eta xxi. mendeetan izan diren bost gertaera garran tzitsu aipatuz.


b) Gure lurraldeak izan ditzakeen hobekuntza posibleak.

Eusko Jaurlaritzaren eskumenetako bat da EAEko biztanleen osasuna babestea eta denoi osasun-zerbitzu egokiak eskaintzea.

U11 211
Bilboko ontziolak diktaduraren amaieran.
Gogoan hartu!
Gasteizko Plaza Berria gaur egun.
XX. eta XXI. mendeak: zer pertsonak eta gertaerak izan dute eragina?


Zer gertaeratan nabarmendu ziren pertsona ezagun hauek?
Zergatik izan ziren garrantzitsuak gertaera haiek?
Espainian izandako lorpen historiko baten eragile nagusietako bat naiz: 1933. urteko hauteskundeetan, emakumeek lehen aldiz botoa eman ahal izan zuten. Legelari, politikari eta idazle modura jardun nuen. Espainiako eskubideak defendatu nituen. Besteak beste, Emakumeen botoa eta ni (1935) idatzi nuen.


1902an hasi nuen erreinaldia. 1876. urteko Konstituzioaren zina egin banuen ere, Primo de Riveraren estatu-kolpea babestu nuen, eta hark diktadura ezarri zuen. Errepublika aldarrikatu zutenean (1931) Espainiatik alde egin nuen.
Errazionamendua
Gerra Zibilaren ondoren, gerraostean, oinarrizko produktuen (ogia, esnea, olioa, arroza...) eskasia handia zegoen. Hori dela eta, estatuak errazionamendua ezarri zuen, hau da, pertsona edo familia bakoitzarentzat produktuak eskuratzeko kupo bat ezarri zuen. Horretarako, errazionamendu-txartela banatu zuen: kupoiz osatutako dokumentu bat, oinarrizko elikagaiak eskuratzeko estatuak kontrolatzen zituen dendetan. Horren guztiaren ondorioz, produktu horien prezioa igo egin zen, eta merkatu beltza edo legez kanpokoa sortu.
xx. mendearen hasierako langilegrebetan parte hartu nuen, eta Espainiako Alderdi Komunistako (PCE) buruzagia izan nintzen. Gerra Zibilaren ondoren, herritar asko bezala, Espainiatik alde egin behar izan nuen. 1977. urtean bueltatu nintzen, demokrazia ezarri zenean, eta herritarrek Parlamentuko diputatu aukeratu ninduten.




212
6
Clara Campoamor (1888-1972)
Alfontso XIII.a (1886 - 1941)
Dolores Ibarruri (1895-1989)
Espainiako Trantsizio demokratikoko pertsona gakoetako bat izan nintzen. Frankismo-garaian hasi nuen nire ibilbide politikoa. Franco hil ondoren, Juan Carlos I.a erregeak gobernuburu izendatu ninduen, garai hartan Espainia herrialde demokratikoa bihurtzeko helburuz. Alderdi politikoak legeztatu nituen; izan ere, diktaduragaraian debekatuta egon ziren. 1977. urtean egin nuen hauteskundeetarako deia, eta irabazi egin nituen. 1981ean dimititu egin nuen.
Espainiako historian gobernu bateko lehen emakume ministroa izan nintzen: Osasuneko eta Gizarte Laguntzako Ministerioko burua izan nintzen Bigarren Errepublikan. Gerra Zibilean, Frantzian erbesteratu nintzen. Franco hil, eta bi urtera bueltatu nintzen Espainiara.

1 Jarri izenburua. Irakurri hemen aurkeztutako pertsona bakoitzaren biografia, eta saiatu esaldi batekin laburbiltzen zer ekarpen egin duen historian.





2 Adolfo Suárezez gain, Espainiako demokraziako zer beste presidente ezagutzen dituzu? Ikertu, eta idatzi haiei buruzko aipamen txiki bat. Partekatu gainerako ikaskideekin zure ikerketen emaitzak.

Antropologoa, irakaslea eta ikertzailea naiz. Euskal Herriko Unibertsitatean (EHU) Gizarte Antropologia irakasteko kontratatu zuten lehen pertsona izan nintzen. EHUn bertan, 1984an, antropologia feministari buruzko lehen ikastaroa eman nuen. Emakunderen Berdintasun saria eman zidaten 2010ean. Gaur egun, EHUn Gizarte Antropologiako katedradun emeritua naiz.

2008an hasitako ekonomia-krisiak eta PSOEren eta PPren gobernuek egindako gizarte-murrizketek kalera aterarazi gintuzten, eta M-15 mugimendua sortu zen: demokrazia partizipatiboagoa eskatzen dugu. Manifestazioaren ondoren, batzarrak osatu genituen, eta zenbait mugimendu sortu ziren, hezkuntzako eta osasun-arloko murrizketen kontra protesta egiteko, hala nola Marea Berdea eta Marea Zuria. «Ahal da» Herri Batzarretik, 2014an Podemos alderdia sortu zen.



U11 213
Federica Montseny (1905-1994)
Teresa del Valle (1937)
M-15a. Herritarrak (2011ko maiatzaren 15a- gaur egun)
Adolfo Suárez (1932- 2014)
Z er ikasi dut ?
1 Zer egoeratan zegoen Espainia xx mendearen hasieran Alfontso XIII.ak bere erreinaldiari ekin zionean?
2 Primo de Riveraren gobernua diktadura bat izan zen. Zergatik?
3 Aipatu Bigarren Errepublikan egin ziren erreformetako batzuk.
4 Zer dira gerra zibilak? Laburbildu Espainiako Gerra Zibilak izandako ondorio nagusiak.
5 Zein izan ziren frankismoaren etapa nagusiak? Azaldu horietako bakoitza.
6 Zein dira 1931ko eta 1978ko konstituzioen arteko desberdintasun nagusiak?
7 Azaldu baieztapen hauek zuzenak (Z) edo okerrak (O) diren.
• Primo de Riveraren estatu-kolpearen ondorioz hasi zen frankismoa.
• Bigarren Errepublikaren garaian, Alfontso XIII.a erregea Espainian geratu zen.


• Gerra Zibilean, altxamenduaren aldekoek Alemaniaren eta Italiaren laguntza izan zuten.
• II. Errepublikako Konstituzioan, Espainian lehen aldiz onartu zen emakumeen boto-eskubidea.
• Gerra Zibilaren ondoren, herritar askok, Espainiatik alde egin, eta erbestean bizi behar izan zuten Francoren diktaduraren errepresalien beldurrez.
• II. Errepublikaren garaian izandako gobernuetan Espainian ez zen gatazkarik izan.
• Espainia 1992. urtean sartu zen Europar Batasunean.
8 Kokatu denbora-lerroan, gutxi gorabehera, aipatzen diren etapa historikoak.
9 Sailkatu taulan honako gertaera eta pertsona historiko hauek.
Adolfo Suárez
Monarkia parlamentarioa
Autarkia
Emakumeen botoa
Manuel Azaña
Estatu-kolpea
Diktadura
Desarrollismoa
Ezkontza zibila eta dibortzioa
1978ko Konstituzioa
Espainia Europar Batasunean sartu
1931ko Konstituzioa
Alderdi politikoak debekatu
Adierazpen-askatasuna
Biltzeko eta elkartzeko askatasuna
Alderdi politikoak legeztatu
II. Errepublika Diktadura frankista Trantsizio demokratikoa ? ? ?
Semaforoa. Margotu koadernoan, ariketa bakoitzaren ondoan, honela:
erantzuna badakizu
laguntza behar izan baduzu
erantzuna jakin ez baduzu
214 PORTFOLIOA PORFOLIO
19001910
Alfontso XIII.aren erregealdia Espainia EBn sartu Francoren diktadura
Espainiako Gerra Zibila
II. Errepublika Trantsizio demokratikoa 19201930194019501960 1970 19801990200020102020Oraina
Primo de Riveraren diktadura
HELBURUA AURRERA
Eztabaidatu medikuntzako aurrerapenek duten garrantziari buruz eta osasun-zerbitzuak hobetzeko moduei buruz
1 Zirikatzeko galderak deritzon pentsamendu-teknikaren bidez, hausnartu ikasi duzunari buruz, eta ikaskideekin eztabaidatu medikuntzan egiten diren aurrerapenek eta gure osasuna zaintzeko lan egiten duten profesionalek duten garrantziari buruz, gai horien inguruko ideiak, argudioak eta ondorioak azalduz. Lotu ondorengo galderak ikertutako elementuekin, eta azaldu zure iritziak eta ekimenak.
Galderak Ikertutako elementuak
– Zergatik dira garrantzitsuak…?
– Zein da honako hauen helburua…?

– Zer gertatuko litzateke honako hauek ez baleude:…?
– Zer aldatuko litzateke hauek hobetuko balira:…?
– Nola azaldu diezaiekegu gure aitortza eta esker ona honako hauei:…?
N ola ikasi dut?
1 Ikasi duzu lehen ez zenekien zerbait? Zer irudi gogoratzen dituzu? Ikasi duzunetik zer gustatu zaizu gehien? Zertarako da baliagarria ikasi duzuna? Zertarako balioko dizu zure eguneroko bizitzan?
2 Pentsatu zertan hobetzen jarraitu dezakezun aurrerantzean eta egin horri buruzko gogoeta. Hausnarketa zabaltzeko, pentsatu zer hobetu dezaketen ikaskideek.
1. … (penizilina,Medikuntza-aurrerapenak txertoak...)
2. … Garatu herrialdeetangabekoboluntariolanak egiten dituzten elkarteak eta profesionalak.
3. … Gizarte Segurantzaren sistema.


4. … Ikerketarako inbertsioa, osasuneko azpiegiturakprofesionalak, eta aurrerapen teknologikoak.
Galdetu hau zeure buruari!
Zuk zer egin dezakezu medikuntzako aurrerapenen eta osasuneko profesionalek egiten dituzten ahaleginen berri emateko, eta jendea kontzientziatzeko horrek guztiak aitortza eta esker ona behar dituela? Nola lagundu dezakegu arlo horietan hobetzen eta aurrera egiten jarraitzeko?
Ideia hauek ikasitakoa aplikatzen lagunduko dizute.
– Bidali idazki formal bat buruzagiei.
– Adierazi esker ona zure erreferentziazko osasun-zentroko profesionalei.
– Lan egin boluntariotza-elkarte eta -mugimenduekin.
– Parte hartu ikastetxeko kontzientziazio-kanpaina batean.
U11 215
12 E konomia, gizartea eta kultur a
Gaur egun, gure eguneroko bizimodua energia-zerbitzuen inguruan dago ardaztuta. Jaikitzen garenetik oheratzen garen arte gailu teknologikoak, etxetresna elektrikoak, garraiobideak eta funtzionatzeko energia-iturriak behar dituzten bestelako tresnak erabiltzen ditugu.
xix. eta xx mendeetan, gizakiak erabili dituen energia-iturri nagusiak erregai fosilak izan dira, hala nola ikatza, petrolioa eta gasa. Baina haiek erabiltzean karbono-isurpen handiak eta berotegi-efektuko gasak sortzen direnez, klima-aldaketa eragiten dute, eta kaltegarriak dira jendearentzat eta ingurumenarentzat.
Hori dela eta, xxi. mendean, munduko herrialdeak aztertzen ari dira nola azkartu energia-sistema jasangarri baterako trantsizioa, energia berriztagarrietan inbertituz (eguzki-energia, eolikoa...) eta kutsatzen ez duen energia baliatzen duten teknologiak garatuz.

Zer deritzozu?

Iraganean zertarako behar ziren energia-iturriak? Eta gaur egunean? Noiz asmatu zen elektrizitatea? Zertarako erabiltzen dugu?
Zer energia-iturritatik lortzen dugu elektrizitatea? Horietako zeinek isurtzen dute karbono kantitate handia atmosferara? Horrek zer ondorio ditu gure bizitzan?

Datua
Unitate honetarako...
Helburua aurrera
Ikertu energiaren inguruan dagoen
arazoari buruz, eta egin gida bat gizarte-kontzientzia zabaltzeko.
Gidan zure ideia propioak eta ekintza txiki ekoarduratsuak jaso behar dituzu.
Jarraitu hariari!
Energia da klima-aldaketan gehien eragiten duen faktorea. Izan ere, mundu osoko berotegi-efektuko gas-isurpenen % 60 energiari dagokio.
xix. mendeko ekonomia- eta gizarte-aldaketak
1
Zertan oinarritzen zen klase-gizarte berria?
216
xix. mendeko kultura eta artea
2
Zer aldaketa izan
zituzten hiriek
XIX. mendean?





xx. eta xxi. mendeetako ekonomia eta gizartea
3
Zer bilakaera izan dute ekonomiak eta gizarteak XX. eta XXI. mendeetan?

xx eta xxi mendeetako kultura eta artea
4
Zerk bultzatu ditu XX. eta XXI. mendeetako kultura- eta arte-aldaketak?
5
Aro Garaikideko gertaerak eta pertsona ezagunak Zer gertaera eta pertsona nabarmendu dira garai honetan?
217 7
Zertan oinarritzen zen klase-gizarte berria?
Industria Iraultzaren eta garraiobideen aldaketaren ondorioz, hirietan energia gehiago behar izan zen?
xix mendea aldaketa- eta erreforma-garaia izan zen. Espainian, aldaketak motel eta, beste herrialde batzuekin alderatuta, berandu gertatu ziren, eta herrialdeko sektore eta eremu zehatz batzuetan soilik izan zuten eragina.
Industria Iraultza
Fabriketan eta landa-eremuan makinak erabiltzen hasi zirenean, ekoizpenean eta kontsumoan aldaketa handiak gertatu ziren, eta horrek Industria Iraultza eragin zuen. Britainia Handian hasi zen, 1800. urte inguruan, eta handik Europako gainerako herrialdeetara zabaldu zen.
Industria Iraultzaren aurretik erabiltzen ziren lanabesek gizakiaren edo animalien indarrarekin funtzionatzen zuten. Zenbait asmakizunek (lurrun-makina...) eta fabriken sorrerak aldatu egin zituzten ekoizpena, lan egiteko modua eta garai hartako jendearen bizi-baldintzak.
Espainiako Industria Iraultzaren aurrekariak. Nekazaritza-erreformak
Espainiako ekonomia-jarduera nekazaritzan oinarrituta zegoen nagusiki. xix mendean zenbait erreforma egin ziren, nekazariek beren lur propioak izan zitzaten; adibidez, desamortizazioa.
Desamortizazioak, hau da, nobleziaren eta Elizaren esku zeuden lurren salmentak nekazarien eskuetara igaro zitezen, mesede egin zien nobleziari eta burgesiari, haiek baitzituzten lurrak erosteko baliabideak. Hala, nekazariak lurrak soldata baten truke lantzen hasi ziren.
Espainiako industrializazioa
Espainian industrializazio-prozesua geldoa izan zen: xx mendera arte iraun zuen. Nagusiki, hiru sektoretan ardaztu zen: meatzaritzan, Asturiasen; siderurgian, Euskal Herrian, eta ehungintzan, Katalunian.
Hauek izan ziren Europako beste herrialde batzuekin alderatuta Espainian industriak izandako atzerapenaren arrazoietako batzuk:
• Produktu-eskaera txikia zegoen, nekazariak pobreak zirelako eta biztanleriaren hazkundea txikia zelako.
• Ez zen fabriketan inbertitzen; horretarako bitartekoak zituztenek, hala nola burgesek edota nobleek, lurren erosketan inbertitzen zuten.
• Lehengai, energia-iturri eta halako baliabideen eskasia zegoen, eta beste herrialde batzuetatik inportatu behar ziren.
• Koloniak galdu ziren, eta, horiekin batera, produktuak saltzeko merkatuak ere bai.
Industria Iraultza
Zerk eragin zuen?
Ekoizpenean eta kontsumoan izandako aldaketak.
Noiz eta non gertatu zen?
1800. urtean, Britainia Handian. Espainian, xix mendearen erdialdean hasi zen.
Elementu bereizgarriak:
• Mekanizazioa. Makina berriak sortu ziren, hala nola lurrun-makina. Hura makina (ehungailuak, iruteko makinak...) eta garraiobide (trenak, itsasontziak…) mota guztietan aplikatu zuten.
• Fabrikak. Fabrikek ordezkatu zituzten lantegiak.
• Langile-klasea edo proletarioak, hau da, soldata oso txiki baten truke fabriketan lanaldi luzeak egiten zituzten pertsonak.
Lurrun-makina
1 Zein zen desamortizazioen helburua? Lortu al zen?
2 Garai jakin batean, fabriketako ekoizpenean makinak erabiltzen hasi ziren. Zer izen du garai horrek?
a) Siderurgia
b) xix. mendea


c) Industria Iraultza
d) Klase-gizartea

218 1
Garraiobideen modernizazioa

xix. mendean, errepideak hedatu ziren eta trenbidea eraikitzen hasi ziren.
Espainiako lehen trenbideak Kuban —Espainiaren kolonia zen— eta Katalunian eraiki ziren. 1855etik aurrera, Madril Espainiako portu nagusiekin lotzeko trenbideak eraiki zituzten.
Klase-gizartea
Gizartean, estamentutan oinarritutako gizarte batetik klasetan oinarritutako batera aldatu zen. Klaseak pertsonen aberastasunaren arabera banatuta zeuden, eta hiru bereizten ziren: goi-klasea, erdi-klasea eta behe-klasea.
Klase hau gutxi batzuek osatzen zuten, eta talde hauek bereizten ziren:
Goi-klasea
Antzinako noblezia. Boterea galdu zuen. Burgesia. Baliabide ekonomikoak zituztenek osatua; nekazaritza-, industria- eta merkataritzajardueretan inbertitzen zuten.
Erdiklasea
Klase hau pertsona-talde ez oso handi batez osatua zegoen, eta honako hauek bereizten ziren: Lurrak zituztenak.
Medikuak, abokatuak, merkatari txikiak eta halako lanbideak zituztenak.
Klase honetakoak ziren biztanle gehienak, eta honako hauek osatzen zuten:
Beheklasea
Soroetan, fabriketan eta meategietan lan egiten zuten. Lanaren ordainetan, gehienetan, soldata oso urriak jasotzen zituzten.
Gizarte-gatazkak
• Landa-eremuan. Nekazariek erreboltak eragin zituzten, soldata txiki eta bizi-baldintza gogorren kontra egiteko.
• Hirietan. Fabriketan lan egiten zutenek (gizon, emakume eta neska-mutikoak) oso lanaldi luzeak egiten zituzten soldata eskas baten truke. Arazo horiei aurre egiteko eta haien bizi-baldintzak hobetzeko, langile-mugimendua
xix. mendeko azken hamarkadetan langile-mugimenduak indar handia hartu zuen. Ekintza kolektiboak egin zituzten, eta organizazioak eratu: lehenengo, elkarteak, eta, gero, sindikatuak.
Espainiako lehen trenbideak
1837. urtean, Kuban —garai hartan Espainiaren kolonia zen—, Habana-Güines trenbidea eraiki zuten.

1848. urtean, berriz, Bartzelona-Mataró trenbidea eraiki zuten.

Energia-iturriak. Zertarako erabiltzen dira?
Energia-iturriak guztiz presente daude gure egunerokotasunean, bai ekonomia-jardueretan, bai jendearen zereginetan.
Aztertu zer energia-iturri erabiltzen dituzuen zuk eta zure familiak ekintza hauek egiteko:
• Etxea berotu neguan
• Elikagaiak fresko mantendu
• Herrian leku batetik bestera mugitu
• Kozinatu
• Tresna elektronikoak kargatu
• Gauean argia piztu
• Dutxa hartu


Ekintza horietako askotarako energia elektrikoa behar duzuela ohartuko zinen. Zer dira zentral elektrikoak? Nola iristen da elektrizitatea gure etxeetara? Komentatu zure ondorioak gainerako ikaskideekin.
3 Azaldu zein izan ziren Espainian industrializazioa atzeratzearen eta moteltzearen arrazoiak.
4 Zertan oinarritzen da klase-gizartea?
Zure ustez, zer klasetakoak izango ziren kultura-arloko pertsonak ?
Espainian 1875ean eraiki zen lehen zentral elektrikoa, Bartzelonan.
U12 219
Gogoan hartu!
Zer aldaketa izan zituzten hiriek XIX. mendean?
Erabiltzen ziren energia -iturriak berriztagarriak ala berriztaezinak ziren?
Hiriak handitu egin ziren
Industria Iraultzak jendearen bizimodua aldatu zuen. Jende asko aldatu zen landa-eremutik hirietara, fabriketan lan egitera. Hiriak handitu eta berregituratu egin ziren. Auzo berriak sortu ziren hiri-inguruetan; adibidez, langile-auzoak edota zabalguneak. Zabalguneetan, adibidez, burgesia kokatu zen.
Tren-geltokia. Eraikin berria

Hiri-ingurua. Langile-auzoak, trazadura nahasikoak. Ez zuten ez ur, ez argi, ez estolderiarik.
Zabalguneak. Auzo burgesak, ondo trazatuak. Luxuzko etxebizitzak.
Eraikin berriak. Eraikitzeko, material berriak baliatu ziren: beira, burdina, altzairua.
Hiri-ingurua. Langileentzako auzoak
Berrikuntza eta asmakizun nabarmenak
Hezkuntza Museoak eta liburutegiak
Hezkuntza-erreformek jaitsi egin zuten zegoen analfabetismo handia. Heziketa-joera berriak bultzatu ziren (Irakaskuntza Erakunde Askea...), hezkuntza berritzeko eta irakaskuntza mistoa —neskak eta mutilak ikasgela berean— ezartzeko.
Desamortizazioekin, Elizaren ondasun asko museo, liburutegi eta unibertsitateen eskuetara igaro ziren, kontserbatu ahal izateko. Museoek, esate baterako Prado museoak, betekizun hezigarria bereganatu zuten.

Zinema Argazkia

Lumière anaiek asmatu zuten 1895ean, Frantzian, eta berehala zabaldu zen gainerako herrialdeetara. Espainiara 1896an iritsi zen. Orduz geroztik, zinemak, ikuskizun modura, bilakaera etengabea izan du.



Joseph-Nicéphore Niépcek egin zuen lehen argazkia, 1826an, baina Louis Daguerrek garatu eta zabaldu zuen asmakizuna, 1839an. Argazkiak eragin handia izan zuen pinturan, errealitateari modu fidelean begiratzeko eta enkoadratze eta plano desberdinak planteatzeko bidea eman baitzuen.

220 2
Fabrika. Eraikin berria
Zabalgunea. Burgesiarentzako auzoak
Nondik sortzen da energia?
xix. mendean eta xx. mendearen zati handi batean erabiltzen ziren energia-iturriak berriztaezinak ziren nagusiki; adibidez, ikatza eta petrolioa. Gaur egun, industrian, udalerrietan eta etxeetan erabiltzen dugun elektrizitatea zentral elektrikoetan sortzen da. Zentral elektrikoak energia elektrikoa sortzeko instalazioak dira, eta, horretarako, energia-iturriak (berriztagarriak zein berriztaezinak) erabiltzen dituzte.
Zentral elektriko mota desberdinak daude; adibidez, eguzki-zentral fotovoltaikoak eta zentral nuklearrak. Ondoko grafikoan, Espainian elektrizitatea sortzeko erabiltzen diren energia-iturri primarioak ageri dira.
Arte- eta kultura-mugimenduak
2022ko otsaileko energia-sorkuntzaren egitura
Ziklo konbinatua % 22,5
Fuela + gasa % 1,5
Hondakin berriztaezinak % 0,7
Kogenerazioa % 10,0
Bestelako berriztagarriak %1,8
Hondakin berriztagarriak % 0,3
Energia nuklearra % 22,6
Berriztaezinak 61,0 %
Berriztagarriak 39,0 %


Ikatza % 2,7
Ponpatzeturbinazioa % 1,0
Eguzkienergia termikoa % 1,0
Energia hidraulikoa % 5,9
Eguzki-energia fotovoltaikoa % 7,8
Energia eolikoa % 22,1
Energia hidroelektrikoa % 0,0

Iturria: Red Eléctrica de España.
• Ikertu. Zein energia-iturrik erabiltzen dituzte energia primario berriztagarriak, eta zeinek ez?
• Kalkulatu. Energia-iturri berriztagarrien eta berriztaezinen zer ehuneko erabiltzen da?
• Zer ondorio ateratzen dituzu? Bururatzen zaizu aldaketarako ekimenik? Komentatu ondorioak ikaskideekin.
Industrializazioak politika, ekonomia eta gizartea aldatu zituen, baita pertsonen pentsatzeko eta munduarekin harremanetan jartzeko modua ere. xix mendean arte- eta kultura-joera berriak sortu ziren.
Erromantizismoa
Errealismoa
Inpresionismoa
Pertsonaren eta haren sentimenduen garrantzia aldezten duen arte-joera. Espainiako literaturan hauek aipa daitezke: José de Espronceda, Gustavo Adolfo Bécquer, Rosalía de Castro eta Jose Mari Iparragirre euskal poeta eta musikaria.

Errealitatea den bezala agertu nahi duen arte-joera. Espainiako literaturan, hauek aipa daitezke: Benito Pérez Galdós, Emilia Pardo Bazán eta Vicente Blasco Ibáñez.
Batez ere, pintura-arloko arte-joera. Munduaren berezko irudikapena lortu nahi du, argia eta unea islatuz. Hauek aipa daitezke: Claude Monet, Edgar Degas, Joaquín Sorolla, Mary Cassat eta Fernando Amarika.


1 Zer esan nahi du hiri industrialetan zabalguneak eraiki izanak? Ikertu, eta eman xix . mendeko Espainiako hirietako zabalguneen adibideak.
2 1826an egin zen lehen argazkia. Nork egin zuen?

Bilatu Interneten historiako lehen argazkia, eta deskribatu zer ageri den bertan.
3 Erreparatu arretaz xix. mendeko ondoko artelanei. Zergatik dira aipatzen den arte-estilokoak? Komentatu zure ondorioak ikaskideekin.
Energia eskuragarri eta ez-kutsatzailea 7. GJHaren arabera, 2030erako nabarmen handitu beharko litzateke energia berriztagarrien erabilera energia-iturrien artean.
U12 221
Erromantizismoa Inpresionismoa Errealismoa
Gogoan hartu!
Zer bilakaera izan dute ekonomiak eta gizarteak XX. eta XXI. mendeetan?
Nola aldatu da gure etxeetan energia kontsumitzeko modua?
Espainia Europar Batasunean sartu zen
Ekonomiaren bilakaera
1900-1936
mendearen hasieran, elikaduran eta medikuntzan izandako hobekuntzei esker, biztanleria areagotu, eta heriotza-tasa jaitsi zen. Landa-eremuan eta herrixketan, ekonomiak eta gizarteak industriaeremuan eta hirietan baino geldoago egin zuten aurrera.
1936-1960

Gerra Zibilaren ondoren, Francoren diktadurak autarkia-politika ezarri zuen, hau da, Espainiak bere baliabide propioekin hornitzen zuen bere burua, eta ez zuen ezer erosten edo saltzen beste herrialdeetan. Horrek eskasia eta geldialdi ekonomikoa eragin zituen.




1960-1978



tera heldu zen. Espazio horretan pertsonek eta salgaiek libre zirkula dezakete estatu kideen artean.
Eurogunea ere osatu zen. Europar Batasuneko herrialdeak diru bakarra erabiltzen hasi ziren: euroa.

Zer da globalizazioa?
xx mendean, komunikabideetan izugarrizko aurrerapena izan zen, eta xxi mendean, berriz, esan daiteke sekulako iraultza egon dela arlo horretan. Mundua «herrixka handi bat» bihurtu da, non pertsonen bizimodua antzeratsua den toki guztietan, eta haien artean planetako edozein tokitatik berehala komunika daitezkeen teknologia berriei esker.
Planetako biztanleak interkonektatu, eta herrialdeen arteko merkataritza-trukeak areagotu ditu prozesu horrek, baina pertsonen arteko ekonomia- eta gizarte-desberdintasunak ere areagotu ditu.
1960ko hamarkadan, amaiera eman zitzaion autarkiari; beste herrialdeekiko harremanei eta merkataritzari ekin zitzaien, eta horrek ekonomiaren modernizazioa ekarri zuen. Horren ondorioz, herritarren bizi-baldintzak hobetu egin ziren.
1978-gaur egun
Demokraziarekin, Espainia kapitalismoan barneratu zen. Sistema hori merkatuekonomian eta kontsumo-gizartean oinarritzen da. Gaurko gizartearen ezaugarri nagusietako bat ekonomia-desberdintasunek eragiten duten gizarte-desberdintasuna da.

222 3
HERBEHEREAK ALEMANIA LUXENBURGO DANIMARKA FINLANDIA SUEDIA ESTONIA ERRESUMA BATUA BELGIKA FRANTZIA ESPAINIA ITALIA PORTUGAL IRLANDA ESLOVENIA KROAZIA BOSNIAHERZ. IPAR MAZEDONIA MONTENEGRO ALBANIA SERBIA Kosovo AUSTRIA ERRUMANIA BULGARIA TURKIA ZIPRE GREZIA MALTA POLONIA TXEKIAR ERREP. ESLOVAKIA HUNGARIA LETONIA LITUANIA Ipar itsasoa Itsaso Baltikoa Itsaso Beltza Norvegiako itsasoa OZEANO ATLANTIKOA itsasoa Mediterraneo EBren hedapena 1957 1973 1981 1986 1990 1995 2004 2007 2013 EBko kide izatea eskatu duten estatuak 2020 Hautagai potentzialak 0250500750km
Telefonoa Irratia
Telefono finkoa xix mendean asmatu zuten, eta 1920ko hamarkadan hasi zen etxeetan erabiltzen. 1928an, Espainiaren eta AEBren arteko telefono-zerbitzua inauguratu zen, Alfontso XIII.aren eta Estatu Batuetako presidente Calvin Coolidgeren arteko elkarrizketa batekin. Herritar gehienen aldetik, 1990-1995 urte bitartean hasi zen lehen telefono mugikorren erabilera.
Telebista
Telebista izan zen xx mendeko komunikabide nagusia. Gaur egun ere, publizitaterako bide eraginkorra da.
Irratia xix mendean asmatu zuten, 1920ko hamarkadatik aurrera toki garrantzitsua izan zuen etxeetan. Irrati-nobelak, musika, albistegiak eta entretenimendu-programak ematen zituzten.
Smartphoneak


Telefono adimendunak dira, ukipen-pantailadun ordenagailu txiki batzuk balira bezala. 2007an zabaldu zen erabilera herritarren artean.
Internet 2.0 weba




Internet elkarrekin konektatutako komunikazio-sareen multzo bat da. 1969an sortu zen, Estatu Batuetan, world wide web (www) sortu baitzuten, baina, oro har, etxeetara ez zen iritsi 2006. urtera arte.
Komunikabideen bilakaera
2000. urtetik aurrera, Interneten aro soziala deitu izan dena sortu zen, hau da, erabiltzaileek edukiak sortu ditzakete. Foroak, blogak eta beste plataforma batzuk sortu ohi dira edukiak partekatzeko helburuarekin.
xx mendera arte, jendeak albisteen eta gertaeren berri «ahoz aho» jasotzen zuen, edo egunkarien edota herri eta hirietako agintarien iragarki ofizialen bidez. Toki batetik bestera komunikatzeko, gutun idatziak bidaltzen edo jasotzen ziren. xx mendean, baina, komunikabideek aurrerapen handia izan zuten, eta xxi mendean, berriz, arlo horretan benetako iraultza gertatu dela esan daiteke.
Energia-efizientziaren etiketak
xix eta xx mendeetan , komunikabideen arloan aurrerapen handia izateaz gain, etxetresna elektriko batzuk ere asmatu ziren; adibidez, hozkailua eta garbigailua.
Gaur egun, gure etxeetan egunero erabiltzen ditugun etxetresna elektrikoak ditugu. Tresna horiek energia behar dute funtzionatzeko.
• Ikertu, eta komentatu zure hipotesiak. Zenbat energia elektriko kontsumitzen da gure etxeetan? Zein etxetresna elektrikok kontsumitzen dute energia gehien?
• Etxetresna elektriko bat erosten dugunean, haren etiketak erakusten digu zer energia-efizientzia duen eta zenbat kontsumitzen duen. Bilatu informazioa etiketetan agertzen diren balioen esanahiari buruz.
Etxetresna elektriko efizienteak erabiltzeak esan nahi du energia gutxiago kontsumitzen dela, eta, eskala handiago batean, karbono gutxiago isurtzen dela energia elektrikoa ekoizteko orduan.

1 Azaldu zer den globalizazioa. Taldeka jarrita, hausnartu globalizazioaren abantailei eta desabantailei buruz.
2 Galdetu familiakoei nolakoak ziren irratia eta telebista txikiak zirenean. Alderatu aipatzen dituzten komunikabideetako batzuk nola erabiltzen ziren garai batean eta zuk gaur egun nola erabiltzen dituzun.
3 Espainian, noiz iritsi zen Internet etxeetara? Egin konparazio-taula bat Interneten abantailekin eta desabantailekin.

U12 223
Gogoan hartu!
Komunikabideen bilakaera.
Zerk bultzatu ditu
XX. eta XXI. mendeetako
kultura- eta arte-aldaketak?

Artea eta kultura nola bil daitezke mugimendu berdera, eta nola erreibindika dezakete garapen jasangarria?
xx . mendean eta gaur egun, kulturan eta artean aldaketa asko eta azkarrak gertatu dira eta gertatzen ari dira oraindik ere. Kontsumorako eta aisialdirako espazio asko eta askotarikoak sortu dira ekoizpenteknika modernoaren, teknologiaren, publizitatearen eta marketinaren eraginez.
Arkitektura eta hirigintza

Arrazionalismoa
Organizismoa

Eraikinen eta naturaren arteko harmonia lortu nahi da.
Literatura eta zinema
Ezaugarriak
Literatura


Literatura-generoak eta autoreak asko eta askotarikoak dira. Autore batzuk: Federico García Lorca, Rosa Chacel, Eduardo Mendoza, Almudena Grandes, Bernardo Atxaga, Arantxa Urretabizkaia.
1 Alderatu xx mendean garatu ziren arkitektura-estiloak.
2 Bilatu high-tech eraikinen adibideak, eta egin ezazu informazio-fitxa bat haiei buruz. Esate baterako, zertarako erabiltzen dira eraikin horiek? Zein tokitan daude? Zer urtetan eraiki ziren?
High tech
Diseinu futuristak, arkitektura eta ingeniaritza uztartuta.


Zinema, hasiera-hasieratik, asmatu zenetik alegia, entretenimenduzko ikuskizun bihurtu zen. Zinemaren industriak milaka film ekoitzi ditu, eta, hala, arte bihurtu da.

224 4
Joera nagusiak
Eraikin berriak dira, bizimodu berrietara egokituak.
Zinema
Abangoardiak eta haien berrikuntzak
Fauvismoa Kubismoa Futurismoa Surrealismoa
Arte-mugimenduak



xx mendearen hasieraz geroztik, zenbait arte-mugimendu sortu ziren: abangoardiak. Haien ezaugarria esperimentazioa eta aurrekoarekin haustea zen. Mugimendu berritzaileak izan ziren, eta gizarteak beti ez zituen ulertu, ezta balioetsi ere.
Mugimendu berdea
xx mendeko azken hamarkadetan, mugimendu ekologista edo berdea sortu zen. Energia ekoizteko orduan natura neurriz gain erabiltzen dela salatzeari ekin zioten garai hartako gizatalde batzuek. Mugimendu berdearen helburuak honako hauek dira, besteak beste: baliabide naturalen kontserbazioa eta birsorkuntza, basabizitzaren babesa, eta kontzientziazioa, kutsadura apaltzeko eta hirietako bizimodua hobetzeko.





Landu zure ekologista-kontzientzia, eta bil zaitez energia aurrezteko keinu txikien mugimendura!
Etxean gaudenean, ekintza txiki batzuek energia aurrezten lagundu dezakete, esate baterako: argi naturala aprobetxatu; egunez argiak itzalita eduki; tresna baten kargagailua deskonektatu, erabiltzen ari ez bagara. Baina keinu txiki horietaz gain, beste zer egin dezakegu?
• Ikertu, eta komentatu zer hiru ekintza xumek lagundu dezaketen etxean energia aurrezten.
3 Zer esan nahi du zinema asmatu zenean mutua zela? Noiz aldatu zen egoera hori?
4 Bilatu xx mendean sortu eta hemen aipatzen den arte-estilo bakoitzari dagokion obra bat. Ikertu ezazu obra zein artistarena den eta gaur egun non dagoen ikusgai. Komentatu zure emaitzak gelako gainerako ikaskideekin.


Gogoan hartu!

Plastikoa, besteak beste, honako material hauek erabiliz egiten da: ikatza, gas naturala eta petrolioa. Energia aurrezteko helburuz, plastikoa eta halako materialak birziklatzea edo berrerabiltzea kontuan hartu beharreko keinu xume horietako bat da.

U12 225
Marrazkia eta kolorea nabarmentzen dira.
Irudiak forma geometrikotan bereizten dira.
Etorkizuna, modernitatea eta makinak erreibindikatzen dira.
Subkontzientea eta irrazionala islatzen dira.
Espresionismoa Dadaismoa Arte abstraktua Abangoardien berrikuntzak Sentimenduak adierazi nahi zituen. Artearen suntsipena aldarrikatzen zuen.
Ez dira errealitateko objektuak edo irudiak irudikatzen.
1945az geroztik sortu ziren: pop artea, hiperrealismoa...
Pop artea komikietan, publizitatean... inspiratu zen.
Zer gertaera eta pertsona nabarmendu
dira garai honetan?


Zer pertsona historiko nabarmendu ziren Aro Garaikideko ekonomia, gizarte, kultura eta artearen eboluzioan?




Bilbon jaio nintzen, eta Espainiako argazkigintzako aitzindarietako bat naiz. Nire argazkietan kalitate teknikoa nabarmendu daiteke, eta garai hartako ohiturak, jaiak eta tradizioak erretratatzen nituen. Ia beti kanpoaldean eta argi naturalarekin egiten nituen argazkiak, garai hartan ohitura monumentuetan zentratzea eta estudioko argazkiak egitea bazen ere. 1891n Ingalaterrara joan nintzen bizitzera, eta hantxe deskubritu nuen argazkigintza, materialak eta teknika.

Emakumezko lehen euskal idazlea, euskaraz alegiak argitaratu, eta haurrentzat euskaraz argitaratu zuen lehen idazlea naiz. Oso gazterik, umezurtz geratu, eta osabarekin, Joan Antonio Mogel apaiz idazlearekin bizitzera joan nintzen. Osabak, Peru Abarkaren egileak, euskaraz, gaztelaniaz eta latinez irakurtzen eta idazten irakatsi zidan. 1804an argitaratu nuen Ipui onac izenburuko alegia-bilduma.
Málagan jaio nintzen. Filosofiaren ikerketan nabarmendu nintzen. Irakasle jardun nuen unibertsitatean, doktore-tesia egiten nuen bitartean. Gerra Zibilean giza laguntzako misioetan aritu nintzen. Europako eta Hego Amerikako zenbait herrialdetan bizi izan nintzen, eta irakasten, hitzaldiak ematen eta idazten aritu nintzen.
Meatzaritza: industrializazioaren oinarria Bizkaian. Bizkaiko burdinak garrantzi berezia izan zuen industrializazioan. Burdinolek eta Somorrostrotik ateratzen zen kalitate handiko metalak merkatu ona zuten Europa atlantikoan. Gainera, Bilboko portua leku estrategikoa zen nazioarteko merkataritza hori egiteko. Burdina meatzeetatik itsasontzietara eraman behar zen, eta horretarako idien bidez gurdietan eramateko sistema hobetu behar zen.

226
5
Eulalia Abaitua (1853-1943)
Bizenta Mogel Elgezabal (1782-1854)
Bizkaiko XIX. mendeko meatzaritza
María Zambrano (1904-1991)
«Kapelagabeak»
«27ko belaunaldia» deritzon mugimenduko zenbait emakumeri izen hori eman ziguten. Besteak beste, honako hauek osatzen dugu kapelagabeen taldea: Margarita Manso, Maruja Mallo, Concha Méndez, Josefina de la Torre eta Ernestina Champourcin. Gizonen artean, hauek aipa daitezke: Federico García Lorca eta Pedro Salinas. «Kapelagabeak» deitu ziguten artista-talde batekin batera parte hartu genuelako kapela eramateko derrigortasunaren kontrako erreibindikazio batean: kapela kendu, eta Puerta del Sol plazan, Madrilen, ibili ginen protestan. Batzuek, iraindu, eta harriak bota zizkiguten.






1 Ikertu Aro Garaikideko beste pertsona eta gertaera batzuei buruz. Horren ondoren, egin biografia edo txosten bat.
2 Idatzi izenburu bat. Ikasitakoa kontuan hartuta, laburbildu esaldi batean pertsona ezagun hauetako bakoitzaren bizitza. Zer bururatzen zaizu?
Venezuelan jaio nintzen, baina urtebete nuela familia Euskal Herrira aldatu zen bizitzera. Arte Ederretako doktore naiz (EHU), eta, gaur egun, animaziozko zinemari buruzko klaseak ematen ditut EHUn bertan. 1993. urtean hasi nintzen filmak egiten. 1997an, Goya saria jaso nuen, Pregunta por mí (Nigatik galdetu ezazu) animaziozko film laburragatik.


Kazetaria eta idazlea naiz. Cádizen jaio nintzen, eta 12 urterekin Madrilera aldatu nintzen bizitzera. Kazetaritza ikasten hasi nintzen, baina utzi egin nuen, esatari, gidoilari eta aktore modura lan egiteko irratian eta telebistan. Manolito Laubegi nire lehen nobelak, Madrilgo Carabanchel auzoko haur bati buruzkoak, arrakasta handia izan zuen. Pertsonaiek Espainiako gizartea islatzen dute. Beste pertsonaia bati buruzko (Olivia) liburuak ere idatzi ditut, baita helduentzako obrak ere.

U12 227
Elvira Lindo (1962)
Begoña Vicario Calvo (1962)
Z er ikasi dut ?
1 Aukeratu erantzun zuzena. Zer izan zen Industria Iraultza?:
a) Gizarte-gatazka bat.
b) Fabriketan lan egiteko eta ekoizteko moduan izandako aldaketa multzo bat.
c) Langile-klasearen mugimendu bat.
2 Erreparatu ondorengo irudi honi. Zer gertaera historikori eta garairi dagokio? Zer toki izan zitekeen?




Goi-klasea ?
6
a) Inpresionismoa.
b) Kubismoa.
c) Pop artea.
d) Surrealismoa.
e) Dadaismoa.
7 Egin eskema bat komunikabideek xx . mendean izandako bilakaera azalduz.
Erdi-klasea ?
8 Azaldu globalizazio kontzeptuaren esanahia zein den . Aipatu, zure bizitza-estiloa kontuan hartuta, globalizazioaren bi adibide.
Behe-klasea ?




Semaforoa. Margotu koadernoan, ariketa bakoitzaren ondoan, honela:

erantzuna badakizu
laguntza behar izan baduzu
erantzuna jakin ez baduzu
228 PORFOLIO PORTFOLIOA
3 Osatu konparazio-koadroa gizarte-klaseen arteko desberdintasunak azalduta.
4 Azaldu aztertu dugun garaian zer garrantzi zuten hiriek eta zer aldaketa izan zituzten.
5 Idatzi zer arkitektura motari dagokion eraikin bakoitza. Laburbildu estilo bakoitzaren ezaugarriak.
Arte-estilo hauetatik zein dira xix mendekoak?
A B C
HELBURUA AURRERA
Egin energia aurrezteko gida bat
1 Gurpil logikoa pentsamendu-teknikaren bidez, antolatu unitatean zehar ateratako ondorioak. Identifikatu arazoa, eta konparatu energia eta elektrizitatea ekoizteko orduan energia berriztagarriak eta berriztaezinak erabiltzearen artean dauden aldeak, eta bakoitzak ingurumenean dituen ondorioak. Gero, proposatu eguneroko bizitzan energia aurrezteko egin daitezkeen ekintza xumeak, gizarte-kontzientzia handitzeko balio dezaketenak.
Identifikatu


Zer dira zentral elektrikoak? Zer energia primario mota erabil- tzen dituzte? Etxean zertarako erabiltzen dugu elektrizitatea?
Argudiatu, aztertu Zer egin dezakegu? Zer ekintza xumek lagundu dezakete?
N ola ikasi dut?
Kausa-ondorio loturak egin Aldaketa behar dela uste duzu? Zer ondorio izan ditzake egoera aldatzeak edo ez aldatzeak?
Alderatu
Espainian zer energia-iturri primario dira erabilienak? Egoera aldatu al da aurreko mendeekin alderatuta?
Galdetu hau zeure buruari!
Zer egin dezakezu zuk gai honetan zure harri-koxkorra jartzeko, eta, horretaz gain, beste pertsona batzuk kontzientziatzeko etxean energiaren erabilera arduratsua egiteari buruz?
1 Ikasi duzu lehen ez zenekien zerbait? Zer irudi gogoratzen dituzu? Ikasi duzunetik zer gustatu zaizu gehien? Zertarako da baliagarria ikasi duzuna? Zertarako balioko dizu zure eguneroko bizitzan?
2 Pentsatu zertan hobetzen jarraitu dezakezun aurrerantzean eta egin horri buruzko gogoeta. Hausnarketa zabaltzeko, pentsatu zer hobetu dezaketen ikaskideek.
Ideia hauek ikasitakoa praktikan jartzen lagunduko dizute:
• Komentatu, eta zure familia kontzientziatu. Praktikan jarri etxean energia aurrezteko zure ideiak.
• Zabaldu zure ondorioak ikastetxean.
• Egin energia aurrezteko gida bat, eta lagundu gizartean kontzientzia zabaltzen.
• Sortu arazoari buruzko materiala, gizartearentzat deigarria izango dena. Azaldu munduari zure ideiak eta ondorioak.

U12 229
1 2 3 4 Gurpil logikoa
L agundu zalantzak argitzen

Historia garaikidea. xx. eta xxi. mendeak




Bandera hori ikusten dut batzuetan. Zer garaitan eta zergatik sortu zuten?
Gure herrian zeuden fabrikak ageri dira argazki hauetan, baina Espainiako Gerra Zibilean eta gerraostean azpiegitura asko suntsitu zituzten. Zer dakizu garai horretaz?
Badakizu nor zen Franco? Zenbat urte iraun zuen diktadura frankistak Espainian?
Euroa ezarri baino lehen, Europako edozein herrialdetara joateko, jendeak dirua aldatu behar izaten zuen. Zer da EB? Zer herrialde dira EBko kide?
Abenduaren 6a, Konstituzio
Eguna, jai da. Dena den, zera… Zer da eta zertarako balio du konstituzioak?

ABENDUA
Liburu hau gure Autonomia Estatutua da. Zer gertaera historiko jazo ziren estatutuak onartu baino lehen?

230 2 1
6 5
REPASO
4 3
BERRIKUSPENA
Historia garaikidea. Ekonomia, gizartea eta kultura

Britainia Handira egin dugun bidaia honetatik gehien gustatu zaizkidan jardueren artean, museo industrial honetara egindako bisita nabarmenduko nuke. Zer da Industria Iraultza eta zergatik iritsi zen hain berandu Espainiara?

Hiri hau Industria Iraultzaren garaian hazi zen. Zabalgunea eta hiri-ingurua gehitu zizkioten, eta eraikin berriak agertu ziren. Zertan dira desberdinak zabalgunea eta hiri-ingurua?

xx. eta xxi. mendeen artean sortutako berrikuntzei esker, gaur egun, munduko edozein bazterretan gaudela ere, bat-batean komunika gaitezke. Zer berrikuntzari buruz ari naiz?
Asko gustatu zait museoan ikusi dugun abangoardiei buruzko erakusketa. Zuri ere bai? Zer abangoardia-mugimendu aipatuko zenituzke?

Nola aldatu den trena Espainian! Iberiar penintsulako zer eskualdetan egin zuten aurreneko trenbidea? Garai batean, trenak Espainiako hiri eta portu nagusiak lotzen zituen. Zer dela eta?

Horra kapelagabeak. Badakizu nor izan ziren?

231 HIRUHILEKOA 3 7 9 11 8 10 12
11. ETA 12. UNITATEAK
ITZALAPROIEKTUAK UZTENDUTEN
EZAGUTU DIZIPLINARTEKO PROIEKTUA
Birika berdea
ITZALTZEA BAINO, SAIHESTEA HOBE
Zertan lagundu dezake ingurumenhezkuntzak baso-suteen prebentzioan?
Babestu ditzagun gure mendiak!
Batzarrean, hitz egin gai hauei buruz: Zer da baso-suteen prebentzioa?
Zer egin dezakegu guk prebentzio-neurrien alde konprometitzeko?

Zer hutsegite motaren ondorioz piztu daiteke sua mendian?
Zer aholku ezagutzen dituzu suterik ez izateko?
Eta etxean, zer egin dezakegu suterik ez izateko?
Idatzi ideia-jasa honetan aipatu dituzuen ideia guztiak.
Sistema batzuk oso aproposak dira suteak prebenitzeko, eta, sutea pizten bada ere, ondorioak arinagoak izaten laguntzen digute.

Sute gehien-gehienak hutsegiteen edo jokaera arduragabeen ondorioz pizten dira.
Bildu informazioa eta grabatu gure erkidegoko herritarrak sentsibilizatzeko telebista-saio bat!
Informazioak ekoarduratsuagoak izaten lagunduko digu!

232
1 T hink P ENTSATU D esign 2 DISEINA T U
Informazioa hautatu eta laburtuko dugu; idatzi erraz ulertzeko moduan, eta eutsi beti zorroztasun zientifikoari.
Ikasgelan, banatu lanak: grabazioa, aurkezpena, argiztapena, soinua, gidoia, Interneteko bideoak…
Eska diezaiokezue laguntza profesional bati, zuen saioan parte hartu dezan?
4 PRESENTA S tage
AURKEZTU

Gizartea ingurumen-arazo larri honetaz sentsibilizatzeko ikasi dugun guztiaren berri ematea da saioaren helburua.

Erabaki noiz emango duzuen saioa; gelan proiekta dezakezue, edo ikastetxeko areto nagusian, edo udalak utzitako areto handiago batean, edo eskolako web-orrira igo dezakezue, edo zuen herri edo hiriko telebista-kate baten bidez zabaldu… Telebista-saio ikusiena bihurtuko da, inondik ere!

EGIAZTAT U 5
Ez nekien, eta orain badakit.
233 3. HIRUHILEKOA
EGIN
3 M aker T est